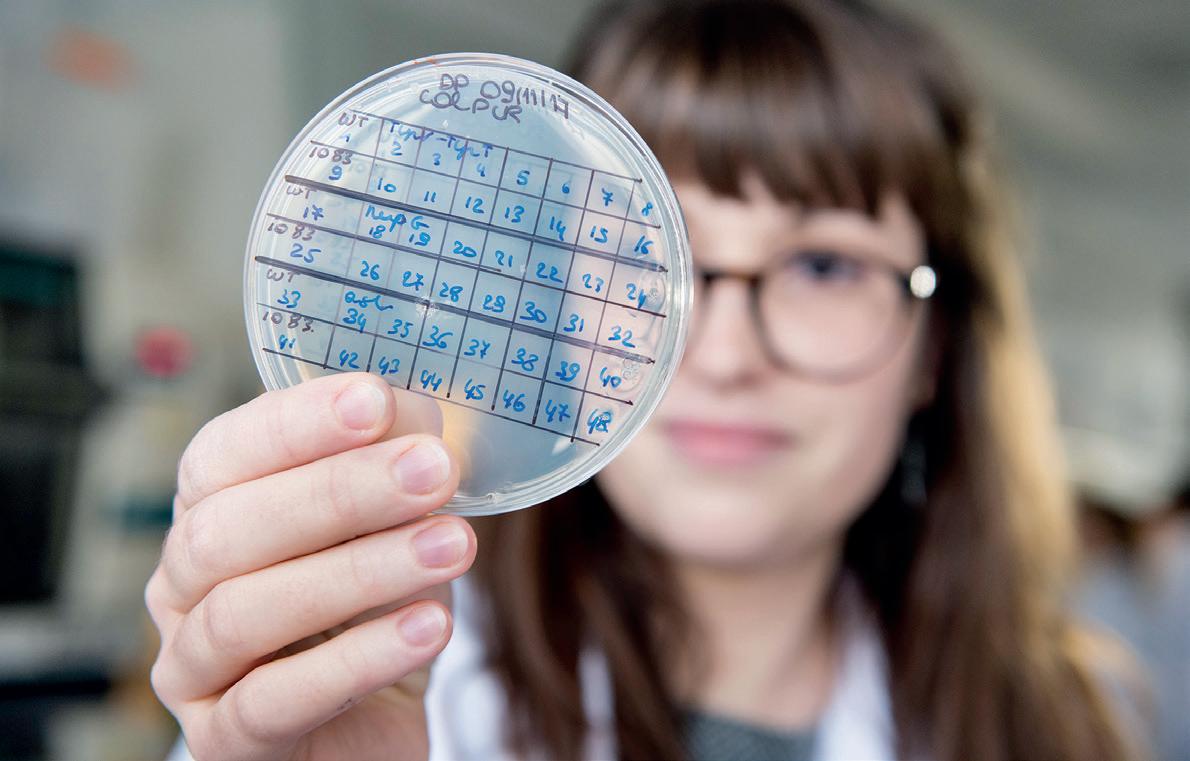
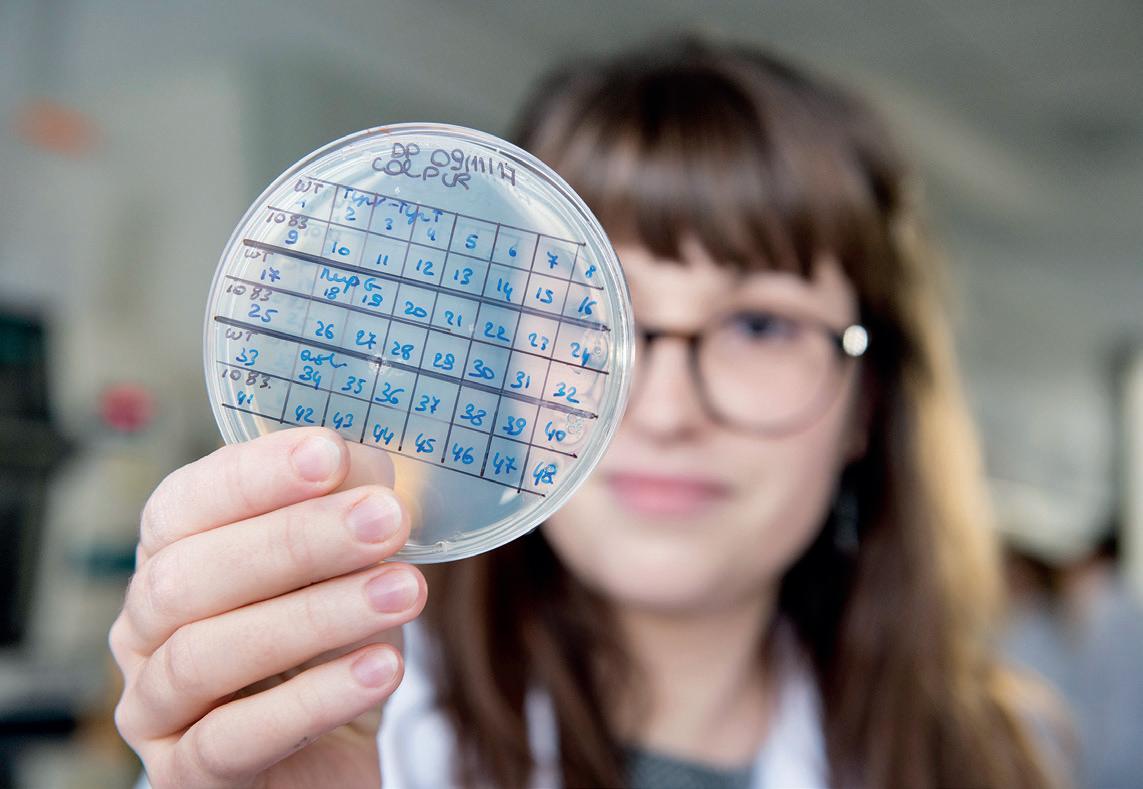

Belgian Research in Europe
R&D, Technology, Innovation
Editorial and Administration Rue













What is your assessment of the Horizon Europe programme?
Horizon Europe, the EU’s key funding programme for research and innovation, has made remarkable progress. We’ve received an impressive 58,000+ proposals in our calls, and we see a significant increase in both quality and success rates compared to its predecessor, Horizon 2020.There’s a growing participation from widening countries, which is heartening. Also, over a third of the beneficiaries in Horizon Europe are newcomers, primarily from the public and private sectors. Detailed performance figures will be presented in the forthcoming 2023 annual report. Furthermore, the interim eval uation slated for early 2025 will be a pivotal moment. It will allow us to comprehensively assess the programme’s first three years. However a clear conclusion is already emerging: we need
a strong budget in order to fund even more of the high-quality proposals that we receive.
Could you give us a few examples of disruptive research and innovation projects funded by the European Innovation Council?
The European Research Council is our launchpad for revolutionary technologies and innovation, as evidenced in the recently published EIC Tech Report1. This report, with a focus on early-stage projects funded after thorough independent expert review, offers insights into several cutting-edge areas:
• Green hydrogen production: portfolios of projects using electricity, solar energy and/or biomass as input sources;
• Quantum Computing: a range of approaches addressing stability and scalability of qubits, the smallest data storage units in quantum systems;
• Cancer Treatment and Biomarkers: efforts to clinically validate new biomarkers with potential to revolutionize cancer treatment.
I encourage readers to delve into this report to find out more about these exciting technologies funded under Horizon Europe.
What measures have you taken to harmonise research activities with the European Union’s economic priorities?
The interplay between research and innovation (R&I) and economic priorities is absolutely vital, especially in today’s world, characterized by disruptions and geopolitical tensions. R&I plays a critical role not only in driving economic recovery but also in accelerating the essential green transitions and enhancing the EU’s technological sovereignty.
The EU has made notable progress in further aligning research policies with its economic goals. Key achievements include:
1. Launching 49 European Partnerships with the private and public sector.
2. Making substantial advancements in the EU Missions, addressing major societal challenges.
3. Strengthening the EU’s position as a leader in market-creating innovations through the European Innovation Council.
4. Harnessing R&I’s potential for the sustainability transition through synergies with other programmes.
5. Improving the EU’s business environment and innovation capacity through the New European Innovation Agenda.
6. Connecting various actors, systems and regions within the European Research Area.
7. Increasing the uptake of research and innovation investments and reforms within National Recovery and Resilience Plans.
Furthermore, the longstanding cooperation between the European Commission and organizations such as the OECD, the European
Investment Bank and the World Bank on R&I aspects is instrumental in shaping a resilient and forward-thinking EU economy.
How is the European Commission supporting the creative industries as a driver of innovation?
The European Union offers a variety of funding instruments specifically tailored to support the cultural and creative sectors:
1. Horizon Europe’s “Culture, creativity and inclusive society”2 Cluster features calls focusing on cultural heritage and the cultural and creative industries. Several calls are currently open.
2. EIT Knowledge and Innovation Community (KIC) for Culture & Creativity under Horizon Europe, set to launch in January 2024, will offer new funding opportunities, for the cultural and creative arenas.
3. Creative Europe’s “Culture Moves Europe”3 Mobility Scheme is a boon for artists and cultural professionals. Currently, two calls are open.
4. Creative Innovation Labs call for cross-sectoral projects, to be launched soon, aims to bring together various cultural and audio-visual sectors through innovation and new technologies.
For those interested in exploring these opportunities further, the CulturEU web tool4 provides detailed information about EU funding available for the cultural and creative sectors.
Could you tell us about the European University Initiative? Which Belgian universities are involved?
The European Universities initiative5 represents a significant stride in fostering transnational collaboration among higher education institutions. As of now, the initiative boasts 50 European Universities, which collectively include over 430 higher education institutions spread across Europe. They collaborate closely with nearly 1,700 associated partners ranging from NGOs and enterprises to local or regional authorities. Belgium plays a prominent role in this initiative, with 15 of its higher education institutions participating as full partners. Examples include the Catholic University of Leuven, which is a member of the Una Europa alliance, and Université Libre de Bruxelles (ULB), which is part of the CIVIS alliance.
How do you view the participation of Belgian players in European research programmes?
Belgium’s commitment to research and innovation (R&I) is indeed noteworthy, as reflected in its recognition as a Leader Innovator in the European Innovation Scoreboard 20236. Not only does the country rank second in Europe in terms of R&I expenditure per inhabitant, but it also boasts an astounding 6,539 researchers per million inhabitants. Belgium ranks sixth both in terms of participation and budget (Net EU Contribution) share in the Horizon Europe programme. There are presently 486 grants in preparation, in addition to the 1,927 grants already signed. The success percentage of eligible Belgian applicants is 27.07% (EU-27 average of 22.71%), and Belgian participants have received EUR 1.8 billion so far.
Could you give us a few examples of projects financed by European funds and involving Belgian researchers?
The success of Belgium in Horizon Europe is illustrated by several remarkable projects, underscoring the country’s innovation and
research capabilities. Among the numerous successful ventures, a couple of standout examples are:
• Veoware7, who conducted an in-orbit demonstration of their Control Moment Gyroscope technology earlier this year, which improves the manoeuvrability of satellites, allowing faster operat ing times and better connection.
• Sunrise8, a revolutionising home sleep testing, to improve access to treatment for the 1 billion people worldwide who suffer from sleep apnoea.
These projects are just a glimpse into the breadth and depth of innovation that Horizon Europe funding is facilitating, particularly highlighting Belgium’s role in pushing the boundaries of technology and healthcare.
How can players in the fields of research, innovation and training be given more support to keep pace with the transitions that are underway?
Horizon Europe provides a range of opportunities for R&I actors to adapt to the dynamic global environment. Participation in the programme, including its parts such as the European Research Council (ERC) and the European Innovation Council (EIC), offers not just financial support but also invaluable opportunities for knowledge exchange and collaboration.
Marie Skłodowska-Curie Actions (MSCA) 9 are another part of Hori zon Europe. They work at the intersection of education, research and innovation, creating an ecosystem conducive to nurturing talent and facilitating transitions within the European Research Area (ERA)10
Beyond Horizon Europe, Erasmus+11, the EU flagship programme in education, or NextGenerationEU12, complement the EU’s comprehensive approach to fostering a resilient, innovative, and interconnected R&I landscape. I encourage everyone to explore the opportunities our programmes present.
(1) https://eic.ec.europa.eu/system/files/2023-10/EICTechReport-2023-DigitalVersion_0.pdf
(2) https://research-and-innovation.ec.europa.eu/funding/ funding-opportunities/funding-programmes-and-open-calls/ horizon-europe/cluster-2-culture-creativity-and-inclusive-society_en
(3) https://culture.ec.europa.eu/creative-europe/ creative-europe-culture-strand/culture-moves-europe
(4) https://culture.ec.europa.eu/funding/cultureu-funding-guide
(5) https://education.ec.europa.eu/education-levels/ higher-education/european-universities-initiative
(6) https://research-and-innovation.ec.europa.eu/statistics/ performance-indicators/european-innovation-scoreboard_en
(7) https://cordis.europa.eu/project/id/855443
(8) https://cordis.europa.eu/project/id/816336
(9) https://marie-sklodowska-curie-actions.ec.europa.eu/news/ msca-nobel-2023
(10) https://research-and-innovation.ec.europa.eu/strategy/ strategy-2020-2024/our-digital-future/european-research-area_en
(11) https://erasmus-plus.ec.europa.eu/
(12) https://next-generation-eu.europa.eu/index_en
An interview with Mr Thomas DERMINE, State Secretary for Economic Recovery and Strategic Investments, in charge of Science Policy, added to the Minister of the Economy and Employment
As BELSPO collects R&D statistics for the country as a whole, can you tell us how Belgium compares with its partners in terms of R&D intensity?
The latest figures validated by CFS/STAT (end October 2023) show an R&D intensity of 3.41% for 2022. This means that spending on research and development in 2022 represented 3.41% of our GDP. We don’t yet have the 2022 statistics for all the other countries, but we were top of the list of EU Member States in 2021. This is a truly remarkable performance, which we owe to the dynamism of our businesses, our universities and the efforts made by the public authorities, in particular to create a favourable environment (taxation, subsidies, infrastructure, etc.), a fertile ecosystem.
The parliamentary term is coming to an end. What is your assessment of your work as head of Federal Science Policy?
In terms of organisation, during this legislature we have put the Department back on track. We have co-created an ambitious Strategic Plan with all the components of the BELSPO, appointed a Chairman of the Executive Committee, appointed all the Directors-General to head the federal scientific establishments (except for three whose appointment procedure is in the process of being finalised), reorganised and reactivated the bodies of the Department’s business units, reorganised the Federal Science Policy Council, and so on.

In more operational terms, in collaboration with my colleague Mathieu Michel in charge of the Régie des Bâtiments, we have launched major projects to renovate and redeploy museums. I’m thinking of the Cinquantenaire site, and in particular the Art and History Museum, or the Royal Museums of Fine Arts.
We have also carried out an in-depth rethink of the research programmes managed by BELSPO in order to better respond to the needs of society and make life easier for researchers. Broadly speaking, and in addition to the possibility of creating centres of excellence, we have created a “science for policy” programme aimed at informing political decision-making based on scientific data, and a “science for science” programme aimed at supporting scientific excellence in our establishments and their partners, particularly universities.
A legislative mechanism has been created to enable the restitution of objects acquired illegitimately in the context of our colonial past. This system is original because it is holistic (all the objects held in our federal museums are potentially concerned; once a joint commission of experts has given its opinion on the conditions under w hich
an object was acquired, the govern ment can take the decision to transfer ownership of it to the country of origin, and then, possibly, and under conditions agreed with the partner country, proceed to the physical return of the object).
And what about the space sector, which accounts for around half of BELSPO’s budget?
In November 2022, the ESA Council met at ministerial level to decide on ESA’s activities and the subscriptions to its programmes by the Member States and associated countries for the period 2023-2027. This meeting confirmed the will to strengthen European leadership in space, to ensure the strategic autonomy of our continent and to accelerate the use of space to respond to major societal challenges.
The Belgian space envelope (ESA and nonESA) has been considerably increased. We have in fact increased our subscriptions for the period 2023-2027 by around €250 million compared with the previous period (ESA Council of 2019). This increase consists of several decisions, including co-financing by Defence of dual-use space activities to the tune of €100 million.


Belgium was thus able to maintain its rate of participation in ESA optional programmes (5.6%) and maintain its enviable position as 5th net contributor to the Agency.
During the Ministerial Council, the ESA DG also presented the new generation of European astronauts. Among the 5 career astronauts selected is Belgian Raphaël Liégeois, which is obviously excellent news for our country.
Any further increases in funding for research?
Yes, additional funding has been obtained for various research initiatives: calls for proposals in support of federal research infrastructures and polar research, participation in European initiatives, strengthening of “biodiversity” platforms. In addition, the creation of two new research and development laboratories focusing on the green hydrogen sector has been decided and funded, in collaboration with the Von Karman Institute (fluid dynamics).
You have also set up a Climate Centre...
Yes. I see climate change as the greatest challenge of my generation. We have created a ‘Climate’ Centre of Excellence within the Royal Meteorological Institute to bring together and coordinate the climate research of our federal scientific establishments and to strengthen their collaboration with other research centres and universities. The climate-related needs of the various economic and political players (adaptation measures, mitigation strategies, etc.) are also at the heart of this new centre’s mission.
The Belgian Presidency of the Council of the European Union is underway. What are your priorities in this context?
In view of growing international competition in the space domain, reinforcing the competitiveness of the European space ecosystem is at the heart of the Belgian Presidency.
In this regard, we are firmly committed to achieve substantial progress on the EU Space Law which will be presented by the Commission very soon. Council Conclusions on the mid-term review of the European Union’s space program will also be adopted.
Moreover, focusing on strengthening cyber-resilience of space and terrestrial systems and networks will also be a major priority of our presidency. In this context, BELSPO is organising a Workshop on Cyber Resilience in Space to be held on February 8. As the Presidency of the Council, Belgium takes this opportunity to highlight the collaboration between the European Union and ESA. This collaboration is key if we want to assert Europe’s position as a space power.

On May 23, a joint meeting of the EU and ESA ministers will take place on the premises of the Council of the European Union. This meeting is commonly referred to as the “Space Council” and aims to endorse a common text by the ESA and the European Union. This Space Council will mark the 20th anniversary of the framework agreement governing relations between the EU and ESA.
This joint meeting will bring to a close a series of meetings putting the spotlights on space. I will be chairing the Competitiveness Council (Space component) which will be followed by an ESA Council meeting chaired by Germany. Space raises a whole series of key issues for Europe and its strategic autonomy, and I want to bring these issues closer to the European citizens. In addition to the “space” focus, and in close collaboration with the Walloon Region, Chair of the Research component of the Competitiveness Council, we will focus on the adoption of Council Conclusions on the promotion of knowledge (1) and on the ex-post evaluation of Horizon 2020 (2).
Several scientific events will be organised to showcase research, development and innovation in Europe, such as the European Research Area Network (ERA-NET). Other important topics , such as climate (Equinox Summit in April 2024) or overlooked medical needs (Unmet Medical Needs Conference in June 2024), will also be addressed under the auspices of the Presidency.
How do you see the future of Federal Science Policy following the likely institutional negotiations?
BELSPO’s skills have their place at the federal level. We conserve collections that sometimes date back to the 13th, 14th and 15th centuries (the manuscripts from the Library of the Dukes of Burgundy, which are kept in the Royal Library), well before the birth of Belgium. It is a common heritage that belongs to all Belgians. How can we imagine transferring this treasure to the federated entities? As mentioned above, we also manage Belgium’s participation in the ESA. The Agency’s only interlocutors are its Member States, and I am convinced that it is the follow-through of successive federal governments and the agility of the Federal Government’s management of this competence that have enabled space to become a genuine Belgian success story. Another area is research programmes. Every entity in the world is developing a research capability to support its own competencies. Who else but the Federal Government could be asked to conduct research into issues such as public health or justice?
I am convinced that the Federal Science Policy (BELSPO) as it stands today is fully relevant. During this legislature, I have tried to consolidate it so that it can face the future with confidence. I will continue to defend it wherever I am.
‘Multidisciplinary’, ‘for monitoring and research’, ‘for science and technology’, ‘for sustainable use of the ocean’ and ‘for national and international use’ are core concepts justifying a national research vessel. By meeting all these conditions, the new RV Belgica enables Belgian scientists to punch above their weight in national and international marine research and monitoring.

After more than 1,000 scientific campaigns, over one million kilometers travelled and 37 years of service, the former RV A962 Belgica (1984-2021) needed replacement for Belgium to remain at the forefront of marine science, marine spatial planning, Blue Economy and the training of marine scientists. The new RV Belgica started her scientific activities on 27 January 2022. It was the culmination of a long process: feasibility and financial studies were carried out in 2005-2014, the Council of Ministers agreed on a new research vessel on 28 October 2016, the public tender for the construction was launched on 31 March 2017 and the contract was awarded to the Spanish Freire Shipyard (Vigo) on 16 March 2018. Construction started on 13 February 2019, with the keel laying on 27 March 2019 and first launch on 11 February 2020 being important milestones. On 25 June 2022, the new RV Belgica was baptized by godmother HRH Princess Elisabeth in the city of Ghent.
The new multidisciplinary RV Belgica guarantees Belgium’s compliance with national and international obligations and ensures the continuity of support to marine sciences. Scientific research as well as monitoring of the state of Belgian and surrounding marine waters are the main tasks. Monitoring activities include the national implementation of the EU Marine Strategy Framework Directive and the documentation of the ecological effects of human activities at sea (sustainable fishing, offshore generation and storage of renewable energy, sand and gravel extraction, …). In this way, knowledge necessary to support the Blue Economy is built up. The new RV Belgica is also active in the European EUROFLEETS+ network, allowing international scientists to obtain ship time on foreign vessels.
Compared to its predecessor, the new RV Belgica is larger (71.4 m compared to 50 m) and offers four times more laboratory space with the capacity to embark up to 24 scientists. The ship is equipped with state-of-the-art scientific equipment that allows samples to be taken to a depth of 5,000 m, is a silent ship (important for fisheries research) and has a light ice strengthening for research in Arctic areas during summer. Although the North Sea remains the focus, the research area extends further: northwards to above the Arctic Circle, further south including the Mediterranean and Black Seas, and westwards to the Atlantic Ocean. The vessel has an autonomy of 30 days and is intended to carry out research for up to 300 days at sea each year. The specifications enable the scientific community to focus on new challenges.
Deploying RV Belgica is only possible thanks to cooperation between different policy areas. The Belgian Science Policy Office (BELSPO) represents the Belgian State as the owner of the ship, the Institute of Natural Sciences (RBINS) manages the calendar, budget and scientific instrumentation, and the Belgian Navy component provides the bridge personnel and the home port of Zeebrugge. The exploita tion of RV Belgica also involves a private partner, the French operator Genavir that is responsible for the integrated management and operation.
Since the start of the scientific operations, many users have already conducted successful scientific campaigns with the new RV Belgica. Outside the Belgian part of the North Sea, the vessel has been active in Greenlandic, Icelandic, Irish, Scottish, English, German, Dutch, French, Spanish, Portuguese and Italian waters.
More information:
https://odnature.naturalsciences.be/belgica/en/;
https://www.belspo.be/belspo/NewRV/index_en.stm

On March 29, 2018, the Belgian Chamber of Representatives unanimously adopted the so-called “Métis Resolution” to shed light on the segregation experienced by the métis born during the Belgian colonisation in Congo, Rwanda and Burundi between 1885 and 1962. The approval of the Resolution, the result of a long struggle led by the métis and their relatives, is supported by various associations, researchers and parliamentary deputees and is closely followed by the media.
Additionally, the Métis Resolution contained several requests to the federal government, particularly regarding access to archives to reconstruct the history of colonial métis, including finding their birth names and identifying their biological parents. It specifically asked the government to conduct historical research into the role played by civil and ecclesiastical authorities in the treatment of the métis during the Belgian colonisation (art. 6) and to identify and correlate all personal files of the métis preserved in the archives in order to solve problems caused by name changes or misspellings (art. 7).
Concretely, the implementation of the Métis Resolution resulted in a two-part research project cofunded by the Belgian Federal Science Policy Office - BELSPO. The first part, that began in 2019, has two main objectives. First, it aims to create a database that helps reconstruct individual, familial, and collective trajectories of the colonial métis. This includes information on the métis themselves, their families, and the schools and religious institutions they attended. The database covers both colonial métis who were displaced to Belgium or other countries, and those who remained in Congo, Rwanda and Burundi. The second objective aims to catalogue the sources in order to provide access to relevant archives to métis who wish to reconstruct their trajectories and family history. By the end of summer 2023, more than 300 métis or their relatives had submitted a request to trace their origins.
The second part, which began in 2022, consists of an in-depth historical study on Belgian colonial policies towards métis and the segregation they experienced, as well as how métis and their families navigated through these policies. The study integrates different levels of analysis. On a transnational level, the historical study aims to present the ideological and international debates that shaped Belgian policies and practices. It also looks at the treatment of métis in other colonial societies to identify Belgian specificities. At a national scale, it identifies different colonial and metropolitan actors and networks involved in the segregation of métis. It also studies how these actors interpreted the laws and the consequences that these different interpretations had in the life of métis. At a local scale, the study focuses on the various trajectories of the métis and highlights particular and shared experiences. It also pays attention to the religious institutions and schools through which many métis passed.



To achieve the goals of both parts, the research project is based on a wide range of sources. This includes interviews conducted in Belgium and in research stay in Congo, Rwanda and Burundi. Written sources are also a crucial source of information. The research team proceeds with the identification and study of several thousand personal files of métis or colonial agents produced throughout the first half of the 20th century. Additionally, other public and private archive collections in Belgium and abroad are being examined, such as the archives of the Association pour la promotion/protection des mulâtres, of religious congregations, of the United Protestant Church of Belgium, etc.
To share the accumulated knowledge and assist those willing to navigate these complex documentary resources, a research manual was published in March 2023. This includes introductory elements related to the archival context, practical advice for reading records and introducing a search request, and summary tables of the main archive collections. In addition to the publication of the research manual, the redaction of scientific articles, the participation in conferences but also the intervention in media or the creation of a virtual exposition participate to the visibility of the research project among the largest possible and diverse audience.
Coud you remind us of NIHDI’s mission and key figures?
NIHDI plays a key role in the Belgian social security system. We manage the public and national pole of health care insurance and indemnity insurance related to temporary or long-term work incapacity due to a non-occupational disease or accident.
In 2024, the budget for health care insurance will be more than 42 billion and that for compensation insurance almost 15 billion, making these two insurance policies the second and third largest social protection items after pensions. This investment allows for the integration of useful innovations for the benefit of patients and companies.
By providing quality and accessible care, we reduce the risks of disability or mortality. For patients in the labor active age this means that we support them in going back to the labor force once dropped out. This supports our economic model and that itself feeds social security. A win-win situation between social protection and economic development, each supporting the other.
What international cooperation have you developed?
Collaboration and consultation are in our DNA and at the heart of our processes. It is therefore quite natural that they are also at the international level to share our experiences and developments in our sectors of activity. We have established numerous contacts with WHO-Europe, the OECD or the ISSA (International Social Security Association), and the European Commission. We have contacts with France, Luxembourg, the Netherlands, Germany, but also with countries in Africa (via CIPRES - Inter-African Conference on Social Security), Asia (Indonesia) or North America (Canada).
These collaborations concern, for example, the fight against benefit fraud and inappropriate care, the innovations in the field of medicines and biotechnologies (via Beneluxa or the International Horizon Scanning), the professional reintegration of people on disability (through our membership in the European IPS-learning community), the implementation of a health insurance system, the financial sustainability of our budgets, performance indicators or health objectives (Quintuple Aim).
What developments in terms of support for innovation and quality of care?
We try to integrate R&D in the pharmaceutical and biotechnology sector as early as possible. We want to support early on innovations with high added value in terms of patient

benefit: either a more effective treatment in terms of health, or a more affordable treatment for the same result. Innova tion is increasingly costly for the patient, the healthcare system and the companies that implement it. We must therefore be increasingly selective in our choices in order to mobilise resources with a real return for health and its financing, but also to detect appropriate innovations at source and indicate to firms and research centres our interest in their work without wasting energy and unnecessary investment. Our multi-annual budget pathway allowed us to redirect our budget margins towards appropriate care and real patient value.
How will NIHDI be involved in the Belgian Presidency of the Council of the European Union from 1 January to 30 June 2024?
The Belgian Presidency will take place at the end of the 2019-2024 European legislative cycle. This is however an opportunity for Belgium to make proposals regarding some of the implementing instruments available to the EU to encourage its action in the field of health.
In this respect, NIHDI along with several organisations and the academic sector, participates in six working groups that aim to make proposals and organize debates within the Health and Social Security sectors: “Health Professionals”, “Unmet Needs”, “Towards an Inclusive Digital Health System in Europe”, “Antibiotic Resistance”, “Access” and “Mental Health and Work”. These works will help Belgium to formulate recommendations to the Council. This involvement of NIHDI in the preparation of the Belgium Presidency of the Council is also an opportunity for NIHDI to strengthen and enlarge its existing national and international network.

How does the FAMHP, as regulatory agency, facilitate research and development in Belgium?
Recently designated as CEO of the FAMHP, I can confirm that making innovative therapies available to patients in a safe but timely manner, remains a major objective of our agency. That is why we have multiple measures to facilitate research and development such as offering an attractive environment for clinical trials by maintaining short timelines for mononational phase I trials and taking a leading role in part of the multinational clinical trial procedures. We aim to keep in direct contact with the stakeholders and informing them when needed.
Another important element is that before the submission of a clinical trial procedure, all sponsors can request scientific and technical/ regulatory advice for medicinal products including drug-device combination products through our National Innovation Office and Scientific Technical Advice Unit. Active patient engagement is foreseen in specific cases. The FAMHP is also actively involved in the simultaneous national scientific advice pilot procedures which offer joint scientific and regulatory advice from different authorities at an early stage of development and at the same time, optimising the quality and consistency of the advice. In this context, our agency has been handling 23% of those requests in Europe as lead national competent authority and 29% as participating authority. Via active participation in the European innovation network and in EU funded projects initiatives, we specifically offer support for small and medium enterprises and academia.
To ensure that the patient has further access to the medicines once clinical trials have ended and the marketing authorisation and commercialisation are awaited, we also have the possibility for compassionate use programs for groups of patients with a chronically, seriously debilitating or life-threatening disease, who cannot be treated satisfactorily by an authorised and reimbursed medicinal product.
In order to facilitate R&D for human body material (blood, tissues and cells) we have a service that coordinates the exchange of information between the relevant services of the FAMHP. It also forms a bridge to advanced therapy medicinal products (ATMPs) or stable derivatives of blood and plasma. And more strategically, it is important to note that we are actively involved in the Bioplatform, a demand of the Belgian government with the goal of making Belgium an even more attractive biopharmaceutical hub.
What are the main challenges for the FAMHP in its role as facilitator of R&D?
Since 2021 many challenging European regulations went into force such as the Clinical Trial Regulation, the Medical Device regulation, the In Vitro Diagnostic Regulation, and the New Veterinary Regulation. The implementation of these required major updates of processes and procedures. Simultaneously new EU por tals (Clinical Trial Information System, Eudamed) and EU databases (Union Product Database) are in development or were released. We give our feedback during the development process of these portals and once final, we need to embed the work in the new regulations in our processes and foresee the required additional capacity and collaborations with external partners such as ethics committees. With regard to the general review of the pharmaceutical legislation that is in progress, we support the focus on need-driven developments in the area of important unmet medical needs. As you know the life scientific and healthcare climate is quickly evolving and the FAMHP needs to keep its expertise up to date within several domains such as digitalisation (use of real-world data), ATMPs, complex clinical trials and drug/device combination products. Assuring timely and safe access for the patient to important innovative medicines or devices remains the main drive for the FAMHP.
This is all the more important since we are faced with three major challenges: the shortages of medicines, the need to have devices, including IVDs, on the market in spite of a new, longer, certification process, and antimicrobial resistance, which compels us to have as many antibiotics available as possible to use as little as possible.
How does the FAMHP position itself in a European context?
The FAMHP is a strong partner within the European Medicines Regulatory Network and collaborates very actively with the European Commission, the European Medicines Agency, the Heads of Medicines Agencies, the Medical Devices Coordination Group and follows the new evolutions very closely (Accelerated Clinical trials in Europe, CT Cure and Safe CT, Big Data, shortages, antimicrobial resistance…).
The FAMHP has selected two particular fields of excellence: vaccines and In Vitro Diagnostics. This is essential in view of the strategic orientation of the agency in a rapid and highly changing environment in order to serve our patients for the best, but of course also in view of the preparation of the European presidency during the first Semester of 2024.
 By Prof. Pascal VERDONCK, Member of the
By Prof. Pascal VERDONCK, Member of the
Royal Flemish Academy of Belgium for Sciences and Arts and board member of the Belgian & European Association of Hospital Managers, And Prof. Alain KALMAR, Anesthesiologist at St Jan hospital, Bruges and visiting professor Ghent University
Hospitals, especially operating theatres, produce a substantial amount of waste and greenhouse gas emissions. Beyond consumables and volatile anesthetics, the majority of emissions from operating theatres stem from electricity consumption, which is gradually improving due to the greening of electricity production, irrespective of hospitals’ actions. Consequently, the primary responsibility increasingly lies with disposables and waste gases. Notably, volatile anesthetics, which are nitrous oxide (N2O) and fluorinated hydrocarbons, possess an exceptionally high global-warming potential. To mitigate the environmental impact of operating theatres, it is imperative to focus on the most significant sources of pollution.
While ESG Environment, Social (people and society) and Governance is increasingly dominating the boardroom agenda of hospitals it remains art to distinguish between popular measures and, on the other hand, drastic and relevant changes. Healthcare still has a lot to gain in terms of CO2 savings. Most of the CO2 (38%) comes from the energy use of hospital buildings. Travel by both employees and patients (22%) and medicines (18%) are also an important source of CO2 according to Gupta Strategists. In the operating rooms the most energy is used to refresh the air. In surgical procedures, the substantial volumes of disposable materials are immediately noticeable. These materials are incinerated and converted into CO2. Anesthetic gases easily go unnoticed, yet a life cycle analysis reveals that their climate impact frequently surpasses that of all solid materials consumed during surgery, both from production and incineration. While the industry is developing technologies to capture or destroy anesthetic gases, their effectiveness, with less than 50% emission reduction, remains largely unproven. Therefore, top priority should be reducing primary anesthetic gas usage.
A simple illustration provides an idea of the magnitude. The production and incineration of all waste from an appendectomy emits around 1020 kg of CO2. A life cycle assessment over a 20-year time horizon reveals that one hour of intravenous anesthesia causes less than 1 kg of CO2. Sevoflurane anesthesia in modern equipment emits 15 kg, while desflurane in older equipment easily generates 1300 kg of CO2 equivalents. Adding N2O contributes an extra 180 kg. Neglecting to prioritize anesthesia policy during greening efforts, clearly overlooks the ‘elephant in the operating room’.
References
1 “Gezondheidszorg kan fors bijdragen aan CO2-reductie”; Consultancy.nl 2019

Three simple steps can dramatically reduce total theatre pollution: stop central N2O distribution, phase out highly polluting anesthetics, and use routinely available technology to cut unnecessary waste of volatile anesthetics. The most striking example is N2O, still available in many hospitals through central piping. Substantial leaks (often > 90% of total consumption) occur in these circuits, and the anesthesia machines themselves. These leaks alone represent in hospitals where it has been studied, much more than 1 million kg of CO2 equivalents per hospital per year, and often exceeds the emissions from incinerating all surgical waste. Both Belgian and European anesthesiology associations recommend discontinuing central distribution of N2O. Two types of fluorinated anesthetic gases - desflurane and sevoflurane - are routinely used. Desflurane, which is 50 times more polluting for the same level of anesthesia, will be prohibited in Europe from January 1, 2026, with exemptions for cases deemed ‘strictly required’. Many European hospitals, including universities, have phased out desflurane, but some persist despite no clear benefits. Adopting advanced anesthesia workstations cuts emissions by 20%-80%, recouping investment by minimizing gas waste.
Even with the ‘least polluting’ anesthetic gas, emissions can surpass one million kg of CO2 per hospital annually. Thus, these reductions, alongside N2O mitigation, each often outperform any other feasible interventions in the operating room. The most direct way to reduce anesthetic gas pollution is to replace them with total intravenous anesthesia (TIVA) when feasible. TIVA has minimal environmental impact and provides additional medical benefits. The main challenge is training anesthesiologists to match their current expertise with vola tile anesthetics.
First things first. Eliminating this anesthetic gas pollution source requires minimal financial investment and even quickly generates a significant financial return, while often reducing emissions to less than 1% of common practices. Eliminating central N2O distribution and leaks saves hospitals tens of thousands of euros annually, and intravenous anesthesia is notably more cost-efficient than volatile anesthetics. Educating anesthesiologists in eco-friendly practices and ensuring easy access to essential equipment are crucial.
2 The Glasgow declaration on sustainability in Anaesthesiology and Intensive Care, Eur J Anaesthesiol 2023; 40:461–464
3 BeSARPP (Belgian Society of Anesthesiology, Resuscitation, Perioperative medicine and Pain management) recommendations on responsible and sustainable use of inhaled anesthetics; Acta Anaesthesiologica Belgica 2023

What are essencia’s key figures and missions?
The chemicals, plastics and life sciences sector is a very important industrial sector in Belgium. In 2022 it represented 99,300 direct jobs, 230,000 indirect jobs, 87.9 billion € turnover, and 36.1 billion € in trade surplus. In addition, the chemicals and life sciences sector remains the undisputed leader in innovation. The amount spent on research and development (R&D) in Belgian chemicals, plastics and pharmaceuticals more than doubled in the last decade to 5.8 billion € in 2022, a new record. The sector accounts for two thirds of all industrial expenditure on R&D in Belgium, mainly due to the high R&D intensity of life sciences companies active in pharmaceuticals and novel biotechnologies.
Innovation is undoubtedly a key element in ensuring the sustainable anchoring of the sector in Belgium. No wonder that essenscia’s mission is to ensure a stimulating framework for companies to keep innovating for a more sustainable future. Our world is facing important challenges in the use of energy, the protection of natural resources, and the provision of food, water and health for its growing population. Chemistry and life sciences are essential to making the world’s development sustainable. Its innovative research is crucial to the development of new products, applications and services. The chemistry innovation agenda is broadly structured around a so-called double twin transition: the industry has to become climate neutral and circular, transition to more safe and sustainable products, and simultaneously digitize its (production) processes at a rapid pace. The capture and storage or utilization of CO2, the development of a hydrogen economy, the electrification of production processes, the use of bio-based raw materials or the chemical recycling of plastic waste: all these technologies have the potential to contribute to a more sustainable economy and society.
In life sciences, the aim is to accelerate the development of new medicines and vaccines, using pioneering technologies such as messenger RNA, plasmid DNA, genome editing, biosensors, cell and gene therapy and the use of monoclonal and polyclonal antibodies. This should lead to more targeted treatments and personalised medicine tailored to the patient.
What services do you offer your members in terms of information, training and advice?
In the field of information, we offer discussions in working groups on strategic priorities as well as information sessions on hot topics. As regards formation, let us mention VLARIP (Vlaanderen REACH Implementation Project in Flanders) and WALRIP (Wallonie REACH Implementation Project in the Walloon region) for REACH and CLP, along with annual seminars on product policy, crisis communication and social themes. With the Process Safety Academy and the Security Club we provide several in depth training sessions on process safety. The essenscia Patent Cell offers free advice and information on intellectual property management, including technology trend watching. essenscia also offers tailored advice, expertise and advocacy on new legislation and strategic priorities.
Could you present essenscia’s activities in terms of innovation and patents?
Innovation is at the core of our federation and numerous initiatives have been launched: the essenscia Patent Cell, the Innovation Award (the most prestigious award in Belgium for industrial innovation, with the 5th edition held in 2022 and the Innovation Fund (39 investments in promising companies).What is more, essenscia has engaged in innovation clusters in Flanders (Catalisti) and Wallonia (GreenWin, BioWin). essenscia is also the main shareholder in BlueChem, the first incubator for sustainable chemistry in the Benelux that has opened its doors in 2020. And let us not forget that our federation was the driving force behind the foundation of the National Fund for Scientific Research in the 1920s. A decade characterized by an innovative alliance between science and industry, which resulted in the famous Solvay Conferences and world conferences on chemistry in Belgium.
Could you give us some examples of new products, applications or services developed by the chemical, plastics and life sciences industries to address major global challenges?
Let me first mention that the chemicals, plastics and life sciences sector is a solution-provider to tackle climate change. In that prospect, it is designing insulation materials for energy efficient construction and household appliances, lightweight materials for sustainable transport, components for renewable energy and electric car batteries. It is also striving to turn CO2 into a valuable resource, to integrate plastics in a circular economy and to boost the industrial application of hydrogen. On the other hand, Belgium has become an internationally renowned ‘health and biotech valley’. Our country hosts some of the largest vaccine production sites in the world. At the same time, we can count on a high concentration of pharmaceutical and biotech companies that are working on - and already have come up with - breakthrough medicines, therapies and production processes that can help patients worldwide.

pharma.be, the umbrella organisation for some 130 innovative pharmaceutical companies operating in Belgium, published its Pharma Figures 2022 on 30 June 2023, an annual overview of the sector’s economic footprint. The figures show once again that the biopharmaceutical sector remains in full development. However, this is no guarantee for the future.
Competition with other countries is fierce, Europe needs to take steps to strengthen its position internationally, and the search for talent remains a challenge. The threat of introducing restrictions that make it more difficult for patients to access new therapies persists at national level.
Some key figures for 2022:
- In 2022, 43,501 people were directly employed in biopharmaceutical companies in Belgium. This represents an increase of 18.8% over the last five years. The sector’s impact on employment in our country goes even further: for every job in the Belgian biopharmaceutical sector, two other jobs are created in the Belgian economy.

- Investment in research and development (R&D) amounts to more than €15 million a day, for a total of €5.7 billion, up 14.7% on last year. The number of researchers working in the sector has risen by 25.5% over the last five years.
- For the first time, total exports of medicines and vaccines exceeded €100 billion, representing 17% of total Belgian exports. Every day, the Belgian sector exports €275 million.
- Finally, the biopharmaceutical industry is one of the few sectors to generate a significant trade surplus (€19.4 billion) by exporting medicines and vaccines.


“Although the figures for 2022 show that the Belgian pharmaceutical sector is strong, this is no guarantee for the future. Our sector remains one of the most dynamic in the Belgian economy, but the environment remains fragile. The Belgian Pharma Valley is facing serious competition from other countries that are strongly supporting their own biopharmaceutical sector.
What’s more, we are seeing a worrying trend: more and more R&D activities in the pharmaceutical industry are leaving Europe for the United States or Asia. 25 years ago, around half of all new medicines came from Europe. Today, only a fifth remains. To halt this trend, Europe - and certainly Belgium - needs to take urgent action.
For pharma.be and its members, health is essential. Our mission is to transform knowledge into solutions and bring them to market so that patients can benefit from them. Although Belgian companies invest heavily in the research and development of innovative medicines, all too often these drugs are not available quickly enough for patients in our country.
This is a structural problem that places our country in the European average, far behind neighbouring countries where patients have obtained reimbursement for these innovations. An important detail in this respect is the fact that spending on drugs has increased much more slowly than other spending in the NIHDI INAMI-RIZIV health budget over the last decade.
The latest figures for the pharmaceutical industry demonstrate the importance of this sector for our country. We need to maintain this engine of growth, employment and innovation, because patients and society as a whole will benefit from it.”
Caroline Ven, CEO pharma.beFounded by Agoria and managed by the technology industry itself, Sirris has always put the interests of Belgian companies first. In short, we support them to make technology happen – resulting in about 1,300 innovation projects a year. But in recent times, the world has changed fundamentally, forcing us to step up our game. The result: a renewed brand identity, with lots of assets to better support companies with an appetite for technological innovation.

“Resource scarcity, climate change, the energy crisis, disrupted supply chains, hybrid working, evolving consumer behaviour… business challenges pop up all around”, says Herman Derache, Managing Director at Sirris. “Blink your eyes twice and the world has changed as many times, so to speak. Within this context, it’s becoming increasingly hard for companies to stand out from the crowd, to stay one step ahead. Even more so if they have to do it on their own. That’s why more than ever, Sirris acts as a hands-on companion for technological innovation – the ideal way to differentiate a company and achieve sustainable growth.”

“Technological innovation is a risky and resource-intensive business”, clarifies Jeroen Deleu, Director Strategy and Corporate Development at Sirris. “In times when risks and resources are very delicate topics, we want to provide peace of mind. That’s why we grant extensive support to companies that reach out to us. To illustrate, we give them direct access to over 150 multidisciplinary experts and 200 partners, open up our 8 industrial labs, and share tons of specialised inspiration.”
“Meanwhile, we’ve set up an industrial community with Agoria – the federation of the Belgian technological industry – to better align our services. By doing so, we aim to ensure Belgian technological companies, who represent 320,000 employees together, are fully equipped to realise their innovation ambitions.”
Accessible, inspirational, audacious, dedicated, accurate… these are just some of the core values that form the heart of Sirris’ renewed identity. They weren’t chosen at random. Instead, they are the result of an in-depth strategic exercise. Herman Derache: “We had thorough
conversations with companies, key clients, government bodies, partners, Agoria staff members and, of course, Sirris colleagues too. We’re all in this together. And we’re convinced that, based on their feedback, we’ve chosen the right course.”
The adjusted course is reflected in a few key communication initiatives:
• A clear-cut website so interested companies can quickly find their way to relevant areas of expertise, industrial labs, partners, and Sirris experts.
• An industry-leading content platform to share insights and inspiration about the technology that will shape business in the next couple of years.
• A refreshing visual style to highlight our dynamic mindset and to align our designs with the type of organisation we’ve become.
Enjoy browsing our website, gathering ideas on our content platform, and feasting on some eye candy with our new designs.
https://www.sirris.be/en


Stay on the cutting edge of innovation thanks to SynHERA, the network of researchers in the Universities of Applied Sciences
Providing scientific answers adapted to the many challenges facing our society: this is the challenge facing hundreds of researchers from the Universities of Applied Sciences and associated Research Centres of the Wallonia-Brussels Federation. Scientists with specialised expertise who can count on the SynHERA structure to support them and promote their projects in the socio-economic world.
Faced with a constantly evolving society, enriching our knowledge is more essential than ever.
To do this, it is necessary to support applied research and its many actors. In the Wallonia-Brussels Federation, hundreds of researchers are working on concrete projects that will enable us to meet the needs of our society today and tomorrow. In order to develop their discoveries in the best possible way, these scientists need human and financial levers, be they regional, federal or international. The European Union has created various research funding programmes, each of which addresses societal challenges from a specific angle. For example, the Horizon Europe programme considers the issues in a global manner, while the economic development fund and partnerships take account of regional or cross-border specificities (Interreg). As for innovation support programmes, they focus on the needs of the economic fabric and of companies in particular (EIC, Eurostars, etc.). In addition, researchers as individuals are supported by mobility programmes that allow them to strengthen their network (COST) or to acquire new skills (MSCA).

In order to give themselves the best chance of being selected in the framework of one of these calls, these researchers can rely on SynHERA, the research support and development network of the 19 Universities of Applied Sciences and the 10 associated Research Centres of the Wallonia-Brussels Federation. Composed of a team experienced in monitoring and setting up innovation projects, this network collaborates with hundreds of researchers with diverse and varied profiles. While for some people the term “research” still evokes the image of a microscope and a scientist in a white coat, the reality is quite different. Applied research is, in fact, multidisciplinary research with projects in agronomy, paramedical and technical fields as well as in the human and social sciences. Indeed, while the so-called technical sciences have been the focus of attention for many years, the human and social sciences have profoundly enriched the field of action of research by taking an interest in other issues such as those related to education, immigration, territorial fractures, the economy, sustainable development and innovative management.

Enriching this knowledge is good, enhancing it is better!
But if providing new knowledge is essential, the other step is to share this knowledge. This is why SynHERA participates in numerous events, such as world-renowned trade fairs, in order to bring real visibility to this applied research. With a team at the heart of the research ecosystem, SynHERA also enables these researchers to share their knowledge with other scientists from all over the world. Valuable collaborations that allow each of them to deepen and enhance their knowledge. And here again, SynHERA plays a key role! As a true interface between the academic world, the socio-economic world and funding bodies, this network allows companies, associations, etc. to collaborate with the members of its network. This is an opportunity for them to access scientific expertise directly related to their field, to collaborate with researchers with specialised knowledge and to develop new and increasingly innovative projects!
More info:
https://www.synhera.be/en_GB/?fw=1


Missions ensure that Belgian companies receive the greatest cross-border prospects with the least amount of
Could you share details about the economic missions that were scheduled in 2023?
In response to the question about the economic missions planned for 2023, let’s delve into the noteworthy Belgian Economic Mission that took place in Senegal from May 21st to May 25th, led by HRH Princess Astrid. This mission held special significance due to its rescheduling from 2020, a delay attributed to the global COVID-19 pandemic.
The delegation, comprising approximately 360 members, was a diverse mix of over 150 companies spanning various sectors, as well as representatives from academic institutions and several political leaders. During their visit, the official delegation had the privilege of meeting with key figures in Senegal, including HE President Macky Sall and HE Prime Minister Amadou Ba. The mission itinerary included business visits to Belgian companies operating in the region and a distinct focus on promoting female entrepreneurship.

Recognizing the paramount importance of the medical sector, the economic mission sought to foster collaboration in the development and distribution of medical equipment and devices. This cooperation is instrumental in enhancing healthcare accessibility and quality. Another critical area of emphasis is renewable energy. In light of the pressing global need for sustainable energy sources, the mission placed special emphasis on cooperation in this field. By pooling our resources and expertise, we can work towards a greener future while ensuring energy security. Furthermore, we encourage cooperation and knowledge exchange in the field of life sciences. This commitment is aimed at advancing healthcare solutions and contributing to innovative medical breakthroughs that benefit both our nations and the global community. This diverse range of sectors underscored the mission’s goal of strengthening economic ties between Belgium and Australia, promoting innovation, and fostering mutually beneficial partnerships.
What’s in store for Belgian Economic Missions in 2024?
One notable aspect is Senegal’s growing importance as a trading partner for Belgium and the European Union. In 2022, the EU-27 exported goods to Senegal were worth approximately 4.7 billion EUR, with Belgium accounting for a substantial 23.8% share, solidifying its position as the leading EU exporter to Senegal. Belgium’s interest in the Senegalese market is also reflected in its Exporters’ Database, which comprises 1,040 Belgian enterprises actively exporting to Senegal and an additional 2,140 businesses expressing interest in this market. One of the highlights of the mission was the signing ceremony of 38 economic and academic agreements.
Ambassador Hubert Roisin also seized the opportunity during the economic mission to underscore the significance of the pharmaceutical sector and the collaborative efforts between Senegal and Belgium in this field, emphasizing its importance for biopharmaceutical and biotech industries.
The second Belgian Economic Mission of 2023 took place from October 19th to October 28th spanning the vibrant cities of Sydney and Melbourne in Australia. This mission held particular importance as it marked the second of its kind since the last mission in 2012, which saw the participation of 185 delegates. This time, Belgium sent a 315-strong delegation to Australia. For this mission, a strategic focus was set on several key sectors that promise substantial opportunities for collaboration and trade between Belgium and Australia.
In 2024, the Belgian Economic Mission is set to embark on two significant journeys. From June 16th to 19th, a mission will head to Norway, and later in November, from the 22nd to 29th, a second mission will make its way to Brazil, both under the distinguished leadership of H.R.H. Princess Astrid, Representative of His Majesty the King.

The LiEU Network, the knowledge transfer offices (KTO) from the universities in the Wallonia-Brussels Federation, celebrated its 20th anniversary in late 2023. An opportunity to look back on two decades dedicated to research valorization and support for the economy and innovation.

Two decades ago, the landscape of knowledge transfer between universities and companies was quite different. At that time, the LiEU Network (for Liaison Enterprises-Universités) was established by the Council of Rectors of the universities in the Wallonia-Brussels Federation (CRef), with the support of the Walloon Region. The initial objective was clear: creating socio-economic impact in Wallonia by fostering the connection between universities and businesses.
Eric Wyart, Operational Director of the LiEU Network, emphasizes, “The LiEU Network is more than ever the unique interlocutor and showcase of university research to the socio-economic stakeholders in Wallonia. After 20 years of existence, we now have referents advisors who are directly related to Walloon strategic axes in terms of innovation domains, clusters and thematics networks.”
Two decades ago, only a few “TTO” structures, which stands for Technology Transfer Offices, existed. The need for integration into the socio-economic fabric was already evident: the desire to build connections with companies was present, as was the need to valorize the results of certain university research by, for instance, creating spin-off companies.
Nathalie Burteau, President of the LiEU Network, specifies, “These were often small structures, consisting of two or three people and created at the initiative of universities within the framework of
Research Administrations. They were relatively unknown to researchers and not very visible within the socio-economic fabric. These nascent TTOs were somewhat isolated, and the term ‘network’ had not yet been coined. However, in 1997, Research Administrations began to collaborate, particularly within the framework of the regional law granting intellectual property rights for results from Walloon projects to universities and the establishment of a fund for patents supported by the region, followed shortly by the creation of ‘First Spin-off’ funding. In 2003, the LiEU Network was born as a working group of the CRef.”
In 2008, the LiEU Network secured its first ESF (European Social Fund) project, the “ Mise en Réseau de la Valorisation – MIRVAL “ project. This project led to the structuring of the network and the professionalization of a field for which no specific training existed at the time.
At the heart of this adventure was the partnership charter that established the LiEU Network. The CRef stated, “Universities have the triple mission of conducting research, transmitting knowledge, and engaging with society. Through their research activities, universities contribute to the development of knowledge and have the concern of making this knowledge accessible to society at large, and especially to businesses, thereby allowing them to maintain a competitive position in the economic arena.”
Moreover, it is on this ambition that a Network was built, which now positively impacts the development of its region based on the results of university research, by combining expertise, a spirit of collaboration, and active cooperation within its ecosystem.

“LiEU Network promotes the connection of research with socio-economic stakeholders and assists researchers in maximizing the impact of their results,” notes Eric Wyart. “The LiEU Network offers a wide range of services, including a dedicated intellectual property service through the PATLIB unit, support and facilitation tools, as well as training and awareness-raising initiatives for researchers on intellectual property and valorization. Today, LiEU Network is more than ever the bridge between university research, the industrial world, and civil society, both within the Walloon ecosystem and in relation to foreign partners.”
The LiEU Network relies on a multidisciplinary team, bringing together experts in valorization, business developers, communication specialists, data managers, legal experts, patent managers, investment funds, and more. These teams are supported by a combination of regional, academic, and private funding.
Over the years, the LiEU Network has established robust governance and a structured mode of operation, with management bodies, steering committees, and a system of coordinators. “This organization allows us to provide coordinated responses to our external partners while promoting close collaboration between each KTO and the researchers of their institution,” adds Nathalie Burteau. “A significant development acquired over these 20 years is the mutual trust that has developed among the members of the KTOs from different universities, putting competition aside.”
In 20 years, the ecosystem of actors supporting innovation has evolved. The LiEU Network has consistently found its place as a value creator. A recent example is that since the beginning of 2023, a portion of the network’s activities has been integrated into the Wallonie Entreprendre program aimed at creating more value in Wallonia. The 20 years of the LiEU Network mark a period of success and growth, as well as a new phase of exciting challenges. Collaboration, agility, continuous education, and a commitment to societal impact will be the keys to success in an ever-evolving landscape.
>>> For more information on the LiEU Network, visit: https://reseaulieu.be

Every year, the LiEU Network achieves...
• 40 patents filed
• 1,100 research proposals submitted within the framework of Walloon calls
• 10 spin-offs created
• 140 licenses concluded for the benefit of companies and other organizations.

The LiEU Network brings together the Knowledge Transfer Offices (KTOs), also known as ‘Interface Service’ or ‘Valorization Service,’ of the 5 French-speaking universities:
• Université catholique de Louvain: https://uclouvain.be/ fr/chercher/innover-et-entreprendre-ti.html
• Université libre de Bruxelles: https://www.ulb.be/fr/la-recherche/innovation-services-aux-entreprises
• Université de Liège: https://www.recherche.uliege.be/ cms/c_9006501/fr/recherche-innovation
• Université de Mons: https://web.umons.ac.be/fr/nos-missions/recherche/
• Université de Namur: https://www.unamur.be/recherche







What are Belnet’s key services?
For the last 30 years, Belnet has been offering its services to universities, colleges and research centres in Belgium. Our infrastructure is available to federal scientific institutions, public or private specialised research centres of all sizes. In addition to our network, which allows researchers and students to share large amounts of data securely, we offer a range of services to help them carry out their projects. These include eduroam, which allows students and academic researchers to connect to the wifi networks of other participating organisations across Europe without having to request specific access, but also DMPonline.be, which allows researchers to generate and manage their data management plans, and the Belnet Storage service, which offers secure, bespoke cloud hosting for storing research data and other data. In addition, in recent years we have also expanded our service offering in the area of cyber security. This year, for example, we have launched a completely new anti-DDoS solution.

What is Belnet’s role as the Belgian organization mandated by EOSC (European Open Science Cloud)?
This broad programme aims to give the European Union a global role in research data management and to ensure that European scientists enjoy all the benefits of data-driven science. In 2020, Belnet was appointed as the mandated organisation (MO) for Belgium within the Association, which concretises and deepens its commitment to Open Science by ensuring that it benefits the institutions connected to its network. EOSC Focus supports the EOSC Association in its mission to make Open Science the new standard and to achieve the objectives described in the collaboration agreement between the European Union and the EOSC Association. Within the EOSC Focus project, Belnet collaborates with eight other European members and contributes to increasing the availability, accessibility and re-use of data for the transformation of scientific results into concrete innovations for the benefit of the public. Belnet is best placed to inform Belgian institutions about European developments within EOSC and to guide them in their digital transition to Open Science. Belnet can, together with its R&E community, leave its mark on the developments within EOSC and optimise its service offering.
Could you tell us about the BeQCI project, which aims to deploy a quantum communications network in Belgium?
In early 2023, Belnet began collaborating on the deployment of a Quantum Key Distribution network in Belgium. The BeQCI project brings together partners from R&E and industry to implement and test this promising technology. The infrastructure we are putting in place is a combination of optical fiber links and the quantum devices that will be connected to them. What makes the infrastructure different are the Quantum Key Distribution (QKD) boxes, machines that use the effects
of quantum physics to generate a stream of random data at both ends of the optical fiber, which we know with certainty has not been read by a third party along the way. This guarantees that this way of exchanging cryptographic keys is perfectly secure, and always will be. Phase 1 (implementation of the boxes) is scheduled for January 2024 in Ghent, Brussels and Redu, and phase 2 for May 2024 on the basis of the new use cases received.
What are Belnet’s upcoming projects?
As part of our new 2025-2029 strategy under development, we will be even more attentive to the specific needs of the various user communities, and will keep innovation at the heart of our activity. Beyond the connectivity layer, our basic foundation, we will propose a scalable offering with our Cloud services in our own data centers, next to the cloud solutions portfolio OCRE (Open Cloud for Research & Education), as well as our Trust & Security services for connectivity and data protection. We will also adapt and let evolve our AAI (Authentication and Authorization Infrastructure) services and are evaluating the possible roll-out of SOC (security operation center) services. In terms of open science for federal scientific institutions, we will be implementing tools covering the entire lifecycle of research data (FedEOSC project). So many exciting projects!

Belnet
WTC III
Boulevard Simon Bolivar 30 B 2
1000 Bruxelles
Tel.: +32 (0)2 790 33 33
E-mail: info@belnet.be
https: //www.belnet.be

Belgium remains in the leading group of ‘innovation leaders’ within the European Union in 2023. It holds fifth place there, preceded only by Sweden, Finland, Denmark and the Netherlands. This is according to the European Innovation Scoreboard 2023. As Flemish Minister for Innovation, how do you respond to this?
It is clear that years of joint efforts by knowledge institutions, companies and governments are paying off. Also, the Flanders Region is an innovation leader, we rank 23 on 239 regions in Europe in the Regional Innovation Scoreboard 2023. It is the result of the investments we have made in research and development in recent years. In 2021, Flemish companies, knowledge institutions and the government together invested 10.8 billion euros in res earch and development. That is 3.65 % of the gross domestic product. As a result, we jumped over Sweden and became the absolute number one in Europe in terms of Gross Expenditures on R&D (GERD).
Can you highlight some investments?
It is difficult to choose, but characteristic of the investments we have made in recent years is that we have resolutely chosen sustainability. For instance, the transition to a circular and sustainable economy is one of the spearheads of our policy.
Similarly, hydrogen will become important in the coming years, to further make industry and heavy transport more sustainable. With the strategic location of our ports and the expertise of our companies, research and educational institutions, we have all the assets to become the hydrogen hub of Western Europe. This is an opportunity we cannot afford to miss. Among other things, we have already signed a cooperation agreement with the government of Tasmania for enhanced cooperation around research and development of green hydrogen and its export to Flanders.
Both our industry and educational and research institutions have built up a lot of knowledge and expertise in the hydrogen domain in recent years. For example, the ‘Hydrogen Industry’ cluster already reached more than 120 members who cooperate and share knowledge on hydrogen storage and use. But we also have knowledge and expertise here to make sustainable hydrogen cheaper, for example through innovations in that so-called elec trolysis cell. Flemish expertise is therefore highly coveted internationally and a valuable export product - perhaps even our most valuable export product. I like to take the example of wind turbines as inspiration, which we were early adopters of in our country. Now our companies are placing them abroad.
Towards companies, too, ‘sustainability’ is a focus we focus on fiercely. We invest to strengthen innovative companies and make Flanders future-proof in terms of sustainability and digitalisation.

Entrepreneurs and companies are essential for the further expansion of prosperity in Flanders. By supporting, guiding and strengthening our companies, we help them in the sustainable and digital transformation of their business.
Companies have a lot of potential to tackle societal challenges. Think of circular and sustainable business, with respect for people and planet, where innovative companies with a green mindset make the difference.
Digital transformation will also remain a top priority in the coming years, with creative SMEs fully exploring the possibilities of artificial intelligence but at the same time facing cybercrime. Our policy aims to support Flemish companies in realizing innovative projects that have a positive impact on the future of us all.
Internationally, Flanders is considered a water deficit region. How does your policy respond to this?
The drought was more urgent this summer than ever before. That’s why we now provide free water scans for SMEs to raise awareness and support them in water-saving measures. It is clear that companies can save water through many different ways. However, sometimes companies do not have the time or technical knowledge to map their water use and identify possible water-saving measures.
The water scan is a first-line scan that addresses this. Through the preparation of a water balance, a water scan visually maps a company’s water use. If appropriate, this can also be substan-
tiated via flow measurements. Moreover, the water scan provides concrete suggestions for saving water through water-saving devices, using alternative water sources or reusing water. In a water utilization plan, these suggestions come together in a concrete and economically substantiated step-by-step plan that a company can take further.
Flanders, as you yourself confirm, is an innovation leader in Europe. Yet it is too little known in Europe. How would you like to raise Flanders’ profile?
To show the world that we are a technology country, we will organize the FTI (Flanders Technology & Innovation) festival in Flanders in 2024. There we will show the world what we have to offer. We must also inform and enthuse our own citizens and young people about research, innovation and technology. Young people can thus help build a better future. We need their brains and hands, which is why the FTI must also become an enthusiasm story for our youth.
Will these ambitions also be expressed more directly through education?
Knowledge remains Flanders’ most important export product. Our colleges are indispensable pivotal figures to transfer innovation to existing and new companies. They anchor themselves in the local economy and create a positive impact for everyone around them.
They are an important link between research and practice because of their geographical spread and their connection to local SMEs. Every euro we invest in these, we earn back twice over in the living standards of our entire society.
In 2022, we invested heavily in new research infrastructure, totalling more than 120 million euros, for the five Flemish universities, the knowledge institutions imec, Vito, Flanders Make and the Institute of Tropical Medicine. Also in 2022, as part of the relaunch plan ‘Flemish Resilience’, we invested another 3 million euros in the research infrastructure of Universities of Applied Sciences. Investing in this infrastructure is an important part of the Flemish coalition agreement, but within the relaunch plan we can shift up a gear with the Flemish Government. After all, top-class research increasingly requires top-class research equipment as well. Universities of Applied Sciences can receive up to 80% of the total estimated cost as a subsidy, with a ceiling of 300,000 euros per project. In 2023 we continued to invest through our funding agency FWO. This way, we support our institutions to acquire top equipment - a cost that pays off multiple times over: both in training, in human capital, in knowledge generation and in the practical and economic application of new innovations. Our grey matter is our greatest export product.


What are EWI’s core tasks?
The Department of Economy, Science and Innovation (EWI) is responsible for policy preparation, policy follow-up and policy evaluation for the sectors of economy, science and innovation within the Flemish government. In this framework, our most important goal is to allow Flanders to evolve into one of the most progressive and prosperous regions in the world.
Our three levers in this are the promotion of excellent scientific research, an attractive and sustainable business climate and a creative, innovative and entrepreneurial society. EWI strives towards excellence in fundamental research, strategic knowledge development and the exploitation of this knowledge. Prerequisites for this are human capital and research infrastructure. In addition, we follow up the policy themes that are related to the development of an attractive and sustainable business climate and the stimulation of innovation and entrepreneurship.
The focus of the Flemish cluster policy is on a limited number of large-scale and ambitious spearhead clusters. These spearhead clusters will develop and implement an ambitious long-term strategy and competitiveness programme for the Flanders strategic domain, in collaboration with companies, knowledge centres and the government. Catalisti is our spearhead cluster for sustainable chemistry and synthetics, SIM is involved in materials, Flux50 in energy, VIL in logistics and transport. For agrifood we have Flanders Food as our spearhead cluster. Blue Cluster is focussing on blue growth. Medvia – the most recent cluster, founded in 2021 – crossovers in biotech, medical and digital technologies or, more generally expressed, in health and care. It aims to develop and promote economic activities in the health tech domain, in particular the development of an internationally leading ecosystem around the convergence of technologies at the interfaces between biotechnology, medical technology and digital technologies. The four themes Medvia focuses on are personalized medicine, digital medicine, disruptive health solutions and value-based efficient health and care.
How does EWI carry out fundamental and strategic basic research? Excellence is very much the keyword in scientific research. The ambition of Flanders is to finance the most excellent research using this criterion. Flanders has a number of different
instruments for the funding of fundamental and strategic basic research at the Flemish public knowledge institutions such as universities, strategic research centres and other research institutions. Based on this, the EWI department implements a clear policy, coordinates and evaluates these funding mechanisms.
Assignment of a specific grant or subsidy to a researcher takes place through the knowledge institutions themselves or through our agency FWO. In addition to this funding, it is naturally also important to be able to have excellent researchers and research infrastructure. For this reason, we are also investing in our human capital and in state-of-the-art research infrastructure in Flanders and internationally.
Can you give some examples of research funds/ programmes?
The Industrial Research Fund (IRF) is an internal designation fund of a university association (a university and one or more colleges) whose resources are used for strategic basic research and applied scientific research. The objectives of an IRF are – in the short to medium term – to stimulate the interaction between the association and the business world and to build up a portfolio of application-oriented knowledge within the association. In the medium to long term, an IRF must result in better coordination of the strategic basic research and applied scientific research with the economic needs and the application and exploitation of the profile of business knowledge built up. The IRF thereby fits into the broader whole of efforts to strengthen the interaction between higher education institutes and economic players.
The Odysseus programme aims to bring researchers with a foreign career to Flanders via early-stage funding for scientific research. This may involve both leading researchers with international recognition - who lead the way and have a post at a foreign university – and researchers who have the potential to be among the world’s best in the near future. For a period of five years, they are able to build up their own research group. The organisation of the Odysseus programme is in the hands of the Fund for Scientific Research - Flanders. Universities take the initiative to nominate candidates. They provide an academic position, the infrastructure, offices etc. Universities can also nominate a candidate together. Approved projects receive between 100,000 and 1,500,000 euros a year for a five-year period.
What is the importance/added value of strategic research centres?
Strategic research centres (SRCs) have formed thanks to the excellent and relevant results of academic scientific research in a wide range of scientific fields in micro- and nano-electronics, biotechnology, digital technologies, environmental topics and our manufacturing industry. With a view to economic and social valorisation, we continually strive for an appropriate balance between targeted and non-targeted research. In that regard, the strategic research centres have an important
bridging function between fundamental and applied research. SRCs therefore also play an important role in the transformation of the Flemish economy. The marketing of their knowledge through the (co)-creation of spin-offs forms an important part of this. In addition, in other sectors - such as clusters in the agri-food industry, sustainable chemistry & synthetics, materials, energy, logistics & transport, blue economy and health - Flanders also applies an integrated support, research and knowledge policy. Flanders has 4 SRCs that are world leaders in their field. VIB for biotechnology, imec for nanoelectronics and digital technology, Vito for cleantech and sustainable development and Flanders Make for the manufacturing industry and industry 4.0.
Can you evaluate the result of these efforts on the international place and reputation of Flanders?
In Belgium, almost 81% of the total public R&D&I support is managed by the Communities and Regions. Flanders counts for 58% of all Belgian public R&D support. The European Commission ranked Flanders in the Region Innovation Scoreboard 2023 as an ‘innovation leader.’ Flanders spends about 3,65% of its GDP in R&D. The Organisation for Economic Co-operation and Development (OECD) maintains a ranking, which compares the R&D-efforts of its country members. In the most recent list, Flanders was ranked first, before Sweden, Belgium, Austria and Germany.
Several international rankings in which academic or knowledge institutes are listed, provide an indication of their rela tive strength in an international perspective. All Flemish universities score very high on these different ranking. On almost each ranking they belong to the top 3% worldwide. KU Leuven and Ghent University even rank in the top 1% in each of the three major rankings. Each ranking uses different criteria with different weights in their calculation of the rank ing position.

Vlaamse overheid
Departement Economie, Wetenschap & Innovatie (EWI)
Koning Albert II-laan 35, bus 10 B-1030 Brussel
Email: info.ewi@vlaanderen.be www.ewi-vlaanderen.be twitter.com/Departement_EWI www.linkedin.com/company/departement-economiewetenschap-en-innovatie-ewi
The Flemish Advisory Council for Innovation and Entrepreneurship – VARIO – is an independent body which advises the Flemish Government and Parliament on matters related to research, innovation and entrepreneurship. VARIO publishes its advisory reports both on its own initiative and on request. The Council consists of ten experts from the scientific world and the business community, who take part in a personal capacity. Lieven Danneels chairs the council.
Optimal weighing on and responding to EU research, innovation and industrial policy (Advisory report 31)
In this report on broadening our strategic international orientation towards Europe, VARIO indicates how Flanders can best respond to European policy to get the most benefits from it. Moreover, how can we optimise the way Flanders helps shape European policy?
The council puts forward the following recommendations: (1) Provide a strategic framework, to better respond to opportunities and weigh more on agenda setting in the context of European science, innovation, entrepreneurship and industrial policy;
(2) Work towards a strong political Flemish position in Europe;
(3) Maintain maximum commitment to the European framework programme for research and innovation. Discuss a strategy with all stakeholders; (4) In addition, focus strongly on other European programmes and initiatives. Make clear choices regarding co-financing and provide sufficient resources for this.
VARIO positively advises on the EC-Proposal for a regulation on plants obtained by certain new genomic techniques and their food and feed (Advisory report 32)
VARIO was asked by minister of Economy, Innovation and Agriculture, Jo Brouns, to advise on the EC’s proposal of the 5th of July 2023 for a regulation on plants modified with cer tain new genomic techniques (NGT) and food and feed produced from them. VARIO first provides an extensive explanation of the context and a number of concepts followed by an analysis. VARIO concludes that an amendment of the GMO-regulation is urgently needed. VARIO welcomes any improvement to the current framework and agrees with the current draft regulation, subject to a preliminary thorough revision of ANNEX 1. The council encourages the legislator to take new regulations in the future to a higher level and to apply the innovation principle, which makes legislation future-proof and guarantees legal certainty.
VARIO-memorandum 2024-2029
VARIO worked on a memorandum for future policy makers in the Flemish Parliament and Flemish Government in the context of the Flemish elections in 2024. VARIO proposes four ambitions to safeguard Flanders’ position as one of the most innovative regions in the world and also to capitalize on it through entrepreneurship: (1) give innovation policy the leadership it needs, (2) streamline innovation funding, (3) secure more innovation talent and (4) work on a sustainable and prosperous innovation economy. The Memorandum was also the topic of the 2023 VARIO colloquium, which took place on Thursday, December 14, 2023, and where representatives of the various political parties debated the proposed priorities.

Transformative innovation policy
Transformative Innovation policy is a new generation of innovation policy and involves both transition- and mission-driven innovation processes. It leads to economic and broad social system changes. But how can Transformative Innovation Policy be given concrete shape in Flanders? Which policy model best lends itself to this? What kind of policy instruments are required? What are factors to make Transformative Innovation Policy successful? For this advisory process, VARIO and AWTI, its Dutch counterpart, jointly conducted an international benchmark analysis with lessons from Sweden, Switzerland and Austria. The VARIO advisory report is scheduled for early 2024.
Host ‘European STI Councils’
VARIO is an active member of the network of European Science, Technology and Innovation Councils. These councils gather semi-annually for a preliminary spring meeting with the directors-secretaries and for a formal autumn meeting with the chairs and directors-secretaries of the advisory councils. On November 16 and 17, VARIO hosted its European sister councils for the annual autumn meeting in Ghent. The topic of the gathering was ‘The strategic orientation towards Europe’.
VARIO council composition
Lieven Danneels, co-CEO Televic Group, chairs VARIO. The other members are Dirk Van Dyck (vice-chair, UAntwerpen), Katrin Geyskens (Capricorn Partners), Wim Haegeman (UGent-VIVES), Johan Martens (KU Leuven), Koen Vanhalst (De Clercq & Partners), Vanessa Vankerckhoven (Idevax), Marc Van Sande (ex Umicore) and Reinhilde Veugelers (KU Leuven). The council is supported by a permanent staff directed by Danielle Raspoet.

What services do you provide to entrepreneurs?
VLAIO is the agency of entrepreneurship and innovation of the government of Flanders. Its clients are the companies in Flanders. Thanks to our own front office, we can answer their questions, deliver guidance, send advisors to the company’s location to discuss business cases as a whole and innovation in particular, and match them with the relevant members of our network of partners. On top of that we can give companies in Flanders some basic advice on intellectual property, a key aspect of innovation, and we also provide them with financial support for their projects, be it directly or indirectly via other Flemish agencies. Since we have a wide portfolio of grants and subsidies, most of the financial support to companies is given by VLAIO. Subsidies can be granted to professionalize the staff of SMEs or help their growth; they can also be allocated to bigger companies wishing to make an investment to reduce their ecological footprint. Last but not least, our subsidies are mostly focused on R&D and innovation. And let us not forget the fact that VLAIO is an internationally oriented agency: as such, we are the coordinator of the European Regional Fund for Development in Flanders and we also act as contact point for European subsidies in the framework of Horizon Europe and other European research programmes.
How do you help foreign entrepreneurs and investors to establish or expand business in Flanders?
This task is carried out in close collaboration with FIT (Flanders Invest ment & Trade): with about hundred officers around the world, FIT enjoys a strong connection with potential foreign investors. When one of them shows interest to settle down in Flanders, VLAIO and FIT join hands to give that potential foreign investor advice and provide him with the right partner. In terms of advice VLAIO proves to be a privileged partner considering the amount of information we have about subsidies for investments. Since foreign companies are often willing to carry out R&D activities in Flanders, VLAIO can connect them with universities and other knowledge institutions. We can also help them to find a location with the close cooperation of municipalities, project developers, realtors and (air) port authorities.
What support do you offer for research & development?
We offer direct financial support for R&D activities and encourage companies to collaborate with universities and other institutions and/or companies. This incentive is in no way compulsory but it remains interesting given that R&D is a hazardous process: it can fail to yield the expected business results. That is why cooperation enables risk sharing while subsidies encourage risk taking by companies. There are two kinds of subsidies. The first one covers research projects with a lower TRL, i.e. a focus on knowledge generation that implies a bigger support; higher development projects with a higher TRL, closer to the market and therefore less risky (which implies a smaller support); joint projects between companies or between companies and universities; and incentives for PhD students and postdocs to work in a company (this incentive has been very successful over the last years). The second kind of subsidies is related to the various European networks (Eurostars, European partnerships, Eureka…) in which VLAIO funds Flemish players in international consortia supporting international collaboration and creating a leverage to European cofunding. In addition, in its function as national contact point, VLAIO guides companies to join European programmes such as Horizon Europe. For the current period, VLAIO provided funding for projects in European value chains elaborated in the context of the Important Projects of Common European Interest (IPCEI).
How do you help innovation clusters in Flanders to increase their competitiveness?
Clusters are an important instrument to promote cooperation and innovation within the same value chain. We mainly support six spearhead clusters: Catalisti (sustainable chemistry), Flanders Food, VIL (logistics), Flux50 (energy innovation), Blue Cluster (economy and innovation in the North Sea) and the youngest one, Medvia (healthcare innovation). VLAIO grants subsidies for cluster projects. For instance, Blue Cluster has recently launched the project Blue Marine with the aim to develop technologies for growing plants in the North Sea: these sea farms are interesting for various sectors, such as the pharmaceutical industry and the textile industry. Thanks to this project, different sectors work together via a very innovative, atypical approach which can benefit everyone. VLAIO also supports smaller innovative business clusters (eleven at the moment), which are bottom-up initiatives launched by companies active in drones, offshore energy, etc.
As of 2020, VLAIO has taken an active role in supporting enterprises during the COVID-19 crisis by providing funds to alleviate the direct financial impact. In the recent period, the emphasis has shifted from mitigating the impact of the crisis to the relaunch and recovery of the economy. VLAIO managed several projects within the Flemish Resilience Plan, partially funded through the European Recovery and Resilience Fund (RRF), and has opened a call within the RePowerEU initiative. In this relaunch Flanders actively supports the evolution to a low emission economy, sustainability, digitisation etc. and pays attention to working in missions. VLAIO also takes up an active part in the newly established governmental frame to support Flemish companies affected by the rising energy prices.

Anticipating the future is what Howest, the University of Applied Sciences has in mind. This is also reflected in the research that is dominated by new trends and technologies with an impact on business and society. Because of that, Howest officially joined the RUN-EU (Regional University Network - European Universities) on January 1st, 2024. RUN-EU is an alliance of 8 like-minded higher education institutions drawn from all regions of Europe. RUN-EU and Howest focus on 3 thematic areas: bio-economy, future industries and social innovation.
“Our research results flow into education and business. They were already easily shared at the regional level and from now on, this will also happen at the international level.”

The mission of RUN-EU is to provide s tudents, lecturers, researchers and staff members from various partner institutions in Belgium, Spain, Ireland, the Netherlands, Austria, Finland, and Portugal with the opportunity to exchange knowledge and expertise. All members of the alliance share the ambition to establish collaborations across national borders. “By broadening our horizons through collaborations with Euro pean partners, we aim to reverse the trend of brain drain into brain gain,” says Frederik D’hulster, president of Howest. “The strength of this alliance also lies in the fact that all partners have a strong network of companies around their respective colleges or universities,” adds Lies Vanhaelemeesch, RUN-EU coordinator at Howest. “Howest is deeply rooted in West Flanders, and advanced skills are taught for
societal transformation in peripheral regions. Our research results flow into education and business. They were already easily shared at the regional level and from now on, this will also happen at the international level.”
RUN-EU focuses on three thematic areas, which Howest also emphasizes during projects:
Bio-economy: Recycling solutions for businesses
The Circular Solution Lab of Howest’s Industrial Product Design research group conducts research on improved recycling and design-for-reuse of non-domestic packaging. The Circular Solution
Lab also gives demonstrations to companies. “A lot of new European legislation is coming our way, just think of the Packaging and Packaging Waste Regulation (PPWR), which defines sharp targets for packaging,” says Howest researcher Katrijn Sabbe. “In that context, we will develop cases in which we demonstrate to West Flanders companies solutions that show that Packaging Waste Regulation offers many opportunities, and does not necessarily have to be a threat. Furthermore, we will support companies with tailor-made advice on recycling and the implementation of reusable packaging concepts.”
The Art-Ie project investigates how to strengthen the Flanders-Netherlands border region in terms of digital innovation in general, and AI in particular. “Although the corona crisis has accelerated the digitalisation trend, Flemish SMEs and Dutch SMEs still encounter a lot of problems and challenges,” says Gilles Depypere of STARlab (Smart Tech AI Research lab). “That is why we are very happy to cooperate with this project. This includes building an AI lab where our researchers and partners will work on innovation questions from different companies. That way, companies can learn about our expertise and infrastructure in an approachable way. The programme includes open lab days, Art-IE talks, theme days and lots of events.”
Howest is building a Digital Health Lab in Bruges in West Flanders, focusing on digital and preventive health. There will be a demonstration room where healthcare institutions, companies and the general public are welcome to get inspired about digital health. “This way, we want to stimulate innovation within organisations and thus help enable the implementation of preventive digital applications in healthcare,” says Active Health Howest research coordinator Sigrid Van den Branden. “Furthermore, there will also be a co-creation space to look together with the healthcare sector and technology developers at where the technology needs are and how we can meet them with our university college. The results of our research will also be valorised from the Digital Health Lab.” The Digital Health Lab is a coordinated collaboration between Howest and POM West Flanders, with ERDF support.

Howest, University of Applied Sciences
Marksesteenweg 58
8500 Kortrijk
Tel.: +32 (0)498 67 16 54
Email: research@howest.be
http://www.howest.be


All thirteen Flemish Universities of Applied Sciences and Arts conduct applied and practice-oriented research in various domains of science and technology. It is widely accepted across Europe, and highly valued by European authorities, that practice-oriented research activities are essential for our society to successfully cope with the major transitions it is facing and will face in the near future, such as the so-called double transition (digitisation and circularity).

Universities of Applied Sciences and Arts - also referred to as Professional Higher Education Institutions - are nowadays (without any dispute) regarded as the best performing innovation and valorisation engines for relevant scientific findings, increasingly not only at a regional level but also at a national and even international one. By its nature, practice-based research allows immediate and impactful implementation of its findings in relevant parts of society.
The Flemish Universities of Applied Sciences and the Arts have mastered the art of practice-oriented research and have a long tradition of close ties with society. They focus on building strong networks with various public and private stakeholders. In this way, they have created a high level of awareness and understanding of the changing needs and challenges in different parts of society, which they have then made the heart of their mission, activities, and processes. Both in their educational and practice-oriented research activities, our Flemish Universities of Applied Sciences and the Arts place a great deal of emphasis on ‘co-creation’ with relevant stakeholders in society, ranging from SMEs to sector federations, NPOs, knowledge institutions, etc. By maintaining a close relationship with stakeholders, they continuously enrich not only their education portfolio, but their research programme as well.

Each of the Flemish Universities of Applied Sciences and Arts today has reached a high level of expertise in at least some of the 9 key domains, all related to the UN SDGs, demonstrating the level of awareness of the crucial role they play in providing solutions for current and future social problems.
Typically, most Flemish Universities of Applied Sciences and Arts have expertise that combines different areas of technology as well as on such topics as future-oriented and people-oriented approaches to health and well-being, climate and the environment, digital transformation, smart mobility, etc. They also usually emphasize entrepreneurship and the empowerment of students. To meet the challenges of the future, all Flemish Universities of Applied Sciences and the Arts have developed both the necessary high-tech infrastructure and an organisation that can deal with questions and requests from relevant stakeholders in the most efficient way. This usually means an interdisciplinary approach, combining the expertise of different research groups to deal with the problem or challenge at hand in the most efficient way. All Flemish Universities of Applied Sciences also participate in the ‘Blikopener’ programme, which plays a central role in connecting all relevant stakeholders.
www.vlaamsehogescholenraad.be/nl/onderzoeksthemas

Contact : Johan Van hunsel
Stakeholder relations officer research & innovation
+32 494 56 04 99
johan.vanhunsel@vlaamsehogescholenraad.be
www.vlaamsehogescholenraad.be/nl/contactpersoon/johan-van-hunsel www.linkedin.com/in/johan-van-hunsel-123188a/
Everyday life in the beginning of this decade has made it painfully clear how complex, vulnerable supply chains are. It has demonstrated how globally interconnected our world has become and how quickly things can go wrong. At the same time, we understand that a general decarbonisation of all aspects of society is key to ensure a liveable planet for future generations.


In this context VIL, Flanders’ spearhead cluster for logistics, together with its almost 700 members of which 2/3rds are SMEs, meets the challenges head on and explores, supports and engages in innovative and sustainable projects for the logistics sector.
“Our primary focus lies with innovative logistics projects and their subsequent valorisation. Together with its members VIL has defined four domains in which such projects will be conducted: digital transformation, last mile, hinterland connectivity and green logistics,” says managing director Liesbeth Geysels. “VIL also acts as a facilitator bringing together different key stakeholders around pertinent innovation tracks and leverages collaboration.”
A prime example of a project digitally transforming processes and logistics is Gateway2Britain.
Brexit has had an important negative impact on Flemish companies that trade with the UK, both in terms of turnover, cost structure and logistics operations. Gateway2Britain aims to overcome these issues and allows for frictionless trade with the UK. The project consists of two pillars.
The technological pillar consists of a cross-border data sharing platform providing accessibility to data and documents throughout the supply chain. This platform will connect the existing data sharing platforms in Flanders and the UK.
The physical pillar, taken up by VIL, creates a one-stop service point for all logistics services required for post-Brexit EU-UK trade. This pillar focusses on SMEs that have difficulties complying with the new border formalities and are looking for a simple, affordable, and high-quality service provider. Next year logistics service providers will have been certified by VIL in order to support all SMEs with their export activities towards the UK.
VIL also actively commits in international efforts and focuses on co-ordination and collaboration with international cluster organizations and coaching its cluster members while participating in European projects itself or support its members by directly joining various consortia in European funded programmes.
An example is the DISCO project (Data-driven, Integrated, Synchromodal, Collaborative and Optimized), where 48 European partners collaborate in creating new sustainable solutions for on-demand city logistics and exploring opportunities for secure data sharing via data spaces in urban logistics. “Together with the city of Ghent, IMEC & Be-Mobile, VIL as leader of the living lab, will develop the Dynamic Access Control concept, which allows information on access rules to the city to be used in planning systems of transporters, into a concrete and applicable system in the Ghent city centre,” says Kris Neyens, manager internationalisation.
Let’s demonstrate it!
Log!Ville, VIL’s open state-of-the art logistics demonstration and experience centre is unique in Europe. Companies can visit and explore innovation for real in the physical demonstration area, where Log!Ville partners exhibit mature but not yet mainstream solutions that are ready to be implemented.
Dive also into the future of logistics in the Digital Experience Centre with focus on game-changing technologies that ensure companies to become future-proof. The potential of tube logistics with the hyperloop, the limitless applications of AI, the dark warehouses, the fuels of tomorrow, and much more will be discovered.

We accelerate the transition to a sustainable world. We de-risk innovation for businesses and we strengthen the economic and societal fabric in Flanders, with interdisciplinary research and large-scale pilot installations.
Sustainable solutions for buildings
Building towards a fossil fuel-free and healthy living and working environment
Sustainable buildings are not just buildings lit, heated and cooled with green energy. They are also designed and implemented in a manner that makes the impact on the environment, and the climate as low as possible. In addition, they are healthy and comfortable for residents, users and visitors too. VITO/EnergyVille has a strong focus on all these aspects.
Robust water management
Towards a climate-proof water system through research and innovation
From a region plagued in turn by drought and water scarcity, then by water nuisance and flooding, to a model region for efficient water usage. This ambitious transition is what the Flemish government is proposing in its Blue Deal. With this broad package of measures, Flanders is seeking to accelerate its robustness against water problems.
Towards a circular and bio-based economy
Circularity rhymes with sustainability
In a circular economy, as few new primary raw materials and ingredients are used as possible, and as many as possible are reused and recycled – losing as little value as possible. Bio-based raw materials and products can help to make the circular economy more sustainable. Reuse and recycling make Europe less dependent on importing primary raw materials from other continents.
In the vanguard of the energy transition
Europe wants to be the first over the finish line as a climate-neutral continent by 2050. We need to be moving at full speed. VITO/EnergyVille uses a system vision for the energy transition. Innovations in energy coming from VITO/EnergyVille’s labs are putting Flanders on the map as a pioneer in the transition in various fields. From the hydrogen economy through smart and flexible energy distribution to carbon-neutral industry. In doing so, technological developments will quickly find their way abroad, including beyond Europe.
Global warming is not the only crisis threatening our planet. Biodiversity in the many unique ecosystems that the Earth has in abundance is under great pressure or is already declining. These demands action. With its activities in the fields of analysis, modelling and remote sensing, VITO has been very well-equipped for this for years. In projects on climate monitoring or biodiversity, VITO has, as always, been working with respected partners, ranging from the European Space Agency (ESA) through the United Nations’ Environment Programme to the African Union.

Good health is very dear to us. Naturally, prevention is always better than cure. This is making preventive healthcare more and more important. One of the factors influencing our health is our living environment. If this is healthy, there are some automatic benefits to our own health. Treatments and therapies are becoming ever more individual, a consequence of the rise of personalised healthcare.
Enhancing the Flemish economy and making it more sustainable
The expertise and technology that VITO develops does not remain in-house. It is also valorised by transferring it to the business world. This is another part of VITO’s mission, as this tech transfer enhances the Flemish economy and makes it more sustainable. The spin-off programme has evolved since its launch in 2015. Whereas spin-offs initially came about from within VITO, they are now more often launched in collaboration with other knowledge institutions. Several long-term partners with which VITO is a ‘co-parent’ of spin-offs are the KU Leuven, the University of Antwerp and imec.

Voka Health Community is an ecosystem of more than 600 welfare and care institutions, businesses, knowledge centres and patient groups. Within the Voka Health Community they work together to create and valorise added value through innovative solutions in (health)care.
Voka Health Community focuses on three major building blocks:
- Integrated and high-quality care and care delivery that focuses on prevention and health promotion
- Innovative business development around care organisation, technology and digital transformation
- Solidarity-based social security with financing that stimulates doing what is right following the value-based healthcare principles.
A contemporary (health)care system that is adapted to the future needs is possible: a more digital care with a focus on prevention and an alignment of tasks with respect and motivation for the care profession will help us move forward and help us to tackle the challenges in welfare and healthcare.
Staff shortages are the number one. The ageing of the population is a triple challenge: with the increasing number of elderly people, our care needs are becoming not only larger, but also more chronic and complex. Our care system must therefore meet both a greater volume and more intense care needs. The third effect is due to the ever-shrinking active population. In 1991, the care and financing of 1 elderly Belgian was carried by 4 pairs of active shoulders. In 2050 that number will have halved to 2. We will have to bear the greater number of elderly people and their complex care needs with fewer and fewer people. The labour market on fire? You ain’t seen nothing yet.
Therein lies a great paradox: according to the Organisation for Economic Co-operation and Development (OECD), Belgium has a quarter more active nurses than the OECD average. Generally, they appear to be better educated than in other countries. The diagnosis: our health personnel lose time with administration, logistics and household tasks while the norms keep the door open for support staff. The shortage of personnel in the healthcare sector is causing major and justifiable headaches.
This brings us to digitisation. The care sector is still walking around in the digital 90s. Paper forms have been replaced by exactly the same digital ones. So, a lot of opportunities remain unavailable. A digital transformation goes further: besides collecting data, you also have to analyse and evaluate them and adapt your way of working. Digitalisation must support healthcare staff in organising and coordinating care efficiently, instead of frustrating them – and their patients – endlessly.
The key to achieve a digital transformation in health is not to develop the necessary technology. Smartphones, apps, mobile sensors: the technology is already there. The challenge lies in regulating and implementing that technology so that it supports

the goals around quality and affordability. Europe is leading the way here with the European Open Data Area. In Belgium, hospitals and home care institutions are already working to make their data not only available but also FAIR: findable, accessible, interoperable and reusable. With some investment in capacity and digital competences, this will receive an enormous boost. With Voka Health Community we will commit to implementing technology and innovation in the health and care sector.
Besides digitalisation, focusing on self-care and prevention is a no brainer. Today, Belgium spends 1.6% of its health budget on prevention, while the World Health Organisation’s target is 5%. Investing in prevention prevents up to 80% of cardiovascular diseases and diabetes, and up to 40% of cancers. People who do not fall ill, fall ill less or fall ill later, need less care.
Within the Voka Health Community, we set to work together. We use the evolutions in science, innovative ideas and the experiences of our members to move forward. You can find information about Voka Health Community, our activities and our publications on www.voka.be/healthcommunity.
Daan Aeyels+32 475.298.377
Daan.Aeyels@voka.be
www.voka.be/healthcommunity

In the first sustainability report for the technology industry in Belgium, published in 2022, Agoria informs about the progress of the sector in the field of sustainability.

With this report, realised in cooperation with its 2,000 members and stakeholders, Agoria fulfils its responsibility to communicate transparently its sustainability strategy, with clear engagements and the impact of the sector. The report can be considered as a baseline measurement, the indicators and data of which Agoria will continue to supplement in the coming years.
“With our sustainability report, we want to inspire companies within and outside our sector to integrate sustainability even more into their business operations. Committing to sustainable change will be the decisive factor for the future of our companies,” says Jolyce Demely, general director of Agoria Flanders.
“Technological innovation is the driving force of our industry. Our motivation to innovate stems from the ambition to continue creating added value for society, including in the long term. The manufacturing industry is the engine of Belgian export and prosperity. Every job in the manufacturing industry creates at least one other in related service sectors. Almost one in four Belgians earns his or her income thanks to the industry. But high labour costs, the automatic index and inflation put pressure on the added value and competitiveness of Belgian manufacturing companies. Furthermore, the current energy crisis makes it even more difficult for our companies to grow and invest. Research and development are crucial to continue creating added value and jobs from the technology industry and the manufacturing industry in particular. Only by transforming into ‘factories of the future’ – agile, digital, technological and people-oriented undertakings – can our manufacturing companies embed production activities sustainably in a hyper-competitive global economy. Continuous
innovation is therefore a necessary precondition to securing the long-term future of the manufacturing industry in our country,” says Demely.
Technology not only creates economic value, but also helps society in many other areas. For example, technology plays a key role in improving traffic safety, strengthening healthcare, fighting and dealing with pandemics and tackling the increasing ageing population. Technological innovations are also vital to the success of the green transition, just think of CO2 capture and storage, smart energy grids or electric vehicles. In short: without technological innovation, we would live in a less safe, comfortable, healthy, sustainable and connected society. “From our sector, we strive to maximize all such positive impact of technology, while keeping an eye on related concerns, such as the ethical use of AI, the impact of technology on organizations, universal access to digitization and ensuring privacy,” she adds.
In 2023, Belgium was in fifth place on the European Innovation Scoreboard and is counted among the European Innovation Leaders, along with Sweden, Finland and Denmark. We aspire to be in the top three by 2030. In 2022, the technological industry invested 2.6 billion euros and R&D expenditures amounted to over 3 billion euros. With that amount, the technology industry financed 29% of all Belgian R&D efforts.
“In our sustainability report, we commit ourselves to create a net 40,000 additional jobs and fill them by 2030. In addition, we make sure that employees in our sector know what competencies are needed for their jobs in 2030 and that they receive the necessary training.”
Jolyce Demely Jolyce.demely@agoria.be www.agoria.be
- We aim to have Belgium in the top three of the European Innovation Scoreboard by 2030, with the technology industry accounting for a third of R&D expenditure in Belgian industry.
- The added value of the technology industry will grow by an average of 2.2% per year by 2030.
- The added value of the manufacturing industry will grow by 1% per year by 2030.
- We will bring five breakthrough technologies (product or process) to the market that create societal value by 2030.

Becetel combines more than sixty years of expertise, total independence and extensive testing facilities, which is unique in Europe. A wide range of companies, organisations and certification bodies call on the services of this ISO 17025 accredited laboratory for testing plastics pipes and fittings.
The Belgian Centre for Technological Research on Pipes and Fittings started as a spin-off of Ghent University. By now, it has grown into a test laboratory with international allure. “We limit our field of activity to testing plastics pipes and fittings,” says general manager Joris Vienne. “Things however changed over the years. In our early years there was only PVC, today a wide range of plastics is used in piping. Initially we only worked with piping materials for drinking water and gas. Today, you can find plastics piping in all utilities, industrial processes, rainwater infiltration, waste water treatment and construction… By participating in international symposia, training and research, our knowledge also evolved. As a result, Becetel is one of the few laboratories with so much expertise in this specific field. Our customers greatly appreciate this. Most of them are located outside Belgium. With the evolution of PE 100 to ‘slow crack growth resistant’ PE 100-RC materials, Becetel is also involved in testing this new generation of materials.”
Becetel always proactively translated its knowledge into test equipment. “We continuously invest in new solutions”, says Vienne. “Thanks to our in-house expertise and creativity, we regularly succeed in creating our own solutions. For example, we have our own installations for the accelerated Notch Pipe Test (aNPT), the Plain Strain Grooved Tensile (PSGT) test and various creep tests. These solutions are developed either in cooperation with equipment suppliers or in our own mechanical workshop with equipment for turning, milling, drilling, sawing and welding and a CNC milling machine.”
Of course, Becetel has a lot of other test infrastructure: large water tanks for hydrostatic pressure testing, pressure stations, universal testing machines with load ranges from 0,5 kN to 400 kN and equipped with extensometers (contact and video non-contact), temperature chambers, impact testers, pressure cycling units, data-logging equipment, ultrasonic thickness gauges, hardness testers, flow meters, fusion machines, torque wrenches, dimensional measuring equipment, height and strain gauges, thermocouples… “We have a temperature conditioned lab for the dimensional measurements, creep testing and multiple universal testing machines for determination of tensile, flexural and compressive proper ties,” Vienne explains. “In our multifunctional hall we perform hydrostatic pressure tests, impact tests, leak tightness tests, temperature cycling tests… There is also a lab for physical properties, such as MFR, DSC, IR, Vicat, thermal stability testing, IR analysis… And microscopic facilities for failure analysis. We can handle various pipe diameters, from 8 till 2000 mm.”
Today, Becetel mainly carries out mechanical tests on plastics pipes, including fusion joints, connections and accessories. “We also have an extensive experience in performing rapid crack propagation (RCP) tests, formerly with the full-scale test site and since decades with the S4

(Small-Scale Steady State) test,” says Vienne. Furthermore, Becetel developed software to perform the Standard Extrapolation Method analysis described in ISO 9080. “Because we have built or modified some of our testing equipment ourselves, we can even carry out tests that fall outside the standards. We also accumulated experience in the testing of elastomers (ageing, compression set...). Becetel also acts as a partner in various standardisation and certification systems and we are actively involved in the international standardisation committees of CEN and ISO. It is regularly called in as an expert in the event of claims related to failures in plastics.”

Becetel vzw
Gontrode Heirweg 130
9090 Melle
Tel.: +32 (0)9 272 50 70
E-mail: info@becetel.be
http://www.becetel.be


What are the key figures of R&D at imec?
Imec brings together more than 6,000 people from over 100 nationalities. We are headquartered in Leuven and have distributed R&D groups at a number of Flemish universities, as well as in the Netherlands, of the USA, and representation in 3 continents.
Could you introduce your expertises?
As a world-leading research and innovation hub in nanoelectronics and digital technologies, we combine our leadership in microchip technology with profound software and ICT exper tise. Add to this our world-class infrastructure and local and global ecosystem of partners across a multitude of industries. Together, we create ground-breaking innovation in the semiconductor industry as well as in application domains such as health and life sciences, smart cities and mobility, industry 4.0, sustainable energy, agrofood and education.
How is imec collaborating with companies across the world?
We offer R&D partnerships as well as innovation services. We firmly believe in the synergy of R&D collaboration. Together with universities, companies and public stakeholders, we aim to maximize knowledge and expertise to push technology forward. All our R&D partners benefit from the unique assets that imec offers such as our state-of-the-art infrastructure, our top-of-the-class international talent with multidisciplinary scientific background, our unique IP, and our one-of-a-kind ecosystem of local and global partners including universities and world-leading companies from a multitude of industries.
Our unique environment ensures more interactions, higher creativity and better integrated technologies. Next to our R&D program offering, we also work together with companies on a bilateral basis, for private research. This can be an R&D collaboration supporting companies with the development of technological solutions to innovate their products and services. But this is not limited to R&D support: we offer support throughout the entire lifecycle of the innovation process. Whether it is hardware, software, or both. And for innovators from around the world, as well as for local initiatives in Flanders.
Could you tell us about imec’s smart health research?
Imec leverages its expertise in chip design and chip technology, MEMS, bio-electronics, sensors, photonics, microfluidics, etc. to develop innovative tools for the life sciences, pharma R&D, clinical diagnostics, therapeutic and surgery, biopharma production and analytical biochemistry industries. Our IP is available for licensing, we provide research and development support, and we can also help companies with the prototyping, testing and manufacturing of their custom smart biochip solutions. We also combine electronics and data science to develop and validate solutions for our partners’ health applications. We develop solutions for a variety of health applications, focusing on medical devices and chronic disease management, as well as on a healthy lifestyle and preventive care…
What do you see as the main challenges facing life sciences companies in the coming years?
New diagnostics techniques are poised to play a crucial role in the future. These new techniques will have to be more sensitive, faster and cheaper so that we can test and treat all patients whenever there is a need. And this without overstretching the already heavily challenged healthcare budgets. Size, cost, power consumption, performance, sensitivity, within each patient’s reach and with medical accuracy and fast diagnostic results, become crucial parameters in research and diagnostics. As a pioneer in nanoelectronics, imec brings the power of chip technology to the world of healthcare to drive the development of innovative tools for diagnostics, sequencing, cell & gene therapy, neurotech, implantable medical devices, medical imaging and more. With silicon technology, we have the ability to design and fabricate breakthrough miniaturized tools and instruments at low cost, high parallelisation and ultra-high precision.
Every day, Labo Maenhout carries out more than 5,000 laboratory analyses for primary care. It also plays a leading role in the introduction and roll-out of innovative applications in this segment of healthcare provision.
 © Labo Maenhout
© Labo Maenhout
Our independent clinical lab is highly computerised clinically and uses the latest available technologies,” says pharmacist-biologist Thomas Maenhout. “We perform analyses not only in the field of clinical chemistry, but also on hormonology, toxicology, therapeutic monitoring, haematology, coagulation, immunohematology, immunology, serology, microbiology and anatomopathology.” The lab has been in existence since 1 March 1979, when it was established for Thomas’ father Patrick, also a pharmacist-biologist. “I have experienced for more than forty years that laboratory medicine as a discipline remains in a state of flux,” says Patrick. “I witnessed the technological advancement of analytical methods, the development of reliable quality systems and the ongoing digitalisation of our healthcare system. In doing so, I noticed that in terms of technological advances, the clinical laboratory has often been and still is a spearhead within medicine.”
Labo Maenhout therefore constantly invested in the development of new, faster and more automated methods and communication platforms. “Always according to international quality standards, such as the ISO 15189 quality guideline for clinical biology. Throughout these technological and digital advances, we never lost sight of the human aspect. As a family business, for instance, we realise better than anyone else the importance of dedicated employees. Today, our team comprises about 30 people, clinical biologists and specialised laboratory technicians.”
“Besides our services to primary care - general practitioners and extramural physician specialists - we have a research activity in which we focus on non-invasive collection techniques of blood, saliva and other bodily fluids. One of the projects we are fully involved in is the introduction of the Tasso, a device that allows people to take blood
themselves at home and send it by courier. There is no need to prick a vein; it works on a capillary basis. The only obstacle is cost, as each Tasso can only be used once. To be widely used, a policy decision is needed to allow health insurance intervention. The data that we collect through our analyses and questions about the perceived ease of use help to demonstrate the usefulness of this. We are also work ing on testing other devices. Working with microvolumes is an important challenge for us as a lab. We sometimes work on such projects independently, sometimes as a partner of Ghent University Hospital or the Free University of Brussels.”
For instance, Labo Maenhout also collaborated on a study to improve the safety of the drug desmopressin in elderly people at risk of sodium deficiency: “For this, we introduced a way of monitoring sodium levels in capillary blood to reduce the risk of sodium deficiency, increase patient safety and eventually introduce self-monitoring of sodium levels. The first step in this was to validate capillary-derived sodium. In doing so, we were able to show that was no significant statistical difference between venous and capillary sodium levels.”
“We already find applications of capillary blood sampling in startups that want to offer at-home collection and in pharmaceutical companies, in their PSP (patient support programmes). There, blood sampling is very expensive and this technology can save costs,” comments Thomas Maenhout.
Labo Maenhout
Roger Vansteenbruggestraat 64/1
B-8790 Waregem
Tel.: +32 (0)56 62 07 73
Email: info@labomaenhout.be
http://www.labomaenhout.be

The Neyts-Laboratory of Virology, Antiviral Drug & Vaccine Research at the Rega Institute for Medical Research, part of the KU Leuven, has a long-standing expertise in the development of antiviral strategies and drugs against emerging and neglected viral infections. It also focusses on the development of novel vaccine technologies.
Lab-leader Prof. Dr. Johan Neyts teaches virology at the medical school and at the school of dentistry at the KU Leuven. He is past president of ISAR, the International Society for Antiviral Research. Prof. Neyts co-founded the KU Leuven spinoffs Okapi Sciences and AstriVax. Until now, he published more than 640 papers and gave about 350 invited lectures. His laboratory has over the years been partner in, or coordinator of a large number of EU-funded projects. Johan Neyts is often interviewed by the general press on virus-related topics.
Together with the Centre for Drug Design and Discovery (CD3) in Leuven, his laboratory works on the development of novel antiviral strategies against several viruses or viral families for which no small molecule antiviral drugs exist yet.

Each year, the dengue virus sickens an estimated 100 million people in subtropical regions around the world. There is no drug for the treatment or prophylaxis of dengue. With support from the British Wellcome Trust his laboratory, together with CD3 and later joined by Janssen Pharmaceutica, developed a highly potent pan-serotype inhibitor of the dengue virus.
Their findings were published in 2021 and 2023, in two Nature papers. In October 2023, Janssen Pharmaceutica announced promising data from a Phase 2a clinical trial that the drug – codenamed JNJ-1802 – results in antiviral activity against dengue in humans. The drug is also safe and well tolerated. JNJ-1802 is the first antiviral to show such activity in humans. The compound has now advanced to a community-based field study to establish efficacy against circulating dengue serotypes in a real-world setting. Together with CD3 and again funded by the Wellcome Trust, the team also developed a potent class of RSV inhibitors that is now being further developed by Gilead Sciences. Also, together with CD3 and Aligos Therapeutics, a new generation of coronavirus protease inhibitors is being developed that, unlike Paxlovid, no longer require the PK-booster ritonavir. This drug is currently also in clinical development.
Since long, in the context of epidemic and pandemic preparedness, Johan Neyts is an advocate for the development of small molecule antivirals that are active against entire families of viruses. He explained this idea even at the 8th Wuhan Conference on Modern Virology in September 2019, months before the beginning of the pandemic. It is highly likely that novel viruses that emerge in the future, thus also dangerous new pathogens, will belong to already known families of viruses. A number of viral families have high potential for such emergence. The concept is to develop in
epidemic/pandemic peacetime orally available antiviral drugs that are active against entire families of viruses. If stockpiles of potent, safe, oral pan-coronavirus antivirals (such as Paxlovid) would for example have been available at the start of the Covid-19 pandemic, clinical studies with such drugs could have initiated in the early weeks of the outbreak. Such drugs could have been used to treat the most vulnerable but also to protect healthcare workers and may have had a major impact on the number of Covid deaths. The Neyts-lab, together with CD3, is working towards developing broader-acting antivirals for other families, also within the context of EU-funded projects.
To facilitate such type of studies, the team designed and built several years ago a fully automatic high biosafety laboratory-in-a-box. This facility, unique in the world, is called Caps-IT and an explainer video is available on the website of the laboratory. During the Covid-pandemic, the team screened more than 2 million molecules, both from CD3 and from external parties, for potential SARS-CoV2 activity. “Our current capacity is roughly 25,000 antiviral tests per day in this high biosafety environment. We run tests against multiple viruses. Very few teams have such capacity,” says Neyts. Caps-IT has a footprint of just about 20 m². Each instrument in Caps-IT has its twin; this allows the software, in case an instrument would fail, to re-route the work to its double. The antiviral tests are being carried out in 384-well plastic plates with in each well cells and a test compound. A robot-arm opens the lid of the plate and another instrument adds the virus to each well. Another robot-arm then places the plates at 37 °C after

which the virus is allowed to replicate for a couple of days. When time is up, the software decides - this can be in the middle of the night - to place the plates on the fully automated microscopes for evaluation. This way, terra-bytes of data are collected.
The Belgian federal government agreement of 2020 stipulated that Belgium had to establish a so called VirusBank to be better prepared against viral threats. Johan Neyts and Patrick Chaltin, director of CD3, submitted a proposal. In December 2022, the Belgian government decided to invest 20 million euro in such a VirusBank Platform in Leuven. This research unit will develop tools for viral epidemic and pandemic preparedness. This implies among other establishing viral assays for large panels of representative viruses and clinical isolates for the particular viral families; it also includes for example establishing reverse genetics systems but also relevant animal infection models. Likewise, CD3 is establishing a large library of small molecules to facilitate the identification of new classes of broader-spectrum viral inhibitors. The VirusBank Platform was officially opened in October 2023 by federal prime-minister Alexander De Croo, minister of public health Frank Vandenbroucke and state secretary of science policy Thomas Dermine.
Together with the team of Prof. Kai Dallmeier, also at the Rega Institute, the Neyts-lab is also working on developing novel vaccine technologies against viruses. An important issue with vaccines is that they need a strict-cold chain which is often a major challenge in low-income countries, certainly in remote (sub)tropical places. One of the essential vaccines in many regions in Africa and Latin America is the vaccine against the yellow fever virus. It is a highly effective and safe vaccine. Besides the need for a cold-chain, another issue with this vaccine is however that it needs to be produced in fertilized chicken eggs; the Pasteur Institute in Dakar, where the vaccine is being produced for local use, needs for example to fly every two weeks, such eggs in from a specialized facility in Germany. The team in Leuven developed a technology that allows the same vaccine to be produced in fermenters, thus no longer requiring chicken eggs. As a bonus, the candidate vaccine thus produced becomes also highly thermostable.
To enable the further development of this vaccine technology, during the summer of 2022 Neyts and Dallmeier co-founded the KU Leuven spinoff AstriVax. The closing of 30 million euro was the largest ever for a KU Leuven spinoff. Renowned investors, V-Bio Ventures, Fund+, Flanders Future TechFund managed by PMV, Thuja Capital, Ackermans & van Haaren, OMX Europe Venture Fund (Mérieux Equity Partners and Korys), BNP Paribas Fortis Private Equity and the KU Leuven Gemma Frisius Fund made this investment possible. The first project of AstriVax is to bring the yellow fever vaccine based on the technology of Dallmeier and Neyts to clinical development. But since the yellow fever vaccine can also serve as vector, it allows to also develop highly potent vaccines against other diseases. AstriVax is hence also further developing other very promising vaccine candidates, namely a prophylactic vaccine against rabies and a therapeutic vaccine to cure chronic hepatitis B.





The emerging field of nano-science and nano technology has been driven by and requires the development of innovative tools and techniques for observations at nanoscale. Single molecule microscopy is a prominent tool with a high non-invasive character for this kind of research. It also is the speciality of the Hofkens Laboratory at KU Leuven.
“
Over the past decades, optical spectroscopy and microscopy at the ultimate limit of a single molecule have grown into extremely powerful techniques for exploring the individual nano-scale behaviour of molecules in situ and in real time in complex local environments,” says lab leader Prof.Dr Johan Hofkens. “Observing a single molecule removes the usual ensemble average, allowing the exploration of hidden heterogeneity in complex condensed phases as well as direct observation of dynamic changes.”

The best description of the Hofkens laboratory re search vision is a quote from ‘Chemistry for the next decade and beyond,’ commissioned by the UK Engineering and Physical Research Council: “New insight is generated in laboratories where unique instrumentation is being developed.” The Hofkens lab not only is an active proponent of this view, it also has gone way beyond building unique equipment by applying the instrumentation on a wide variety of timely and societal relevant topics.
“The physical laws governing light diffraction restrict the view with traditional fluorescence microscopes to length scales well above 250 nm. As the biomolecular actors which regulate the fundamental processes of life are typically in the few nanometers range, our ability to gain insights into many biological systems is severely compromised. Expansion microscopy obtains a higher resolution by physically expanding the sample. This results in resolutions up to 10x better than with traditional microscopy.” While expansion microscopy has shown its potential, the technique is still in its infancy. Problems such as signal loss due to poor crosslinking need to be solved.” The Hofkens Lab is working towards a linker chemistry approach that allows the simultaneous readout of different cellular biomarkers, while better crosslinking individual molecules to the polymer matrix. Linkers and protocols are shared with colleagues worldwide for fast progress in this field.
Another research line involves metal halide perovskites. “These semiconductor materials attracted considerable attention, because of their high compositional freedom and unique electro-optical properties, in combination with low-cost fabrication,” Hofkens explains. “They are extremely promising for applications such as solar cells, LEDs and photodetectors. Fundamental understanding
of their properties is key to understand why they work so well. Establishing the structural changes and the charge carrier dynamics of metal halide perovskites under influence of external stimuli (light, temperature, humidity) at high spatial and temporal resolutions will further improve their efficiency.” This research is conducted in tight collaboration with KULeuven colleagues Debroye and Roeffaers as well as with the Max Planck Institute for p olymer research in Mainz.
Currently the Hofkens laboratory works on optical trapping, also known as optical tweezers. This microscopy technique allows literally ‘catching (or trapping)’ of small objects (nano particles, cells...) in solution, much like a tweezer, and resulted in a Nobel prize for its inventor, Prof. Ashkin. “We observed that the trapping surprisingly vastly expands beyond the focused laser spot when applying this technique at interfaces, resulting in nanoparticles that move like swarms of birds, a completely new phenomenon,” Hofkens explains. Through purpose build advanced microscopy, they start to understand the underlying physical principles. Together with imec and partners from other European universities the Hofkens team now investigates if these insights can be used to build cheap and ultra-high density colloidal memories (through EIC Pathfinder project FastComet), highly needed with the widespread digitization of business operations, healthcare, science and personal devices, with an expected 181 zettabytes of data generated by 2025.

A decade ago, the Hofkens Lab developed Fluorocode, a new metagenomic approach for the rapid and high-performance profiling of the microbiome. Due to its -still not fully decipheredinterplay in human health and disease, the human microbiome has been a topic of extensive research during the past two decades. The discovery of new biomarkers, therapeutic targets, drugs as well as routine testing require high volumes of high-quality data to cut through the noise. Better, faster, and cheaper analytical technologies are needed to unlock insights and tap into the microbiome’s full potential for health and wellness such as the one Hofkens and his team develop.
The Hofkens Lab repurpose methyltransferases and developed in-house a method to fluorescently modify the enzymes’ substrate S-Adenosyl Methionine (SAM), to fluorocode metagenomic DNA. Fluorescence along DNA fragments >20kbp form robust taxonomic barcodes with strain-level resolution. This code can be resolved using optical mapping using fluorescence microscopy. Through proprietary analysis code, these fluorescent barcodes are scanned and assigned to the source organism, as such profiling the microbiome with throughputs easily ranging in the gigabase scale. The research efforts, originally funded by an ERC Advanced Grant, resulted in establishing the company Perseus Biomics. This spin-off biotech company is developing DynaMAP, the technology platform based on Hofkens research. Perseus Biomics develops DynaMAP both as a metagenomic service and an integrated benchtop laboratory device.
Perseus owes its name to a binary star. “It is a reference to us from a joint project between the Hofkens Laboratory for Photochemistry and Spectroscopy at KU Leuven and the Ecole Polytechnique Féderale de Lausanne. This started in 2012 and led to the creation of Perseus four years later. Meanwhile, it already employs 25 people. Thanks to a recent round of investment, this could become 35 in the near future. Most employees are postdoctoral researchers or working on their PhDs. There are also lab technicians and some engineers, of course.” In addition to its headquarters in Tienen, Perseus has an IT department in Poland.

Hofkens Lab - KU Leuven
Celestijnenlaan 200F - bus 2404
Chem & Tech Building - B-3001 Heverlee
Tel.: +32 (0)16 32 78 04
Email : johan.hofkens@kuleuven.be
https://www.hofkenslab.com/
Perseus Biomics
https://www.perseusbiomics.com


“We immediately put research results into practice and education”
As a specialised third-line hospital, the Antwerp University Hospital (UZA) stands for innovation and the latest techniques and treatments. In addition, the hospital is a reliable partner for cooperation with other healthcare providers and medical companies. The UZA also conducts groundbreaking scientific research with an international dimension. “Sharing expertise and resources offers many advantages. First and foremost for the patient.”
With 573 beds and some 717,000 consultations and 50,015 day admissions annually, the UZA is a midsize hospital by Belgian standards. In 2017, the UZA was the first European hospital to gain Magnet® recognition.
This is the highest form of recognition for nursing care worldwide. “As a university hospital, we have a wide range of specialized treatments. Much of our added value comes from top expertise for complex and rare syndromes. In doing so, we play a pioneering role in the wider region, both in diagnosis and treatment,” says CEO Prof. Dr Marc Peeters. “In addition, we promote ‘evidence-based medicine’: medicine based on scientific evidence. Science, training and innovation are essential, and that also ensures that our health care delivery improves for every patient.”


In fact, according to the UZA, that care delivery is best done by working together with general hospitals. The days of being each other’s competitors are definitely over. Just look at the Helix network. The future is therefore all about synergy. “Not only with hospitals, but also with companies operating in the medical sector. The aim is to form an integrated system, say a kind of ‘Antwerp Health Harbour’: an Antwerp innovative health hub in which all healthcare actors in the region work closely together.”
Essential for a university hospital is the training function. “Not only for doctors, but also for nurses and paramedics. That is why we have a close relationship with the University of Antwerp and its Faculty of Medicine and Health Sciences, as well as with the asso ciated colleges.”

Besides care and training, basic and translational research is also a main task in a university hospital. “When we conduct research, we immediately take the results into practice. To treat patients better, but also to enrich education. So the ‘bench to bedside and back’ principle applies here to the maximum extent. The time and resources necessary for continuous training and research are structurally embedded in our organisation. Furthermore, our staff takes on social responsibility from their clinical, pedagogical and/or scientific expertise.”
In 2021, 423 clinical protocols were submitted to the Ethics Committee. That year, 15 UZA employees defended their doctorates in medical sciences at the University of Antwerp. “We also participated in 20 externally funded projects at that time. We also receive many requests from companies to test new drugs. A total of 307 academic and 116 commercial studies were involved.” Within oncology alone, there are more than 100 studies running every year.
Over the years, the UZA built a strong reputation around oncology research. Just think of the research into new biomarkers and microtumours conducted at the Medical Genetics Centre and at the Centre for Oncological Research (Core).
The university’s Life Sciences campus connects to that of UZA. Cooperation between the hospital and the university manifests itself in joint project teams, such as oncogenetics. The university hospital and

the university want to further structurally streamline and intensify their research and innovation cooperation. “One way to do this is a joint valorisation manager. Currently, patent applications, the establishment of spin-offs and contacts with industry still go through two separate legal entities. It is not always clear who should take the lead.”
“On the joint campus, there is still plenty of space available for new initiatives,” Peeters says. “Not only for spin-offs, but also for infrastructure for sports physiology research.”
During 2022, the UZA opened the University Clinical Research Centre Antwerp (Uniccra), the renovated centre for early clinical studies. It is twice the size of the former research unit. “Here we follow up the very first treatments with new drugs. In addition to a completely new day hospital, the centre has an integrated laboratory and more space to bring together specialised teams. The aim is to give patients access to drugs that often won’t come on the market for several years.”
The centre is for all clinical trials. “We do focus there on phase 1 and phase 2 studies. These early studies are very labour-intensive and require specific expertise from study staff. Precisely because the drugs are so new, patients have to be followed up closely. But even in phase 3 studies, it is important to pick up all signals immediately.”
Uniccra is equipped with a completely new day hospital with a monitoring system, an integrated laboratory and a kiosk that allows patients to measure all their blood pressure, pulse, oxygen saturation and weight by themselves. Currently, the majority of phase 1 studies consist of cancer patients. “But we want to make the centre available to researchers and patients from all disciplines, both internal and external. The research centre should be an incubator that helps us bring even more studies to our region.”
In 2022, the University of Antwerp opened the research centre Vaccinopolis on their campus in Edegem, specially built for testing vaccines against numerous infectious diseases, such as RSV, dengue or whooping cough. This can further ac celerate the fight against new and existing diseases - such as influenza. Test subjects first receive a vaccine or placebo and then a reduced dose of a pathogen. This allows researchers to test w hether and how a particular vaccine candidate works in an accelerated manner. There is no comparable facility of that size in continental Europe. Vaccinopolis has thirty beds. In some studies, test subjects will spend several weeks in complete quarantine. This is done for safety reasons: the pathogens must obviously not be allowed free rein in society.
Care teams at UZA examine more than 15,000 patients with rare diseases every year. Prof. Dr. Marc Peeters stresses that UZA is strongly committed to their diagnosis and treatment. “According to European research, patients with a rare condition give care a higher rating when the multidisciplinary care team participates in a disease management programme. We therefore share our expertise and knowledge on rare diseases in 15 of the 24 European Reference Networks (ERNs). When healthcare providers share expertise and experience, patients with rare diseases get a correct diagnosis and better treatment faster.”




UZA
Drie Eikenstraat 655 - B-2650 Edegem
Tel.: +32 (0)3 821 30 00
Email: vragen@uza.be - https://www.uza.be/

The University of Antwerp awards nearly 250 PhDs every year. It has 23,202 students, 17.5% of whom are from other countries. Together, its nine faculties offer 146 programmes, 29 of which are entirely English-speaking. Together, they also pool a wide range of fundamental and practice-oriented research.
UAntwerpen came about in 2003 through the merger of three existing university ‘centres.’
Yet it is no youngster in higher education in Flanders. Its seeds were sown as early as 1852. “Incidentally, the three university centres had been working closely together long before 2003,” explains vice-rector for research and biologist Ronny Blust. “Back then, some courses overlapped and a significant part of the candidate courses (today: bachelor’s) were taught in a different university centre than the master’s courses. Today, none of that remains. We have logically grouped the various fields of study we offer across the three campuses. The younger generations can still barely picture the original structure with three institutions. This shows that the merger has been particularly successful.”
That logic means that the human sciences are housed on the City Campus, partly in restored or renovated buildings with a long historical background. For example, the students of economics, social sciences, arts and philosophy and law, among others, are located in the centre of the old town, the city hall and the city archives. Medicine and biomedical sciences students house at the Drie Eiken Campus, which is adjacent to the University Hospital Antwerp (UZA). “We are developing this site into a Life Sciences campus, while the Middelheim-Groenenborger site continues to profile itself as a Sciences & Technology campus,” says Blust. “At Campus Groenenborger, we are currently building out a new home for our Chemistry Department.”

“The research conducted at the University of Antwerp has a strong fundamental basis. In some fields, we are among the best in the world. But we don’t stop there. It is equally important for us to translate scien tific knowledge and insights into applications of social and economic importance. Today’s society has numerous challenges both at the level of ecology, health, sociology and economy.”
The research strategy is homogeneous and balanced for the university as a whole. “The University of Antwerp has 15 research excellence consortia (OEC), active in various scientific disciplines. They are international signposts that bring together consortia of outstanding researchers. Each OEC has a research manager who supports the consortium’s research strat egy and plays a crucial role in identifying and raising funding opportunities.”
“In this way, we also pool our research infrastructure as efficiently as possible and can provide our researchers with top infrastructure. This does not alter the fact that certain essential infrastructure remains available in multiple locations. The core facilities are bundled per area of expertise, but for other equipment a distributed setting proved more appropriate. Although the core facilities are concentrated within certain strategic research groups, other researchers can also use their infrastructure. This fits in with our multidisciplinary approach.”


Research funding is channelled through four channels. “Besides the Flemish government’s basic investment for university education, there are also subsidies through various Flemish, Belgian and European initiatives. These are awarded very competitively,” explains Blust. “We encourage and support our researchers to submit applications for these. Such research projects can leverage new ideas and strengthen the university’s image in the outside world. The resources of the Special Research Fund (BOF) also allow us to attract new research professors, further strengthening research and stimulating new initiatives and fields.”
Internationally, UAntwerpen focuses on certain research areas. “For example, our EMAT team is a global leader in materials research and electron microscopy. Our expertise in infection and vaccination research within the Vaxinfectio group is also world-class. Consider, for instance, the brand-new vaccine research centre Vaccinopolis, a unique facility in continental Europe. In genetic and cancer research, environment and climate, sustainable chemistry, digital data and communication, social and political policy, we are also very strong. In the Times Higher Education World University Rankings, we have been moving up considerably in recent years. We are now ranked 161 worldwide there. For a university of our scale and young history, that is a place we can be very satisfied with. Our international appeal is also reflected in our participation in various European Union-supported research projects by academic institutions and partners from different countries, and the increasing visibility and impact of UAntwerpen in society. Our investments in buildings and infrastructure where researchers and companies can think and work together such as BlueApp and The Beacon will further strengthen this in the future.”
In Flanders itself, research is further underpinned by collaborations with federal and regional institutes and agencies, and increasingly with industry. As far as applications are concerned, such collaborations are mainly via the Industrial Research Fund (IOF). This way, we do not stop at continuous fundamental research, but immediately create openings to practical applications. We therefore ensure that expertise from the outside world is brought into a number of our advisor y committees and decision-making bodies.”
AIPRIL
Antwerp Interdisciplinary Platform for Research into Inequality
CASCH
Catalysis for sustainable organic chemistry
DIGITAX
Digitalisation and Tax
EXPOSOME
From exposome to effect assessment of contaminants in human and animal models
GCE
Global Change Ecology
GENOMED
GENOmics in MEDicine
GOVTRUST
Trust and distrust in multi-level governance: causes, dynamics, and effects
INFLA-MED
Fundamental and translational research into targets for the treatment of inflammatory diseases
IPPON
Integrated Personalized & Precision Oncology Network
μNeuro
Multidimensional analysis of the nervous system in health and disease
MST
Microbial Systems Technology
NANOLAB
Bringing nanoscience from the lab to society
PLASMA
Plasma for environmental, medical, analytical chemistry and materials applications
RCRC
Research Centre on Representatives and their Communication
VAX-IDEA
Vaccine & Infectious Disease Institute
Antwerp University (UA) and Antwerp Univeristy Hospital (UZA) recently applied for a patent for an optimised version of the bag-in-the-lens (BIL) application aiming at restoring vision and accommodation after cataract surgery.
Its first version was developed more than 20 years ago by Prof. Dr Marie-José Tassignon, who also led the research for the updated solution. Thanks to numerous operations with her bag-in-the-lens technique, Social Security saved a lot of money on YAG laser capsulotomy, necessary after classic lens-in-the-bag implantation.
At the time, Tassignon was department head of ophthalmology at the UZA and head of the ophthalmology lab at the University of Antwerp. Since her retirement, her official role has been consular. “The essential feature of the new solution is that it is no longer monofocal. A patient no longer has to choose optimal distant or near vision, both should now be possible at the same time,” she explains. “We are currently in discussions with some companies that want to bring it to market. Meanwhile, the original version is in the public intellectual domain.”

available anatomy of the capsular bag. But the human eye has multiple axes, such as the visual axis and the pupillary axis.
“A multifocal intraocular lens placed according to the wrong axis causes distortions in the image. Our solution is the only one that can avoid this. With current techniques, those axes are now measurable.”
“The BIL, primarily introduced to prevent posterior capsule opacification (PCO), reached 100% success in adult eyes and almost 85% in paediatric eyes, which is exceptionally high. Compared to the traditional lens-in-the-bag technique, it also shows particularly good outcomes regarding postoperative macular edema and retinal detachment.” An inserted artificial lens is a foreign body but, in the BIL concept, immune reactions almost cannot occur because the lens has almost no contact with cells of the recipient.
Research continues
In the research, Tassignon brought in her own surgical expertise, gained during numerous years of practice. “The approach was very multidisciplinary. I worked closely with Dirk Van Dyck, the former vice-rector of innovation at Antwerp University. As a physicist, he is an expert in the diffraction of light. Also essential was the contribution of Laure Gobin, engineer in biomedical optics. Her input resulted in the development of the toric version of the bagin-the-lens, which corrects corneal astigmatism (see photo).”
Traditionally, the new lens is positioned in the capsular bag of the eye lens. “We reversed this principle by placing the capsular bag inside the lens,” she says. “In the past, the anterior interface, located between the posterior capsule and the anterior vitreous hyaloid, was considered a virtual interface which is why cataract surgeons in training were taught never to touch the posterior capsule. This dogmatic education was unfortunately based on the poor knowledge of that anterior interface by their seniors.” Tassignon took benefit of this anterior interface to implant the bag-in-the-lens.
Bag-in-the-lens placement provides the surgeon with an additional degree of freedom to choose the optimal location for the implant. In traditional surgery, implants are positioned according to the
Research is still ongoing. “We calculate the ideal strength and location of the lens based on a number of parameters. The current formulas are suitable for the vast majority of the population. But for people with exceptional eye size, unusual lens thickness or curvature of the cornea, we need to find a modified calculation. This group of ‘outliers’ is becoming increasingly recognisable.
“We also made a lot of progress in recent years in tackling hereditary cataracts in children. We were the first to define a specific entity of congenital cataract and are now trying to find its cause. Today, hereditary cataracts should be diagnosed even before birth thanks to the refinement of pregnancy ultrasound imaging.”

Department of Ophthalmology
Antwerp University Hospital
Drie Eikenstraat 655
B-2650 Edegem-Antwerp
Antwerp University Middelheimlaan 1
B-2020 Antwerpen
Tel. +32 (0)3 821 4803
E-mails: Marie-jose.tassignon@uza.be tassignon@unusual.be http://www.uza.be/oogheelkunde
The Loeys-cardiogenomics lab aims to contribute to the further elucidation of the genetic and mechanistic landscape of thoracic aortic aneurysm, with the ultimate goal of improving patient management.
Its ongoing research lines are contrived in a way its results should increase the molecular diagnostic yield, improve genetic counseling, and identify predictive markers and develop curative therapies. Together with an American colleague, Bart Loeys discovered a previ ously unknown form of aortic aneurysm, which now bears their name: the Loeys-Dietz syndrome. This discovery framed his research into Marfan syndrome - a specific weakening of the aorta - and related diseases, which contributed greatly to a better understanding of the genetic mechanisms that cause aortic damage.
The lab has a longstanding tradition in the use of DNA sequencing technologies to find novel thoracic aortic aneurysm genes. Besides traditional molecular biology approaches, the current research projects involve the use of state-of-the-art techniques such as whole genome sequencing, transcriptomics and interactomics/proteomics in patient samples, induced pluripotent stem cell-derived vascular smooth muscle cells and/or mouse models. “By profoundly mapping the downstream functional consequences of gene mutations, we aim to identify genetic modifiers and pinpoint novel drug targets,” says team leader Prof. Dr. Bart Loeys.
In an aneurysm, part of a blood vessel is abnormally dilated. Such a dilation occurs unnoticed and usually causes no symptoms. As the aneurysm grows, the aortic wall becomes increasingly weak and can rupture even at normal blood pressure, resulting in life-threatening bleeding. “We are looking for innovative solutions to test better treatments faster in aortic models. One obstacle is that we do not yet have a good human model. We now use mouse models, but drugs that seem safe and effective for mice may be ineffective or even harmful for humans. As an intermediate step, we want to develop a human aorta on a chip - a 3D complex of cells that mimics the real aorta. From the patient’s white blood cells, we make stem cells, which we differentiate into the various cell types in the aortic wall. We are now trying to bring those cell types together on a chip containing mini-channels so that we can irrigate the cells to mimic blood flow or to test candidate drugs.”
In mice, it was shown that a high dose of losartan can stop aortic dilation. “But in humans, oral administration of such a high dose of losartan results in side effects that are too severe. Therefore, a method is needed to administer losartan very specifically, so that it acts specifically on the diseased parts of the aorta. Therefore, we are now testing in mice first the use of nano-particles loaded with losartan. By chemically ‘labelling’ these particles, we send them specifically to

the diseased spot in the aorta and investigate whether they can better prevent aneurysm formation there. We also want to test this later in the aorta-on-a-chip, before setting up clinical trials with patients. Impor tantly, the use of nanoparticles in humans has already been approved. Once we succeed in developing an effective ‘address label’, we can start using them on humans.”
Together with patient organisation F101G-foundation, Bart Loeys is leading the international GEMS project (Genome-wide Epistasis for cardiovascular severity in Marfan Study), “We identified one specific genetic FBN1 variant that causes a very variable clinical picture in Marfan patients worldwide: from aortic dissection at a young age to completely normal aorta in later life. Based on whole genome sequencing and study of the stem cells of patients with these extreme presentations, we hope to identify the genetic modifier(s). “Its discovery may lead to new therapeutic pathways to prevent aneurysms.”

UZA/UA Center of Medical Genetics - Cardiogenomics
Prins Boudewijnlaan 43/6 - B-2650 Edegem
Tel.: +32 (0)3 275 97 64 - Email: bart.loeys@uantwerpen.be
http://www.genetica-antwerpen.be / http://www.loeyslab.com
Thanks to patient organisations and European incentives for research into pathophysiology and therapy, over the last decade rare diseases have received growing attention. In the set of rare diseases, mitochondrial diseases are one of the largest and most frequently occurring subgroups. The Mitochondrial Investigations Laboratory on the Ghent University Hospital campus aims to unravel pathophysiological mechanisms of these disorders and has engaged in a new route of therapeutic opportunities.
Mitochondrial diseases are challenging to identify as they can affect almost any organ, in any combination and symptom onset can appear at any age. Currently, for most of these disorders no curative treatment is available. Receiving a final diagnosis after a long odyssey is for most patients a relief even if no curative options can be offered. The Mitochondrial Investigations Laboratory was founded in 1995, by prof. dr. Rudy Van Coster. “He set up this laboratory after achieving his PhD at Columbia University, New York, on the topic of OXPHOS and PDH deficiency,” says prof. dr. Arnaud Vanlander, the current head of the laboratory. “Rudy Van Coster profiled the lab as the national reference centre for biochemical evaluations of mitochondrial functioning and subsequently expanded its fame via many international collaborations. Initially the laboratory focussed on diagnosing mitochondrial diseases in patients and discovering new mitochondrial diseases. Today, the lab strengthens its diagnostic performance by implementing new techniques. It also enlarged its activities by further exploration of pathophysiological mechanisms and by searching for appropriate targeted therapies.”
With the advent of genetic tools becoming largely available, diagnosing rare diseases has become more straightforward. “Genetic results however are not always easy to interpret and sometimes ask for confirmation. Here, biochemical analyses add value.” The Mitochondrial Investigations Laboratory can explore pathogenicity of genetic variants, by assessing enzyme activities, evaluate oxygen consumption, cell viability and perform targeted microscopic analyses as well as proteomics analysis.

A subgroup of mitochondrial diseases encompasses the group of mitochondrial amino-acyl tRNA synthetases deficiencies (aARS2). “The diagnosis is often easily made by genetic analyses. However, much about the pathophysiology of these diseases remains to be discovered. Even within one family the clinical presentation can vary substantially between individuals. To find what causes this variability, a zebrafish model of aARS2 deficiency was set up in order to try to unravel the biochemical background of the disease, using multi-omics tools, and evaluate why some organs are more prone to aARS2 deficiency than others. Moreover, the aARS2-deficiencies are possibly an actionable group for treatment strategies. Aside of the research on pathophysiological mechanisms, the zebrafish model is used to explore treatment options to be extrapolable in men.”
To improve management of mitochondrial disorders, the lab aims to open a new research pipeline, exploring the possibilities that neuronal induced pluripotent stem cells can offer in diagnostics and pathophysiology research in mitochondrial diseases. As the central nervous system involvement constitutes an important disease burden in mitochondrial diseases, modelling the disease in neuronal cells will potentially offer better insights on its dysfunction and how this can be reversed.
Finally, the Mitochondrial Investigations Laboratory has many running collaborations with other research units in Belgium and abroad, asking to explore the role of mitochondrial dysfunction in particular diseases. Also, evaluation of potential toxicity of pharmaceutical compounds on mitochondria, i.e. mitotoxicity, yielded several frequently referenced papers.
In the field of mitochondrial medicines still much has to be discovered. The Mitochondrial Investigations Laboratory has engaged to contribute to this quest, utilizing the latest research technologies.

Mitochondrial Investigations Laboratory
UZ Gent, Blok B (entrance 36)
C. Heymanslaan 10 - B-9000 Gent
Tel.: +32 (0)9 332 24 89
Email: mitolabo@ugent.be
https://www.uzgent.be/patient/zoek-een-arts-of-dienst/neurologie-enmetabole-ziekten-kinderen/laboratorium-voor-mitochondriaal-onderzoek
Axes Health was founded in 2019, by Katrien Van Geyt. Before, she gained more than twenty years of experience in the biopharmaceutical industry. With her background as a pharmacist, she has always been passionate about the development of innovative medicines. The creation of Axes Health is the result of her dedication to patient access.
 Katrien Van Geyt, founder of Axes Health
Katrien Van Geyt, founder of Axes Health
“
The core objective of patient access, and consequently Axes Health is to ensure that patients in need have a timely and sustained access to new, innovative medicines and technologies,” Katrien Van Geyt says. “However, today’s patient access environment is becoming more and more chal lenging. To minimize the risk of clinical uncertainties and safeguard the healthcare budget, national authorities (payers) want to see increasingly compelling evidence. For some innovative medicines this evidence is missing at the time their marketing authorization gets approved by the European Commission.
Meanwhile pharmaceutical companies want payers to look beyond price, acknowledging the value and rewarding innovation. Axes Health was founded to overcome this patient access challenge by bridging the gap between the various stakeholders and co-creating solutions in conjunction with patient groups, national authorities, local experts, academia and the biopharmaceutical company.
The Axes Health-team is composed of integer, highly driven and solution-oriented people with a background in pharmaceutical sciences. Most of them obtained a PhD. “Our clients are biophar maceutical companies, mainly headquartered in Europe, with no or very little insights in the Benelux healthcare ecosystem, that want to bring their innovative healthcare solutions to the Benelux market,” Van Geyt explains. “We embrace working in cross-functional teams. We also believe in the power of collaboration throughout the product life cycle, embedding patient access from clinical development towards the creation of real word data. Hereby, we strongly focus on early-stage dialogues with all in volved stakeholders: patient groups, national competent authorities, aca demic institutions, healthcare providers, clinical experts and biopharmaceutical companies.”
“Using this personalized and collaborative approach, we obtain clear insights in the healthcare landscape, the needs of all stakeholders and the opportunities they offer. This is our base for the development of a patient access strategy focused on demonstrating real value.”
“Typical deliverables we offer, are a real-world data generation plan to address the clinical uncertainties of newly developed inno vative medicines, an early access program to reduce the waiting time for patients to get treated, a pharmacotherapeutic and pharmacoeconomic analysis for requesting pricing and reimbursement at the local competent authorities, and an innovative payment scheme to address budgetary uncertainties.”
One of our recent success stories was to get reimbursement in Belgium for a medicine which allows patients to receive a kidney transplant. Without this innovation, these patients would reject the donor kidney and would be lifelong on dialysis. With the support of a cross-functional team, we were able to discuss with the authorities that reimbursing this innovative treatment is not only a game changer for patients, it also saves money for the healthcare system by avoiding dialysis.
We support biopharmaceutical companies to take up a role as a healthcare partner rather than solely a product supplier. That’s why we also support our clients in working together with the healthcare professionals and patient groups in setting up services and solutions that can help patients better manage their disease and improve treatment adherence.
“Being born in Belgium and having studied in Ghent made the choice for Ghent as location evident. Apart from that, we should be extremely proud with Belgium as one of the foremost biopharmaceutical areas in Europe. The fact that Belgium is the number two in Europe in clinical trial applications is very helpful in our work. The entire value chain of the life sciences industry is represented here, from research and discovery to development and commercialization.”

Axes Health
MeetDistrict
Ottergemsesteenweg-Zuid 808
B-9000 Gent
Tel.: +32 (0)475 75 26 46
Email: info@axeshealth.com
http://www.axeshealth.com

In its more than two hundred years of existence, Ghent University has built up a solid scientific reputation. It invests in both fundamental and high-risk as well as applied research. Consequently, Ghent University is highly regarded internationally for its expertise in life sciences, (animal) medicine, materials science, agricultural and sports sciences, psychology and history.

Research is the engine of Ghent University. The results of this research have an impact on society at large. The research gives new impulses to education and lays the foundation for a progressive knowledge society. In the period 2008-2021 alone, this led to the creation of 91 spin-offs and the granting of 1.661 patents.
The top can count on a solid basis: thanks to a bottom-up research policy, young researchers are given the necessary opportunities to grow. Thanks to the excellent performance of its entire research community, the university has been ranked since 2010 in the top 100 of the Shanghai Ranking - a worldwide ranking based on research indicators - for many years. Currently, it is the highest ranked Belgian university (84th worldwide). It is also exploring new horizons in interdisciplinary research. This interdisciplinary approach is mainly expressed in the ten specific interdisciplinary research centres (IDC) established within Ghent University.
The IDCs are funded through the university’s Special Research Fund. In addition to interdisciplinarity, they also pursue transdisciplinarity and cocreation with non-academic stakeholders. Thus, the IDC Psync is a model for a new form of research collaboration on mental health. Gray (Ghent University Research for Aging Young) is an IDC aimed at boosting healthy ageing through translational research, social impact and valorisation of new solutions, interventions, products and services. This IDC brings together expertise in the biology of ageing, health promotion, healthy behaviour
(exercise, nutrition, mental wellbeing and cognitive behaviour), geriatrics, environments that encourage healthy ageing and the use of adaptive technologies within the field of ageing.
In addition to the IDCs, there are the IOF platforms. These platforms stand at the intersection of different research domains and have an eye for the innovation needs of industry. In this way, they meet the growing social and economic importance of interdisciplinarity. The IOF network consists of a number of business development centres that bring together complementary research departments per application area or domain of expertise. Each centre is responsible for technology transfer within its area of competence.
The Belgian zone of interest in the North Sea is much smaller than that of the other coastal states, but it is intensively used. By shipping, for various submarine cables, for fishing, mussel farming, sand extraction and for offshore electricity production by wind turbines. Ghent University is actively involved in researching the various economic and ecological aspects of the blue economy. On its Ostend campus, the university invests in labs and personnel through the company Greenbridge. In addition, together with the port and the province of West Flanders, the university has founded Ostend Science Park, which will build a blue science park. By allowing more expertises to work together and linking them, the university wants to reconcile the values of ‘good for the ecosystem’ and ‘good for the economy’. Among other things, it is trying to find out whether artificial oyster reefs break the waves, so that it would no longer be necessary to blow up sand to keep the Flemish coast intact.

A team is analysing the microbes in water to improve the health of farmed fish and shrimps. By taking snapshots of the bacteria in the water, the scientists can detect infections early and take preventive action against diseases. As a result, the use of medication can be reduced and mortality among young fish can be reduced. In fish farming and other forms of aquaculture worldwide, up to 80% of young animals still die during the first two to three months. The researchers at Ghent University are making the animals healthier and stronger by monitoring the water quality, optimising the diet and reducing stress. They are also looking for alternatives to antibiotic use, for example by working with probiotics and with plant components such as green tea extracts.
Ghent University is project leader in four and partner in nine of the twenty projects of the latest Belgian Energy Transition Fund (ETF). The goal of the ETF is to encourage and support research, development and innovation in the field of energy within the federal energy competences. Each year, a call is launched to submit projects that fall within three specific themes: renewable energy sources in the North Sea and biofuels, nuclear energy applications and security of supply and grid balance. Ghent University expertise in this area is mainly concentrated in the Ghent University valorisation consortia EnerGhentIC (energy transition) and Metals (metals). It is supported via the Ghent University Hydrogen Platform. The MuSE (Molecules at Sea) project looks for opportunities to import renewable molecules, such as hydrogen, methanol and methane from offshore energy production. This research examines both the technical and scientific obstacles and opportunities and the socio-economic and legal framework, with a view to a circular economy. Ghent University also leads BLEEPID, a project for the development of new techniques to optimise the maintenance planning of the blades of offshore wind turbines by means of drone inspections, thus extending their lifespan. Through CO2MBS, Ghent University and its project partners want to examine the extent to which CO2 from, for example, gas-fired power stations can be reused to make synthetic methane together with hydrogen and whether this can then be efficiently integrated into the Belgian energy system. HYSource is a research project into the possible use of existing pipelines to transport hydrogen.


Pivfi Dracarys Di08, born in the summer of 2023, is the first IVF foal in Europe. In vitro fertilisation (IVF) is quite a challenge in the horse. Pivfi Dracarys Di08 represents the second successful attempt in the world and the first in Europe. After SmICSI in 2009 and VICSI in 2017, this is the third ‘first foal’ at the Department of Di08 at Ghent University’s Faculty of Veterinary Medicine. This foal, a healthy colt, is the result of dr. Marion Papas’ postdoctoral research, led by clinic head Jan Govaere, Prof. Katrien Smits and Prof. Ann Van Soom of the Department of Internal Medicine, Reproduction and Population Medicine.
Because IVF is so difficult in the horse, test-tube foals currently are made by intracytoplasmic sperm injection (ICSI). This technique is also used clinically in the equine clinic of the Faculty of Veterinary Medicine. Oocytes are collected from genetically valuable mares through ovum pick-up (OPU) and after fertilisation with ICSI, the embryos are grown in the lab until they can be transferred to a receptor mare.
This clinical OPU-ICSI programme is the base for further research into artificial reproductive techniques led by Katrien Smits and Jan Govaere. The clinical application of IVF needs further improvement and is the subject of future PhD projects.

The new Coastal & Ocean Basin (COB) in the Flanders Maritime Laboratory in the Ostend Science Park is the newest tool to support the scientific community in its efforts to tackle climate change and come up with countermeasures to protect coastal communities and offshore investments, such as wind turbines or infrastructures for the breeding of oysters and mussels.
The COB is a joint initiative of Ghent University, KU Leuven and Flanders Hydraulics Research (FHR). This wave tank is able to reproduce wave, current, and wind conditions, offering an unprecedented opportunity for researchers and industry to take a closer look at ocean hydrodynamics, and the structural response of coastal and offshore structures. It also enables them to advance marine renewable energy technologies and to validate numerical models. The construction works started in 2017 and the facility is operational since early 2023.
Acceleration in sea level rise and increased intensity of storms have put coastal populations at risk, and pushed the scientific community to come up with better solutions through designing coastal protection structures, developing new ocean renewable energy technologies, or implementing nature-based solutions.

“In any case, designers have to go through the integrated research methodology, which combines both numerical and physical scale modelling,” say Prof. Dr. Peter Troch (Ghent University), who coordinates the COB.
“Flanders has experimental infrastructures at Ghent University and FHR, with a limitation to relatively small-scale experiments. Therefore, and to cope with the emerging needs, a consortium led by the civil engineering department at Ghent University, in partnership with KU Leuven and FHR secured funding for a new state-of-the-art test facility. The COB is designed to cover a wide range of physical modelling needs while minimizing operating costs. This results in a large range of opportunities for academic research and for governmental and private sector projects.”
“Starting with coastal engineering, scale experiments will offer valuable data on the wave impact loading of structures, the prediction of wave overtopping over dikes and breakwaters and damage to coastal structures. Emerging marine renewable energy technologies including offshore wind, floating photovoltaics and tidal and wave energy converters will be also tested in the COB. Moreover, interdisciplinary work that combines marine ecology with engineering will help shape the role of seagrass vegetation and natural reefs with their habitants. The civil engineering department at Ghent University focuses on these applications. Traditional work of this department concerned wave overtopping, wave energy converters and scour protection. It also pioneers in coastal defences and wave attenuation by vegetation.”
The Flanders Maritime Laboratory also hosts a towing tank (174 m x 20 m). This combination offers a unique opportunity to perform multipurpose tests within the same facility, which will create strong research synergies. The COB laboratory consists in a large technical facility housing the
basin and the accompanying systems to operate it. The main wave and current basin covers an area of 900 m² (30 m x 30 m). It is operated by four components: a wave generator, a current generator, a wind generator and a water transfer system. “A fully automated data acquisition system ensures smooth and perfectly controlled set-up, start-up and management of all testing scenarios. Auxiliary systems that improve the efficiency of the experiments have been also installed. These include an access bridge, a crane, an operation control room and a workshop.”
The COB’s most crucial mechanical system is the wave generator. “It was designed according to the typical physical modelling scenarios that will be performed. The wave generation system is composed of relatively narrow wave paddles, capable to generate very realistic waves in any direction. The L-shaped configuration of the wavemaker covering two sides of the basin, enables to test a large variation of short-crested wave angles. Coupled with the reversible current generation system, it can achieve any desired relative angle between the generated current and waves.”
The dimensions of the basin combined with the wide range of hydrodynamic conditions to be reproduced places the COB in a leading position on the global scale in terms of both coastal and near offshore experimental setups. “The COB offers a variable water depth ranging from 0.4 to 1.4 m, enhanced by a central pit with a maximum water depth of 4.0 m. Multi-directional wave generation with a maximum height of 0.55 m is targeted, together with a full spectrum of wave-current interaction, with currents of up to 0.4 m/s,” Troch explains. Compared with currently operational wave basins in other European countries, the COB stands out clearly with regard to the relationship between maximum water depth and capability to generate large waves, emphasizing also


on the practical aspects for easy, yet accurate, operation of the facility. Moreover, the COB offers the capability to test offshore scale models for applications in marine renewable energy and offshore engineering.
The COB is capable to generate combined waves, currents and wind loads. “To our knowledge, there are very few facilities which offer combined wave and current generation at any relative angle of prop agation. As a result, until now, experiments regarding combined waves and currents are also scarce.”
The COB’s current generation system is a tailor-made solution, based on the dominating flow conditions in the Belgian coastal waters, characterized by tidal currents with a typical depth-averaged flow velocity of about 1.0 m/s in full scale. “Considering a maximum scaling factor of about 1:8, the flow velocity in the model is scaled down to 0.4 m/s, requiring a total discharge of approximately 11 m³/s. These design parameters place the COB in a leading position with flow velocities that are almost twice the average of the maximum velocity at many other facilities. The current is introduced in the basin through a set of guiding grids flush-mounted in the basin floor. Each grid can be replaced by a lid when the current system is not being operated.


On a part of the North Sea beach, in front of Domain Raversijde, near the Flanders Maritime Laboratory, the Flemish Maritime and Coastal Services authorities, FHR and Ghent University have constructed an artificial test dike. The dike has a length of 20 meters, a width of 17 m and a height of 5 m. It stands on the beach between low and high water. The goal is to gain more insight into the impact of storms on our coastal protection in order to make it even more efficient.
“It can seem strange to place a dike on the beach in front of the real sea dike,” says Peter Troch. “However, the location was chosen carefully. Only in extremely severe storms do the waves overtop the existing dike. In order to measure the impact of the waves on the sea dike in the short term, we built the test dike with a lower crest elevation on the beach. Sensors on the test dike measure wave overtopping and wave loads. A wave buoy in deeper water and three measuring poles in the intertidal area – the zone that remains above water at low water and submerges at high water – measure the wave transformations up to the test dike. By gaining more insight into the processes of wave overtopping and forces, our authorities will be able to make coastal protection more safe.”
Prof. Peter TROCH
Coastal & Ocean Basin - Flanders Maritime Laboratory Wetenschapspark 8
B-8400 Ostend
Tel.: +32 (0)9 264 54 89
Email: Peter.Troch@UGent.be
https://www.cob.ugent.be


The Centre for Primary Immune Deficiencies Ghent (CPIG) is a multidisciplinary platform including clinicians, clinical biologists, geneticians, paramedics and researchers (Ghent University) treating patients with inborn errors of immunity. CPIG coordinates the clinical care, diagnostic work-up and research on more than 1,500 paediatric and adult patients with inborn errors of immunity (IEI), previously called primary immune deficiency (PID), followed at Ghent University Hospital (UZG).

Inborn errors of immunity (IEI) are a group of life-threatening genetic disorders of the innate and adaptive immune system. To date, the molecular defect of 480 IEI disorders has been unravelled which has led to significant improvement in the diagnosis and treatment of individual patients. Inborn errors of immunity most often lead to increased susceptibility to severe and/or recurrent infections. In addition, immune defects can also lead to immune dysregulation presenting with autoinflammatory and autoimmune manifestations and lymphoproliferation. IEIs are very complex, heterogenous and rare disorders. As a result, a large number of patients remains undiagnosed lacking appropriate treatment leading to irreversible organ damage and increased morbidity and mortality. This places a heavy burden not only on patients and families, but also on health care systems.
The PID research lab (PIRL), founded in 2015, is embedded in the Centre for Primary Immune deficiencies Ghent (Ghent University and Ghent University Hospital) and builds bridges between clinicians and researchers. Prof. Dr. Filomeen Haerynck is principal investigator of PID research lab and works together with the Inflammation Research Center at the Flemish Institute for Biotechnology (VIB, Ghent) and international collab orators (National Institutes of Health, Rockefeller University, Cleveland Clinic
Research Centre) (US), Imagine Paris (Fr), Gar van (AU)). PIRL accommodates a large biobank of more than 20 000 blood samples of patients with IEI and healthy controls. The Haerynck research team has an outstanding track record on IEIs, including Th17 immune disorders, common variable immune deficiency, auto - and hyperinflammatory syndromes and nucleic acid sensing defects. Prof. Haerynck published more than 138 manuscripts in peer reviewed journals, resulting in a H-index of 39 and more than 9,600 citations.
The PID research lab aims to understand why some children and adults develop severe or life-threatening illnesses with certain microbes, while others exposed to the same microbe do not suffer such outcomes. Additionally, the lab investigates the mechanisms behind uncontrolled immune activation leading to autoinflammatory and autoimmune conditions. Haeryncks lab employs high-throughput techniques studying patient cells, cellular and animal models to establish a connection between newly discovered genetic defects and the clinical symptoms observed in patients with a suspicion of IEI. Revealing monogenic holes in the host defence is pivotal for early diagnosis, genetic counselling of families and for the development of targeted treatments which will save many lives.

Since 2015, CPIG is recognized as a Jeffrey Modell Foundation Diagnostic and Research centre. This recognition was instrumental in putting Ghent University and Ghent University Hospital on the international map in the field of translational and clinical research on inborn errors of immunity. In 2021, the CPIG was recognized as member of European Reference Network for Rare Immunodeficiencies, Autoimmune and Autoinflammatory disorders (ERN-RITA), which is pivotal for additional European clinical and translational research. Among the 72 members of ERN-RITA, only two are recognized in Belgium.
The Haerynck lab studies the human genetic and immunological determinants of life-threatening viral infections and reveals monogenic holes in the host defence.
Herpes simplex virus 1 (HSV-1) infections are very common and usually cause only minor symptoms (Herpes Labialis). In rare cases, the HSV-1 infection goes awry and turns into herpes simplex encephalitis, a devastating brain disease that becomes lethal if left untreated. Haeryncks team, in collaboration with VIB Ghent (VIB Grand Challenge Project) and Gack lab (Cleveland Clinic institute), discovered at first a defect in GTF3A gene, a novel key gene that predisposes to HSV-1 encephalitis. They discovered a pseudogene, once considered ‘junk’ DNA, as an unexpected clue that solved the puzzle. Defects in GTF3A do not induce pseudogenes during HSV infection causing encephalitis. “Our discoveries show in a completely new way how our immune system can protect us against viruses such as herpes. Rather than detecting the virus itself, our immune system recognizes danger signals within our own cells upon viral infection. It helps us to better understand why certain people are selective vulnerable to herpes simplex encephalitis,” explains Prof. Haerynck.
PIRL coordinates for Belgium the international research consortium (COVID Human Genetic effort), led by Prof. Casanova (US) to unravel the immunologic underpinnings of severe COVID-19 in previous healthy children and adults. They discovered inborn errors of type I interferon immunity and autoantibodies neutralizing type I interferon in more than 15% of these patients. These results, identifying the crucial role of type I interferon in the defense against SARS-CoV2 virus, were published in outstanding journals (Science, Science Immunology, Journal of Experimental Medicine,...).
Medical Research Building II (Entrance 38)
Ghent University Hospital
C. Heymanslaan 10 - B-9000 Ghent
Tel.: + 32 (0)9 332 6439
Email: filomeen.haerynck@uzgent.be - pirl@uzgent.be www.uzgent.be/centrum-voor-primaire-immuunstoornissen Filomeen Haerynck (0000-0001-9161-7361) - ORCID
The PID research lab coordinates the multi-centre FEBRIS study; a Flemish joint Effort for Biomarker pRofiling in Inflammatory Systemic diseases. “We integrate cytokine profiles into the diagnostic workup and management of paediatric and adult patients with inflammatory syndromes such as systemic autoimmune diseases, autoinflammatory disorders, or hyperinflammatory conditions. The validation of our assay in larger cohorts with proven or suspected inflammatory disorders will guide time-, resource- and cost-efficient workup and personalized management.” In addition, an aberrant type I IFN signalling pathway, often due to inborn errors in genes encoding viral sensors, can lead to conditions known as interferonopathies and autoimmune diseases within a broad spectrum of human diseases, spanning clinical immunology, rheumatology, pneumology, and neurology. The rapid and accurate diagnosis of dysregulated type I IFN signalling remains a challenge. Nearly 50% of those with undifferentiated autoinflammatory disorders remain undiagnosed. The PID research lab has established the RT-qPCR based ‘interferon gene score’ measuring the expression of interferon regulated genes including IFI27, IFI44L,
IFIT1, RSAD2, ISG15, SIGLEC-1.Filomeen Haerynck, both paediatrician and researcher, started her research career in inborn errors of immunity with a fellowship at the department of Paediatric Immunology-Haematology at Hôpital Necker in Paris. In 2002, she was awarded with the GlaxoSmithKline Award in pneumopediatry and the Pfizer Educational grant. In 2014, she obtained her PhD on innate immunity in chronic infectious and inflammatory diseases. She is founder and coordinator of CPIG, director of Jeffrey Modell Foundation Diagnostic and Research Centre at Ghent University Hospital. Since 2017, she is full time associate professor at Ghent University and principal investigator of PID research lab. She is the clinical head of the Department of Paediatric Pulmonology and Immunology at Ghent University Hospital and responsible for in- and outpatient paediatric clinics for inborn errors of immunity. She is paediatric immunologist consultant at University Hospitals of Antwerp and Brussels. She advises policy makers about newborn screenings for inborn errors of immunity. She is member of the steering committee of the clinical working party of European Society of Immune deficiencies (ESID) and coordinates the European vaccination guidelines in patients with inborn errors of immunity.




As the leading life sciences research institute in Flanders, VIB performs strategic basic research with a strong focus on translating scientific results into real-world pharmaceutical, agricultural, and clinical applications.
Over 1,800 scientists from more than 75 countries conduct research at VIB. The institute is distributed across nine research centers embedded in the five Flemish universities: Ghent University, KU Leuven, Vrije Universiteit Brussel, University of Antwerp, and Hasselt University. Research areas cover bioinformatics, cancer, inflammation and immunity, microbiology, neuroscience, plant biology, proteomics, structural biology, and systems biology.
To add the development of a thriving research program in computational biology to that list, VIB has recently launched its Data Core to provide researchers with the tools to manage the increasing amount of data generated in life sciences research. New technologies have led to an exponentially increasing amount of data in the life sciences. The mission of VIB’s Data Core is to enable groundbreaking research by managing research data efficiently while adhering to international standards.
In 2023, VIB researchers added several breakthroughs to the life sciences.
Researchers from the team of Pierre Vanderhaeghen (VIB-KU Leuven Center for Brain & Disease Research) solved a mystery of human brain development. It takes several years for the human brain to develop fully, whereas this happens much faster in other species. The slow maturation of the human brain is thought to be important for its function, but it was unknown what caused this. The scientists found that the mitochondria, the energy factories in the brain cells, are responsible for the rate at which the brain develops. This discovery sheds light on human evolution and may have important implications for brain function and diseases.
A new insight in the field of cancer research came from the lab of Sarah-Maria Fendt from the VIB-KU Leuven Center for Cancer Biology, which uncovered that frequent metastatic sites in ad vanced breast cancer, such as the lung and liver, are enriched in lipids. The building blocks of lipids, more specifically the fatty acid palmitate, can initiate a series of signals in cancer cells that equip them to grow into metastases. The availability of palmitate further increases with a high-fat diet. This discovery fur ther illustrates the importance of diet for cancer progression.
In a combination of nature and technology, the team of Ive De Smet (VIB-UGent Center for Plant Systems Biology) developed tools, including a deep learning model, that predict the functionality of proteins, even in non-model organisms. This helps us understand the complex biochemical networks underlying plant growth and development, which ensures crop genetic diversity as a powerful tool to adapt crops to a changing climate.
In 2023, collaboration shone brightly in VIB’s spin-off constellation, not only through existing spin-offs but also through the newly-launched pre-seed venture fund ‘Biotope Ventures’. The venture fund provides investments to early-stage agrifood and health biotech startups to help them narrow the gap between science and practical applications by providing financing to de-risk their early innovations. The fund complements the biotope by VIB incubator program, launched in 2022. The program helps start-ups to rapidly advance their biotechnology, grow confidence, and turn their startup into an investment-ready busi ness by offering them access to a stimulating life sciences ecosystem and one-on-one support. The fund-incubator combination will boost the biotech ecosystem with new participants and invites further private investors to join the effort.
Existing spin-offs had great news of their own to share.
VIB spin-off company Augustine Therapeutics announced a collaboration with Charcot-Marie-Tooth Research Foundation (CMTRF), a US patient organization. Augustine Tx will continue its work on delivering treatments for Charcot-Marie-Tooth disease by further investigating the safety and effectiveness of their newly discovered class of selective HDAC6 inhibitors.
VIB spin-off company Confo Therapeutics, a leader in the discovery of medicines targeting G-protein coupled receptors (GP CRs), entered a collaboration agreement with Daiichi Sankyo for the discovery and development of small molecule agonists against an undisclosed target associated with CNS diseases. Confo Therapeutics also engaged in a collaboration with AbCellera for the discovery of therapeutic antibody candidates targeting two


undisclosed GPCR targets. Confo will apply its proprietary ConfoBody® technology to stabilize the selected GPCRs in their disease-relevant conformations, which will then be used as antigens to enable antibody discovery and development.
On top of new and existing collaborations, VIB spin-offs managed to secure crucial funding. Dualyx, a VIB spin-off developing next-generation immune mod ulators, completed a €40 million Series A financing, which will enable Dualyx to progress its lead autoimmune program as well as its pipeline of other candidates. Meanwhile, another VIB spin-off company, ExeVir Bio, received a two-year R&D grant of €1.6 million from Flanders Innovation & Entrepreneurship (VLAIO) for pre-clinical research towards prophylactic and therapeutic solutions for dengue.
As part of its mission to benefit society, VIB’s Grand Challenges Program (GCP) funds transdisciplinary projects that address challenges in healthcare and agriculture and involve extensive collaboration with partners beyond VIB. In 2023, three projects were chosen in the Program’s fourth call. The ‘Flamycon’ project will establish a center of excellence for integrated and faster

diagnosis and treatment of peripheral amyloidosis. The ‘Biopet’ project will develop a yeast-based platform for the production of alternative and sustainable fatty acids for animal feed. Finally, Pointillism 2.0 will build on a previous GCP project and validate predictive biomarkers for immune-checkpoint blockage therapy response.
Beyond science and translation, VIB is also highly active in science communication. In 2023, VIB remained invested in science outreach events, including Flanders’ largest science festival Nerdland. The institute’s education initiatives, such as Wetenschap Op Stap, inspired kids aged 10-12 throughout schools in Flanders. By bringing VIB scientists to the classroom, children got hands-on experience in scientific research, from a microscopic journey through the elements in our blood to cultivating soybeans and learning about soil microorganisms.
By leaning on its three pillars – science, translation, and communication – VIB remains assured of a firm foundation to support cutting-edge research, enable its judicious application, and inspire the next generation of researchers.
The Incubation and Innovation Centre University UGhent (IIC UGent) is a service centre for spin-offs of the Ghent University Association. It is at the disposal of spin-offs coming from the various faculties of the association and their partners.
IIC UGent was established in 1990 as one of the first Incubation and Innovation Centres in Flanders. It is a joint project of Ghent University, Hogeschool Gent, the province of East Flanders, the city of Ghent, the Gewestelijke Investeringsmaatschappij Vlaanderen, BNP-Paribas Fortis, ArcelorMittal, Suez (now Engie), Ethias, Nokia Bell, the Internationale Jaarbeurs Vlaanderen, LVD, imec and UCO.
“The IIC University of Ghent is first and foremost a business generator,” says managing director Prof. Dr Marnix Botte. “We want to stimulate the start-up, growth and development of young innovative high-tech companies there. By fostering intellectual synergy and networking, as an incubation centre we want to create a dynamic environment for young and creative entrepreneurship, where new ideas can grow into successful businesses.”



In practice, this means that spin-offs of the Association University of Ghent receive logistical and operational support there. “Our offer also includes a strategic service package. We advise on concluding leases and provide information on financing opportunities, subsidies and other support measures. We also provide support in obtaining the necessary permits. The IIC can achieve the right guidance mix for each project by drawing on its extensive network of technical, legal and financial advisers. It offers solutions for every challenge in the start-up and growth process, thanks to close cooperation with strategic partners such as Ghent University Technology Transfer, Hogeschool Gent, the East Flanders Regional Development Agency, the city of Ghent and our other shareholders. But we do remain independent, Ghent University is one of our shareholders, but the shareholding is so widely spread that no one can take a dominant position there.”
The wider synergy is also helped by the fact that IIC’s buildings are located along the so-called ‘Tech Lane’, south of the core city and close to the cloverleaf of the major traffic axes Lille-Kortrijk-Ghent-Antwerp-Eindhoven and Ostend-Brussels. “Tech Lane Ghent Science Park consists of two nearby campuses, Ardoyen and Eiland Zwijnaarde. It is a vibrant ecosystem of international corporate R&D centres, public research institutes and high-tech growth enterprises, providing a very stimulating environment for innovation and entrepreneurship. Currently, the park hosts eleven university labs, twelve public research centres, eight industrial pilots and test-facilities and more than ninety knowledge intensive start-ups, academic and corporate R&D centres.”

At the end of 2023, the IIC had four buildings, three on the Ardoyen campus and one on Eiland Zwijnaarde. “Three in full ownership and one in co-ownership with Ghent University. Altogether, this involves a floor area of 6,400 m²,” said Botte. “When we erected our first building on Ardoyen in 1991, we only found two neighbours there, Texaco and Ghent University. The choice of location was partly dictated by the proximity of various departments of the university, such as veterinary medicine and pharmacy, and those of Ghent University Hospital. Importantly, meanwhile, the Flemish Institute for Biotechnology (VIB) is also present on this campus and uses our facilities by placing a number of start-up companies within IIC Ugent. Several companies that we house and others, which have established themselves elsewhere on the campuses are active in biotechnology. From historical growth, pharmaceuticals also weighs heavily, but otherwise there is a broad mix, in which technology is very strongly represented.”
The second and third buildings of the IIC were constructed early this century, and the fourth has been in use since 2021. “The occupancy rate has always been very high. It currently stands at 97%. Of our current tenants, we can consider six to be large companies, the others are a mix of small and medium-sized businesses. Many past and current users started here with just one or two premises, usually a combination of a lab and office space. Some grow very quickly and then need a lot of extra space. We then like to see them move on. The fact that they are then not always inclined to move quickly anyway is due to the lack of available locations near the university buildings. For ourselves, we do see an opportunity for expansion within the Tech Lane campuses in the near future.”
Foreign companies are also welcome. “They must then have signed a cooperation agreement with the Ghent University Association,” Botte underlines.


Since its inception, more than a hundred high-tech companies have so far started up in the IIC Ghent University. Some 30 companies are currently based there. “The fact that there is a wide variety of fields and activities in the Incubation and Innovation Centre leads to a pervasive synergy, which is a breeding ground for the emergence of new innovative activities,” explains the managing director. In the past, it already housed DevGen/Syngenta (crop protection) and CropDesign (agrobiotech), among others. Current users include breast milk sugars specialist Inbiose, Primoris (nutritional analyses), Crodeon (monitoring systems), eTherNa (immunotherapy), Morrowoptics (smart lenses) and ThermoFisher (scientific instruments).
IIC UGent
Technologiepark 82 - B-9052 Gent
Tel.: +32 (0)92 41 56 11
Email: marnix.botte@ugent.be http://www.iicugent.be/


With more than 3,000 patients a day and more than 6,500 employees, Ghent University Hospital is one of the largest and most specialised hospitals in Flanders. Patients can go there for a full range of highly specialised, high-quality care. The hospital has extensive facilities and more than 1,000 beds for one-day and multi-day admissions.

Quality customer-friendly service is central to the care provided. As a university centre, UZ Gent also invests in scientific research and training. To this end, the hospital works closely with the Faculty of Medicine and Health Sciences of Ghent University. Doctors and physician-specialists are trained there, and researchers work on new techniques for diagnosis and treatment in numerous services.
The hospital campus is currently undergoing major renovation. The UZ aims to be a contemporary, accessible and sustainable health campus that meets the needs of all users by 2029.
The UZ Gent has pursued a scientific spearhead policy since 2009. Together with UGent’s Faculty of Medicine and Health Sciences, four research domains were selected that receive extra funding to further expand their position: oncology, genetics, immunology and neuroscience.
The choice of these four domains was made on the basis of objective criteria: leading position recognised by peers, number of A1 publications, current trends in epidemiology and care needs. The translational character and social valorisation of the research were also decisive factors. The spearhead research should quickly lead to research results that allow patients to be treated better. Today, UZ Gent already has a leading position in each of these four research domains.
Research at UZ Gent is carried out by the Kenniscentrum voor de Gezondheidszorg Gent (KCGG) or Ghent Healthcare Knowledge Centre and the Health, innovation and research institute (HIRUZ) which is structured in five units: Clinical Trials Unit, Data Management Unit, Contract Unit, Innovation & Valorisation Unit, and the Biobank.
Researchers at UZ Gent and UGent recently introduced a test that improves the treatment of children with acute lymphatic leukaemia (ALL), the most common childhood cancer. “The test teaches us very quickly whether a treatment is succeeding or not,” says Prof. Dr Tim Lammens. “We are now applying it to all children with ALL in Belgium. Seventy children in Belgium are diagnosed with ALL every year. A key component of the treatment is the enzyme asparaginase. This enzyme breaks down the essential building blocks of leukaemia cells, causing them to die and disappear.
15% of children develop an allergic reaction to the treatment and produce anti-asparaginase antibodies. Those antibodies block the action of asparaginase. “Usually the reaction is evident through typical allergy symptoms,” explains paediatric haemato-oncologist Dr Veerle Mondelaers. “But in a third of these children, the reaction happens without these symptoms. In them, the treatment does not work, but without a test we would not notice it.” If the test shows that a child responds poorly to treatment, the doctor adjusts the treatment with a different type of asparaginase. Research to better understand how asparaginase works started back in 2013. All children diagnosed with ALL since 2014 provided a blood sample during their treatment with asparaginase for a test in the UZ Gent lab.
The research will continue in the coming years. “Why do certain children produce antibodies and others not? Do we find asparaginase enzymes with less chance of an allergic reaction? We also hope to answer those questions,” states Tim Lammens.

The vascular and interventional radiology service (Vinrad) at Ghent University Hospital has been the first in the Benelux to use a robot to treat vascular diseases in the brain since the end of 2022. “This allows us to work even more precisely and limits radiation for the caregivers,” explains head of service Prof. Dr Luc Defreyne.
When treating an aneurysm in the cerebral artery, the doctor inserts a flexible catheter into a blood vessel via the arm or groin. From there, he manoeuvres the catheter through the blood vessels to the brain, supported by X-rays and contrast medium to visualise the vessels and blood flow. Vinrad applies the treatment about eighty times a year.
The Siemens Corindus CorPath GRX robot, which has taken over performing the treatment, is controlled with joysticks, from a radiation-shielded cockpit. Previously, some Belgian hospitals deployed it for cardiology procedures.
“The robot moves the catheter, metal wires or stents to the site of the aneurysm. Meanwhile, we closely monitor the work via classical imaging. Should the robot ever get stuck, we can intervene immediately and take over the treatment manually,” says Luc Defreyne. “In the long term, the robot may be able to navigate itself using micro cameras or sensors. For now, it has not reached that point yet.”
In a cockpit, doctors do not have to wear a lead apron against harmful X-rays. This makes his work safer and more comfortable. Nurses can also keep more distance from radiation. “The robot also provides efficiency gains. Nurses now play a greater role in the preparation and execution of the procedure and the interventional radiologists can focus on their core tasks,” adds deputy chief nurse Elise Devlieghere. “This makes nurses’ work more substantively interesting.”


The hospital has been using a new scanner, HiRise, for lower limb imaging since spring 2023. “Because the patient stands upright in this scanner, we can examine the influence of load under gravity up to the hips. Those 3D images explain the patient’s complaints more clearly than when the scan is done lying down,” report radiologist Wouter Huysse and orthopaedic surgeon Arne Burssens.
“Patients with lower limb complaints suffer mainly when standing up or moving,” Dr Burssens informs. “If you have these patients lying down in a scanner, you often don’t see exactly what the problem is. The HiRise changes this.” Because the patient is upright under a normal load, the new scanner can make a realistic assessment of the bones in the lower limbs and their mutual position.
Prostheses and other orthopaedic materials also come into clear view. It is an ideal solution for patients with O- and X-legs, flat or hollow feet, complex and operated fractures, some ankle sprains and congenital bone anomalies. In addition, the HiRise is a Cone Beam CT scanner (CBCT). Its radiation dose is 20 times less than a traditional CT scanner.


In recent years, the food packaging value chain has been characterised by a never-ending stream of innovations. In Belgium, Pack4Food is the driving force behind the optimisation of packaging for the food industry. The cross-sectoral approach in which all stakeholders throughout the whole value chain bundle their knowledge and expertise, proves particularly efficient. Thanks to Pack4Food, Belgium plays a leading role in the international research on food packaging.
Pack4Food is a consortium of research institutes and companies throughout the food and packaging industry (food producers, packaging materials producers including printing, filling and measuring equipment, …). “They join forces to stimulate innovation in food packaging,” says director Peter Ragaert. “Pack4Food acts as a bridge builder and communication channel. An important task for our six-persons team is to initiate and coordinate research and development projects with added value for companies and other stakeholders in the food packaging value chain, based on their needs. Our ambition is to formulate answers to real food packaging challenges from an unbiased vision and approach.”
Pack4Food also has earned its spurs internationally. The organisation is increasingly involved in European research projects and is putting Belgium on the map as a leader in innovation in food packaging. On top, Pack4Food is leading, with support of Flanders’ FOOD and NATUREEF, the European S3 Partnership Food Packaging, a European collaboration platform with 20 clusters from 11 countries, representing more than 2000 companies. The aim is to facilitate the exchange of know-how along the whole food packaging value chain and thus accelerate the introduction and implementation of new sustainable and/or smart food packaging technologies and innovations in the

food packaging industry on an international level. The S3 partnership also aims to develop a network of ‘living labs,’ allowing companies to test their packaging for e.g. shelf life, recycling potential, intelligence, etc.
The fact that Pack4Food is involved in several national and international research projects, leading to improved packaging concepts for food with spill-over in other industries, has everything to do with the vision of the organisation. In cooperation with Flanders’ FOOD, Catalisti, SIM and VIL, this was translated into the innovative cross-sectoral Roadmap ‘Food Packaging of the Future’. Peter Ragaert: “This roadmap formulates answers to the packaging challenges of 2030. The roadmap is based on three pillars: circular packaging, smart packaging and packaging & logistics with an overarching pillar: packaging and digitalisation.”
European collaboration is key!
To achieve the current (and upcoming) European targets related to food packaging by 2030, industrial stakeholders have a strong need for innovation and investment througout the entire food packaging



value chain, in which interregional cross-sector collaboration is essential. To strengthen the capacity, competiveness and resilience of these stakeholders, the S3 Partnership initiated the Interregional Innovation Investment (I3) project Value4Pack. Value4Pack aims to boost innovation and investment capacity in the European food packaging value chain by building an interregional resilient ecosystem between its relevant penta-helix actors (industrial stakeholders, research institutes, investors, regional authorities, consumers and NGOs). By facilitating interregional cooperation, Value4Pack increases the capacity of companies in the food packaging value chain by engaging them in interregional innovation projects and initiatives, develop new business ideas and resulting in concrete interregional innovation investments for validated solutions that meet their needs. Pack4Food strongly fosters its broad international network and ecosystems which is also a clear benefit for its members.
The research area’s of Pack4Food are very broad. Nevertheless, the emphasis in recent years has mainly been on sustainability. “It is true that we always approach this theme from the point of view that packaging must first and foremost ensure the required shelf life of food products,” says director An Vermeulen.
In the Tactic research project, multiple tools assessing sustainability of food packaging are tested and reviewed on e.g. their scientific integrity and methodology. Furthermore, communication strategies are being developed to explain sustainability choices to consumers. In this way, the companies participating in Tactic are both supported in selecting the right sustainability tools to improve their packaging designs and communication to their consumers.
The Multi2Recycle project formulates an answer to the question “How can multilayer polypropylene food packaging foils be recyclable and at the same time have the optimal barrier properties to ensure the shelf life of food products?” More specifically, it evaluates the impact of the packaging composition vs. its mechanical recyclability. It aims to recycle these packaging foils into new foils for secondary or tertiary (food) packaging and primary non-food packaging applications. Moreover, the mechanical recyclability of mixed streams of polypropylene foils and its repetitive recycling is also evaluated. Even so, guaranteeing the functionality of the packaging for the food products (i.e. barrier properties, transport simulations,…) remains key in Multi2Recycle.
The functionality of food packaging is also paramount in Repac², a European Cornet project. This project evaluates the applicability of various coated paper packaging materials today on the market for several food products as well as their recyclability.
Meanwhile, digital technologies and data also provide an important transformative driver for the food packaging industry. Building a more resilient supply chain involves investing in new technologies and the interconnectivity of digital tools, physical infrastructure, and underlying data streams to move from descriptive to predictive supply chains.
The Smart Packaging for Intelligent Logistics project is a good example. This project, initiated by AIPIA (Active & Intelligent Packaging Industry Association), assessed how to increase the use of commercial smart packaging technologies to improve supply chain efficiency (cost, energy
and waste reduction) in four sectors (food, beverage, health care and high tech). Pack4Food was work package leader for the beverage case and engaged AB InBev to participate in the project. AB InBev’s overall goal is to make packaging environmentally friendly at affordable cost. Within the project they wanted to find solutions to motivate consumers to return their re-usable crates (faster). This project was especially interesting for asset management of re-usable packages.
No doubt smart technologies will encourage and support the circular economy and as such the transition towards circular food packaging. “For example, Pack4Food together with Imec and Flanders’ FOOD and with the financial support of EFRO, are investigating in Vision2Reuse how smart camera technologies and AI can be used for quality control of reusable food packaging,” says An Vermeulen. “We are thinking of a system by analogy with empty bottles. After usage, a smart camera verifies the reusable packaging material, whether it is damaged and its degree of dirtiness. Based on this information, the packaging is diverted to recycling or the washing line. In a next development stage, this information will be used to steer and optimise the washing process to also be sustainable in terms of energy, detergent and water consumption. After washing, an extra camera check will guarantee the food safety of the pack for re-usage. “
Pack4Food does not only make a difference by initiating and partnering in research. The organisation also ensures a flow of latest information to the field. Peter Ragaert: “Together with various research partners, we provide practical training on a regular basis to companies, in Dutch or English. Our trainings range from packaging technologies such as packaging under modified atmosphere (MAP) over packaging materials such as biobased and compostable plastics, to new technologies such as active and intelligent packaging. Because we are close to the innovation sources, we can constantly optimise the training courses with the latest information obtained from various research projects or the academic world.” Finally, Pack4Food supports the new advanced master program ‘Sustainable Food Packaging’ at Ghent University (www.sfp.ugent.be).



Pack4Food vzw
Coupure links 653
B-9000 Gent
Tel.: +32(0)9 264 99 30
Email: info@pack4food.be
https://pack4food.be/en


The transition towards a circular packaging economy is high on the agenda, not only in the corporate world, but also among policy makers. European frontrunner in this area is Belgium, with its unique organisation for commercial and industrial (C&I) packaging - Valipac - allowing the country to already meet and even exceed the latest recycling targets today. ‘Let’s act together for a circular economy’ is not an empty slogan at Valipac, but an ambitious objective.
While the other EU-member states slowly begin to set up a scheme for C&I packaging, the Belgian system was installed 25 years ago. Since then, Valipac is the accredited body for extended producer responsibility for C&I packaging in Belgium. It works according to a mutualistic and participatory model, based on consultation between the various stakeholders. Trade federations, companies and employers’ organisations all are part of its decision-making bodies.
By 31 December 2025, at least 65% by weight of all European packaging waste must be recycled, increasing to at least 70% by 31 December 2030. The Extended Producer Responsibility imposes producers to design their products from the most eco-friendly materials available and in such a way as to optimise their collection, but also to ensure the processing of their products with special attention to recycling.
 Francis Huysman, Valipac’s Managing Director © Valipac
Francis Huysman, Valipac’s Managing Director © Valipac
Contrary to other European countries, Belgium has established two separate EPR-organisations for packaging waste, one for household packaging and another for C&I packaging. Only a few Belgian companies can comply individually with their EPR obligations. “This small minority is well organised to do so,” explains Valipac’s Managing Director Francis Huysman. “But the majority of the companies has delegated this responsibility to Valipac, by paying a fee. We cover about 85% of the market.” The remaining ‘free-riders’ aren’t working according to the legal terms and can be fined. Most of them however are small companies with very low amounts of packaging.”
“Until recently, we focussed on registering the C&I packaging placed on the market and collected in Belgium, and encouraging selective collection from companies,” says Francis Huysman.
“In more than twenty-five years, we succeeded in raising the recycling percentage of C&I packaging from 74 to 92.4%, making Belgium the leading nation in Europe. Currently, 61.5% of the plastic packaging gets recycled, 91.1% of the metal, 98% of the wood and even 100% of the paper and cardboard. In this model, the recycling of plastic packaging is mainly done outside Europe, for instance in Turkey and some South-East Asiatic countries.
“However, this model is not sustainable. On the one hand, because the export of waste materials means a loss of secondary raw materials and added value for European industry. On the other hand, because it makes traceability and control of effective recycling more difficult. That is why we are evolving towards a circular model in which most of the recycling process and use of the recyclate remains on European soil. It is important to find European companies interested in the processing and reusing of collected packaging waste.”
To get a detailed view on the exact current destination of the Belgian commercial & industrial packaging waste, Valipac set up agreements with the largest waste traders, the companies who purchase, sell and ship waste to different destinations for recycling. These contracts with the traders, in combination with the information provided with the waste collectors, generated a detailed mapping of the final destination of our packaging waste. “Currently, Valipac is the first organisation in Europe to have a clear overview of the final destinations of 99% of the industrial plastic packaging waste and 95% of the paper and cardboard packaging waste from Belgian companies. Together with SGS, Valipac performs audits at recyclers where Belgian C&I packaging waste is treated in order to verify that the packaging waste is effectively and entirely recycled in compliance with environmental, safety and social standards. Since autumn 2023, companies that have their packaging waste collected by waste management companies affiliated to Valipac, have the possibility to obtain a report from their waste management companies indicating the final destina tion and the level of compliance of the recyclers who process their C&I plastic packaging waste.”
Overall, companies are continuously sorting more and better, but there still remains some room for improvement. Through profound analysis of the waste production and the sorting behaviour of more than 200.000 Belgian companies, Valipac pinpoints the waste streams that require extra initiatives to


create further awareness. “We promote the principle of circularity in Europe with a circular model in which the focus is on the co-responsibility of all stakeholders,” Francis Huysman explains. “We no longer only register the C&I packaging placed on the market and collected in Belgium. We are seeking and entering into partnerships with new stakeholders across Europe: traders and recycling companies will have to cooperate in full transparency in order to be able to find out where the C&I packaging waste ends up and how much of it is recycled. From the packaging producers, we will collect information on how much of this new raw material is converted back into packaging.”
Starting in 2022, Valipac supports companies which adopt sustainable packaging with an incentive and takes herewith the lead of packaging circularity in Europe. “We pay our clients a bonus of 50 euros per tonne of post-consumer recyclate incorporated into their C&I plastic packaging. The only conditions are that the packaging is used for goods that are sold in Belgium and that the percentage of recycled content is certified. The packaging may be produced internationally, as long as the percentage of post-consumer recyclate incorporated in the packaging is proven. The minimum requirement is set on 30%. Logically, given that today only a handful of packaging producers offer such solu tions.”
The launch of the new bonus-system was accompanied by the launch of the platform myRecycledContent.be, where supply and demand can find each other. “Even today, few companies are aware that films with recyclate are equivalent to virgin films,” says Francis Huysman. “Unknown is unloved, so there is no demand for such solutions. As a result, few packaging producers are interested in investing in production lines to process recyclate. We want to eliminate this chicken-and-egg story by sharing knowledge and raising awareness, but also by offering a tool where parties can find each other. Doing so, we took another step towards a European approach, because logically the website isn’t used by only Belgian players.” In collaboration with its partner organisations in France, Germany and the United Kingdom (the initiative isn’t limited to EU-members), Valipac also started www. myRecycledContent.eu. This project aims to bring together suppliers of plastic C&I packaging containing recycled material on a single European platform and to establish a common database, without any commercial or marketing purpose.
Valipac also stimulates and assists in company specific projects to use packaging with as few difficult to recycle additives as possible. “For example, we were able to convince a brick producer to reduce the number of pigments in his plastic packaging (shrink hoods). The use of the pigments resulted in a downgrading of the recyclate. With the new solution - only a small sleeve with printed pigments - most of the packaging can be reused to produce new transparent packaging.”


Valipac
Avenue Reine Astrid, 59A bte 11 B-1780 Wemmel
Tel.: +32 (0)2 456 83 10
Email : info@valipac.be
https://www.valipac.be/

As a research and advice centre, Inagro assists farmers and horticulturalists in their quest for sustainable and efficient cultivation methods since 1956. Initially, its activities were limited to the province of West Flanders, but Inagro has since built up such an amount of expertise that it also can offer cross-border services.
Ever since its establishment as a research centre, Inagro strives for better cultivation techniques through trials on a practical scale. Inagro’s 230 mainly scientific and technical employees carry out their practice-oriented and -driven research programmes partly on farms, but mainly in its own extensive research infrastructure.
“This makes Inagro the farmers’ and their technology providers’ key-R&D partner in the transition towards a more durable society,” says deputy director and research manager Greet Ghekiere. “Our research agenda focusses on the development of solutions to meet the goals of the European Farm to Fork strategy. We aim to implement the results of our research in practice within the shortest possible time. This why we perform our research, validation and demonstrations in real-life environments, in open air and greenhouses.”


“We always had an eye for new trends, not only in agriculture and food, but also in a broader social context. This includes searching for solutions to mitigate the impact of farming on the climate, especially related to livestock farming: we focus on development of technological solutions as well as management practices to reduce the greenhouse gas emissions from livestock farming. Our solutions are based on resilient soil management and finetuned water and food management. An example is our project to reduce the emission of methane by cows.”
“We have pilot scaled research facilities for the production of mushrooms and Belgian endives and as well for aquaculture,
insect breeding and anaerobic digestion. In our trial fields, we experiment with soya, quinoa, chickpeas and even duckweed, crops that could potentially provide locally produced proteins. In collaboration with a major retailer, we already developed a houmous based on chickpeas. We also conduct research into the professional cultivation of insects to produce alternative proteins. Our attention goes to the entire food chain,” explains Ghekiere. Together, the trial fields cover an area of 35 hectares. Inagro also has 10 000 m² of greenhouses and an installation for the production of biogas.”
Inagro also works on the implementation of nature-based solutions to limit the use of chemical pesticides and nutrients within primary production. Within the Future Farming Hub, Inagro develops production practices for the future within conventional, organic and agroforestry farming systems. “We are testing the effectiveness of bio-pesticides and bio-control-agents. We also develop smart and data driven decision support systems for crop protection, that must improve the performance of integrated pest management. We seek to implement digital solutions and smart farming technologies to optimize farming systems and to prevent leaching of nutrients and pesticides to the environment.”
Inagro’s response to the current trend of growing vegetables on roofs in highly urbanised environments is the roof greenhouse Agrotopia. “We try to find out if it is possible to organise this on a larger scale, using residual flows from the immediate surroundings. We want to develop hydroponic and indoor vertical farming systems using water, nutrients, space and energy in a very efficient way, with a minimum of pesticides needed to keep the crops healthy.

In the 1950s, flax and some other traditional Flemish industrial crops were experiencing difficulties. The Flemish flax fibre preparation industry was and is highly concentrated in West Flanders. This gave rise to the idea of setting up a provincial research institute. Originally, it would mainly study the technical problems of industrial crops. In May 1956, the foundation of the Provincial Research and Information Centre for Industrial Crops was official. From the start, the focus was on improving cultivation techniques, comparing varieties and introducing new crops. This was done close to and with the sector so that results could be implemented quickly on the farms. “We consider multi-actor working as an essential part of our approach. We prefer to work in co-creation with all relevant stakeholders. Significant for this approach is that Inagro manages two ENOLL approved living labs, one for greenhouse agriculture and the other dedicated to the development of concepts for the circular use of water, energy, biomass and nutrients.”

By now, intensive livestock farming as well as vegetable and potato production also have become cornerstones of important local food processing industries in West Flanders. And farms have developed into real businesses. Today’s farmer is a well-educated manager who needs knowledge in various fields. In terms of practical technical knowledge, Inagro offers him a lot of support. “Providing scientifically substantiated practical research and transferring knowledge to stakeholders in the agricultural sector are Inagro’s core activities. In search of fairer economic returns for farmers, Inagro explores innovative business models for farmers, within the short supply chain but also based on ecosystem services, such as carbon sequestration and use,” Greet Ghekiere underlines. “The global challenges of economic competition, demographic change, climate change and sustainability requirements call for initiatives on a regional, national and European scale to future-proof sectors such as agriculture and horticulture. Innovation and knowledge are the keys to bringing about sustainable change,” says Inagro director Mia Demeulemeester. “Inagro is an important partner in the European international Agriculture Innovation and Knowledge System (AKIS).” By actively participating in international networks and projects, Inagro ensures a global perspective in its innovations. That is why Inagro is an experienced partner within Horizon Europe and Interreg programs.
An important topic in Inagro’s living lab dedicated to circular use is the production and use of ReNuRe, recovered nitrogen from manure, as well as the use of waste water from food processing industries and municipalities for plant production. “There still is no legislation about the production of nitrogen from manure. Research must provide the legislators objective data about the pro and contra. Generally, Inagro seeks to implement digital solutions and smart farming technologies to optimize the use of inputs within farming systems and to prevent leaching of nutrients and pesticides to the environment. Testing the effec tiveness of bio-pesticides and biocontrol agents as well as developing smart and data driven decision support systems for crop protection, Inagro improves the performance of integrated pest management.”

For fast-growing crops and when weather conditions change rapidly, it is crucial to be on the ball. Fast, high-quality analysis is therefore of great importance. For this purpose, Inagro has its own independent and accredited laboratory. Farmers and horticulturalists can go there to have their soil, crops, manure, water and fodder analysed. The ISO 17025-certified lab is equipped with various state-of-the-art equipment for sample preparation and different measuring devices for a wide range of analyses. Every year, it analyses about 70 000 samples, mainly soil samples. Customers can deliver samples 24/7 via the refrigerated night safe. “Inagro participates in efforts to meet future requirements. Every year, we carry out more than 400 tests. These form the basis for our independent advice. We also organise more than 150 seminars, demos and training sessions.”

Inagro
Ieperseweg 87
B-8800 Rumbeke-Beitem
Tel.: +32 (0)51 27 32 00
Email: info@inagro.be
https://inagro.be/eng


With six study areas and a multitude of study programmes, VIVES is a university of applied sciences where various sectors meet. This is also reflected in its research, which is increasingly drawing the map of multidisciplinarity. As a result, VIVES creates innovative knowledge that solves real problems, bridging the gap between fundamental research, industrial production and operation applications.
VIVES University of Applied Sciences engages in hands-on research. VIVES reaches out to companies and organisations that face modern day challenges. By offering a solution to these challenges, it improves its knowledge and adjusts its insights in and on education.
VIVES, the largest university of applied sciences in West-Flanders, provides higher education and practice-oriented research. With its research VIVES wants to participate in innovation on a regional, national and international scale. “The integration of innovations resulting from this research in the educational programs ensures that this offer remains future proof and retains its high level of quality. For us, staying in line with current professional practices is not enough. We want to go much further,” says Isabel Vanslembrouck, director VIVES Research and Development.
On the five VIVES campuses, an average of 16,000 young people annually opt for a study programme in health care, education, applied social studies, biotechnologyapplied engineering & technology or commercial sciences, business management and informatics. “There is a centre of expertise for each field of study. Together, approximately 200 employees deliver scientific research there,” says Isabel Vanslembrouck.
VIVES combines high-tech infrastructure, which is crucial for preparing students and companies for the latest industrial developments, with an innovative view on trends in research and ser vices. At the same time, VIVES also works in a future-oriented and human-centered manner in the fields of health and well-being, food innovation, cli mate, entrepreneurship, empowerment, educational technology, digital transformation and smart mobility. Most leading researchers combine their research activities with teaching.
“As a university of applied sciences, we focus on practice-based research that is increasingly being initiated by a demand from the professional field,” says Vanslembrouck. “We work on research questions evolving from knowledge institutions and companies/ organisations from a wide range of other sectors.”
VIVES research activities are organised in six centres of expertise. Its Centre of expertise for Agriculture & Biotechnology focusses on five domains: food processing, food & health, urban forestry, smart farming and animal behaviour
“Within food processing, three lines of research are currently running,” explains coordinator Yves De Bleecker. “First, there is the development and optimisation of food products. In this line, we look at new possible sources of protein, among other things. Insects are one such source, but

also macro-algae, the so-called vegetables of the sea. Limited use already exists in the food industry. In addition to their nutritional contribution, we are investigating, among other things, to what extent we can exploit their foaming potential in food products. Our efforts are part of an overall drive towards greater sustainability. In doing so, we aim to partially replace proteins of animal origin with proteins of vegetable origin.” Another project revolves around the use of the yacon tuber as a sugar substitute. “This opens interesting perspectives for diabetics.”
The valorisation of by-product streams forms the second line of research. “For example, we already created a salmon croquette from the cutting losses of salmon in fish processing plants. In doing so, we paid attention to the typical taste of salmon and an optimal texture of the croquette’s filling, so that it does not burst open during frying.” In cooperation with 23 companies, the centre of expertise is also pursuing operational chain to develop food from brewers spent grain, a residual mass from beer production. “Traditionally, brewers spent grain is already processed in
animal feed. In Belgium, it is about 230,000 tonnes a year. It is rich in protein and fibre. Therefore, it can be more usefully processed in food for humans, such as bread, biscuits and meat substitutes.”
The third line of research is all about microwave ovens. “Besides the familiar household applications, microwave ovens offer other interesting possibilities. The heat they generate is very suitable for drying and pre-cooking food. Pre-cooking meat can be useful for improving the energy efficiency of baking lines. Under the right conditions, drying in microwave ovens preserves aroma and colours well. Recently, we discovered that drying walnuts with microwaves takes much less time than methods traditionally used for this purpose.”
In a brand-new building, the first incidentally on the POM West Flanders’ Food Innovation Park in Roeselare, VIVES recently housed its FoodLab. Among other things, it contains a semi-industrial kitchen, where we conduct research into the quality of meals and meal components,” says FoodLab coordinator Lien Van den Broeck. “We now span the whole chain from raw material to balanced meal on the plate.”
The kitchen is equipped with the latest equipment available for preparing and regenerating meals in a large-scale kitchen. “In care facilities, large numbers of meals are produced. They are prepared and kept warm until serving time or prepared, cooled and then reheated. We can mimic these processes perfectly. For instance, we look for the ideal temperature/time combination for regeneration. In our labs, we then investigate the impact of keeping warm/reheating on the quality of the meals. Besides the physical characteristics of the product (colour, texture, moisture content, etc.), we also assess its organoleptic properties (taste, smell, texture, etc.).
For this purpose, we use test persons in sensory labs. In one of our ongoing studies, we are investigating how to prevent broccoli from acquiring a dull appearance upon regeneration.”
FoodLab’s capabilities and projects are far from limited to developing and optimising meals. FoodLab’s infrastructure also includes a gymnasium and various devices to measure people’s body composition. These are used in our research into sarcopenia, the loss of muscle strength and muscle mass, due to age or as a result of an underlying condition. Strength training combined with extra protein are key there.”
“That’s why we develop nutrition tailored to specific target groups,” Van den Broeck explains. “For example, elderly people need extra proteins. We study what effects adding them to foods has on their nutritional value, appearance and (after)taste. We also focus on chewing and swallowing problems. To remedy these, we also try to adjust the texture of food products by thickening or grinding them, for example.”
The FoodLab presents itself as a dynamic place where students and researchers engage in practice-oriented research, education and service around the themes of food and health. Researchers from both the agriculture and biotechnology centre of expertise and the centre of expertise in care innovation are particularly active in the FoodLab. “Companies and healthcare actors are also welcome there to make use of the available research infrastructure.” The nutrition research team has ten full-time equivalent staff members, supplemented by students who do their internship there or do their final work through a research project.




Thanks to high-quality programmes and, above all, practice-oriented programmes, Vlerick Business School can call itself the best management school in Belgium. It extends this reputation to its research activities that can be perfectly described by four Rs: Relevant, Reliable, Responsible and Reach. In short, in an academic way, Vlerick’s researchers are invariably looking for applicable solutions to real business problems. The school also engages its stakeholders to create synergies between research and learning activities.
Every year, the three campuses (Ghent, Leuven and Brussels) of Vlerick Business School prepare around five hundred (international) students for a master or MBA degree. In addition, a mult itude of people follow a short open enrolment management programme, aiming to boost their careers, gain a better understanding of their tasks or optimise their management skills. “All functional areas within business and management are covered,” says research manager dr. Eva Cools. “From marketing and HR, over accountancy and finance, to operations and people management. On top of that, we offer customised programmes for companies and organisations that want a tailored programme for their specific needs.”

This same broad focus is also used in the research activities, albeit topped off with a sauce of digital transformation and entrepreneurship. “These are the trends that determine the current economic climate. Digital transformations accelerate business opportunities. Strong entrepreneurship ensures business continuity.”
Since 2019, Vlerick is an institutional partner of the Responsible Research in Business & Management (RRBM) network. “We are one of the few business schools in the world to be recognised as a RRBM Pioneering Institution. This testifies that we are a source of best practice. It also highlights that we strive to have societal impact through our research and teaching programmes. As signatories of the RRBM vision paper, we endorse the principle that academic research should play a role in developing knowledge that benefits businesses and wider society.”
“We’re engaged in both fundamental academic research and research for business and society. This means we involve our stakeholders,” says dr. Cools. “This may appear to be obvious. In the academic world however, this isn’t always the case. We are always alert to gaps that exist in fields of knowledge highlighted by stake holders - and we explore them with academic rigour. We know that the world needs research that makes impact - and we are committed in delivering it. Our doctoral research, for example, should have broader business application. At the same time, our joint research with companies is based on the rigour of sound academic practice.
This makes our research for business approach unique. Via our research centres and long-standing partnerships and memberships, we create truly practical relevance for the business community.”
Interdisciplinary research is becoming ever-more important in finding answers to today’s business challenges. “Because of this, we join forces across our own domains - and with external international professors and professors from our parent universities in Ghent and Leuven. We then integrate knowledge gained from solid research into our education activities, by developing tools, business games and simulations. The need for sound academic practice is also something we instil in our students - with critical reflection and business research methodology being essential components of their projects.”


Vlerick Business School has fifty professors who are expected to spend about 40% of their time conducting academic research. “They often start from a practical problem that is then embedded in a gap in academic literature”, says dr. Cools. “In addition, we have about sixty researchers, a mix of (post)doctoral students and junior/senior researchers. These researchers are consciously looking for partnerships with companies. To finance the research, but also to keep a finger on the pulse. We believe that understanding what is going on within companies and identifying the most pressing challenges together is the first condition for providing research with added value.”
To make sure our research strategy is widely supported within the school, the Vlerick Research Charter was created. “It sets out the ways we work to produce credible research. It safeguards our robust academic practices - and it provides a framework for academic integrity and ethics. All faculties, researchers and DBA participants sign our charter as a commitment to adhere to its principles of sound academic conduct. As an institute, we take responsibility to create an environment that supports and stimulates sound academic practice with training, mentorship, necessary infrastructure and guidelines.” Vlerick Business School supports the push towards open science. “We believe that the exchange of information is at the heart of science itself. In line with the European Code of Conduct for Research Integrity code, we adhere to the principle: ‘As open as possible, as closed as necessary.’ We take a pragmatic approach and implement policies around open access and data management sensibly - and in support of the open science movement.”

One of the most important objectives is to ensure that research results reach as wide an audience as possible. That is why Vlerick Business School translates them into white papers, articles or reports that are distributed free of charge. “Regularly, the research also leads to the development of a tool that allows companies to check how far they are in a particular area,” says dr. Cools. “In addition, we sometimes work out cases that other educational insti tutions use in their programmes. Furthermore, companies can come to us for tailor-made research.”
Over the years, Vlerick Business School has built up a solid reputation that goes far beyond national borders. Not surprisingly, the research team is increasingly involved in European research projects. “Our practice-oriented approach in particular is praised internationally,” explains dr. Cools. “This is why we are regularly asked to develop the business model behind a research project or to develop a concept that allows us to translate the results into useful tools. For example, we were involved in STORY, a European pilot project investigating the technical possibilities of energy storage in batteries. This in itself has nothing to do with management. Nevertheless, we have an important role to play. After all, we are developing a business model with which the financial feasibility of a wider dissemination of the technology can be calculated. Ultimately, this broad applicability always remains the key question within a project. It is precisely in this area that Vlerick Business School has built up enormous expertise and knowledge. It is an added value that we are happy to bring research and practice together as much as possible.”


Vlerick
Campus Gent: Reep 1 - B-9000 Gent
Tel.: +32 (0)9 210 97 11 0
Campus Leuven: Vlamingenstraat 83
B-3000 Leuven
Tel.: +32 (0)16 24 88 11
Campus Brussel: Bolwerklaan 21
B-1210 Brussel
Tel.: +32 (0)2 225 41 11
Email: info@vlerick.com - http://www.vlerick.com














What are the missions of the CPSRBC?
The CPSRBC is an independent advisory body to the Brussels government which brings together experts in research and innovation in the region: universities, colleges, research centres and social partners (Agoria, Essenscia, BRUXEO, trade unions, etc.). It advises the Brussels government in the preparation of its science policy and keeps a critical, constructive eye on this policy. A true forum for exchange between all its members, the CPSRBC formulates advices and recommendations at the request of the regional government or the cabinets of Ministers like Minister Barbara Trachte, responsible for science and innovation. For instance, Ms. Trachte presented us her “Shiftingeconomy. Brussels” initiative and suggested that the issue of gender equality in the RDI area could be the subject of an advice. Requests for advice by the government or cabinet are usually made for the implementation of new legislations touching on RDI policy, as well as for the implementation of new political plans such as the regional operational planning for the European Regional Development Funds. Advices are often initiated by the CPSRBC itself.

How do you view regional policy on science, research and innovation? Brussels-Capital is recognised by the European Commission as a European leader in innovation. Indeed, it excels by its vibrant innovation system in SMEs, a strong collaborative dynamic, a strong knowledge base and a very strong performing scientific fabric (highly cited publications and scientific collaborations).

Furthermore, a solid expertise base in ICT makes Brussels a digital capital. It must also be said that Innoviris (the Brussels-Capital Region’s innovation funding agency) plays a central role in granting aid to innovative companies. It is a very efficient, available and competent player, who manages the available resources well. I would, however, have three reservations: the difficulty of putting the results of research into industrial use, which limits the creation of potential jobs; the difficulty for start-ups to move on to the next stage of scaleup in the production sector and to become international; and finally, the difficulty for companies to retain talent and recruit the right people. On all these points the CPSRBC is working with Innoviris to move things forward.
What advice have you given recently?
A working group is currently working on a memorandum to address our concerns to the politicians before the elections. Other recent advices concern comments on the preliminary draft of the 2021-2027 ERDF programming in the Brussels-Capital Region, as well as on the 20212027 Regional Innovation Plan (RIP) and the Smart Specialisation Strategy. For the latter, the council also contributed to the development of the monitoring tool. In addition, Advice 58 on regional gender equality policy in the field of RDI made recommendations to improve the gender balance in the evaluation panels of research programmes and within these programmes themselves. In total, the CPSRBC has issued almost sixty opinions since 2001.
How are Agoria and the Brussels-Capital Region working together to further encourage scientific research and innovation in Brussels?
As a federation of technology companies, Agoria is actively involved in promoting innovation and works with the training organisations Technicity and Digitalcity to develop their offer in accordance with the challenges of the Brussels region. Agoria also participates in the “Sustain.Brussels” project (“European Digital Innovation Hub” call for projects) which supports companies in the optimal use of artificial intelligence to develop their business. What is more, Agoria has a board of directors for the Brussels based members headed by René Konings to help these companies face their various challenges. We also support our industry with studies: “Digital4Climate” has established that 5G increases the level of data processing but the average impact of the 5G application will drastically reduce our energy impact; “Be the change”, which looked at the jobs of the future and the skills to be developed in this context, was taken into account by the two training organisations mentioned above. Ultimately, Agoria is acting to guide the decisions of the Brussels government in the interests of businesses, which in turn will be better able to help the region’s development. A virtuous circle!
Since it was set up in 2016, this acceleration programme run by hub.brussels, the Brussels Agency for Entrepreneurship, has welcomed and promoted 64 innovative projects active in connected and unconnected medical devices. And 70% of these start-ups are still active today. It has already helped launch a number of big names in the sector, including Pulso, Lys Medical, Axiles Bionics, Gratiago, StellaScreen, SurgeLight, Smarcos, Momly and Tulipal.

For 6 months, 5 medtech prototypes were refined, challenged and fine-tuned, with a great deal of coaching and expertise. Because that’s what the MedTech Accelerator® programme of our lifetech.brussels cluster is all about: convincing results in half a year.
Here are the five projects that put their concept to the test this year:
- AETECH, which wants to market an extracorporeal cardiac and respiratory assistance device, with the aim of facilitating the recovery of cardiac patients.
- Bioease, which has developed a tool for harvesting and grafting tendons.
- Young patients suffering from dyspraxia (DCD) can count on software from Hecateris, which enables them to learn to overcome their obstacles in a fun, digital way.
- For women suffering from severe menstrual pain, Mirapulse offers a solution based on electrostimulation.
- Finally, Stellar Closure has developed a medical device for the rapid and effective closure of laparoscopic openings.
Stellar Closure and AETECH won the Jury Prize and the Public Prize respectively, and received a budget of €3,000 excluding VAT and €2,000 excluding VAT to further develop their prototype.
An adrenaline rush for the medical technology industry
The MedTech Accelerator® is specifically aimed at entrepreneurs, researchers and healthcare professionals creating innovations in the medical and e-health sector.
For several months, entrepreneurs are closely supervised by a number of experts and coaches. They follow an intensive programme including practical group workshops, personalised coaching, discussions with the ecosystem and site visits. They also have the opportunity to present their products to different audiences. And the mentoring of the entrepreneurs does not stop at the end of the programme, as the lifetech.brussels cluster continues to provide individual support to each project leader.
“These entrepreneurs are not only developing solutions that improve or even save lives, they are also creating much-needed jobs in Brussels,” explains Evelyne Huytebroeck, Chair of the hub.brussels Board of Directors.
The MedTech Accelerator® is a Brussels initiative developed in 2016 by hub.brussels’ lifetech.brussels cluster and supported by the ERDF. With this programme, hub.brussels aims to accelerate the potential for HealthTech innovation in Brussels by capitalising on the expertise, infrastructures and ecosystems available nationally.
The 2024 edition of the MedTech Accelerator® will be launched in the spring. Information and the new call for projects will be available at www.lifetech.brussels/en/medtech-accelerator-2/


Could you present the missions and ecosystem of Innoviris?
Our first mission is to support and encourage applied research and innovation among Brussels’ players, i.e. research centres (universities, colleges, collective research centres, etc.), companies (start-ups, SMEs, companies in the process of scaling up, large companies), but also players in the non-profit sector and the public sector. Because innovation benefits all these sectors. Our second mission is to promote science, especially among young people: to make them understand the importance of science in meeting societal challenges and to encourage them to pursue a career in STEM (science, technology, engineering and mathematics). Finally, our third mission is to represent the Brussels region at the national (for example by facilitating interregional cooperation in innovation projects) and European level (for example by supporting Brussels companies in their participation in European projects).
What financial aid is available to support the RDI projects of Brussels’ academic actors and companies?
The Regional Innovation Plan 2021-2027, with a budget of €500M, grants subsidies for the co-financing of research and innovation projects within the framework of various programmes depending on the beneficiaries (universities, companies, public-private collaboration), the technical or commercial maturity levels or the themes defined for their strategic nature. The two main types of programmes are open programmes for which we accept applications continuously and project calls with more specific topics and deadlines for submitting applications. Each application is analysed according to several criteria: its scientific or innovative quality, its feasibility, its economic importance and its value for the region. In case of a positive evaluation, we propose that the Brussels-Capital Region
government grant a subsidy. In this way, 300 out of 700 applications are financed each year.
Could you give us some examples?
“R&D Project” is our largest programme. It is an open programme which co-finances industrial research, experimental development or process innovation. In general, small companies and cooperative projects benefit from a higher co-financing rate. The programme “SPIN-OFF” aims to create spin-offs valorizing the results of academic research. A very different kind of programme, “Prospective Research Brussels”, finances academic research projects mainly in the humanities and social sciences that apply the prospective approach to urban issues. The last edition focused on the socio-technical barriers to technological innovation and the political means to remedy them. We are also keen to be accessible to businesses. To this end, we have created a single access point called “Test your idea”: companies are invited to fill in a two-page document to find out whether their project has potential for Innoviris financing or whether they should be redirected to another funding agency. Having been an entrepreneur myself, I can tell you that this is appreciated!
In 2023, the Brussels-Capital Region launched a new tool to facilitate financing and support for innovation to entrepreneurs. Could you tell us more about it?
The new concept is called Innovation Journey (innovationjourney. brussels). Its aim is to make it easier for businesses to access regional aid for research, development and innovation. It is part of the regional “Shifting Economy” strategy, which aims to direct aid towards economic, social and ecological transition. Companies are supported in their research and innovation efforts to meet the societal challenges Brussels is facing. Developing a new idea, getting it validated and scaling it up: all these stages are covered by Innovation Journey, which combines financial support through


Innoviris and finance&invest.brussels with guidance for research, development and innovation projects. To propel the economic transition together with innovators, 10 partners in the Brussels ecosystem pool their expertise. Innovation Journey is a comprehensive, integrated and coherent offering.
Three sectors have been identified as part of the Innovation Journey... That’s right. They are digital technologies, circular economy and social innovation. But that’s not all: we have identified certain gaps and decided to fill them by launching new programmes and initiatives. For example SustAIn.brussels provides free help to enterprises that want to use digital technologies in a sustainable way. It was launched in May 2023 and is part of the new network of European Digital Innovation Hubs dedicated to facilitating business access to new technologies. The name sustAIn means that artificial intelligence is put at the service of sustainability and that it is used in a sustainable way: it helps businesses to choose the best technologies, to access the right training, to find investors and partners. It is a free service coordinated by business specialists (Sirris and Agoria), BeCentral, the digital campus located at the Brussels Central Station and academic partners (the Vrije Universiteit Brussel (VUB) and the Université libre de Bruxelles (ULB)). It is funded 50% by the European Commission and 50% by the Brussels-Capital Region via Innoviris. In addition, sustAIn is working closely with FARI, an independent, not-for-profit initiative in the field of artificial intelligence for the common good, run by VUB and ULB.
Do you have any other innovation programmes?
Yes, and I’m thinking in particular of the Innovative Starters Award (ISA). Every year, the Brussels Region invests €1,500,000 in startups and scale-ups with strong innovation potential. Three laureats receive a grant of €500,000 to finance their strategic innovation plan. The now well-known company Collibra was one of the first

winners of this programme. The Innovative Starters Awards edition 2023 have been awarded to Befemtech, Sentometrics and Wanit.
In your opinion, what are the main challenges to be met in order to strengthen the attractiveness of the Brussels ecosystem in terms of innovation?
Brussels is already a highly innovative region: an Innovation Leader according to the European Regional Innovation Scoreboard 2023. We owe this top status to the quality of our researchers, universities, university hospitals, strong international cooperation and start-ups active in the digital sector. That said, I see two major challenges: the war for talent, as talent is indispensable for companies expanding their innovation potential, and, in the long term, the transition to a more resilient economy, which combines social equity and respect for the environment. Innovation has a major role to play in guiding businesses towards products and services that meet these new needs. Circular economy, health, mobility, better energy production and less energy use: these are all areas of strategic innovation in which the Brussels ecosystem can provide solutions thanks to its high potential.
In 2023, we reached a new and important milestone in our plans to build a Brussels Centre for Science Promotion in the commune of Molenbeek. A first major funding was awarded by EFRO to Innoviris and Citydev for the realization of a Science Promotion Lab, constituting the first phase of the future centre. Our aim with this ambitious project is to make young people and the general public enthusiastic about science and technology, and to let them discover the role of science for society. Through critical thinking, they may also want to become part of the solutions to local and global issues themselves. Innoviris aspires to realise this with the many science promoters already active in Brussels today.
An interview with Dr Marius GILBERT, Vice-rector for research and development, ULB FNRS Senior Research associate, Head of the Spatial epidemiology Lab (SpELL)
What are the key figures and the strong points of research at ULB?
ULB represents around 3600 researchers and professors, 2000 PhD students, 250 theses defended each year, and over 200 research units and interdisciplinary research institutes. By 2020 the university had obtained 40 ERC grants and prestigious scientific prizes such as the 2013 Nobel Prize in Physics for François Englert, several Francqui Prizes and Wolf Prizes as well as 21 FNRS five-year prizes.
Focused on scientific excellence, ULB's research strategy provides a fertile environment for the research community by helping them to seek funding, contributing to the administrative management of projects, promoting independence and academic freedom, and providing support infrastructures. In addition, ULB occasionally offers internal funding (theses, equipment) to encourage the exploration of certain very early ideas and facilitate the subsequent obtaining of external funding.

Could you give us some examples of ongoing research projects in the field of human health?
A brand new institute of vaccinology has just been created with a budget of 40 million euros financed by federal funds and patrons. Led by Prof. Arnaud Marchant (ULB) and Prof. Pierre Van Damme (University of Antwerp), this institute works on the molecular mechanisms underlying the development of vaccines and carries out clinical research for the evaluation of vaccines. The team of Prof. Cédric Blanpain, winner of the Francqui 2020 prize, works on the processes of stem cell differentiation and the regulation of cancer development. Prof. François Fuks' team is recognised for its expertise in cancer epigenetics. This recognition is also shared by the ULB Center for Diabetes Research (UCDR).
Could you present the research activities of SpELL, give us some examples of ongoing projects and indicate the main challenges in this field of research?
The laboratory aims to understand the mechanisms of geographical spread of diseases using statistical modelling, genetic analysis (phylogeography) and virus genome analysis. I am working on the spread of avian influenza in Southeast Asia: this zoonosis has a high pandemic potential and it is important to understand what can slow down or accele rate its spread. In July 2021, epidemiologist Simon Dellicour co-published a paper in Science on the spatiotemporal dynamics of the spread of SARS-CoV-2 in the UK. This work is part of MOOD, an H2020 project funded by the European Commission.
Today, SpELL is mainly confronted with methodological challenges: the aim is to understand how elements of geographical structure are integrated into the genetic analysis in order to better understand the factors that slow down or accelerate the diseases.
Could you give us some recent examples of the valorisation of ULB's research work?
Valorisation of research can take mutliple forms, including collaboration between laboratories and industries, the transfer of intellectual property to partners, the role of experts or the creation of spin-off.
I can highlight the activity of 4 recently founded spin-offs. Founded by Prof. Benoit Vanhollebeke, NeuVasQ Biotechnologies works on neuronal development, mechanisms linking the vascular and nervous systems, and the restoration of lost nervous system func tionality through innovative therapies. ChromaCure was founded by Prof. Cédric Blanpain and focuses on the development of therapies targeting inhibitors of the regulation of cancerous tumours.
Prof. François Fuks founded Epics Therapeutics to explore the potential of molecules targeting genetic mechanisms involving RNA in cancer. Finally, the Secoya technology is based on the integration of the most efficient microfluidic technologies in a robust stainless-steel equipment. This allows the pharmaceutical industry to improve its production processes.

Located at the Brugmann University Hospital, the Clinical Immunology laboratory carries out more than 400,000 analyzes per year, on behalf of 5 public and university hospitals in Brussels. The laboratory also carries out analyzes for hospitals and external laboratories located throughout Belgium as well as for certain French institutions.

With a competent team specialized in the different fields of immunology, the laboratory carries out tests for the diagnosis and monitoring of autoimmune and systemic diseases, allergic diseases and deficiencies of immunity and the complement system. This is a cascade of proteins (enzymes) which can activate or play a regulator y role, occupying an essential place in the development of inflammation and defense against certain micro-organisms.
Since its discovery at the beginning of the 20th century, the complement system has been studied at the molecular and genetic levels in order to better understand its mechanisms and roles. The pathologies in which this system is involved arise either from a deficient action of this cascade by innate or acquired deficiency, or by an excess of its activation due to lack of certain regulatory proteins. The consequences can be severe, with potentially fatal infections or with kidney and blood pathologies.
With its expertise in this field, the immunobiology laboratory is a national reference center for diseases linked to complement system deficiency. As such, the lab was allocated funding from the RIZIV/ INAMI program dedicated to rare diseases. Through its collaboration and synergies with the translational research laboratory on one hand, and the Clinical Research Unit and the Immunoallergology Clinic of the Brugmann University Hospital on the other hand, the immunobiology laboratory has participated in the carrying out of numerous studies on inflammatory diseases, particularly in severe forms of Covid as well as on long Covid syndrome. Other recent studies have focused on the evaluation of the effectiveness of vaccines in immunocompromised



patients (in collaboration with the Infectious Diseases Department of CHU Saint-Pierre and with the Hematology-Oncology Department of HUDERF) and on the immunological side effects of cancer immunotherapy.
Furthermore, the Immunobiology Laboratory is participating in a translational study with an experimental pediatrics laboratory to understand the differences in inflammatory reactions between girls and boys when faced with acute or chronic infections. Molecular systems and certain genes present on the X chromosome are studied to provide clues.
Thanks to its infrastructure and the large number of patient samples analyzed each year, the Immunobiology Laboratory is ideally placed to conduct clinical and exploratory studies. Its main challenge is to identify which of the recently discovered biomarkers can help diagnose an immune deficiency or predict the onset of an autoimmune disease. For example, a personalized medicine in immunology could use autoantibodies as markers to define subgroups of patients to whom appropriate treatments would be administered.
Another development to take into account is the renewal of first-line characterization of immune deficiencies. Until now this has involved biological, functional, lymphocyte and even genetic testing, but with the advent of molecular biology it now increasingly involves broad screening and sequencing of patients’ genomes. Functional tests on cells will become secondary to confirm whether a genetic abnormality really explains a patient’s immune deficiency or whether it is a simple polymorphism. Whether it is a first-line analysis or confirmation of a diagnosis, the Immunology Laboratory still has a bright future ahead!
Clinical Immunology Laboratory
Translational Research Unit, ULB, campus Horta
ImmunoAllergology Clinic
Brugmann University Hospital
Place Van Gehuchten 4 - B-1020 Bruxelles
Email: francis.corazza@ulb.be
https://www.chu-brugmann.be/fr/med/bioclin/

Building on a pioneering training program at ULB, the Osteopathic Sciences Research Unit has developed recognised expertise in joint and soft tissue biomechanics, sensorimotor neuroscience, and movement neurophysiology for neuro-musculo-skeletal therapies.
Developing the osteopathic profession through research and training: this is the dual mission of the Osteopathic Sciences Research Unit (URSO). The hundred or so students inscribed over the last 5 years in the bachelor’s program, the 5 doctoral students and the confirmed Ph.D.s working on this mission attest to the enthusiasm for this new university discipline, developed in close collaboration with the ULB Faculty of Medicine.


With a team of 6 investigators, URSO is equipped with a robotic “haptic” arm to conduct research in 3 intertwined areas: haptic sensation for the identification of musculoskeletal system mobility; mechanisms underlying the onset of chronic musculoskeletal pain (lower back, among others); and improved treatment of pathologies of the musculoskeletal system. URSO’s advances in the fields of neurophysiology and biomechanics combine to characterise tissue characteristics (stiffness, viscosity) that affect the functioning of muscle, tendons and fascia receptors, all of which are essential for tuning muscle tone and movement commands, leading to novel approaches to understanding the aeti ology of pain in the musculoskeletal system.
These three issues are reflected in the URSO’s three types of activities, i.e. basic science, clinical research and public health, with the aim of incorporating osteopathy into integrative care centres to improve the first line of care. In this respect, URSO is participating in the national Be.Hive project (interdisciplinary initiative for the first line of care) which brings together three universities and three “hautes écoles”. This initiative aims to train primary care professionals and benefits from URSO’s evidence-based clinical approach to musculoskeletal pain. URSO is also involved in two flagship international projects. ISMORE (Intracranial System for MOtor REhabilitation), a clinical trial

launched in July 2017 with 7 academic partners, uses brain-machine interfaces, neural decoding and AI to facilitate regeneration of sensorimotor neural connections after stroke. Following encouraging results from an initial patient suffering from stroke-induced hemiplegia, the groundwork is being laid to continue testing with four addition patients with the same chronic condition. The InteX project, completed in 2023, aimed at developing test benches to evaluate next-generation AI for wearable robotics. With 6 European partners and the collaboration of ULB’s Cardio-Pulmonary Exercise Physiology research unit (Prof. Faoro), this project examined the benefits of exoskeletons for worker health and wellbeing: a battery of movement tests was created to check whether fatigue and the risks of musculoskeletal injury can effectively be reduced through the use of this emerging technology. In this context, URSO contributed expertise in clinical functional testing, assessment of muscle coordination, fatigue detection and 3D movement analysis.
Today, URSO aims to position itself in a new promising area of research: the physiology of well-being. The objective is to gain a better understanding of interoceptive processes, i.e. the way in which the brain processes pain. In addition to the interoceptive signals themselves, we also need to take into account the management of the emotions associated with chronic pain. This will enable practitioners to adopt a more global vision (in alignment with osteopathic principles), adapt their treatment to individual patients and circumstances, and better understand the effectiveness of their interventions. The multidimensional nature of pain and pathologies of the musculoskeletal system must be precisely understood: through touch, signals, symptoms, etc. These are all challenges for the fundamental and clinical research carried out by URSO in support of evidence-based therapeutics and patient well-being.

Campus Erasme, Bâtiment N, Niveau 4 / Local N.4.318
CP640 - Route de Lennik, 808
B-1070 Anderlecht
Tel.: +32 (0)2 555 38 91
Email: Ana.bengoetxea@ulb.be

https://cvchercheurs.ulb.ac.be/Site/unite/ULB566UK.php
An interview with Pr Carine VAN LINT, Director of Research F.R.S.-FNRS, Head of the Service of Molecular Virology at the Université libre de Bruxelles (ULB), Member of the International AIDS Society Scientific Working Group on HIV Cure
What expertise have you developed in the field of epigenetic mechanisms regulating gene expression of retroviruses, and what are your main discoveries in this area?
For more than 30 years I have been studying the transcriptional and epigenetic mechanisms regulating gene expression of the retroviruses HIV-1 (Human Immunodeficiency Virus type 1), HTLV-1 (Human T-lymphotropic Virus type 1) and BLV (Bovine Leukaemia Virus). In the context of HIV-1 and BLV, my laboratory has largely contributed to characterize and determine the role of chromatin structure in the molecular mechanisms regulating these viruses, in particular by studying nucleosome positioning, chromatin remodelling and epigenetic modifications (such as histone acetylation and methylation and DNA methylation). We have highlighted the key role of certain cellular factors (such as CTIP2/Bcl11b, UHRF1 (R. Verdikt et al., 2022, eBiomedicine), AhR (D. Chatterjee et al., 2023, Cell Reports) and CTCF (M. Bellefroid et al., 2022, Nucleic Acids Research)) in the transcriptional regulation of HIV-1 and BLV, respectively.

What therapeutic avenues are you currently exploring in the field of HIV ? The major problem in eradicating HIV-1 is the persistence of latent “cellular reservoirs” which express little or no virus but which can be reactivated by various cellular stimuli. These reservoirs explain the rebound in viremia observed in most patients after interruption of the combination antiretroviral therapy (cART). This rebound is due to the reservoir cells in which the virus hides from the host immune system and escapes the cART treatment, waiting for a sign of immune weakness before re-emerging. The virus is in a state of latency in these reservoir cells, where its transcription is repressed by various mechanisms, including epigenetic modifications. On this basis, several international consortia, of which my laboratory is a member, have proposed “shock and kill” strategies aimed at deliberately reactivating the viruses contained in these reservoirs using latency reversing agents (LRAs) (A. Rodari et al., 2021, Annual Review of Virology). The aim of this reactivation is to eliminate the latent HIV reservoirs, while maintaining cART to prevent the spreading of the virus. This kind of strategy would allow the “kill” phase during which latently-infected cells would then die from viral cytopathic effects or host immune clearance. We obtained fundamental results demonstrating the reactivation of HIV-1 by a sequential combination of two LRAs: a DNA methylation inhibitor and a histone deacetylase inhibitor, thereby targeting two impor tant mechanisms of HIV-1 epigenetic repression. This discovery led to the launch of an international clinical trial which is currently underway in collaboration with Prof. Stéphane De Wit at the CHU Saint-Pierre in Brussels (ULB). Another important therapeutic strategy being studied
by various international researchers and our laboratory is the “block and lock” approach, which consists not in reactivating but in reinforcing the latent state of the viruses to avoid a reb ound in viremia after stopping the anti-HIV treatment. These are the strategies being dis cussed by the International AIDS Society Scientific Working Group on HIV Cure, a group of internationally recognized experts chaired by the 2008 Medicine Nobel Prize Laureate Francoise Barré-Sinoussi, of which I am the only Belgian representative.
What do you see as the main challenges in controlling HIV replication in the long term?
The main challenge is to gain a better understanding of the molecular mechanisms involved in the persistence of the HIV-1 virus, so as to be able to develop effective new strategies aimed either at eliminating latent reservoirs or at reinforcing the latent state of the virus so that it is no longer able to ‘wake up’. However, the molecular mechanisms involved in HIV-1 latency are multiple and heterogeneous, and it is therefore very complicated to target all the mechanisms involved in the different cellular reser voirs with a single agent. The current aim is therefore to reactivate highly reactivatable viruses and block the expression of viruses that are more difficult to reactivate, in the majority of cellular reservoirs, with the goal of achieving control of HIV infection by the host immune system in the absence of antiretroviral therapy.
https://smv.ulb.be

What are the key numbers and areas of excellence in the field of research at UCLouvain Saint-Louis Bruxelles?
UCLouvain Saint-Louis Bruxelles excels in social sciences and humanities: law, political and social sciences, economics and business administration, philosophy, history, literature, translation and European studies. UCLouvain Saint-Louis Bruxelles has resisted compartmentalization, which at times may lead to differences in methodology and subjects between the various disciplines, and has acquired a widely recognized expertise in interdisciplinary practice, even in research, the originality of which makes its excellence. Whilst research contributes to opening new fields of knowledge, the interdisciplinary methods remain among the most efficient ones, due to their inherent creativity. The recent merger with UCLouvain does not change this dynamic in any way: the Saint-Louis campus will continue to develop these areas of excellence while enabling it to increase its international visibility.

The following key numbers translate the FNRS’ recognition of our fundamental research. Over the last 5 years, an average of 34% of our FNRS applications were successful, putting us regularly ahead of the global figures of the Fédération Wallonie-Bruxelles. We are equally proud of our average 42% admission rate to the Humanities Research Fund (Fonds pour la Recherche en Sciences humaines – FRESH) launched 10 years ago, which is an essential tool in our field of disciplines.
Could you cite a few examples of the current research programs at UCLouvain Saint-Louis Bruxelles?
Like the other universities of FWB (Fédération Wallonie-Bruxelles), UCLouvain Saint-Louis Bruxelles benefits from special research funds and manages to finance a great number of doctoral research fields. We have recently launched a new interuniversity research project (Action de Recherche Concertée or ARC), TAXFAM. This is the latest

iteration of an ongoing fiscal micro-simulation research project funded by Innoviris (the Brussels Region Institute for Research and Innovation), which has been underway since January 2020. Another Innoviris project also started recently: AUTOBLOC, a research aimed at analyzing the social and technical barriers to softer mobility policies.
What research partnerships have you developed at a European level?
At UCLouvain Saint-Louis Bruxelles, we are particularly proud of the European dimension of many of our research projects. We currently have three ongoing ERC projects (Coaching Rituels, DATAUNION, Bildung Learning), a Jean Monnet Centre of Excellence (EUNMUTE), and four Jean Monnet Chairs (EUGENDERING, EU Indo-Pacific, Regulating Africa-EU Value Chains and EUGlobalGreen). Our research centres also develop international cooperation programs with a great number of European universities. Several transnational research projects involving the UCLouvain Saint-Louis Bruxelles have been funded by the European Commission under its Erasmus+ program. Among them, “RE-VISUALIZE: Gender and Islam in the Francophone Digital World and“ “ARIE,” “Arriving in Europe, Departing from Europe: Turkish and Moroccan Trajectories” are still ongoing. Our research administration has done a tremendous work in obtaining these grants.
How do you value the research work coming from UCLouvain Saint-Louis Bruxelles?
Our university has developed the valorisation of its research with the support of the Brussels (Innoviris) Region. Our Knowledge Transfer Office (KTO) ensures the link between research at the university and the non-academic world. Its task consists in taking care of the diffusion, the mobilisation and the knowledge transfer to society, and in creating collaborations and exchanges between society and the university. In this regard, UCLouvain Saint-Louis Bruxelles recently launched a podcast aimed at promoting the research carried on by its researchers, with a special focus on Brussels. We are also an integrated member of the LIEU network, which gathers the KTOs from Universities within the FWB.
Although this type of research valorisation represents a quite recent development, let us stress that, for a long time now, some of our research centres have shown a keen interest in regional integration, particularly with regards to very advanced research on Brussels. Our Institute for Interdisciplinary Research on Brussels (IRIB) gathers these centres and hosts centres from other universities. We play a leading role in the Brussels Studies Institute (an interuniversity research platform on Brussels) and in the online magazine “Brussels Studies”. Thanks to our expertise, acquired through our research work on Brussels (par ticularly with regards to mobility issues), we have obtained many regional-funded research projects.

The Institute for Interdisciplinary Innovation in healthcare (I3h) aims to educate the next generation of healthcare professionals and to develop scientific knowledge in a way it can efficiently contribute to foster innovative technologies and strategies in healthcare.

We want to bridge competencies and expertise from various disciplines and foster collaboration to contribute to patient-centered healthcare advances,” explains I3h-co-director, Prof. Dr. Hilde Stevens. “It is organized as a virtual institute, a collaborative research and education environment, linking comple mentary expertise to elaborate and educate.”
“Healthcare is entering a new era, characterized by therapeutic and preventive solutions, tailored to individual patients’ needs. Another characteristic is the use of newly developed tools, based on emerging technologies and artificial intelligence. The approach is very data-intensive. The novel health technologies should go together with new economic models.”
I3h is a partner in several interdisciplinary and international proj ects. “A good example is Hi-Prix, involving 18 partners from 10 European countries, including academic institutions, public authorities, healthcare providers, and independent research organizations. Through theoretical models, quantitative simulation, qualitative research work and case-studies, this three-year EU-funded project will generate new evidence on: a) the role of the public sector in R&D, b) indirect medical and environmental costs in pricing and reimbursement determinations, c) the pricing dynamics over pharmaceutical products’ lifecycle, and d) the impact of policies and incentives on the competitiveness, innovativeness and equity in the healthcare system. We will map and formulate new pricing and payment schemes to use across technology classes, therapeutic areas, settings, and healthcare systems/geographies to guide successful adjustment and flexible implementation. However, the lack of appropriate data infrastructure, legal barriers, and unwillingness to adapt current systems often impede the use of these schemes.”
Cancer in children remains a major source of suffering: in Europe, every year around 35,000 children are diagnosed with, and around 6,000 children die from cancer. “Despite major advances in cancer research, children benefit much less from this progress than adults. Some tumours (e.g., neuroblastoma) are almost exclusively observed in children. The development of new therapeutics for children with cancer, however, is hampered by the rarity of each

individual childhood cancer. This makes drug development economically unattractive, resulting in a low interest in paediatric cancer from the traditional pharmaceutical industry.” To improve this situation and to ensure that research leads to access to novel treatments for children, I3h collaborates with Sam Daems, director at Waterland, who tragically lost his daughter to an incurable brain tumour. “Together with the team of KickCancer Foundation (Belgium) and the Imagine for Margo Foundation (France), we developed a novel economic model, published in Nature Reviews Drug Discovery and featured in the Financial Times. It is based on combining resources from public and private parties, profit and non-profit, in a pooled fund which optimally balances risk and returns. This fund will invest in a portfolio of development programmes, each focused on a specific paediatric therapeutic target, reducing the investors’ risks as much as possible. Therefore, early in the development, long before the new medicines are approved by health authorities, pre-agreements will be negotiated with the organizations responsible for their reimbursement.”

Every year, I3h organizes the Interdisciplinary Program in Healthcare Innovation. “This is our educational flagship,” says Hilde Stevens. “Healthcare experts from various domains share their views on challenges and opportunities to establish sustainable, affordable, accessible and patient-centric healthcare systems. It runs in all Belgian universities, and increasingly also in various European universities and health organizations, each time attiring around 120 participants. The program is increasingly followed by master and PhD students, postdocs and professionals interested in healthcare innovation.”
Institute for Interdisciplinary Innovation in healthcare Campus Solbosch
CP135, Avenue Paul Heger 6 - B-1050 Brussels Campus Erasme
Route de Lennik 808 - B-1070 Brussels
Tel.: +32 (0)2 650 21 05 - Email: info@i3health.eu
https://i3health.eu/

The Institute Jules Bordet (IJB), which is affiliated with the Brussels University Hospital (HUB) and specializes in the field of oncology, employs a multidisciplinary approach encompassing various healthcare domains pertinent to cancer treatment. The primary mission of this institution is the delivery of effective treatments within a patient-centered framework. This mission is realized through a tripartite structure that encompasses clinical care, research, and educational initiatives.
Much like the overarching structure of IJB, the Medical Physics Department at HUB adopts a tripartite framework, constituting a multidisciplinary unit. This unit comprises Medical Physicists accredited by the Federal Agency of Nuclear Control (FANC), engineers specializing in equipment maintenance and quality assurance, data scientists, a dosimetry team, and a dedicated research division functioning as a university laboratory. The department operates as a hub for fostering research innovation, applying cutting-edge technology, and promoting interdisciplinary collaborations with the ultimate goal of augmenting healthcare outcomes through technology-driven and data-centric methodologies.

The department maintains intrinsic connections with the Departments of Radiation Therapy, Nuclear Medicine, and Radiology. Through concerted collaborative efforts, the department is committed to facilitating the seamless integration of emerging technologies (as detailed below) into the clinical workflow, thereby enhancing the precision of diagnostic procedures and the efficacy of therapeutic interventions. Our research endeavors also concentrate on the amalgamation of multimodal imaging and dosimetry within the framework of precision radiotherapy, encompassing MRI-Linac and Nuclear Medicine Theranostics (notably 68-Gallium/177-Lutetium PRRT and PSMA).

The establishment of a specialized Data Science unit within the department represents a significant milestone. This unit is responsible for amalgamating diverse datasets sourced from the hospital’s infrastructure. Employing machine learning algorithms, the unit concentrates on developing predictive models based on biomarkers and multi-omics data, thereby pioneering advancements in personalized medicine. Additionally, the data science unit harnesses AI and deep learning techniques to automate labor-intensive tasks within the domains of Radiation Therapy, Nuclear Medicine, and Radiology. In this context, our team is actively engaged in refining data collection methods through the concept of data farming, as well as improving image segmentation (covering CT, MRI, and PET images), predicting absorbed doses, generating pseudo-CT images from MRI data, and modeling TCP/NTCP.
The department extends 3D printing services across various departments, encompassing the production of bolus materials for radiotherapy, phantoms for quality control in nuclear medicine and radiology, and simulations of surgical interventions. Furthermore, the department is venturing into the domain of biocompatible printing







in collaboration with the Laboratory of Clinical Cell Therapy. This exploration aims to unlock the potential for advancements in tissue engineering and regenerative medicine.
The department is actively involved in the evaluation and integration of cutting-edge therapeutic modalities. Current focal areas include the development of image quantification and dosimetry techniques in Nuclear Medicine Theranostics, enabling patient-specific definition of therapeutic windows for these treatments. Initiatives like the introduction of Flash therapy, an innovative radiation therapy technique, and the utilization of MRI-Linac for daily adaptive radiotherapy with continuous MRI imaging during irradiation are actively pursued. Ongoing research in Boron Neutron Capture Therapy (BNCT) is also underway, with plans to establish a dedicated BNCT system in a new facility. Also, our team plays a pivotal role in the preclinical research, for the medical physics aspects, associated with these cutting-edge therapeutic methods.
Collaborative projects with industry leaders such as Elekta, Siemens, GE Healthcare, and IBA serve as bridges between academia and industry. The department, in this capacity, acts as a crucible for knowledge transfer, catalyzing advancements in medical technology.
Aligned with its commitment to scholastic rigor, the department hosts a contingent of PhD candidates and post-doctoral researchers engaged in projects funded by the Jules Bordet Association, Télévie, FNRS, and Biowin. These early-career scholars are integral to the department’s ongoing research endeavors. In summary, the Medical Physics Department at the HUB extends beyond its traditional disciplinary boundaries, serving as a vanguard in healthcare innovation and collaborative research. Its activities are geared towards optimizing patient care through technological and data-driven solutions, making significant contributions to the healthcare landscape.




Cohesion policy is the main long-term investment policy of the European Union (EU). Its aim is to reduce social, economic and territorial disparities between the different regions of the EU. It also strengthens cooperation between regions, particularly across borders.
It is impossible to list all projects financed by Cohesion policy, as they are so numerous. So I’m only going to mention a few concrete projects that ranks Wallonia among the leading European regions in the field of Research, Development and Innovation.
Europe does not fund these projects alone. Wallonia is also contributing.
The European Regional Development Fund is one of the main instruments of EU cohesion policy.
It has 2 main objectives:
- Investment for growth and employment, with a view to consolidating the labour market and regional economies.
- European territorial cooperation, with a view to strengthening cross-border, transnational and interregional cooperation within the Union (through INTERREG).
The BIOMED Technology support project in the Biomed-Hub portfolio aims to acquire cutting-edge equipment to conduct research in the biomedical sector, particularly in the fields of geno-proteomics, clinical imaging and pre-clinical surgery.
This project is designed to support the cutting-edge work that has been carried out for several years at ULiège’s GIGA centre (biomedical and interdisciplinary research centre) and its Cyclo tron Research Centre (CRC).
Exceptional technological equipment for research and innovation, given its cost of implementation and the growing expertise it requires, is a major barrier for SMEs in the biomedical sector. The challenge is to facilitate access to such equipment. European and Walloon funding play a fundamental role in this.
Within the Wallonia-Biomed portfolio, the ERDF programme continues to support the CMMI (Centre for Microscopy and Molec ular Imaging), based in the Charleroi Biopark. The CMMI focuses on life sciences, which require increasingly high-perfor-

mance imaging tools. Imaging has become essential for highlighting molecules, proteins and cells of interest, locating them within a living organism or assessing their effects as part of the development of new therapies.
For the scientific and industrial communities, having imaging centres organised in the form of “Core Facilities” is essential if they are to remain competitive. With this in mind, ULB and UMONS have set up the Centre for Microscopy and Molecular Imaging, with the support of European and Walloon funds.
The aim of the 2021-2027 ERDF programme is to pursue commitments in the field of Research, Development and Innovation. It targets 5 strategic objectives: a smarter, greener, more connected, more social Europe that is closer to its citizens.
The Cybergalaxia portfolio will produce two TRL 6 cybersecurity demonstrators to be located in the Galaxia centre. This will help to put Wallonia in pole position in the field of cybersecurity. To achieve this objective, a programme to increase coordination between Walloon players active in the field of cybersecurity is
being set up at regional level. This CyberWal programme will create a structuring framework for all the initiatives and players involved in the Region’s digital transformation, and will promote research, innovation and training in cybersecurity in order to develop synergies between these players, all in line with the regional policy conducted in this area, and in particular with the DW4Cyber programme.
The CanPro project, part of the MedResyst portfolio, aims to develop a tool to assist in the screening and diagnosis of prostate cancer and, ultimately, in the management of patients, and to make it available to the Walloon hospital network.
The aim of this tool is to improve the efficiency of screening, anatomopathological diagnosis and follow-up of patients with prostate cancer by better targeting of sites to be biopsied on imaging and more objective determination of the morphological grade of malignancy of these cancers.
2) European territorial cooperation (Interreg)
Interreg is one of the European Union’s instruments for supporting cross-border cooperation by funding, among other things, Research, Development and Innovation projects.
The aim of the PathaCOV project is to develop a simple, non-invasive and inexpensive technique for the early detection of bronchopulmonary cancer in at-risk populations, namely smokers aged over 50. Early detection increases the rate of cure from 15 to 80%.
The partners - 5 hospitals and 6 research laboratories on either side of the Franco-Belgian border - have joined forces to develop this screening technique, which uses a sensor to analyse volatile organic compounds (VOCs) in people’s breath. This sensor is used to discriminate between the electrical signals detected in the breath and those corresponding to VOCs suspected of being markers of bronchopulmonary cancer.
The MATTISSE project is proposing a new bioprosthesis designed to help the body restore damaged areas following surgery.
The surgical treatment of serious pathologies such as breast cancer sometimes results in tissue loss, particularly after removal (mastectomy), which is performed in almost 73% of cases.
The aim of the project is to provide patients who have undergone this treatment with a natural prosthesis made from their own fat cells, which is biodegradable and does not require a second operation.
The aim of the “Healthy Ageing” project is to strengthen research, technological development and innovation in the medical field of age-related chronic diseases.
The KIDSHEARTS project aims to develop an infant cardiac surgery activity to improve the quality of life of the population in the Franco-Belgian border area, in particular by reducing the risks currently associated with transfers of newborn babies to Paris and Brussels. These long journeys for indefinite periods often have serious consequences for families. The partners are joining

forces to promote the training of professionals in order to achieve the required level of expertise.
The ParkinsonCom project aims to co-construct an evolving communication aid for people with Parkinson’s disease, taking into account the progression of the disease.
The list of projects supported is long, but these few examples demonstrate that European funding plays an essential role in Research, Development and Innovation in Wallonia. These investments are helping to strengthen the region’s excellence in a wide range of fields, from biomedicine to cyber security. This funding is crucial for advancing knowledge, stimulating innovation and promoting the development of Wallonia.
The future of cohesion policy is at the forefront of discussions of the Belgian Presidency of the Council of the European Union, which began on 1 January 2024 for 6 months. As Minister-President of Wallonia, have the honour of chairing the Cohesion configuration of the Council of the European Union. I am determined to reaffirm the place of cohesion policy at the heart of the European project. While adapting cohesion policy so that it can continue to reduce economic, social and territorial disparities within the European Union, its Member States and its regions. And continue to complement the deepening of the internal market.
Research is a real strength of our Region. Its reputation gives us an important place on the world stage, whether in the fields of space, aeronautics, biosciences, pharmaceuticals or chemistry.
The pharma and biotech sector is a major sector of the Walloon economy in which the Region is an international leader. It has a critical mass of academic and industrial players in the fields of treatment, vaccines and diagnostics.
Wallonia is a “land of life sciences” thanks to:
- its strong technological expertise
- active and innovative scientific and academic ecosystems, attracting many international biotech companies to set up their R&D centres and/or production units
- the presence of multinationals, which act as a driving force for start-ups
- financial support and a favourable tax environment for R&D
- its ideal geographical location at the heart of Europe and one of the densest multimodal networks in Europe.
It’s a sector that provides jobs for the region (nearly 20,000 direct jobs and more than 50,000 indirect jobs), setting an example in terms of R&D and Innovation, but also in terms of investment since it is constantly being renewed.
Pharmaceutical exports make a major contribution to our trade balance, and 2022 confirmed the positive trend seen in 2021. Pharmaceutical products are still by far our biggest export item, accounting for €18.8 billion in 2022, or 31.4% of the Walloon total.
In Belgium, the chemicals and pharmaceuticals sector accounts for two-thirds of all industrial investment in R&D and one-third of patents granted. The Belgian chemical and pharmaceutical sector devotes the largest share of its profits to R&D investment in the European Union! It also employs the most people in research activities (one in eight employees in the sector). In 2022, patent applications in the chemicals, pharma & biotech sector reached a record number (1,071) in Belgium. Our country ranks 4th in the world for the number of patent applications per inhabitant in chemistry and life sciences.
I would like to take this opportunity to underline the importance of Research and Innovation for Wallonia in our Recovery Plan. This area mobilises the largest budget within my remit, with a total of €728 million. This amount is in addition to the ordinary budgets. Never before have so many resources been mobilised for research in Wallonia.

Support for research should be seen as an investment in the future, to meet the challenges facing our society. By 2021, Belgium will have devoted 3.43% of its Gross Domestic Product (GDP) to R&D, making it a leader in Europe.
Wallonia has achieved European recognition as a ‘region strong in innovation’. Our aim is to continue these efforts. Various tools have been put in place in Wallonia to support research by companies, research centres, universities, colleges and research bodies, such as research grants, technology incubators and Walloon economic and financial tools. These have been merged to improve the impact of the Region’s interventions, particularly for businesses and the self-employed.
For the year 2022, €539 million has been invested by Wallonia, via the Research Directorate of the Walloon Public Service. This represents more than 700 dossiers for 325 companies, as well as French-speaking universities, colleges, approved research centres and research organisations. 171 innovation cheques were issued for a total amount of €1.5 million. I have also carried out a complete overhaul of research grants to simplify access and make them easier to understand. This reform eliminates duplication and, above all, fills identified gaps to better meet the needs of businesses, academics and research centres. This reform has been carried out with the constant concern to concentrate public

resources, in line with the Smart Specialisation Strategy (S3), since the objective is for 70% of funding to be granted to projects in the Strategic Innovation Domains (SIDs) of the S3. The adoption of the S3, which aims to concentrate our forces so that research and innovation enable us to respond better to the challenges facing Wallonia, is just one stage in a process of mobilising the entire regional ecosystem to achieve strong ambitions for Wallonia. As a reminder, the SIDs consist of a coherent and ambitious set of innovative activities with a strong economic impact and societal contribution. These SIDs therefore help to strengthen the economy and employment. It is clear to our Government that Wallonia’s recovery will depend on massive support for these areas.
An important step has recently been taken in the implementation of the Walloon S3: 19 Strategic Innovation Initiatives (SIIs) have been selected following calls for projects with a total budget of €60 million. These projects will enable the various SIIs to pursue their roadmap in order to place Wallonia at the forefront of these priorities. We have also set up SID coordinators within the clusters, who help promoters to structure their projects in order to find the most appropriate funding. Calls for projects have been launched for 2023.


Among the projects implemented under our Recovery Plan, one supports strategic research - at the interface between fundamental and applied research - by increasing the resources allocated to life sciences and supporting the development of a new technological focus.
From the outset, we have increased the resources allocated to strategic research in the life sciences, reaching an annual grant of €15 million per year, more or less double the previous figure. We reviewed this support in order to focus on supporting excellent researchers and their teams. But we also wanted to broaden the areas supported, which is why WELBIO has been restructured and renamed to create the not-for-profit WEL Research Institute (WEL-RI), comprising two departments:
- WELBIO - €15 million / year
- WEL-T (Walloon Excellence in Technology) - €9.75 million / year.
WELBIO will continue to support strategic research of excellence in the life sciences with a view to developing discoveries for industrial applications in all areas of medical, pharmaceutical and veterinary biotechnology, and WEL-T will support strategic research of excellence in the engineering sciences, chemistry and physics with a view to developing breakthrough innovations for industrial applications aimed at sustainable transition. WEL-RI complements existing research funding schemes.
The Fonds pour la Recherche Fondamentale Stratégique (Strategic Fundamental Research Fund - FRFS), which is 100% funded by the Walloon Region and managed by the FNRS, has its own governance structure through the WEL-RI. In a nutshell, the aim is to support fundamental research through rigorously selected projects from universities in the Wallonia-Brussels Federation, with a view to developing discoveries for industrial applications in all the fields covered by WELBIO and WEL-T. Through the FRFS, Wallonia grants significant resources over several years to top-level researchers proposing a scientifically excellent research project with real potential for development.
Every day, research and development sow the seeds of our future growth and prosperity.

The Institute of Pathology and Genetics (IPG) is a non-profit association founded in Charleroi, Belgium in 1958. It has 320 highly specialised and dedicated staff. Each year it carries out more than 350,000 analyses.
In 2022, the Institute achieved a turnover of 50 million euros, included BIO.be/Seqalis, its subsidiary founded in 2006 to serve biotechnology companies and the pharmaceutical industry. The IPG’s activity is based on 3 essential pillars: anatomic pathology, the molecular biology laboratory and the human genetics centre, one of 8 such centres in Belgium. In anatomic pathology, the pathologists use conventional and digital microscopy, immunohistochemistry with PDL1 markers, the latest generation sequencing as well as quantitative and digital PCR in order to carry out examinations in fields as varied as pneumology, gynaecology, haematology, dermatology, neurology, surgery and cytopathology.
In the field of human genetics, a double-specialised team of paediatricians and nephrologists with super specialization in genetics carry out supervised laboratory tests and family consultations for patients with rare diseases: diagnoses and prescriptions for innovative treatments are planned in this framework. Finally, the molecular biology activities bring together technologists, scientific experts and bioinformaticians highly specialised who carry out tests for constitutional and genetic diseases in order to guide diagnosis and define targeted oncological treatments that can increase patient survival.
The IPG carries out genetic consultations on its site but also on those of partner hospitals in Wallonia: e.g. the CHR of Namur, the Grand Hôpital de Charleroi, HUmani, the CHC of Liège, Vivalia, Chwapi, CHU Ambroise Paré, Groupe Jolimont, Epicura, CHU UCL Namur... It also collects samples from these hospitals, which commission it to carry out the three main types of examination mentioned above. In addition, its anatomopathologists participate in multidisciplinary oncology consultations in order to define targeted diagnoses and treatments.
The IPG is also an official research institute with an annual budget reserved for this activity. 25 projects are underway in collaboration with universities such as French, European (in the framework of European networks dedicated to genetics) and American centres. The aim is to improve the understanding of rare diseases in order to upgrade the multidisciplinary management of patients. In addition, the IPG has been collaborating for several years with the Grand Hôpital de Charleroi on a “rare disease function”, a programme of the INAMI (health insurance) that aims to improve the care of people suffering from kidney or metabolic diseases and their families.
At present, the IPG wants to make itself more accessible to clin ical doctors by digitalising its activities in order to increase its diagnostic performance for the benefit of referring doctors and patients. Other challenges include the training of doctors in

molecular pathology for innovative diagnostics, technological mastery in genomics (sequencing of the exome, or even the entire genome with the increase in bioinformatics calculation capacities) and overall technological mastery (PCR tests, RNA seq for the diagnosis of lung cancer, digital PCR for the search for anomalies and the follow-up over time of patients with breast cancer thanks to less invasive liquid biopsies. The IPG is also evaluating the potential of Optical Genome Mapping (Bio Nano Genomics). To meet these challenges, the IPG has recently recruited three new pathologists, as well as two new scientific experts, and keeps on collaborating with an oncology consultant to ensure that its diagnostic offer is always up to date and to better orient towards personalized therapies. The IPG has also extended its building by 800 m² in order to group together its sequencers (including the 3rd generation Oxford Nanopore DNA-RNA sequencer used in particular for the detection of certain large structural variants in the context of constitutional genetics projects) for better coordinated management.

Institut de Pathologie et de Génétique
Avenue Georges Lemaître, 25 B-6041 Gosselies
Tel.: +32 (0)71 47 30 47
Email: secretariat.direction@ipg.be
http://www.ipg.be
Seqalis, spin-out of the Institut de Pathologie et de Génétique, IPG, in Gosselies, embodies in its very core the concepts of Services, Sequencing, Quality Assurance and Life Sciences. Seqalis aims at becoming a key long-term and trustworthy Contract Research partner of pioneering biotech, pharmaceutical companies and leading academies.
Seqalis’s 19-year long successful history progressively shaped its capacity to provide their customers with unrivalled R&D services coupled with medico-scientific counsels in booming domains such as Immuno-oncology, Cell & Gene Therapies and Microbiology. Over the years Seqalis has developed an unique analytical service offer in Anatomical Pathology, Cytogenomics and Molecular Biology (NGS and PCR).
In October 2022, Seqalis officially settled in its brand-new laboratory facilities spanning 500 m² within the newly-built wing in the IPG building, hence emphasizing on its strong willingness to be fully dedicated to the delivery of top-notch quality services to its current and future clients. For the time-being the laboratory hosts the whole NGS processes especially the qTCR Seq platform, its proprietary un-biased sequencing process to quantitatively analyse the receptor repertoires of T lymphocytes for immune-oncology drugs, vaccines and cell therapy developments. Seqalis is planning to acquire additional NGS instruments in the years to come to be able to keep abreast with the increasing analytical demand in that field.
In December 2022, Seqalis and the Translational Oncology department of the IPG presented a poster entitled “Spatial sequencing of T cell repertoire in breast cancer” at the ESMO conference in Geneva, showcasing the successful combination of its qTCR Seq platform with the very promising 3D-transcriptomics technology from 10X Genomics, US. This proof-of-concept work demonstrates the feasibility of spatial TCR sequencing in tumor biopsies, providing a new method to explore the spatial organization of T cells clonotypes in the tumor microenvironment, to explore T cells functional profiles at the clonal level and to follow modifications during tumor development and treatments.
In 2023, Seqalis partnered with the De Duve Institute in Brussels and the Belgo-French cancer vaccine leading company PDC*line Pharma to broadcast a very enlightening and insightful webinar for everyone involved in cancer research, breakthrough immunotherapies and better immuno-monitoring procedures.


Seqalis has also gained further ground in the 2 other markets being focussed on, the ATMP’s (Advanced Therapy Medicinal Products) and Microbiology. As for the ATMPs, its diversified and very complementary cytogenomics analytical platform ranging from classical karyotyping, FISH, SNP array to Shallow Whole Genome Sequencing turned out to be instrumental in convincing leading CDMO’s and biotech companies to call upon these services for controlling the genomic stability and integrity of their cell therapies.
Seqalis’s future definitively looks very bright in that sector with the progressive entry of new promising and potentially game-changing technologies such as the OGM (Optical Genome Mapping) from the company Bionano, US.
Last but not least, Seqalis has also made excellent foray into the microbiology fields thanks to the increasing collaborative works established with first-class scientists in the academic world specially in Belgium and in France.
Seqalis has bright short- and longer-term perspectives in developing its activities throughout Europe and soon in North America. The company is eager to grasp any new market opportunities taking advantage of its unique know-how in order to help its clients improve the daily quality of life of patients.

Seqalis
25, avenue Georges Lemaître B-6041 Gosselies
Tel. : +32 (0)71 347 898
Email : info@seqalis.com
https://www.seqalis.com

What are the missions of the Department of Research and Technological Development?
With a budget of nearly 350 million euros, the department is the main provider of funds in Wallonia for the financing of research: companies, whatever their size, research centres, universities and university colleges can apply for R&D funding.
To do this, we have two mechanisms, within a general system called ‘Win4research’: ‘window’ aid (which are our own programmes) or collaborative programmes (those in which Wallonia participates with other funding agencies, especially in an international framework).

I would also add the financing of projects of competitiveness clusters when the latter launch their own calls.
In addition to this first mission, we also accompany these research players. How do we do this? We help them, for example, to file a patent, to promote their research…

And thirdly, there are awareness-raising and popularisation actions through the Science, Technology, Engineering, Arts and Mathematics (STEAM) strategy supported by the Walloon Government, competitions such as L’Odyssée de l’objet, CANSAT or the publication of a magazine for over 30 years, Athena.
Could you tell us about the research support mechanisms for these Walloon research actors?
As I was saying, on the one hand, there is the “window aid”. This is aid that takes the form of a grant or a repayable advance and that varies in intensity according to the size of the company and the qualification of the research (industrial research or experimental development). Unlike universities, which are financed at 100%, or research centres, which are financed at 75%, the regulations on State aid do not allow us such rates. In concrete terms, this means that a company that has a project to finance submits it to us, we analyse it and, if necessary, g rant financial aid.
On the other hand, there are calls. There are two types: regional and international. In these cases, the department launches, alone or with the support of the European Commission in most cases, calls for projects. They can be thematic or non-thematic. In this case, a timetable is set: a start date, an end date and an evaluation and ranking process are specified.
The international calls allow, as their name indicates, Walloon R&D actors to have an opening towards external markets and collaborations that they might not have internally.
Finally, I would also like to mention more specific aids, such as those which allow the creation of spin-offs or which offer companies the possibility of hiring a doctoral student.
To what extent is your Department involved in the Recovery Plan?
In October 2021, the Walloon Government presented its Recovery Plan, which was born from the merger of three other initiatives: Get Up Wallonia, the Recovery and Resilience Facility (European recovery plan) and the Transition Plan (which was included in the regional policy declaration).
7.64 billion euros are to be invested in Wallonia between 2021 and 2024.

Among the axes of this plan, which includes economic development, there are various research initiatives worth 609 million euros, which is not negligible.
Among these projects, some of which have already been completed, such as the development of a Walloon space value chain (more than 20 million euros) or the strengthening of defence skills (35 million euros). I would also highlight the development of collective research programs.
A call for interest is currently underway to bring together research centers around a single theme: materials. Recently, we set up a hydrogen sector as part of the IPCEI (Important Projects of Common European Interest).
The tempo is now set: we must move forward. I am firmly convinced of the link between the economy and research and of the importance of public support for research.
In this respect, I would like to remind you that this year more than 3% of the GDP in Wallonia was invested in R&D and that our region is, every day, a welcoming economic space for innovation. We are among the leaders in Europe.
2024 will be an important year for Belgium which will chair the European Council.
During the first half of the year, Belgium will be the rotating President of the Council of the European Union. This had not happened since 2010 and the next one is not planned until 2035 or 2036!
Wallonia, for the first time, has the lead in research. This means that the department, in collaboration with other relevant administrations, participates in the intra-Belgium discussion, led by the Belgian Permanent Representation to the European Union and the FPS Foreign Affairs but also takes part to ad hoc inter-ministerial committees. Many working groups have been set up and, here again, the department is chairing them.
The European Commission has given us a whole series of tasks which must be carried out, such as mid-term reports on certain European initiatives. We are doing so in perfect harmony with our colleagues.
Many scientific events are also on the agenda: a conference on researcher mobility, another on industry, on health… In total no less than 27 scientific meetings are planned.





















Could you tell us about the missions of the Science Policy Pole in Wallonia?
The Science Policy Pole is an advisory body whose main mission is to issue opinions on science, research and innovation policy. It is made up of players representing the diversity of the R&D&I landscape (research centres, businesses, universities, higher education institutions, trade unions and representatives of environmental associations), which enables it to add real value to Wallonia’s R&D&I policy through its work.
What is your view of the Walloon Government’s recovery plan released in May 2021 and its impact on regional science policy?

The Recovery Plan (PRW) has many positive effects. By setting priorities, it emphasises the key areas for Wallonia’s development. In terms of R&D&I in particular, it has boosted financial resources and made it possible to support large-s cale projects for industry, academic institutions and research centres alike. These projects are intended to be cross-cutting (circular economy, industry of the future, etc.) and structuring (support for the Smart Specialisation Strategy).
Nevertheless, certain aspects need to be kept in mind, such as the large number of appeals and the short deadlines that put pressure on administrations and beneficiaries for appeals and implementation.
The Science Policy Pole hopes that the momentum created will not come to an abrupt halt at the end of the PRW.
Could you tell us about the science policy evaluation report which was published in December 2022?
The Science Policy Pole’s mission is also to evaluate Wallonia’s science policy. As part of this, it publishes a report that takes an in-depth look at the Walloon research and innovation system. The latest report, published in December 2022, identifies the strengths and weaknesses of this ecosystem on the basis of twenty indicators and puts forward eight recommendations:
- Actions to deal with the crisis;
- The need to focus on a long-term strategic vision;
- Reaffirmation of the importance of R&D&I for the redeployment of Wallonia;
- Urgent action to be taken to increase the number of students in STEM subjects;
- Encourage the involvement of research players in European programmes;
- Strengthening links with the administration;
- Support for maintaining the withholding tax exemption for researchers.
What other opinions do you plan to publish between the end of 2023 and the first half of 2024, at the request of the political authorities or on your own initiative?
Between now and the end of 2023, the Science Policy Pole will be preparing its memorandum for the next Walloon government, setting out its priorities for strengthening the regional R&D&I ecosystem. In the first half of 2024, it will focus more on initiative work. The Belgian Presidency of the Council of Europe is an opportunity to highlight the importance of the European level and the opportunities it offers for regional R&D&I activities. The second part of 2024 will be dedicated to analysing the programme of the future Walloon Government for the 2024-2029 legislature.
What do you see as the main challenges to be met in order to improve the Walloon government’s support for scientific research?
Support for R&D&I activities will have to be one of the priorities of the next Walloon Government. One of the challenges will be to continue the impetus given by the Recovery Plan to strengthen regional economic development, in particular through research activities and their exploitation.
For many years now, the Science Policy Pole has also been calling for the Walloon R&D&I system to be simplified and made easier to understand. The efforts already underway must be continued in order to offer the various players efficient and effective services to support them in all their activities.


An interview with Mrs Rose DETAILLE, Managing Director of ISSeP
Could you remind us of the ISSeP’s 4 main areas of activity? ISSeP’s 4 main activities are environment quality monitoring (i.e. water, air, soil, sediments and waste), risk and pollution prevention, the Walloon reference laboratory, and research and technological development. It draws on the scientific expertise of 300 agents in areas like field sampling, lab analysis, numerical modelling, geostatistical analysis, and Earth observation. Environmental monitoring activities cover the ambient air quality network, the control of emissions from 53 industrial facilities, the physicochemical, microbiological and ecotoxicological survey of surface and groundwater as well as sediments, and finally the monitoring of contaminated sites and landfill sites. Risk and pollution prevention studies involve, for instance, the forecasting and the assessment of accidental and chronic risks, the assessment of the impact on ecosystems and the assessment of human exposure through biomonitoring projects and geostatistical approaches, as well as the monitoring of changes in land use by Earth observation methods. Furthermore, we carried out 1,532 checks on stationary transmitting antennas in 2023 as part of the rollout of 5G. As you can see, our activities are very diverse!

tion to these reference instruments, ISSeP has also developed mini-stations for measuring particulate and gaseous pollution. These mini-stations, which are more compact and considerably less expensive, can be deployed in large numbers, both in natural environments, in the city, in the heart of a crossroads or in a narrow street. They provide air quality measurements that are of a lower metrological quality than those from reference stations, but are used to enhance air quality modelling in complement of reference measurement points.
How would you sum up your Intello research project?
Could you tell us about your new tools for assessing air quality?
Over the last few years, ISSeP has acquired instruments to improve its understanding of particulate pollution by measuring black carbon, which characterises soot, as well as ultrafine particles with diameters ranging from 10 to 800 nanometers. Other more specific instruments have also been acquired to equip a station located at Vielsalm in order to better characterise background pollution as part of international air quality programmes such as EMEP (https://www.emep.int) or ACTRIS (https://www.actris.eu). In addi-

The Intello project has enabled ISSeP to develop its skills by integrating artificial intelligence (AI) into its scientific activities. It has demonstrated the benefits of AI in monitoring the Walloon environment. Machine learning, deep learning and data fusion provide considerable assistance to ISSeP researchers in a wide range of areas. For Earth observation, tools have been produced to detect precise objects in very high-resolution satellite images. Land cover can also be extrapolated from the same aerial data, at any point in Wallonia, using specific deep learning techniques. With regard to air quality monitoring in Wallonia, pollution episodes can now be detected automatically and short-term projections of pollution levels can be made. AI also adds value to the estimation of traffic flows across an entire network through data propagation. In addition, AI has made it possible to merge and manage all the ISSeP data on the influence of the environment on people’s health at once, increasing our understanding of the links between them. The results of the Intello project were presented at scientific conferences, raising the ISSeP’s profile both nationally and internationally. A closing seminar for the project was held at ISSeP on 7 December (https://www. issep.be/intello/).


Can you give us other examples of equity-funded research projects?
ISSeP funds in-house research projects to develop its expertise in managing contaminations of emerging concern: microplastics, “forever chemicals” and antibiotic-resistant bacteria are the focus of new research projects. These projects also tackle specific areas of the circular economy, such as biogas or wastewater treatment plant (WWTP) sludge recycling.
A new project has just been launched to study antibiotic-resistant bacteria in WWTP sludge. The aim of the study is to assess their potential for dissemination when WWTP sludge is spread as a soil improver. With WALÔPLAST, ISSeP is developing an analytical method for the analysis of microplastics (MP) in water and sediments in order to assess the occurrence of these MP in Wallonia. The project will also study the contribution of rainwater to environmental contamination by MP. In the IMP-PFAS project, the use of PFAS data from previous projects (BIODIEN, PPB-WAL and ôDiSuPer) will make it possible to increase current knowledge on these contaminants. A battery of ecotoxicity tests will be deployed on samples from the water framework directive network. Cross-referencing PFAS measured data in surface water, groundwater and biota with observed ecotoxicity effects will enable to make the link between exposure and effects, and take better account of the possible synergistic effects of PFAS. The DOGCET project, which began in the summer of 2023, involves the unprecedented use of a working dog trained to detect gas leaks from landfill sites. This meets several objectives: ensuring safety around the sites, limiting greenhouse gas emissions from landfills and enabling the biogas to be recycled. Moreover, ISSeP is also carrying out projects related to climate change. The aim of the TIREX project is to provide Wallonia with a map of the health risks associated with hot and cold thermal hazards at every point in its territory, by exploring the potential of thermal satellite data. A network of micro-sensors will be specially developed to measure the variables needed to calculate the heat stress experienced by citizens.
What citizen participation projects does ISSeP contribute its expertise to?
ISSeP had 11 participatory science projects active in 2023, with a total of more than 1,800 citizens involved. In the general biomonitoring survey, citizens throughout Wallonia are recruited to give blood and urine samples which we will use to define reference values for comparison with those in neighbouring countries. The PFAS crisis has prompted us to hasten the inclusion

of PFAS analyses in our biomonitoring programme. A detailed questionnaire was sent to each participant to determine their lifestyle, dietary habits, etc. and to check whether there were any confounding factors. This is a cross-sectional epidemiological study, which should be repeated every 5 to 6 years to assess the impact of restrictive measures and policy actions on citizen’s exposure.
In addition, specific biomonitoring studies are carried out to investigate exposure near industrial facilities (such as shredders), in historically contaminated sites or during professional activities (e.g. pesticide spraying by farmers).
Furthermore, other citizen science projects are being carried out to study the impact of metal shredders on local residents including the analysis of house dust contaminants, of mobility planning on air quality, or of air traffic on people living near airports, using portable samplers placed on the citizen or at their place of residence.
How can ISSeP increase its role in assisting political decision-making?
In its administration contract (2020-2025), one of its strategic objectives is to support the Walloon Region in its ecological transition plan, using its expertise in waste management. In this context, several projects have been launched in links with transition to a circular, regenerative and zero waste economy (phytomanagement and biomass recovery, asbestos soils, invasive plants...). Furthermore, ISSeP aims to become a benchmark in the field of motor vehicle emissions testing thanks to its hybrid motor vehicle testing laboratory (in progress), a unique tool in Wallonia. Finally, ISSeP contributes to the study and adaptation to climate change through territorial monitoring, using Earth observation methods and data. More than ever a sentinel for the environment and an expert in risk management, the ISSeP is able to respond flexibly in times of crisis and provide concrete support for the Walloon Region’s threefold social, ecological and economic transition.

ISSeP
Liège Headquarters
Rue Chéra, 200 - 4000 Liège
Tel.: +32 (0)4 229 83 11
Email: direction@issep.be
http://www.issep.be



Wallonia boasts a strong innovation ecosystem, with high-performing universities and research centers, a long industrial tradition, and innovative companies across various cutting-edge sectors. Located at the heart of Europe, Wallonia benefits from proximity to advanced regions with large industrial basins, major urban centers, and internationally renowned technological development hubs.
Capitalizing on these strengths, Wallonia has adopted an International Policy Strategy and a Smart Specialization Strategy (2021-2027) to enhance its international visibility, benefiting its businesses and research and innovation stakeholders. The actions of the NCP Wallonia align with this internationalization dynamic, building strong relationships with various players in the Walloon ecosystem, such as SPW, Competitiveness Clusters, WE, AWEX, WBI, WalmeetEU, NCP FNRS, etc.
Recognized by the European Commission to provide high-quality professional services on European research and innovation funding, the NCP Wallonia consists of eight dedicated individuals serving the Walloon research ecosystem.
Funded by the Walloon Government and hosted within the Walloon Union of Enterprises since 2002, the NCP Wallonia aims to maximize the participation of Walloon actors in projects supported by European Research and Innovation (R&I) funding programmes. As a privileged contact for participation in European research and innovation projects, the NCP Wallonia informs, connects, and supports its “clients” by offering personalized assistance in project development and increasing the chances of obtaining funding from the European Commission, especially for Horizon Europe framework program calls.
As mentioned earlier, the NCP Wallonia team comprises eight experts with advanced knowledge not only in the technical and administrative aspects related to European calls but also in various scientific themes of European research programs: health, food, biotechnology, environment, climate, culture, creativity, inclusive societies, mobility, digital, defense, nuclear, security, space, and aerospace.
Informed about the latest policies and strategies pursued by the European Commission in these thematic areas, NCP Wallonia advisors support project development in the EU’s priorities, such as combating climate change, green digitalization, energy supply, intelligent mobility, cancer prevention, smart cities, soil and water decontamination, cybersecurity, food, circularity, etc. This includes guidance on breakthrough

technologies through the European Innovation Council (EIC), considered an essential pit stop for highly innovative startups and SMEs. Another crucial aspect of NCP Wallonia’s work is to simplify access to European projects, saving valuable time for potential candidates.
Whether you are an SME, startup, university, research center, or public entity with innovative ideas or projects, based in Wallonia, and looking for international networking and/or European funding for your R&I projects, do not hesitate to reach out to NCP Wallonia.
NCP Wallonia offers a range of services to help you succeed in your projects and maximize funding opportunities:
• Information and awareness about the Horizon Europe program and other related programs (LIFE, Digital Europe, European Defense Fund, Innovation Fund).
• Analysis of the idea and evaluation of EU funding corresponding to your project concept.
• Identification of the most suitable program for your European and international strategy.
• Identification and selection of the best European partners/consortia for your project.
• Targeted search for partners and experts through international networks (NCP and Enterprise Europe Network).
• Guidance on administrative, legal, and financial rules of the EU tender for a project.
• Assistance in drafting your project, both in form and substance.
• Critical review of your project, in whole or in part, with proposed avenues for improvement.
• Individual support during the preparation of the contract with the European Commission and consortium members, if the proposal is selected for funding.
• Addressing legal and financial questions during the project duration.
• Advice and assistance in technical and financial reports to be submitted to the European Commission.
It’s important to note that all services provided by NCP Wallonia are free, personalized, and conducted with utmost confidentiality. Visit our website at www.ncpwallonie.be and contact us today!

Statistically comparing the last two framework programs, H2020 and Horizon Europe (ongoing), the success rate of projects submitted by Walloons has significantly increased. It currently stands at 20%, whereas it was 13.8% in H2020. Moreover, the quality of projects submitted by Walloons continues to rise, with 59.2% of projects above the threshold demanded by the European Commission under Horizon Europe, compared to 53.2% under FP7 and 58.6% under H2020.
Projects submitted by Walloons in Horizon Europe are more “qualitative,” meaning they surpass the minimal threshold required by the European Commission more frequently. When considering the involvement of NCP Wallonia in the project process, this rate increases to nearly 70%, compared to 55% under H2020. In Horizon Europe, the rate further increases to 75% when analyzing projects submitted with a Walloon company and facilitated by NCP Wallonia, compared to 52% in the Horizon 2020 program.
Since the launch of Horizon Europe in 2021, NCP Wallonia has engaged with and raised awareness among more Walloon stakeholders than during the entire H2020 program. Approximately 1,000 stakeholders, including 600 companies, have interacted with NCP Wallonia, compared to 660 stakeholders, including 470 companies, over the entire H2020 period (2014-2020).
While the initial results of Horizon Europe are promising for Wallonia, efforts must be made in the coming years to ensure that Walloon participation reaches higher levels in European Commission call proposals and significantly increases funding capture rates from the framework program. NCP Wallonia is just one piece of the puzzle. Various initiatives by the Walloon Government during this legislative period, such as funding international references within Strategic Innovation Initiatives as part of the Smart Specialization Strategy of Wallonia (S3), massification project of accredited research centers focusing on innovative and circular materials with specific support for European integration, integration of a performance indicator related to project submission and evaluation above the Commission’s threshold in the criteria for accrediting research centers, and the revival of the grant for project submissions, should contribute to a significant increase in the number of projects submitted.
https://www.ncpwallonie.be/english/
Could you tell us about the research and innovation promotion actions carried out by AWEX and WBI?
Wallonia Export & Investment Agency (AWEX) and Wallonia-Brussels International (WBI) have developed a joint strategy for French-speaking Wallonia and Brussels innovation actors: universities, research centers, innovation clusters and companies. To do this, they rely on several networks active abroad, namely a network of academic and scientific counselors and a network of economic and commercial advisors as well as several strategic partnerships with foreign ecosystems, allowing technology and innovative companies to rapidly access markets with strong potential growth. Furthermore, WBI negotiates and activates bilateral research agreements in order to support international research and innovation projects as well as to promote the international mobility of researchers.

AWEX and WBI carry out various promotional and support activities. For example, each year the two administrations have a joint stand at the Hannover Messe, the world’s largest industrial technology fair. This major event allows us to present the entire innovation value chain with university spin-offs, start-ups, applied research centers, etc. The international visibility of our skills is thus reinforced, as are the opportunities for international collaboration. In addition, AWEX and WBI participate in various economic missions, technological missions, state visits, etc. Since 2016, we have also been collaborating with the Belgian online media Daily Science: our science articles promote the scientific know-how of our ecosystem. Since 2021 and the renewal of the Wallonia Smart Specialization Strategy, we have also been supporting a range of strategic innovation initiatives led by our research and innovation stakeholders. A great example is the organization of an annual summer school by the TRAIL institute through our international networks. This event took place in Berlin in 2022 and in Nantes in 2023, allowing us to connect with other AI excellence ecosystems and position ourselves in European projects.
How do you support the export activity of innovative Walloon companies? We accompany them through technological missions that meet their needs in terms of commercial accessibility to major international markets. These needs include on-site technological validation (with connection points for this validation), connection with local accelerators, acquisition of industrial property, and preparation of fundraising, access to local innovation or demonstrators.
We rely on strong innovation ecosystems with trusted partners for companies to grow and develop their innovations. With this in mind, AWEX’s annual action program, which includes 150 to 180 actions depending on the year, will increasingly specialize in these international technological missions, beyond the promotion of “pure” exports.
How does the One Stop Shop service help foreign companies wishing to set up research activities in Wallonia?
We capitalize on a legislative and fiscal environment that is favorable to such establishments, both at federal and regional level: this is demonstrated by the numerous incentives and tax deductions.
But that is not all: the attractiveness of our ecosystem based on a strategy of smart specialization is just as important. Innovation clusters, companies and universities offer an interesting network of academic, industrial and financial partners. In addition, we have concluded soft landing agreements with WSL, located in Wallonia and considered to be the 6th largest technological incubator in the world. WSL does a fantastic job of welcoming and supporting innovative start-ups. Finally, AWEX has set up dedicated teams to monitor projects: a sectoral team and a team within the Innovation Department to stimulate exports and attract foreign investment.
How do you support the revival of Walloon companies active in the research and innovation sector?
The health crisis has highlighted the creativity and innovation of our ecosystem. All the technological sectors were mobilized to provide rapid responses to various issues: the production of personal protective equipment and parts for respirators, the transformation of production lines, collaboration with research centers, etc. It is this dynamism and reactivity that we want to encourage by informing all R&D operators of international missions, European programs through Horizon Europe, etc. We also make sure to identify local partners abroad in order to create connections for future research partnerships. This dynamic is already well underway with Brazil and Quebec. Finally, we are keen to make companies aware of the importance of sustainable transition: it is crucial that they integrate this parameter into their DNA if they want to succeed in relaunching their activity and convince others of their commitment to social responsibility.
Agoria is the Belgian Federation for Technology industry. Its mission is to support the development of technology companies and improve their socio-economic impacts at the regional, federal and European levels.
Telecoms, mechanics and mechatronics, ICT, industrial automation, electrical engineering, metal products, construction products, metals and materials, contracting and maintenance, plastics and composites, automotive, security and defense, aeronautics and aerospace, assembly and cranes. It is to these high-tech industries that Agoria devotes its energy. In this sector, Agoria represents the interest of 510 companies that employ almost 35.000 people in Wallonia and have a combined turnover of 13,7 billion Euros, two thirds of which are exported.
From day one Agoria has supported the setting up of a strong industrial policy in Wallonia. In this context, Agoria is supporting the competitiveness cluster MecaTech which is focused on mechanical engineering, but also different technological clusters such as Infopôle Cluster TIC (ICT), Twist (technologies of image, sound and text) and Tweed Cluster (energy-environment).
Digitalisation is, at the same time, a major challenge but also a great opportunity for our society and our industry. The health crisis of 2020-2021 has also reinforced our belief that technology, and particularly digital technology, is the source of many solutions to improve our way of life. Through its study “Shaping the future of work”, Agoria has analysed the impact of digitalisation on the job market in Belgium and proposes concrete actions to shape the response to these major challenges. Digitalisation will impact the content of almost all jobs, and skills will need to be updated to ensure job sustainability (https://bethechange.agoria.be/en/). In Wallonia, this will concern 1,200,000 professionals.
Another issue of concern to Agoria in Wallonia involves preparing manufacturing industry for the future and enabling it to be firmly rooted in Belgium in the long term. This is the objective of the transformation processes initiated as part of the Made Different methodology. The aim is to transform our companies into Factories of The Future. This Made Different process starts with a scan of seven areas of transformation, focusing on making companies aware of their current status so that they can see where they stand with respect to other companies. The transformation phase can then begin.
Around 800 companies from all over Belgium have embarked on this phase up to now. These companies include, in addition to Agoria members, an increasing number of businesses from the food, textile, biotech and timber sectors. The programme’s success has not gone unnoticed at European level either. At the time of writing these lines, the programme

has been deployed as a pilot project in eight European countries in addition to Belgium (France, the Netherlands, Germany, Denmark, Italy, Spain, Poland and Slovenia).
By assisting industry in addressing the challenges of human capital and digitalisation, Agoria is a crucial component in underpinning the sustainability of our industry and its development.

How important is research and innovation for Wallonia?
Wallonia’s economic dynamism in 2023 will rely heavily on research and innovation. These two pillars are more than essential to guarantee sustained growth and a prosperous, sustainable future. However, such an ambition requires the mobilisation and alignment of many players, diverse resources and, above all, close collaboration between the private sector and academic institutions. Wallonia is one of Europe’s champions of business innovation. It is therefore essential that the tax incentive framework (such as the exemption from withholding tax for researchers, but also deductions for patents) is maintained. The Union Wallonne des Entreprises is fully committed to meeting these challenges. I have therefore made innovation a priority theme for the UWE during my term of office.
What are Wallonia’s key R&D figures?
Wallonia exceeded the European target of 3% R&D spending in 2019. This figure had even risen to 3.5% by 2021. This is an important milestone, but there are major issues behind these figures. On the one hand, the vast majority of resources come from companies. The public sector is not meeting its 1% target. On the other hand, private funding comes mainly from a few large companies. Greater diversity would be desirable.
What resources does UWE have at its disposal to support innovative Walloon companies?
UWE hosts and manages Wallonia’s National Contact Point, which helps companies, universities and other stakeholders to take part in European research projects, particularly as part of the Horizon Europe programme. I can only express my disappointment at the lack of requests for this expertise from companies in the region. So I’d like to send them a simple and direct message: Come and see for yourself!
In addition, the UWE teams work on a daily basis with the administration, the Walloon Government and the stakeholders in the ecosystem to strengthen the excellence of the region’s research ecosystems.
What do you see as the short-term priorities for research in Wallonia? There are many areas of work to be done, but I believe it is essential to strengthen collaboration between the private sector and academia. Of course, my career at IBA (a spin-off from UCLouvain) underpins this conviction, but there are many factors that reinforce it.
Belgium’s French-speaking universities are breeding grounds for talent, knowledge and cutting-edge technologies. Walloon Business Association have everything to gain by joining forces


with these institutions to create effective synergies. University R&D can help speed up the introduction of innovative technologies within companies. This collaboration is also an excellent way for companies to gain access to young talent who will drive future innovation.
And UWE must be able to fully play its role as a link in this dynamic. Because innovation isn’t just about R&D in the bedroom. It has to be justified by market needs. And conversely, far too many good inventions lie dormant in university drawers - let’s make the most of them!
In this context, it is vital to recognise that R&D should not be the privilege of large companies. And I base this observation on my own experience at IBA which, since its creation, has devoted more than 10% of its turnover to R&D. And it pays off! So we urgently need to put SMEs back at the heart of the research dynamic in Wallonia.
Is Belgian taxation a crucial factor in the performance of its research?
Wallonia, and more broadly Belgium, is one of Europe’s champions of business innovation, as the European Commission’s Regional Innovation Scoreboard shows year after year. And this despite a very restrictive general tax environment. So allow me to insist, because it’s essential: it’s vital to preserve the tax
measures that support research and innovation, such as the exemption from withholding tax for researchers, but also the deductions for patents. These allow companies active in R&D to achieve an attractive competitive balance, allocate substantial resources to R&D and enable our country to remain attractive to technology start-ups and foreign investors. Let’s not shoot ourselves in the foot!
For companies, the road to innovation is strewn with pitfalls. The often high cost of research, the risks associated with new ventures and regulatory complexities are all challenges to be overcome. But these obstacles are not insurmountable.
On the other hand, innovation depends fundamentally on the quality of university education. In other words, the quality of the workforce trained by the universities. In Wallonia, the level is good. We need to maintain it, and even improve it.
At the end of the day, Walloon Business Association, especially SMEs, have everything to gain from investing in research and innovation. Establishing solid partnerships with Belgian universities and a supportive tax environment are effective levers for achieving this. It’s worth remembering that investing in innovation today means building the prosperous and sustainable Wallonia of tomorrow.

What are Wallonie Entreprendre’ missions?
Wallonie Entreprendre (WE) is the economic and financial tool of Wallonia at the service of companies.
WE aims to provide the necessary means for the development of activity in all sectors. Their investments and financing respond to a logic of creation, growth, transmission or revival of companies. WE’s teams ensure that social and environmental standards are respected while advocating sustainability and circularity of economic approaches.
This offer includes on the one hand financial products such as guarantees and co-financing in partnership with banks, but also direct financing from equity to subordinated or convertible loans. This offer also includes information, awareness and support services through a network of field operators.
How does Wallonie Entreprendre support innovation?

Whether it is incremental or disruptive, technological or not, product, process or marketing, innovation is a risky process, full of obstacles and a source of uncertainty for the company. Specific support is therefore recommended and various operators, coordinated by WE, offer tailor-made services aimed at challenging the company’s business model, market positioning, technical approach and intellectual property strategy.
WE’s Innovation Team relies on a team with complementary expertise and technical skills (materials, agri-food, health, digital, intellectual property, etc.). This team also works in close partnership with a network of operators, the European Business and Innovation Centres (CEEI) and the economic development units of the Territorial Development Agencies (ADT) to analyse the technological aspect of innovation projects and their feasibility. Two other important partners of this

team are LiEU and SynHERA, the networks of knowledge transfer services of the universities and the UAS (Universities of Applied Sciences) of the Wallonia-Brussels Federation.
Wallonie Entreprendre is now organized into Business Units, each of which offers financing solutions tailored to each sector (loans, guarantees, equity participation), particularly for strong ecosystems such as Life Sciences, deeptechs or the energy and circular transition. Where appropriate, these fundraisings can be coordinated with one or more of Wallonia’s 9 local invests, with the aim of achieving a wider impact.
In the same way, Wallonie Entreprendre also contributes to the international development of Walloon companies by financing their needs abroad, whether in terms of investments or acquisitions. In this respect, the EUROQUITY platform also offers companies in the process of raising funds the opportunity to make themselves known to potential investors.
How can EEN (Enterprise Europe Network1) help Walloon SMEs?
Set up and financed by the European Commission, EEN has more than 600 organisations and is active in more than 60 countries, including all the countries of the European Union. The network offers free information, support and coaching services to help SMEs access new markets abroad, innovate or find financing.
EEN Wallonia2, jointly supported by Wallonie Entreprendre, AWEX and NCP Wallonia (UWE), does its utmost to support internationalisation and innovation projects, with a focus on sustainability, digitalisation and resilience.
How can Wallonie Entreprendre help companies in the field of intellectual property?
Through its helpdesk, WE helps SMEs and project leaders to understand the challenges of intellectual property (IP) for their business and provides support solutions via personalised meetings or online tools (self-diagnosis, training modules, guides, etc.).
Last year, WE has developed, in collaboration with 4 Belgian and Dutch public organisations3, the “Create, protect and benefit” platform4 to give more visibility and “easy” support about IP to entrepreneurs. Finally, it refers to an expert, including WE, which, in this case, advises companies on the development of an IP strategy and its action plan and directs them to private and/or public agents for specific needs.
1 https://een.ec.europa.eu/
2 https://www.wallonieeurope.be
3 FPS Economy, VLAIO, Wallonie Entreprendre, the Benelux Office for Intellectual Property and the Octrooicentrum Nederland.
4 https://www.create-protect-benefit.com/be-en

What are the key figures for the biotech and medtech sectors in Wallonia? Belgium, and more specifically Wallonia has a rich and significant history in the field of life sciences, dating back centuries. The presence of industry leaders like UCB, GSK, Takeda and IBA has further solidified the country’s position in the life sciences sector. Belgium is one of the most advanced hubs of excellence for biotech, biopharma and medtech today.
Compared to our neighboring countries, Belgium is by far the country with the highest per capita investment in biopharmaceutical R&D in Europe. While Belgium only represents 2.6% of the EU population, the biopharmaceutical industry accounts for 7.8 % of jobs, 18.7 % of exports and 19.3 % of research and development expenditures within the EU. This puts Belgium in third, second and first place respectively in Europe1
Employment has recorded a continuous annual growth of 4.5% for 17 years. It has, therefore, nearly doubled, increasing from 11,325 FTEs to 19,977. A closer look at SMEs reveals that while employment growth remained relatively flat until 2015, it has surged since then. If we focus only on large companies operating in Wallonia (GSK, UCB, Univercells, etc.), there is an 86% increase in employment between 2005 and 2021.
Could you tell us about the BioWin’s strategy?
BioWin’s role is to accelerate innovation to address the public health challenges of the future and to develop knowledge, employment and the competitiveness of everyone involved in the health sector ecosystem in Wallonia. The mission of BioWin is to make Wallonia a region that is internationally known for its
world-class academic, clinical and industrial research environment in the cluster’s technological domains.
BioWin will continue to follow its strategy that was deployed at the outset: supporting the emergence and development of R&D projects; developing talents; integrating companies in international markets; forming and nurturing networks and supporting the growth of companies.
BioWin is focusing on internationalisation and interdisciplinarity in order to achieve its goals for the next 4 years. BioWin will offer its members new opportunities for R&D collaboration with the best ecosystems in the world, near or far and will provide help to set up European projects.
To add to the value chains and nurture the health sector ecosystem, BioWin in close collaboration with AWEX will reinforce its efforts to attract foreign investors. And as part of the smart specialization goal in Europe, BioWin will be prioritising those areas of activity and technology in which Wallonia has a competitive edge. Our strategy is to build on the excellence in our 4 strategic domains: (bio)pharmacy (including cell therapy and biomanufacturing), radiation applied to health, medical devices and in vitro diagnostics, and digital health.
What services does BioWin offer its members?
BioWin brings together 90% of the health- biotechnology- and medical technology players in Wallonia. The cluster therefore has a clear view of the technology value chains and an in-depth knowledge of the stakeholders in the region. This allows BioWin to offer its members the most appropriate services in terms of R&D, internationalisation, skills development and support for company growth.
From early development in R&D to commercialization, BioWin provides support for projects arising from regional and international calls, and one-off assistance to SMEs and start-ups to support their economic development.
At the international level, BioWin works with the world’s most innovative regions to help its members identify the best partners for business and research collaborations. BioWin’s main focus is on networks and partnerships, forging links with key clusters and science parks.
Together with AWEX, BioWin helps Walloon companies increase their international activities by facilitating their visibility at key events in Europe, North America, South-East Asia and China. Together with other clusters in Europe, BioWin helps companies identify relevant gateways to enter key markets.
1 cf. report published by Pharma.be chrome-extension://efaidnbmnnnibpcajpcglclefindmkaj/https://pharma.be/sites/default/files/2023-11/pharma_figures_eu_en.pdf

BioWin works to develop human capital, with a strategic focus on promoting innovation and growth in companies by
(a) contributing to the forward management of skills and talents, (b) encouraging uniformity in the region’s training initiatives, (c) expanding and enriching the pool of regional skills and talents, (d) helping to create bridges between university courses and industry.
BioWin supports company growth by facilitating SME access to private sources of funding and by creating a favourable environment to attract and identify the best talent and expertise.
Could you give us a few examples of R&D projects that have secured funding via BioWin?
BioWin owns a portfolio of 67 R&I projects for a total budget of €35,9 million, including €25,1M in subsidies. Four new projects in the cluster’s strategic areas have been added to the portfolio last year.
Vetphage: the development of phage-based products for the treatment of bovine mastitis, currently targeting two of its major pathogens, S. aureus and E. coli.
Softmed: brings together 4 partners – Transurb, Quimesis, ULiège and Henallux - with the objective to develop an innovative tool for training non-technical skills for nursing and technical staff.
SoftMed focuses on both initial and continuous training. It will utilize virtual reality, be multiplayer, editable, and will incorporate the learner’s stress level as well as assessment grids.
The NEMO project, initiated with BioWin’s support, focuses on advancing the digitalisation of bioprocesses in the Walloon region. Launched in response to BioWin’s Call 34 (2021), with support from the Digital Agency, the project involves collaboration between UCB and DNALytics. The project aims to create a digital twin of the entire pharmaceutical manufacturing process, optimizing it based on historical production data.
Sputumai: this project, in collaboration with the Mecatech Cluster aims to developing a new diagnostic tool for severe forms of asthma using artificial intelligence.
Since the creation of the Cluster and following the call for projects mechanism, 83 products have been developed and 39 services.
What partnerships have you developed in Europe and abroad?
The international strategy consists of consolidating the Cluster’s Strategic Activity Areas in selected territories where the Cluster has identified opportunities (research and economic growth) for its members:
• Europe
• North America
• In Asia: China, South Korea, and Japan.

The international strategy is based on 4 pillars:
• Ensure the international visibility of Wallonia, the Cluster and its members.
• Activate networking and linkages between players in the best biotech and pharma hubs in the world.
• Promote the internationalization and development of members (especially SMEs) through strategic research and/or technology partnerships and exposure to specialized investors.
• Support AWEX in its mission to attract foreign investors and to collaborate with the Business Parks.
Over recent years, BioWin has developed several collaborations and concrete matchmaking activities with several European clusters (Medicen Paris Region, Lyonbiopole, Bio-M, Biocat, BioPmed, Life Science Nord, Atlanpole Biotherapies, etc.). More recently this year BioWin signed a partnershjp agreement with Polepharma to strengthen collaboration in the biopharmaceutical sector. In parallel, BioWin is member of the Council of European Bioregions (CEBR), a network uniting 38 European health clusters. This facilitates discussions with the European Commission, fostering closer ties with key administrations such as DG Grow, DG Health, and DG Connect.
What are BioWin’s objectives for the next three years?
We are driving the development of three major sectors. The first, our ‘historic sector,’ which has been evolving for over 60 years in Wallonia, is the biopharmaceutical sector, encompassing vaccines, biomedicines, and advanced therapy medicinal products (ATMPs), including gene, cellular, and tissue therapies. We have a strong focus on the latter, with many initiatives in preparation that will be launched in the next three years. Among them is a significant call for expressions of interest addressed to the ATMP sector stakeholders to strengthen it from a technological and industrial perspective. This collaborative innovation partnership with 26 partners along the entire ATMP value chain has been officially launched in January 2024. We also aim to develop a portfolio of specific training programs. Our initiative to accelerate the digitalization of bioprocesses, BioMan, which is already underway, has been renewed.
Simultaneously, we seek to consolidate the emerging and less structured medtech sector in Wallonia. This sector faces numerous challenges, particularly with respect to the European directive on
medical devices, which significantly hampers its growth. However, we are beginning to reach a critical mass in the field of radiopharmaceutical products and the development of associated equipment. Lastly, we are promoting the e-health sector, focusing on digital solutions and AI applied to health data. We are collaborating with our Flemish counterparts to raise concerns with federal authorities on a range of issues, especially the secondary use of health data for research purposes, and to align ourselves with the European health data space. We have also prepared a document that we submitted to the Minister of Health at the end of last year.
What do you think are the great challenges to come for the Walloon biotech and medtech sectors?
I see three. The first challenge is undoubtedly to guarantee the training of qualified talents for our companies. BioWin must anticipate the needs of its members. It must also be proactive with the government so that strategies can be put in place to secure a sufficient supply of skilled labour. In early May 2022, BioWin spearheaded `Talent Now’, a unique initiative to tackle recruitment shortages and challenges in the healthtech & biopharma industry. With the support of Walloon government and private companies (GSK, UCB, Univercells, ThermoFisher, Takeda and Janssen. The second challenge is essential and a crucial issue in Europe, and is to support and fund high-quality early development and fundamental research, because that is from where future therapeutic applications will come. The third challenge, for Wallonia and the European Union, is to create a context that favours the growth of SMEs. Wallonia’s SMEs currently employ an average of 30 to 50 people; this total could rise to between 200 and 400 employees if the government were to introduce the right tax incentives and financial instruments.
Key figures for the BioWin cluster (2022)
- 13 world leaders (GSK, UCB, Catalent, Alten, Cenexi, IBA, Johnson & Johnson, Eurogentec, Takeda, Polypeptide, ThermoFisher, Univercells, Roche) and 177 SMEs;
- 5 universities;
- 5 private research centers with 400 research units, 11,000 researchers and 3 university hospitals;
- € 449.7 of R&D expenditures per capita in biopharma in 2021;
- € 5.2 B investments in R&D in 2021
- 132.411 direct, indirect & induced jobs in 2021.

A clinical-stage biotech company founded in 2018, EPICS Therapeutics is led by an experienced team with a proven track record and deep expertise in drug development. It stands out for the development of a novel class of RNA-based therapeutics: a promising pipeline of small molecule mRNA modulators addressing critical areas of unmet medical need in oncology.


Cancer cells show extensive alterations in protein expression levels, which are drivers of their malignant transformation. It is on the basis of this knowledge that EPICS Therapeutics has defined its approach: focus on epigenetic RNA modifications which control protein expression in malignant transformation processes. In that respect, the company’s products target the enzymes responsible for epigenetic mRNA modifications in cancer development and progression.
The challenge was to find the best RNA epigenetic target. EPICS Therapeutics and others have discovered it: METTL3 (methyltransferase), the key enzyme responsible for m6A transfer, the most abundant mRNA modification which has been linked to tumor growth, invasion, and metastasis. Indeed, m6A modification is overexpressed in many liquid and solid tumors and high expression predicts for poor survival. As a result, m6A is a downstream marker of METTL3 activity and decreased m6A correlates to decreased tumor growth. Eventually, the knockdown of METTL3 slows down tumor growth. In other words, METTL3 appears to be a general mechanism that acts regardless of the type of tumor or the type of mutation. It is therefore ideally suited to serving as the basis for a completely new therapeutic approach to inhibiting or controlling the development of various cancers.
Thanks to this discovery, EPICS Therapeutics have developed a best-in-class METTL3 inhibitor alongside with a strong product pipeline of mRNA modulators in epitranscriptomics (EP102 with METTL3 as target for AML and solid tumors, and 5 more products in oncology at an earlier stage of development.
EPICS Therapeutics’ METTL3 inhibitors have already proved highly effective in many different animal models which showed inhibition of tumor cell and reduction in tumor size. By the end of 2024 EPICS Therapeutics should start a phase 1b/2 clinical

trial in order to define dose, safety, pharmacokinetics, and initial efficacy in AML/MDS and several different solid tumor patients.
In that prospect, EPICS Therapeutics is raising €30 M to accelerate their RNA-based therapeutics to market and expand their pipeline. A good opportunity for investors to join the transformation of cancer care with RNA-based therapeutics.


47 rue Adrienne Bolland - B-6041 Gosselies
Tel. : +32 (0)71 348 500
Email: info@epicstherapeutics.com
https://www.epicstherapeutics.com


With 1800 scientists in Belgium and a total of 9.000 employees, 20 candidate vaccines in the pipeline and >1 billion € of R&D expenditure in 2023, GSK is the largest pharma company in Belgium. GSK’s Wavre site is also the largest vaccines manufacturing center in the world with a total of 550,000m2, which is more than 70 football (soccer) fields combined. This key player relies upon global vaccine R&D centers in Europe (Rixensart in Belgium and Siena in Italy) and in the United States (Boston and Rockville). An interview with Phd Jamila Louahed, Vice President, Head of Therapeutic Vaccines R&D and the Rixensart R&D center at GSK.
What are your R&D priorities?
Our R&D focus is to deliver new vaccines and medicines, using the science of the immune system, human genetics and advanced technologies. Our vaccines innovation strategy focuses on 3 priorities.
First, we apply our platform technologies to focus on developing new vaccines with high impact. Having an industry-leading broad portfolio of platform technologies, including recombinant protein subunits, mRNA, adjuvants, live attenuated viruses, toxoids, generalized modules for membrane antigens (GMMA), multiple antigen presentation systems (MAPS), and structural antigen design, is at the heart of our strategy to deliver against this ambition. We apply these technologies - sometimes in combinationbased on scientific insights on pathogens and diseases to create tailored solutions.
Second, we want to broaden the impact of our existing vaccines to protect more people through lifecycle management based on our leadership in the meningitis, shingles or RSV franchises (e.g., label expansion, new formulation, development of “next generation assets”).
 Mrs Jamila Louahed, VP Head of Therapeutic Vaccines R&D and the Rixensart R&D center at GSK
Mrs Jamila Louahed, VP Head of Therapeutic Vaccines R&D and the Rixensart R&D center at GSK
Finally, we connect experts across a wide range of science and technology areas to push the boundaries of innovation. To deliver new and improved vaccines, we leverage our expertise across a wide range of disciplines (e.g., immunology, virology, bacteriology, structural biology, vaccinology) and breakthroughs in life sciences, artificial intelligence, machine learning, and data analysis.
We are fortunate to access huge capabilities and resources within the global GSK R&D organization (encompassing vaccines and medicines), and we complement it with external collaborations and acquisitions that help us deliver the vaccines of tomorrow. We currently have more than 150 external scientific
collaborations globally (20 with Belgian academia and research centers), and our 2022 acquisition of the Boston-based biotechnology company Affinivax is a good example of this approach.
Could you tell us about the vaccine candidates in development?
We have promising vaccine candidates in various stages of development for diseases with high unmet medical need. Our vaccine candidates for bacterial infections could help reduce the use of antibiotics and have potential to play an important role in the global response to anti-microbial resistance (AMR), which is a growing public health problem and contributes to approximately 700,000 deaths annually around the world.
Additionally, we have several vaccine candidates for viral infections with high disease burden.
Could you tell us about your research in the field of therapeutic vaccines?
Science has evolved in a much deeper understanding on correlates of immune control for some health conditions. In parallel, there has been significant acceleration in the development and understanding of platform technologies, such as mRNA or viral vectors, due in part to the COVID-19 pandemic. This progress is enabling us to explore how the science and technologies of vaccines – traditionally used for prevention of diseases – can be applied to have a therapeutic effect on an infectious disease. We are investigating whether generating a targeted immune response against an infectious pathogen – used alone or in combination with small molecules – can help suppress or stop disease progression for specific diseases.
What is the contribution of digitalisation, artificial intelligence and machine learning to the design of vaccine antigens?
Advances in artificial intelligence (AI) and machine learning are playing a significant role in accelerating or simplifying

vaccine development. As an example, we have partnered with other companies to pilot a Digital Twin, a complete and real-time simulation of the entire vaccine manufacturing process of one of our adjuvant’s components. The benefits of this tech nology are numerous, including speed (it can run simulations in hours instead of having to build a test plant), sustainability (it reduces the amount of materials and energy required for real experimentation activities), safety (assurance of quality and yield predictions improve the reliability of supply), manufacturing agility (automation makes process robust and transfer between sites simpler), and education (off-line version of the Digital Twin can be used as a simulator for training). The potential is huge: GSK next plans to expand and replicate this model for the production of all future new vaccines and in some of its discovery activities. Ultimately, the goal is to deliver more vaccines

and medicines faster to people who need them. What do you see as the main challenges and opportunities in vaccine research?
There are still many diseases and conditions for which we do not have vaccines and where the scientific challenge remains. However, the acceleration of scientific discoveries and applications of new technologies present many opportunities to make progress and deliver for patients.
For example, the lead times and investments required to develop new vaccines is challenging. By applying innovative approaches to help validate our targets at an early stage, we can focus on developing our most promising assets and mitigate risks.
Another challenge in vaccines R&D involves the use of biological components which can be quite complex to produce at large scale. We have developed strategic collaborations to help optimize our production processes, like the Digital Twin pilot or our collaboration with a leading nanotechnology research center in Flanders, to leverage nanoelectronics to automate and improve control processes in biomanufacturing of our vaccines, including those in development phase. This collaboration contributes to consolidate Belgium’s strategic role in vaccine R&D and make Belgium the Health and Biotech valley of tomorrow.

GSK
Avenue Fleming 20, 1300 Wavre
Contact us at elisabeth.e.vandamme@gsk.com (external communication GSK in Belgium) or for scientific partnering at vaccinespartnering@gsk.com. https://be.gsk.com © GSK


Founded in 2015 as a spin-off from Realco SA, a manufacturer of enzymatic detergents for the food industry, OneLife targets the hospital sector, where bacterial strains are much more pathogenic. Now a scale-up with 13 employees, it is making a difference with its innovative biofilm detection and dissolution technologies.
With an annual growth rate of 45% and active in nearly 25 countries, including 16 in Europe, OneLife develops enzymatic detergents with a unique formulation. Its secret? Stabilizing the enzymes at a very high concentration level to guarantee their superior effectiveness against biofilm, the main cause of hospital-acquired infections, which jeopardise patient safety and entail major costs for the healthcare sector.
Detect. Dissolve. Prevent. This is the threefold ambition of OneLife’s technology, which uses a dye to attach itself to a protein or other form of residue and check that cleaning has been carried out correctly. In the range, enziQure® is a highly concentrated compound of 7 enzymes that clears 90% of instruments. Similarly, enziMed® Prevent Max was launched at the end of 2022 to ensure the cleaning of instruments and enziMed® PreCleaner is popular for cleaning medical instruments after surgery: designed in the form of a foam, it prevents the appearance of biofilm and dissolves or ganic residues. The latest addition to the range, launched in the beginning of June 2023, meets a crucial need for decontamination of sink drains in hospitals. Called enziSurf ®, it dissolves biofilms of multi-resistant bacteria to prevent them spreading to other pipes and to reduce the risk of contamination of immunodepressive patients. A precaution that’s all the more necessary when you consider that mini-droplets can be spread 1.5 m apart.
 Koen Billet, CEO, OneLife
Koen Billet, CEO, OneLife
Hypoallergenic and pH-neutral, OneLife products have two main categories of application. The first category covers veterinary medicine, dentistry and the hospital sector. As previously stated, enzymatic detergents are very useful for cleaning medical instruments such as endoscopes, as they dissolve biofilm and all organic residues in hollow instruments, thus avoiding maintenance costs. Indeed, these detergents cut 3 million molecular chains per second. Cleaning is the essential prerequisite for the second stage in the decontamination process, namely high-level disinfection. Two complementary processes that reduce microbiological contamination to acceptable levels. The second category of applications concerns critical surfaces, again found in the intensive care sector. In addition, fundamental research is underway to extend the applications of enzymes in the human body: results on infected implants are encouraging and should generate marketable solutions within 7 to 8 years.
In June 2023, OneLife carried out a capital increase to accelerate the commercialization of its products and double its workforce by the end of 2025. At the same time, the company wants to continue innovating for the benefit of endoscopy and hospitals, in search of products that are effective, easy to use safely and affordable. Another OneLife priority is to focus more on green chemistry for the benefit of the environment, patients and hospitals. Its detergents are already 97% biodegradable within a few days. There’s no doubt about it: OneLife is on the right track!



OneLife SA
Avenue Albert Einstein 15
B-1348 Louvain-la-Neuve
Tel. : +32 (0)10 48 34 27
Email : info@onelife-bf.com
https://www.onelife-biofilmfree.com/
Cosmetics, medical devices, biocides: CODIBELoffers a unique solution for health and beauty products in a state-of-the-art facility located in the heart of Europe. In-house expertise combined with the ability to adapt to new regulations and trends to reliably create value, maximise consumer well-being and minimise impact on the planet.
Founded in 1964, CODIBEL has extensive experience in the development and production of cosmetic and oral hygiene products - experience validated by ISO 22716 and ISO 13485 certifications. Its portfolio includes emulsions, gels, pastes and surfactant-based products for hair care, skin care and oral hygiene.
Regulatory aspects are becoming increasingly important in both the cosmetics and medical device sectors, with the latter undergoing a transition from the European directive (MDD) to the new regulations (MDR). These new regulations represent a significant tightening of the conditions for marketing medical devices, including CODIBEL’s bioXtra (www.bioxtra.info) range of products designed to relieve the symptoms of dry mouth.
CODIBEL is resolutely proactive when it comes to regulations, and its R&D department is constantly working to develop new cosmetic product concepts, in collaboration with consultants and external technical and scientific centres. The aim is to integrate future environmental constraints, in particular by better controlling the use of water at two levels: production and the formulation of the final cosmetic product. For example, CODIBEL has developed solid as well as powder-based hair care products. Quality policy is also at the heart of CODIBEL’s business. Its quality management system has been awarded two ISO
certifications: 22716 for cosmetic good manufacturing practice and 13485 for the production of medical devices.
Another priority for CODIBEL is to increase the sustainability of its activities. The sustainability plan put in place several years ago should enable the company to achieve carbon neutrality by 2030.
Today, CODIBEL wants to continue to innovate in the health and beauty products sector. To achieve this, the company intends to meet the two challenges it has identified. Regulatory and environmental challenges. Efforts to achieve compliance at these two levels consume a large proportion of the company’s energy and financial resources, which are no longer available to ensure the continued growth of its industrial activity. After administrative, financial and social obligations, the addition of regulatory and environmental obligations does not put European companies in general, and SMEs in particular, in a favourable position to face international competition. If corporate life were to be compared to a horse race, it could be said that European horses have to compete at a serious handicap! It’s up to CODIBEL to turn this problem into a solution, thanks to its ability to design and develop a product right through to the finished product, where science and nature go hand in hand. And it does this through creative and sustainable partnerships.



Tel.:
Founded in 1956, this family business (and 7th OTC laboratory) is renowned for its range of herbal remedies, which are freely available in pharmacies. With a turnover of 58 million euros, 280 employees , 2 production sites in Belgium and 2 Subsidiaries (France and Portugal), Tilman has more than 110 references in its catalogue. Its credo: quality and innovation to improve the lives of others.
Medicinal plants contain multiple active ingredients. However, these must be effective, sufficient in number and concentration, and have constant composition, to be integrated into galenic forms. This can be assured by using plant extracts standardised in active ingredients and by conducting pharmacological and clinical trials to prove the efficacy and safety of the finished product, like the impressive number of 22 trials conducted with Tilman products. Tilman laboratory complies with the same production standards (GMP: Good Manufacturing Practice) and quality requirements as the whole pharmaceutical industry. Tilman, develops and produces plant-based food supplements and herbal medicines, both according to the same highest quality standards and the desire for excellence.

Tilman goes far beyond classical phytotherapy: several innovative Tilman products are unique formulations with own patents. Tilman began its research 14 years ago in osteoarthritis (inflammation, cartilage degradation) to improve the quality of life of patients, slow down the evolution of the pathology and avoid a too early need for arthroplasty (joint replacement surgery). The laboratory is also active in the cardiovascular field through a research chair at the University of Antwerp which studies in hypertension and hyperlipidaemia. Other therapeutic areas of interest for Tilman are stress, anxiety and sleep disorders as well as the study of intestinal flora (in collaboration with the Catholic University of Louvain-la-Neuve) and immunology (several studies are ongoing to define the most active plants in combination with standard treatment for fighting viruses).
Tilman has made a name for itself with flagship products such as Flexofytol (based on curcumin and now available in combination with boswellia, sold in 30 countries) and Flexicream for joint pain, Sedistress and Sedistress Sleep (available in ten European countries with status of medicine), Cholesfytol for hyperlipidaemia and Tensiofytol for high blood pressure, and Nasafytol (based on quercetin and curcumin) for regulating the immune system. Nasafytol has already resulted in three publications in clinical studies and one publication in pharmacology.
These commercial successes go hand in hand with intense clinical research activity in collaboration with Belgian universities such as Ghent University (osteoarthritis of the hands) and the KU Leuven (nausea in pregnant women). In addition, the laboratory has launched the “ELETILMEX” project for which it has received European funding from the ERDF fund. This project explores the anti-inflammatory properties of boswellia and the immunostimulant properties of quercetin in order to determine a sufficient and reproducible dosage of the active ingredients. Excessive quality control of the ingredients, traditional knowledge and modern technologies are combined to propose innovative solutions.

This eager for innovation bodes well for Tilman. The laboratory is always on the search for new studies to launch in collaboration with Belgian universities. This is an important guarantee of quality and efficacy at a time when the number of scientific publications on herbal ingredients is booming and the competition from Asia, with its thousand-year-old tradition in this field and its high financial resources, is clearly making itself felt. In this respect, Tilman was recently involved in a very promising new study: it targeted the impact of herbal ingredients on 3,000 genes in order to better understand - and thus better control - the interactions between these ingredients and inflammatory and immunological mechanisms. The aim was to develop more effective galenic formulations. Ultimately this study was published in a leading journal. Scientific recognition for Tilman and new treatment perspectives for lovers of natural chemistry!

Tilman
15, ZI Sud - B-5377 Baillonville
Tel.: +32 (0)84 320 360
Email: info@tilman.be
https://www.tilman.be/
An interview with Prof. Dr. Arjen F. NIKKELS MD, PhD, ULiège Faculty of Medicine, Department of Clinical Sciences, Department of Dermatology and Vererology
What are the key figures for the Dermatology Department?
The Department of Dermatology monitors 45,000 patients a year, thanks to its team of doctors (11 FTE), nurses (4 FTE) and secretaries (3 FTE). Over the last 10 years, it is also involved in more than 60 clinical trials and has over 230 scientific publications listed on PubMed, with an H-index of 30.
What are the Dermatology Department’s main areas of research?
We have three main areas of research.
In the field of allergology, we are developing tests to detect allergies to contrast products used for radiographic imaging, to drugs as well as for food allergies.

In the field of dermato-oncology, we are studying viro-oncogenesis and in particular the beta papillomaviruses: our aim is to understand the role played by this virus in the development of squamous cell cancer, the second most common form of skin cancer after basal cell carcinoma.
In the field of cutaneous infectiology, we are working on diagnostic tests for herpes simplex and varicella-zoster viruses, in particular for their atypical manifestations.
Could you give us a few examples of current clinical trials?
A clinical project evaluates the role of teledermatoscopy, which allows us to ‘zoom in’ on suspicious pigmentary lesions to determine whether an urgent treatment is required.
Another study involves the transcutaneous administration of a chemotherapeutic agent, methotrexate (MTX), for the treatment of patients suffering from different forms of superficial cutaneous cancers. The aim is to couple MTX with hyaluronic acid, enabling it to be administered topically in high doses while remaining in the skin - a valuable asset to avoid any systemic repercussions.
What research collaborations have you developed?
Our various research projects involve collaboration with other departments at ULiège: the ENT, Pneumology, Paediatrics, Oncology as well as the Pharmacy and Galenics departments.
We also collaborate with the Universities of Maastricht and Aachen on the ‘oncology’ aspect of our research.
What do you see as the main challenges in dermatology research?
We’d like to be able to study more easily diseases that are neither rare (0.1 per 1000) nor frequent (>10% of the population), but still affect between 1% and 5% of the population. I’m thinking in particular of pityriasis rubra pilaris (PRP), lichenoid pityriasis, lichen planus, etc. So it’s important to have easier access to investigational medicines, even if the pharmaceutical industry considers these diseases to be of little financial interest.
Another challenge is the development of gene therapy for dermatological diseases whose gene origin has been demonstrated. We hope to see rapidly solutions for this, drawing on the ease of access afforded by the skin. In all cases, we are striving to meet unmet medical needs in dermatology.

Clinical aspect of a large sBCC (1a), aspect under occlusion directly after treatment (1b), aspect one month after last treatment (1c), total histological clearing after OFA-LP3-MTX3% (1d) (H/E, x10, scale bar = 140 microm), and persistant sBCC nests (yellow arrows) after LP3-MTX3% (1e)(H/E, x10, scale bar = 140 microm).
(J Invest Dermatol 2020 Mar;140(3):583-592).













 © Viridaxis
© Viridaxis
© Viridaxis
© Viridaxis
© Viridaxis
© Viridaxis
Created in 2004 from research conducted at the Ecology Laboratory of the UCLouvain, Viridaxis produces parasitoids to combat the aphids that affect the sheltered crops of horticulturalists. This is a major technological innovation and a promising alternative to synthetic pesticides that disrupt biodiversity and harm human health.

5% of organic or sustainable growers who grow crops in tunnels or greenhouses use products at least in part. One billion insects are marketed each year in 60 countries, 70-75% of them in the European Union. This is a real success for this company of 45 employees, which has an annual turnover of €10 million. It owes this success to a technology that is unique in the world, first developed at UCLouvain and then by its own research team. This technology has enabled the company to develop a robust system for efficiently multiplying very high quality parasitoids.
The mode of action is as follows: the parasitoid lays an egg in the aphid. The egg becomes a larvae which feeds of the inside of the aphids. After approximatively ten days, the larvae weaves a cocoon and then produces a mummy from which emerges an adult, a 2 to 3 mm flying insect whose antennae enable it to locate aphids in crops. This is far more effective than the search system of predators such as ladybirds. In addition, the production method does not involve plants, but rather nutrient solutions, colours and odours which ensures that very high constant quality parasitoids multiply within two weeks. This ensures that the parasitoids are always available. This is a boon for growers who are subject to fluctuating weather conditions.
Viridaxis is able to multiply half of the hundreds of aphid parasitoids that exist, but it regularly produces ten or so that are particularly interesting for insect control and markets six in particular: Aphidius colemani, Aphidius ervi, Aphidius matricariae, Aphelinus abdominalis, Praon volucre and Ephedrus cerasicola. They can be marketed separately (per species) when the aphid species is already known to the grower, or as a cocktail to control all aphid

species on a given crop - like FresaProtect for strawberries. Parasitoids can be used as a preventive or curative measure, but it is better to prevent than to spend more afterwards!
Viridaxis is currently working on three major R&D projects with three objectives: to develop new technologies targeting other types of insects, to find insects to effectively control other pests and to bring about tests to develop products for open crops. More than ever, Viridaxis is listening to horticulturists to develop insects of high quality, high availability and high flexibility. In this way, the company actively contributes to reducing the use of chemical pesticides. For the benefit of all living things.

Viridaxis SA
Rue Louis Blériot, 11 B-6041 Gosselies
Tel.: +32 (0) 71 48 72 25
Email: info@viridaxis.com
https://www.viridaxis.com/



Michel Georges, you are director of the GIGA since 2016. What are the missions of the GIGA for you?
GIGA’s motto is “Striving for academic excellence in the biomedical sciences to foster groundbreaking medical innovation.” The “academic” emphasis stems from GIGA’s dual mission: research and education. GIGA’s members share the ambition to conduct research that is internationally recognized for its excellence. An honest indicator of research performance is the number of ERC grants awarded to GIGA PIs. It presently stands at eight. Compared to other centers in French-speaking Belgium, this is excellent. Yet, we can increase the number of ERCs [and other grants promoting excellence such as FNRS and Welbio] even more by joining forces. Strength in science lies in cross-fertilization: the “I” of GIGA (interdisciplinary). GIGA counts more than 100 postdoctoral fellows and over 260 PhD students. It is their PI’s responsibility to ensure that the time spent at GIGA becomes a springboard for a rich and fulfilling life. Young scientists should want to join GIGA not only to become skilled researchers but also to acquire soft skills required by public and private organizations alike. It is the mission of GIGA’s doctoral school to support PIs as mentor. If we reach the primary goal of academic excellence, innovations benefitting society will – with appropriate support –naturally follow.
We know that research is an increasingly competitive and ruthless environment.What values do you defend in this context?
It is important to define for one-self some guiding principles, key values that are not to be compromised.
GIGA proposes four:
BALANCE: one cannot be a good scientist for the long run, if at the expense of family, loved ones, or health.
ACCOUNTABILITY: the quality of the working environment is not a given, but rather a reflection of how much each one of us contributes to make it better.


INTEGRITY: it is better to publish negative results that have been obtained rigorously, than to publish results that you know or should know are not going to stand the test of time.
KINDNESS: have you, today, expressed your gratitude to at least one of the many people, scientists or not, that in various capacities make it possible for you to do your work?
One of the great strengths of the GIGA is that it has state-of-the-art technology platforms directly accessible to researchers. Can you tell us more about this?
GIGA technology platforms result from the pooling of technological and human resources to offer state-of-the-art technology, to adequately meet the needs of the researchers. Each technology platform is managed by a scientist and an academic researcher and offers services to academic as well as industrial researchers.
Since the development of new next generation sequencing tech nologies, the field of genomics has had an immense boost. Application of these new technologies have rapidly become common practice in many research and diagnostic fields. Sequencing whole genomes of known and new species are now routine experiments.
The GIGA genomics platform offers a wide range of services in bulk or single cell DNA/RNA analysis. Technologies ranges from Sanger sequencing to high throughput genotyping, high throughput sequencing and to long read sequencing.
The Bioinformatics platform provides scientific support for Genomics data analysis. From experimental design to result interpretation, they can help with the utilization of existing tools and the development of new ones.
The GIGA Cell Imaging Platform has over 14 dedicated systems for advanced light microscopy that are used in a broad range of research fields such as cancer, virology, neurology, infectious diseases, inflammation, immunity, infection,… The GIGA Cell Imaging Platform offers state-of-the-art equipment and expertise ranging from simple wide-field to super resolution microscopy.
Flow cytometry allows qualitative and quantitative analysis of particles, e.g. monodispersed cells that have been marked with fluorescent probes targeting a wide variety of different molecules such as membrane antigens, cytokins, nucleic acids, viral receptors or calcium ions. This technology is used in a broad range of research fields such as cancer, virology, neurosciences, infectious diseases, inflammation, immunity, infection...

The GIGA Flow Cytometry Platform offers state-of-the-art equipment and is staffed with scientists and technicians who have an extensive expertise from simple to multiple immunostaining flow cytometry analysis and who train researchers to use the flow cytometers properly to answer their research questions. They also conduct all the cell sorting and cloning when requested.
The GIGA-Cyclotron Research Centre in vivo imaging is a major hub of research and development at the forefront of in vivo clinical imaging and translational studies. Research at GIGA – CRC IVI range from radiopharmaceutical production to in vivo imaging. Studies in humans are typically conducted for understanding biological processes underlying sleep, mood, cognition (memory, attention, executive functions), movements and their disorders (fatigue, dementia, Parkinson, multiple sclerosis, stroke…).
Other research thematics can be addressed and our platform offers advanced preclinical (see dedicated folder of the CRC preclinical IVI platform) or clinical multimodal functional and anatomical imaging solutions for a broad spectrum of application fields such as neurology, cardiology, inflammation and cancer research. We can conduct radiopharmaceutical projects «from the lab bench to the patient» and we can run clinical trials. The platform is open to all researchers, from public and private institutions, and for specific research trials from industry.
The Immunohistology platform provides all the material, techniques, and know-how to perform consistent and reliable histological studies. This facility has the equipment and expertise for paraffin processing and embedding of fixed and frozen samples, as well as sectioning of paraffin embedded or frozen samples.
Furthermore, thin-layer cell preparations from cell suspensions can be produced if requested. The facility offers both tinctorial and immunohistochemical staining. Finally, the platform has developed and optimized paraffin sectioning as well as staining of firm tissues such as bone and cartilage. The platform is currently extending its expertise to plant tissues as well. Experienced staff is available to provide standardized or tailor-made services for most histological requests.
GIGA-Proteomics
Proteomics is the study of the proteins content (identity, quantity and localization) in cells, a tissue or an organism. To characterize proteins and their modifications, the discipline requires skills in mass spectrometry, data mining and biochemistry. Mass spectrometr y-based methods

in proteomics are steadily in evolution and their developments are closely linked to the use of state-of-the-art MS instruments. Besides proteomics, the platform also offers services of proteins characterization (sequencing, posttranslational modifications, heterogeneity…),targeted quantification (biologics, biomarkers…).
The platform can provide supports to researchers from academia and industry in designing and performing proteomic analysis and in a larger extend to mass spectrometry-based experiments. Collaborative projects can also be set-up from full method development to improvements of existing SOPs.
You need to express a specific protein in your cells of interest? You need to inhibit or KO specific protein expression in your target cells? The GIGA-Viral Vectors platform can help you!
The most important key step when using viral vectors is to design the more suitable vector for your target cells in order to ensure correct, most efficient transgene expression. Moreover, this will reduce the quantity of vectors that you will need and of course this is cost saving. Viral vectors are viruses which have been modified for the purpose of introducing genetic material (transgene) into a cell. As they are the most efficient tool for gene delivery, they are very useful for fundamental research, therapeutic treatments for disease and gene therapy.
The GIGA viral vectors platform team will start to help you at this critical key point in your project and will then generate your own custom viral vector adapted to your target cells.
The GIGA animal facility offers a broad range of (internal and external) services such as housing, management of reproduction, imaging, surgery, experimental behavior recording while monitoring carefully the sanitary status of the housed animals. If needed, experiments can be performed in biosafety levels 2 or 3. Prior any experiment, the experimental protocol has to be approved by the Institutional Animal Care and Use Committee.
Additionally, quality procedures have been implemented and the GIGA Mouse facility which is frequently audited by external companies works under ISO17205-like conditions. For this, standard operating procedures are available as well as a traceability system. GIGA Animal Facility follows the guidelines of the Belgian legislation regarding mandatory training of people involved with the animals (animal caretakers, technicians and researchers).

Biopharmaceutical company based in Liège, Dendrogenix is dedicated to developing “New Chemical Entities” (NCE) named Dendrogenins till early clinical development. These small molecules produced by the cholesterol metabolism stimulate cellular differentiation and promote neuronal survival. Dendrogenins are designed to address important unmet medical needs in the field of neurological disorders resulting from synaptic neuronal deficiency, such as “Hearing Loss” and more specifically presbycusis or age-related hearing loss. A first drug is expected to be on the market before 2030. We met with Stéphane Silvente, CEO of the company.
Stéphane Silvente, since 2018, Dendrogenix develops first-in-class molecules, Dendrogenins, to address high unmet medical needs in hearing loss and neurology?
Dendrogenix currently employs around 20 people, including doctors in chemistry and biology as well as consultants who are experts in preclinical and clinical pharmaceutical regulatory development. Our company is active in the deafness market, for which there are no approved drugs yet and only hearing aids that amplify sound are available. The World Health Organization (WHO) estimates age-related hearing loss, regrouping people aged 60 and over, is the most common cause of hearing loss in the world and will reach more than 500 million people by 2025. Dendrogenix is also a promising company in neurology. In this second area, Dendrogenix launched its R&D program called “STROMA” in September 2022. This ambitious program covers the indications of ischemic stroke and trauma brain injury (TBI). Dendrogenix filed a patent application in 2019 for a breakthrough technology in this area for which there is no effective therapeutic solution. This patent has already been granted in Europe. The STROMA project is financially supported by the Department of research and technological development of the Walloon Region which provided a grant of 1.5M€
2023 has been a pivotal year for Dendrogenix. You have launched the first clinical trial on Dendrogenins to tackle age-related hearing loss? In the field of deafness, after submitting via CTIS platform a clinical trial request to the Federal Agency for Medicine and Health Products (FAMHP) in Belgium early in June 2023, the Clinical Trial Authorization (CTA) Report has been accepted at the end of August 2023 for starting a monocentric first-in-human (FIH) clinical study in Belgium from September 2023. After the successful recruitment of the first healthy volunteers for phase 1 in September 2023, the phase 1/2a study was able to start on Monday October 2, 2023, at the single ATC Pharma clinical site in Liège. The phase I is subdivided into two parts. Part A consists of a single ascending dose study, with a maximum of 80 healthy volunteers included. Based on the results of the part A, Dendrogenix will define both doses: the low and the high doses used in the part B of the study. Part B will consist of a multiple ascending dose study with a maximum of 24 healthy volunteers included. Based on the results of the part B, Dendrogenix will assess the tolerability of multiple dose administration of the DX243. The phase IIa will consist in a multiple ascending dose study, with a maximum of 24 patients administrated by the DX243.
This second part of the clinical study will provide Dendrogenix with preliminary efficacy results, required to design the phase 2b study. The described study is expected to last 2 years.
For this development project, you can count on the financial support of key-partners?
This clinical phase 1/2a is financially supported by the Department of research and technological development of the Walloon Region (Wallonia research SPW - CLINEAR project) which provided 2.5M€ as financial support. Two fundraising events have already been successfully completed, involving several investors such as NOSHAQ & WE, as well as the private company MED-EL, specialized in electronic hearing aids.
Your company can also rely on a strong Scientific Advisory Board?
Dendrogenix’s expertise is centered around the chemistry and biology of Dendrogenins, a new class of molecules, and their innovative mechanism of action, which has already made an impact on the minds of leading experts in the field of deafness. Some of these experts sit on the company’s Scientific Advisory Board, which regularly calls on them to continue its clinical work at their best. In parallel, Dendrogenix has developed international research partnerships with leading players in the field of deafness and neurology, including world-renowned academic centers such as the GIGA-Neurosciences at the University of Liège, and the University of Tübingen in Germany.
In addition to the clinical development platform, Dendrogenix has developed a technological platform?
Dendrogenix has developed expertise in the production process of the Dendrogenins thanks to its Medicinal Chemistry and Biology innovative Technological Platform which makes it possible to generate new molecules. In addition to our Clinical Development

Platform which draws on the expertise of our internal clinical team, Dendrogenix has developed a Technological Platform. Its main objective is to synthesize new molecules derived from Dendrogenins (analogs and prodrugs) and assess the therapeutic effectiveness of these new drug candidates in neurological diseases. This platform has therefore set up several in vitro and in vivo models of neurological diseases, enabling us to file patents, carry out proofs of concept, screen the effectiveness of their portfolio of chemical structures and discover by what mechanisms of action they work. Thanks to the technological platform, Dendrogenix has filed one family of patents for the past 4 years. Dendrogenix can be proud of its performance!
The strength of Dendrogenix also lies in this forward-looking potential? Definitely! Our company is watchful to market developments and wants to focus primarily on the area of auditory degeneration, while remaining open to other potential applications in various neurodegenerative diseases such as brain damage due to failure, and other neurodegenerative diseases related to mitochondrial dysregulation. In this regard, our company’s chemists and biol ogists are continuously working on the development and protection of the intellectual property resulting from new generations of Dendrogenins, as well as their therapeutic applications in new indications in neurodegenerative diseases.
Stéphane Silvente, it’s clear that the staff and scientists behind Dendrogenix are essential, but for you, investors are equally important to the development of your company?
Since our primary goal is to sell products, we want to take them as far into clinical development as feasible, at least to the end of phase II. As a result, rather than picturing a single transaction including all our IP’s, our strategy is centered on fostering the development of different indications through various partnerships. This plan of action relies on a well-structured investor syndicate. I have to say that I’m highly satisfied and proud of the composi tion of our board, which includes sovereign investment funds such as NOSHAQ as well as influent people like Prof. Ingeborg Hochmair, researcher and CEO of MED-EL, famous for creating the first micro-electronic multi-channel cochlear implant in the world.


What are Dendrogenix’s long-term goals
Dendrogenix can rely on its academic partnerships and its well-advanced clinical trial projects to confidently look forward to its medium-term development prospects. Dendrogenix also aims to extend its expertise in Dendrogenins to other families of derivatives or molecule analogs from the first generation. To do this, we can count on our experienced team to enhance our performance, through the extension of our initial patents and a new generation of Dendrogenins covered by the transformation of Belgian patents into international patents.



- Biotech company dedicated to the development of Dendrogenins till early clinical development
- CEO: Stéphane Silvente
- Areas of research: hearing loss and neurology - 20 employees based in Liège, Belgium
- Ongoing clinical trial: DX243 in the indication of presbycusis - phase I
- Ongoing preclinical trial: STROMA - DX243 for stroke indication
Dendrogenix
11, avenue de l'Hôpital - 4000 Liège
Tel.: +32 (0)492 781 781
Email: contact@dendrogenix.com
https://www.dendrogenix.com/
Created in 2004, Trasis provides hospital suppliers with the means to produce radiolabelled compounds. Trasis products consist of synthesizers, dispensers, and consumables. Our objective: to facilitate introduction of the newest radiopharmaceuticals into clinical practise.
Currently present in about one third of the world’s radiopharmacies thanks to its bestseller the AllinOne synthesizer, Trasis has now grown to more than 280 employees, having 60 engineers and chemists in R&D alone. An EU-GMP Part 1 and Part 2 certified company, Trasis opened a US subsidiary in 2020 and currently invests 16% of its turnover into R&D.
Due to this growth, Trasis undertook, in 2021, the construction of new facilities that will add an additional 5,000 square meters to the existing ones, which will be inaugurated in April 2024. This dynamism is directly linked to Trasis’ know-how involving a highly diversified staff with expertise in process automation, synthetic and analytical chemistry, regulatory affairs, software engineering, mechanical design,plastics component engineering, clean room operations, customer service, etc.

Trasis offers four types of products meeting the needs of all stages of radiopharmaceutical production and administration: synthesizers allowing for the production of pharmaceutical molecules labelled with radionuclides; instrument for radiopharmaceuticals quality control, dispensers for the preparation and administration of

radioactive drugs designed for minimal exposure to medical staff; consumables such as drug specific cassettes and reagent kits for the synthesizers, and sterile sets/ syringe-like cartridges for the dispensers.


Radio-labelled pharmaceutical substances are used for medical imaging, such as PET, mainly in oncology but increasingly in neurology and cardiology. The main users of these systems are radiopharmaceutical production networks and university hospitals. In particular, systems for the preparation and administration of single patient radiopharmaceutical doses such as the Trasis Unidose machine, prepare customised doses on demand and provide unparalleled radiation protection for medical staff. A new generation of these systems designed to be more attractive and affordable is currently under development.
In 2023, Trasis has expanded its range of instruments by introducing two new devices to the market: the latest addition to the synthesizer family, AllinOne S, doubles the production capacity of radiopharmaceuticals, while the compact QC1 ensures quality control with fewer operator interventions and in under 30 minutes.
In addition, Trasis has expanded its offering by integrating Eras Labo, which joined the Trasis Group at the end of 2022. The acquisition of this Grenoble-based company, specialized in the manufacture of precursors, enables Trasis to secure part of its supply chains and represents a sought-after diversification opportunity beyond the radiopharmaceutical sector.
Trasis partners such as ULiège and Erasmus Hospital in Brussels offer nearby academic laboratories where cyclotrons produce radionuclides on a daily basis. These collaborations allow the company to test, develop, and improve radiochemistry process es. In addition, Trasis is in contact with research centres and drug companies around the world developing radiopharmaceutical drugs of the future. These drugs now include thera peutic compounds which, once injected into the bloodstream, bind specifically with various tumour cells proving to be very effective and giving new hope to many patients.

Trasis
Rue Gilles Magnée 90 - B-4430 Ans
Tel.: +32 (0)4 365 86 57
Email: info@trasis.com - http://trasis.com/


Could you tell us how GIGA Cardiovascular Sciences – Laboratory of Cardiology came about?
I co-founded this laboratory in 2013 with Prof. Patrizio Lancellotti in order to initiate translational research in cardiovascular sciences at the GIGA Research Institute. The research carried out here is based on my 25 years of experience in thrombosis and the biology of platelets. The aim is to gain a better understanding of how platelets func tion. Platelets are essential to prevent bleeding (hemostasis), but also for thrombosis causing cardiovascular pathologies. Thrombosis is responsible for stroke and myocardial infarction, since it can lead to the formation of obstructive clots in the cerebral and coronary arteries. Platelets also contribute to inflammation, immunity and even cancer.
What are your main areas of research?

We study thrombotic complications (coagulation- and platelet-led thrombus formation) induced by medical devices in contact with blood, such as prosthetic heart valves and catheters. In 2015 we obtained an ERC Consolidator grant to study the problems associated with prosthetic mechanical heart valves. We joined forces with a research team from CERM at ULiège to modify these prostheses, which are highly thrombogenic due to their metallic composition. We developed a new coating that clings to the metal.
In vitro tests (using human blood) and in vivo tests (in pigs) clearly demonstrated the inhibition of thrombus formation on coated mechanical valves, and these results were included in a study published in the Journal of Thrombosis and Haemostasis in May 2023. This work has given rise to the CMDCOAT spin-off, which is developing an antithrombotic and anti-infectious coating (see box). Our coating is based on an advanced polymer chemistry technology: a nanoreservoir made of drug-loaded nanogels attached to the surface of medical devices. This technology is protected by two patent families. The number of layers of nanogels can be adapted according to required quantity of drugs and duration of gradual release onto the surface of medical devices. The nanogels are cross-linked, i.e. they have extremely strong covalent bonds to form a very stable and durable multilayer assembly. We successfully loaded these nanogels with the
antiplatelet drug ticagrelor, thereby providing potent antithrombotic property to coated mechanical valves. In the framework of this project, we also discovered that ticagrelor also had antibacterial properties. The incorporation of this molecule into our coating had therefore a unique potential to simultaneously prevent both thrombosis and bacterial infection of coated devices, i.e., the two main complications of implantable medical devices. Ticagrelor antibacterial activity was validated in vitro in antibacterial assays against Gram-positive bacteria, including the most virulent ones (Staphylococcus aureus) and bacteria resistant to currently used antibiotics (e.g., methicillin-resistant Staphylococcus aureus, vancomycin-resistant Enterococcus faecalis). We then filed a patent for this new indication of an existing drug.
Could you tell us more about this new line of research?
We tested ticagrelor activity against multiple Gram-positive and Gram-negative bacteria, in presence of an outer membrane-permeabilising agent, in order to better understand the mechanisms of ticagrelor’s antibacterial action. We discovered that it has a unique mode of action, making it as active as the most powerful antibiotic against staphylococci. We also launched a collaboration with Prof. Bernard Pirotte’s Drug Research Centre at the ULiège Faculty of Medicine to modify the ticagrelor molecule, isolate its antibacterial activity and make it an effective antibiotic against bacteria. Since then, we have synthesised around a hundred antibacterial molecules, which have been the subject of two additional patent applications, with patents granted in several jurisdictions. In addition, the antibacterial activity of ticagrelor has been tested in vivo in mice: it clearly appears that this molecule inhibits the growth of biofilm in and around implants, at doses similar to those received by patients treated with ticagrelor. In fact, a major clinical trial showed that patients treated with ticagrelor died less of an infection than patients treated with clopidogrel, another antiplatelet drug. We have just published an article in the Journal JACC: Basic to Translational Science on our tests of ticagrelor in mice: a single dose prevents the development of endocarditis where another antiplatelet drug shows no efficacy.

Another line of research consists of studying the role of platelets in the progression of valvular heart diseases in order to identify new diagnostic or predictive tools. For this purpose, we are collecting and analysing patient’s blood samples.
Created in March 2021 by Profs Oury and Lancellotti, the CMD-COAT spin-off’s goal is to bring to market its antithrombotic and anti-infectious coating for implantable medical devices. The first application is venous catheters, the medical devices most commonly used in hospitalized patients and bringing high rates of thrombosis and infection. To date, no manufacturer offers coatings with this dual anti-thrombotic and anti-infectious properties, despite the fact that thrombosis increases the risk of infection and vice versa. To remedy this deficiency, the spin-off further develops this unique coating technology, which is protected by a strong IP (2 patents granted in 32 juridictions). CMD-COAT has also registered two trademarks in Europe: COATI-X® (coating) and Fluometacyl® (ticagrelor-derived active substance) (registration pending in
You also have a project on heart valve prostheses... Yes, we do. We are developing new polymers to produce a new type of prosthetic heart valve. Compared to currently used mechanical valves or bioprostheses, these polymeric valves will be more durable and less prone to thrombotic and infectious complications. What’s more, they can be 3D printed, making them ideal for producing prostheses tailored to each patient’s anatomy.
The manufacture of used polymers (non-isocyanate polyurethanes, NIPU) does not depend on the use of toxic isocyanate reagent. Following on from the Interreg 5 Meuse-Rhine project, which brought together participants from Aachen, Maastricht, Liège (ULiège, Sirris centre) and Hasselt, a doctoral thesis is underway in our laboratory to test several promising NIPU candidates: 3D printable, non-thrombogenic and even non-infectious. Ultimately, they could replace polyurethane in the production of catheters or other medical tubing, making it possible to develop more biocompatible, environmentally friendly medical devices.
Finally, a word about the European CLEAR (“Cell Envelope Anti-Bacterials”) consortium: our aim is to develop an antibiotic that replicates the mechanisms of action of ticagrelor. It’s a great way of answering an unmet medical need related to antibioresistance.
the United States). The potential is immense: the global market for central venous catheters is worth $2.5 billion a year.
In January 2023, Prof. Cécile Oury was appointed CEO of CMD-COAT, which is supported by ULiège (via GESVAL SA), and Walloon public investment funds. Strong with 5 employees, CMD-COAT is working in collaboration with business experts. The spin-off aims to engage a partnership with a catheter manufacturer to transfer its technology to industry. The aim is also to raise awareness of the brand and extend the application of this technology to other medical devices such as pacemakers, which give rise to severe infection problems, and prosthetic heart valves. Given that 50% of hospital-acquired infections are caused by medical devices, there is an urgent need to develop an anti-infectious coating that does not encourage the emergence of new bacterial resistances!


CMD-COAT


The ARCh (Adaptation, Resilience and Change) Research Unit, headed by Prof. Fabienne Glowacz, studies the psychological, social and societal processes involved in individual and collective trajectories. Resolutely multidisciplinary, it is structured into 10 laboratories involving 50 researchers and 30 PhD students. 17 theses have been defended over the last 5 years.

As part of ULiège’s Faculty of Psychology, ARCh conducts research and teaching activities on occupational and organizational psychology, training and education, criminological psychology, clinical psychology, mental health, violence, trauma, senescence, etc.
The originality of its work lies in a mixed approach, both quantitative (data) and qualitative (analysis of narratives and dynamic processes, field observation, analysis of subjectivities), based on regularly updated methodologies. This form of research applied to the field, with all the clinical and societal applications that it promises, was given pride of place at a major international scientific conference: organised on 13 and 14 October 2022 under the title “Understanding the processes of change. The contribution of qualitative and mixed methods”, the aim of the conference was to highlight the contributions of qualitative and mixed methods research in the human and social sciences to the study of change processes.
For ARCh researchers, the analysis of adaptation, resilience and change processes can be seen as a paradigm, i.e. a general framework that guides researchers in their methodological, ontological and epistemological choices. This framework includes a wide range of research themes: suffering at work and burn-out (“REturn to work after Burn-Out (RE-Born)”, a project funded by Belspo in collaboration with the ValoRH research laboratory - Prof. I. Hansez and Universiteit Gent - UGent), ageism and senescence (development of new intervention paradigms in nursing homes with the ongoing HABITAGE project “An integrative approach of habitat and health
for aged people” under the coordination of Prof. S. Adam; adult education with Prof. D. Faulx, who has published an excellent book, “Apprendre à penser autrement”, and higher education pedagogy (project “Elaboration of a competency reference framework and initiation of a training and assessment system promoting early and effective identification and referral of people suffering from psychotrauma(s)” led by Labset (Prof. M. Poumay) in collaboration with the CN2R (Centre National de Ressources et de Résilience, in France).
An important area of research is that of intra-family violence and conjugal violence: a research project is coming to an end on Intimate Partner violence during and after Covid (IPV DACOVID - financed by BELSPO), coordinated by Prof. F. Glowacz in partnership with Spiral (ULiège), INCC and VUB, and a project is starting on conjugal homicides, feminicides.
The impact of the Covid crisis is being investigated by a number of research projects, in the fields of mental health (Prof. F. Glowacz), child abuse (Prof. A. Blavier) and employment (Prof. I. Hansez)
A brand new project has just been selected and funded by Belspo, in which Prof. A. Babic is taking part in partnership with KULeuven, VUB, and Lentic ULiege. It is entitled “The Lasting Impact of COVID-19 on the Workplace: Analysing Effects on Well-being and Inequality among New Labour Market Entrants”.
Another major research project, EPCAP1&2 (Evaluation of Primary Care Psychology in Belgium) is conducted by Prof. F. Glowacz in partnership with the KUL. This project aims to evaluate over several years the new primary care system set up by the SPF (Federal Public Service) Health with a reimbursement system for psychological care that focuses interventions on early mental health detection and prevention in an ecosystemic approach.
The experience of surrogate motherhood, medically assisted procreation and homoparentality are the themes of clinical research carried out by the team of Prof. D. Naziri
In the healthcare field, the “ELS4A: Evaluation Longitudinale de Soins Ambulatoires Alternatifs pour Adolescent-s souffrant d’An orexie” (Longitudinal Evaluation of Alternative Ambulatory Care for Adolescents Suffering from Anorexia) project is led by


On 13 and 14 October 2022, the ARCh research unit organised a conference in Liège on the theme: “Understanding change processes. The contribution of qualitative and mixed methods”.
Prof. M. Morsa in partnership with the Université Sorbonne Paris Nord and the Hôpital Jean-Verdier, AP-HP (France).
ARCh also stands out for its research work in traumatology, with a particular focus on the consequences of acts of abuse during childhood and adolescence (Pr. A. Blavier). Another original feature of the Research Unit is its work on the use of hypnosis in the field of health, (Prof. A.-S. Nyssen) in collaboration with the ULiège Faculty of Medicine.
ARCh’s research work has led to numerous international scientific publications in the above-mentioned fields publications (https:// www.arch.uliege.be/cms/c_5026225/fr/arch-publications).
Sexual violence, gender-based violence, cyber-violence
The BEHAVES study (Bien-être Harcèlement et Violences en Enseignement Supérieur - Well-being, Harassment and Violence in Higher
Education) is another highly mobilising study for the Research Unit. Directed by F. Glowacz, this project is unique in that it focuses on polyvictimisation: moral harassment, cyber-violence and gender harassment, sexist and sexual violence subjects that are usually studied separately. Another innovation is that BEHAVES covers both students and staff in higher education institutions (13,000 people in all). The results will be published in February 2024, but they are already eagerly awaited, as they should make it possible to draw up an inventory of the situation, to specify the prevalence of such acts and their psychosociological impact in a holistic vision that is at once individual, organisational and intersectional (including variables such as gender, ethnicity, social background, etc.). The BEHAVES research report should also lead to scientific and policy recommendations based on the empirical data. BEHAVES is a mixed quantitative and qualitative research model (with focus groups to deepen the data collected, story analysis and the use of the Delphi method, a structured and iterative approach used to gather ideas and opinions from a group of experts in order to reach a consensus on a specific subject).
© ARCh Research UnitUliège
ARCh can boast numerous research collaborations at all levels. It works in partnership with all Belgian universities (ULB, UCLouvain, KUL, VUB, UGent, etc.). Internationally, a source of pride for ARCh is the co-founding of the Mukwege Chair (by Prof. V. Dekeyser, A.-S. Nyssen and A. Blavier), an international chair on violence against women and girls in conflict situations. Following the success of the first two international conferences held in November 2019 in Liège and November 2022 in Bukavu, ULiège hosted the 3rd conference of the international Chair on 23 and 24 November 2023. This third edition addressed the fight against impunity for perpetrators of violence against women and children in armed conflicts. Analyses were carried out using interdisciplinary research tools, including gender theory, to assess the impact of armed conflicts on women.
In the future, ARCh will continue this research, most of which relates to contemporary societal concerns in the fields of clinical psychology, criminological psychology, occupational psychology, health psychology and pedagogy. Analyzing the transitions and crises we are going through, their impact on mental health, psychological and pedagogical practices, and developing intervention models to support the processes of resilience, desistance and recovery are at the heart of its many future projects.

ARCh Research Unit – University of Liege Faculté de Psychologie, Logopédie et Sciences de l’Education (FPLSE)
Quartier Agora - Place des Orateurs, 1 Bât. B33 - Quartier Agora B-4000 Liège
Tel. : +32 (0)4 366 22 71
Email : fabienne.glowacz@uliege.be
https://www.arch.uliege.be/cms/c_4266664/fr/arch








As an integral part of CESAM (Complex and Entangled Systems from Atoms to Materials) and of the department of chemistry of the University of Liège, the CERM develops proven expertise thanks to its academic strength, its three permanent FNRS researchers, its three senior scientists, its two post-doc researchers, its fourteen postgraduates and four technicians and administrators.
As an international team of chemists, CERM is active in fundamental and applied researches focusing on the development of innovative polymers for biomedical and healthcare applications and eco-strategies of polymer synthesis contributing to a safer environment.
It specializes in the synthesis of polymer materials along two main lines: the development of innovative biodegradable materials (ring-opening polymerization, step-growth polymerization) and sustainable polymerization processes. CERM also owns a unique platform (FRITCO2T) in Europe that is dedicated to the transformation/valorization of carbon dioxide into low carbon footprint materials (coatings, adhesives, foams and biomaterials).
The CERM enjoys a wide range of research partnerships, starting at European level with the INTERREG IN FLOW project (flow formulations of biodegradable materials for food, biomedical and healthcare applications). It is also very active in the field of medical devices. In this context, it recently participated in the ERC “PV-Coat” European project on the coating of heart valves and in the INTERREG PolyValve project targeting the development of new materials for heart valves leading to the creation of CMD-Coat SME. CERM is also involved in MSCA European Join Doctorate networks, such as EJD NIPU and D-Carbonize. The first one deals with the development of new chemistries to prepare non-isocyanate polyurethanes from carbon dioxide for the production of low carbon footprint and recyclable foams, coat ings and 3D printing inks. The second one has the ambition to merge the carbon dioxide chemistry with bio-based products for the next generation of greener polymer materials.

The CERM can capitalize on important industrial partnerships with Solvay, Solvin, ArcelorMittal, Saint-Gobain, UCB, Dupont, Bayer, and recently Chanel, so as a great number of SMEs. Particularly, the CERM co-conceived a patent intended for the development of a biomedical implant eluting a contraceptive agent (the patent is being exploited by Mithra), it ensured the reparation of one of the components of intraocular yellow lenses produced by PhysIOL, develops new hydrogel-based medical devices for Dermax (now in the clinical development phase) and elaborates new trends for future products on the basis of patents against royalties. Incidentally, the CERM initiated startups such as EyeD Pharma based on the development of drug-eluting implants for ocular pathologies.
The CERM currently remains involved in many collaborative research projects related to the implementation of biomaterials which have already passed clinical tests, as well as the development of new processing methods such as electrospinning and 3D printing to design scaffolds stimulating cellular regeneration or various medical implants. Finally, the CERM goes into greater depth on the green technology of super critical CO2 to design sterile medical devices (suture threads or implants) with anti-inflammatory properties.
Doubtless, the CERM stands well equipped and ready to address the five major challenges which confront it, from developing synthesis techniques to implementing greener processes (organocatalysts, solvent-free processes, chemical reactions based on atom economy), to helping advanced chemistry, and developing recyclable polymer materials as foams or multifunctional coatings with aqueous processes or without solvents, or developing competitive biomaterials.

CERM, with its unique expertise in polymer chemistry, its state-of-the-art equipment for polymer characterization, processing and formulation, and its CO2 valorization platform, is a partner of choice for boosting the competitiveness of companies active in the healthcare and biomedical sectors, and for supporting companies in the ecological transition.

Center for Education and Research on Macromolecules (CERM)
Université de Liège (ULiège)
Institut de Chimie (B6a)
Agora, Allée du 6 Août, 13 - B-4000 Liège
Tel: +32 (0)4 366 34 91
Email: c.jerome@uliege.be
http://www.cerm.ulg.ac.be/


Created in 2016, the Chemical Engineering Research Unit comprises 80 members including 7 academics, 4 permanent scientists, 20 postdoc or senior researchers and more than 40 PhD students. Chemical engineering and process engineering are applied to design sustainable processes for transforming material, energy, microorganisms and living cells.

With an annual operational budget of € 4-5 million (with 50% coming from public research contracts and 17% from services provided to man¬ufacturers), the Chemical Engineering Research Unit relies on its 2 founding groups (NCE - Nanomaterials, Catalysis, Elec-trochemistry -, and PEPs - Products, Environment and Processes) to carry out its work around 4 main themes: energy, the environment and natural resources, engineering innovative materials, and health . These research activities are further supported by the CARPOR platform, specifically dedicated to the Multi-scale Characterization of Porous Media. CARPOR offers researchers from both academia and industries a panel of complementary techniques allowing for the characterization of materials porosity from the nanometer to the millimeter scale, evaluating thermophysical properties and humidity behavior, as well as the 3D visualization of materials. To that aim, the equipment includes micro-computed tomography, gas adsorption, mercury intrusion porosimetry, gas pycnometry, thermogravimetry-differential scanning calorimetry, moisture analysis and dynamic water vapor sorption.
The Chemical Engineering Research Unit is very active in the field of environmental transition as demonstrated by the FRITCO2T (Federation of Researchers in Innovative Technologies for CO2 Transformation) Platform: four research laboratories at ULiège joined their forces to accelerate the development of new
technologies/products enabling the capture and re-use of emissions. In addition, the PROCURA project (Power to X and Carbon Capture & Utilization Roadmap for Belgium), a Belgian Energy Transition Fund project implying 6 Belgian partners, relies on the ULiège to evaluate the potential for CO2 capture in Belgium and draw a roadmap for this purpose. CO2 and H2 technologies are also dealt with in the TRILATE project: this project from the Belgian Energy Transition Fund targets an integrated analysis of energy infrastructure at industrial clusters level. The team is also active in several projects related to the Resiliency and Recovery Fund of the European Green Deal: Saturn (study of CO2 capture technologies in a consortium with 4 major Belgian industrial players), and NKL (study of CO2 conversion towards e-kerosene, with a special focus on the reverse water-gas shift reaction). Significant experimental equipment for CO2 capture and re-use is also under development, funded by the Walloon-Brussels Federation Resiliency and Recovery Fund. This equipment concerns CO2 capture by absorption in amines (capture of 1 ton/day) in the fumes of biomass cogeneration, and the conversion of CO2 into e-kerosene in order to meet the growing demand for e-fuels imposed by the European Union on the aviation sector (0.7% in 2030, 28% in 2050).
With its expertise in (bio)reactors design, the Chemical Engineering Research Unit brings its expertise to the design of new bioreactors
for the large-scale culture of stem cells for therapeutic applications in the frame of some collaboration with industries like GSK and Silox, a PDR project funded by FRS-FNRS and of a PhD super vised jointly with the University of Lorraine.
The Chemical Engineering Research Unit is involved in (photo) catalysts and inorganic (nano)structures development and use. In the project Era-Net DAF3D “Development of new antibacterial functionalised textiles and 3D-printed filters for process water treatment” (31th call CORNET “Collective Research Networking”), the aim is to validate at pilot scale the effective and definitive disinfection performance of filters functionalized with antibacterial agents like ZnO in the dark. At the regional level, the PhotoTex2 project (WIN2WAL Programme of the Walloon Region) deals with the development of textile films with permanent antimicrobial properties by grafting ZnO-based photocatalysts for the manufacture of uniforms and protective textiles in hospitals. Furthermore, the Walloon project Win2Collective MICROECOTEX aims to produce antimicrobial textiles and coatings for medical (treatment of burns and wounds) and agri-food (food preservation) applications. These textiles and coatings are developed from a silica-alginate composite which will contain polylysin, an antimicrobial agent of natural origin, which will be released in a controlled and sustainable manner over several days/weeks.
The team is also part of the new GreenWin projects MultiO “Functional and modular swimming pools for optimized management of water and energy in the sustainable habitat of tomorrow” and DELFICAR “Biocid filter with managed CO2 capture”. The project MultiO targets an innovative system that will allow the safe reuse of treated wastewater and rainwater in residential uses (including that of the swimming pools). In this project, the Chemical Engineering Research Unit will develop an electro(photo)chemical unit for the degradation of pollutants, and the disinfection of rain waters. The project DELFICAR aims to create filters for air handling units which will integrate several functions (biocide and CO2 management) to improve indoor air quality.
In the field of development of microbatteries, the Chemical Engineering Research Unit is active in different projects like M-Era.net PLASMANODE “Plasma-modified powder materials for Li-ion battery anodes processable by water-based techniques” at the European level, and in the regional project Win4Doc CATHOPLASM “Plasma treatment of materials for the manufacture of positive electrodes of Li-ion batteries by environmentally friendly processes”.
More recently, the Chemical Engineering Research Unit has been selected to participate in three major research projects of the European program Horizon Europe (Sustainable, Secure and Competitive energy supply). For these projects focusing on photovoltaics (PV), the Research Unit will deal with aspects related to eco-design and the analysis of the life cycle of materials implemented in this field with the aim to develop a sustainable, secure and competitive energy supply and alternative, innovative photovoltaic technologies. These projects are called PILATUS, PEPPERONI and VALHALLA.
Another hot topic concerns the reduction of the environmental impact in the building sector, either by promoting recycling of demolition waste or by finding alternative materials during the
production of cement or concrete. The Chemical Engineering Research Unit is in charge of the environmental aspects of several projects in this field, applying Life Cycle Assessment (LCA) in an eco-design approach (REMIND « Reverse MINeral INDustry in Wallonia » in the Walloon recovery plan; Greenwin projects “Geoslags: Formulation of mineral foams” and “Recob2: Formulation of recycled plaster panels”; Win4collective project “Sare4Be: Valorisation of sand from recycling in concrete”.
In the new project CISTEMEEC, part of the Reverse Metallurgy+ portfolio deposited by the Reverse Metallurgy platform as part of a call launched by the Walloon Government for the implementation of the Circular Wallonia strategy, the Chemical Engineering Research Unit, in partnership with two other laboratories from the University of Liège (GeMMe and GREEnMat), operates in the Li-ion battery recycling sector. Currently these batteries are collected and sold at negative cost to processing centers outside the Walloon Region. Also, this project works in the copper sector, and in the chain of rare earth elements contained in the permanent magnets of electric motors and lost in the flow of scrap metal reaching the steel industry. The team is also part of Phos4You, a North West Europe (NWE) INTERREG project, during which the PULSE pilot for phosphorus recovery in wastewater sludge was designed.



UR Chemical Engineering - ULiège
Quartier Agora - Allée du 6 Août 11, B6
B-4000 Liège (Sart Tilman)
Tel.: +32 (0)4 366 44 36
E-mail: secretary.chemeng@uliege.be
https://www.chemeng.uliege.be/cms/c_2275100/fr/ chemical-engineering-portail
CARPOR Platform - UR Chemical Engineering - ULiège
https://www.carpor.uliege.be/cms/c_14238965/fr/carpor

Specializing in the development and manufacture of advanced industrial laboratory instruments for characterizing powder behavior, Granutools boasts an impressive 3-digit percentage growth and an installed base across 25 countries on 4 different continents.
Providing accurate and reproducible measurement techniques for powders: that’s Granutools’ goal.
Founded in 2016 to bridge the gap between complex systems and manual devices, the company offers a range of instruments and services to help industries handle and process powders efficiently.
With numerous customers worldwide, a team of scientists and experts, and numerous research projects in various industries, Granutools has solid expertise in the field of powder flow characterization. This expertise is demonstrated by a series of five complementary instruments. Instruments renowned for their innovative character, high reproducibility, precision and ability to operate independently of the operator. What’s more, Granutools regularly updates its software to adapt to customer feedback and market developments, ensuring that its products remain at the cutting edge of technological innovation.

Granutools therefore offers a set of five instruments - complementary tools that address specific powder analysis challenges. GranuFlow measures powder vertical flow rate, GranuHeap automates angle of repose and static cohesion measurements, GranuDrum evaluates cohesive index and dynamic angle of repose, GranuPack measures tapped density and packing dynamics, while GranuCharge quantifies electrostatic charges before and after powders pass through different materials. In addition to these instruments, Granutools is actively developing software tools to help industry and academia better understand their powders.
Recently, Granutools launched an innovative new measurement of permeability at various consolidation with the GranuPack Permeability. It features a measuring cell specially designed to assess the permeability of powders. The ability of air to pass through a powder is essential in various applications such as silo operations, compression processes and dry powder inhalers. By measuring airflow velocity and pressure drop, the GranuPack Permeability instrument enables powder permeability to be assessed. This new addition to Granutools’ product range offers a versatile solution for measuring physical parameters related to powder packing dynamics and fluidization.
A great example of collaboration is the one between Granutools and the University of Bolton/Centre for Advanced Manufacturing (CfAM) which represents a significant step in advancing research and industrialization of additive manufacturing (AM). The University of Bolton, with its expertise in AM, is focused on redefining the approach to AM design, characterization, and production. The CfAM acts as a bridge between academic research and industry, offering a wide range of AM capabilities and educational programs. The integration of Granutools’ instruments into their laboratory provides invaluable tools for powder flow characterization, a crucial aspect of AM. Granutools’ instruments enable rapid and cost-effective analysis of powders, aligning with the CfAM’s goal of supporting
AM growth and optimizing processes. Granutools’ commitment to similar collaborative endeavors extends across a diverse range of applications, spanning from battery manufacturing to pharmaceutical projects.
Granutools also offers services in its own fully-equipped laboratory. Its team of particle scientists offers customers a comprehensive, discussed and explained analysis of test results. In addition, its experts deliver webinars, courses and training on powder behavior to enhance industry knowledge.
In 2023 Granutools saw a marked increase in demand for powder characterization. Proof, if proof were needed, of the value and relevance of its offerings to the market. Similarly, the strong interest shown by companies involved in energy and battery manufacturing augurs well for future expansion. All the more reason to be optimistic for Granutools, a resolutely agile company, on the lookout for market dynamics and emerging opportunities. A company confident in its solution. And rightly so!

Granutools
Rue Jean Lambert Defrêne 107 - B-4340 Awans
Tel.: +32 (0)4 384 00 74
Email : info@granutools.com
https://www.granutools.com/en/
Created in 2000, GRASP brings together some twenty researchers, including five senior researchers, in a rapidly expanding field of research: soft matter. Each year, it publishes about ten scientific articles in high-impact journals and has about fifteen ongoing research projects.
They are said to be fragile, elastic, flowing, and can fracture or fragment: these representatives of soft matter are the subject of a recent field of research initiated by Nobel Prize winner Pierre-Gilles de Gennes. Unlike hard matter, which is at the origin of the development of electronics and micro-computing, soft matter is characterized by its elasticity and flow properties, with numerous potential medical applications: flexible sensors embedded in patches to take a patient’s temperature or programme the injection of Medicines at regular inter vals, implants, surgical micro- or nanobots, etc.

GRASP participated in the PowderReg project (Interreg Grande Région Sarre - Lorraine - Luxembourg - Wallonie): completed in 2022, this project led to the development of an industrial demonstrator at the University of Nancy to study the physical properties of powders whose flow modalities, which vary greatly depending on the material, have major consequences for industry. This is the case for the pharmaceutical industry, where the challenge is to guarantee an optimal mixture between the 98% of lactose and the 2% of powdered active principle found in capsules. This is also true for the agricultural sector, where the study aimed to improve the flow and transport of grains. Ultimately, 80% of materials and finished products are at some point in powder form in all industries. Moreover, 10% of the world’s energy consumption is linked to the transport, processing and handling of grains (concrete, deposits, etc.). This shows the importance of optimising industrial processes to reduce their energy consumption.

Another project benefits from GRASP’s knowhow: Spacegrains. Funded by ESA, this project is dedicated to research on powders and grains in the context of future expeditions to the moon and Mars. Lunar soil, composed of regolith (a combination of grains and dust), generates a sticky, cohesive and abrasive powder that gets stuck to astronauts’ equipment and suits - with the risk of lung problems that this entails. And the Martian soil is just as dusty. It is therefore important to understand the behaviour of grains and dust in a low-gravity environment. This should eventually facilitate the exploitation of the mining resources of iron asteroids, which are rich in rare earths. An experiment will be conducted on board the International Space Station in 2025 to better understand how to handle granular materials in the absence of gravity.
GRASP’s expertise has led to the invention of instruments for characterising soft matter. This invention led to the creation of the Granutools spin-off in 2015, with the aim of valorising these instruments in the agri-food and pharmaceutical industries. The spin-off, which has a dozen employees, has convinced Nestlé, UCB and BASF to use its instruments. This dynamism has been rewarded by the Deloitte Prize for the fastest growing company in Wallonia.
Today, GRASP is teeming with ideas to use soft materials for tomorrow’s solutions: the capture of water from the air using cloud nets to supply drinking water to villages in arid areas, the combination of elastic materials and magnetism to control their folding (imagine a stent that can be activated remotely by a magnet!), the development of centime sized robots that cooperate to perform complex tasks… A real revolution for classical engineering!

Sart Tilman, University of Liege - B-4000 Liege
Tel.: +32 (0)4 366 37 03
Email : nvandewalle@uliege.be
https://www.grasp.uliege.be

With more than 80 years’ experience in paint manufacturing, Guilmin is proud of what it has to offer: 1,500,000 liters of top-of-the-range paint produced annually, more than 150 products in continuous production and 60,000 colors available on its tinting machines.


Guilmin produces and formulates all its products on the same site, ensuring continuous management of the production chain and excellent responsiveness. What’s more, the fact that the production and formulation departments are all located on the same site means that decisions can be taken very quickly: identification of the materials needed to make new products, analysis of test samples, adoption of the final formulas and verification of their properties. With over 150 formulas available in its range, Guilmin enables its customers to configure the product that best suits their needs.
Guilmin has made a name for itself with flagship products for both indoor and outdoor use. Starting with Universaltex: this paint is highly alkali-resistant, providing long-lasting protection for surfaces. It’s ideal for decorating interior and exterior walls, whatever the material: concrete, cement plaster, brick, fiber cement, plasterboard, ceilings and much more. Another essential Guilmin solution is Unimat. This is an ideal solution for those looking for a paint with a non-glossy, very matt appearance. Its 100% acrylic dispersion formulation gives it remarkable insulating properties. It is specially designed for use on concrete and masonry, sanding and plastering, plasterboard, wallpaper, intact old paintwork, as well as other types of interior walls and ceilings. Always at the cutting edge of technology, Guilmin has recently launched its latest innovation: the Hydro-Siloxan range. This wall paint is composed of acrylic resins in aqueous dispersion and a siloxane resin. What’s in it for you? Superior performance and finishes of exceptional quality.
Guilmin’s R&D center is also currently finalizing Hydro-Prim, the primer in its new range. Another recent innovation is the new Vinimat SF eco-labelled range, a top-quality interior paint. A solvent-free paint, class 1 in washability with excellent application properties. And that’s not all: new paint ranges are currently being developed. What they have in common is that they are all eco-responsible paints. Water-based paints are favored over solvent-based paints to minimize their environmental impact. Currently, the R&D department is working on a new range of bio-based products that combines high quality with an exceptionally sustainable profile.
Including raw materials derived from vegetables in paint’s formulations allows drastic reduction in CO2 emissions giving a good Life Cycle Assessment and placing the company at the top to meet the challenge of ecological transition.
Guilmin’s commitment to eco-responsibility doesn’t stop there: the company is 100% self-sufficient in energy thanks to its 630 photovoltaic panels and its fleet of electric cars. It even reuses waste water, recycles 100% of its manufacturing waste and recovers raw materials packaging: first sorted, it is then transformed into 300 kg bales using compression machines. These bales are then supplied to other companies as part of a circular economy.
With its commitment to sustainable innovation, Guilmin is very optimistic. The company will continue to explore new growth opportunities based on its expertise and the quality of its eco-responsible products. These are all assets that are conducive to expansion into new markets. This expansion goes hand in hand with the strengthening of its twenty or so partnerships. All with the same objective: to offer paint solutions tailored to the changing needs of its customers.


Guilmin
Rue de la Plaine 5
Zoning du Wex B-6900 Marche
Tel.: +32 (0)84 21 16 45
Email: shopmarche@guilmin.be
https://www.guilmin.be/
Founded in May 2021 with three shareholders (Wallonie Entreprendre, SFPIM, Safran Aero Boosters), BeCOVER has chosen Safran Test Cells to design and build an aerodynamic compressor test center unique in Europe. Located in Liège, these new facilities of more than 3,000 m² will validate the breakthrough innovations needed to meet the major environmental challenges facing the aeronautical sector.
BeCover’s mission is to define and validate the technological solutions that will optimize the performance, efficiency and durability of tomorrow’s compressors. Its target market is both civil and military aeronautics. BeCOVER is offering its test capabilities, which will include high- and low-pressure modules with a highly versatile architecture for testing compressors under the different speed, pressure and temperature conditions to which they are subjected. In addition to these distinct configurations depending on the modules tested, BeCOVER will offer double- and triple-flow testing capacity to support the development of future compressors, in line with the EU’s objective of achieving carbon neutrality by 2050. In addition, a closed loop will enable tests to be carried out at altitude, using simulation tools that reproduce pressure conditions at an altitude of 10,000 m. Another major advantage is the presence of a 30 MW electric motor to drive the compressors. The system will be completed by 1,500 measurement lines and the use of proven data acquisition system, Cyres®, developed by Safran Test Cells.
BeCOVER draws on Safran Test Cells’ 40 years of expertise in the design of test benches to lead the project as a turn-key supplier. On an operation standpoint, BeCOVER will rely on an internal experienced team with a proven track record and a perfect command of the skills required to carry out these tests. The civil engineering of the building and the equipment have been completed. So will the installations in 2024, with the first test campaign scheduled for the second semester of that year. Next test campaigns are scheduled in the near future.


Industry will not be the only outlet for BeCOVER, which is eager to act as a catalyst to strengthen the turbomachinery ecosystem by supporting experimental research carried out by the academic and scientific world. These are very high value-added services that should stimulate Wallonia’s research potential around major projects as well as internships, doctorates and post-doctorates.
Today, BeCOVER wants to be representative of the new configurations of civil and military aircraft engines, so as to capture as many customers as possible and leave any competitors who don’t benefit from state-of-the-art facilities in their wake. At the same time, it is looking beyond the aeronautical industry and intends to offer its testing capabilities to the energy sector (industrial gas turbines, wind tunnels) and to manufacturers of drones and other flying taxis, which are expanding rapidly. One thing is certain: the demand is there, and BeCOVER will be there too!



Made up of a CoreLab at the Marie Curie Hospital and an Emergency Laboratory at André Vésale Hospital, the Charleroi CHU Clinical Biology Laboratory (CBL) carries out over 5.5 million tests a year on intra-hospital patients and ambulatory sample centres. Quality and technological innovation are at the heart of this approach.
For doctors based inside and outside of hospitals, the CBL performs all manner of analyses in the fields of biochemistry, haemostasis, haematology, immunohaematology, microbiology, infection serology and non-infection serology, molecular biology and medically assisted reproduction. Its team of a hundred multidisciplinary professionals are experts in the various techniques at the pre-analytic, analytic and post-analytic stage. The CBL also conducts clinical trials at the request of hospital clinicians, and as a secondary investigator issues the analyses specified by the lead investigators. This standardised procedure complies with the requirements of the pharmaceutical industry, in partnership with the intra-hospital Clinical Research Unit. In addition, the CBL maintains privileged contact with its prescribers through the provision of consulting services and therapeutic advice.
Faced with regulatory requirements (federal government decree on the implementation by 2020 of hospital care networks) and competition from other public and private laboratories, the CBL has established a three-way Managerial System for Quality, Strategy and Technological Innovation.

In the field of quality, the laboratory demonstrates a certain experience in its mastery of the various standards and associated requirements: ISO9001 certified since 2006, ISO15189 accredited in its main sectors of activity and sites since 2015 and operating in an institution that is now recognised and accredited by the Haute Autorite de Sante, the CBL is continuing its recognition process by being a pilot sector for the future accreditation of the medical IT sector by following the ISO27001 standard.
In the area of strategic management, the CBL has defined a vision, missions, values and a flexible strategy map and uses modern management techniques to define a guideline and its future developments. In the area of economic management, it has developed dashboards and performance indicators, including benchmarking as well as close collaboration with the hospital’s financial management unit.
More recently, in the context of the Covid-19 pandemic, the CBL was among the first laboratories to validate a home-made PCR screening technique for the virus and to be officially recognised by the federal authorities for these services. This has enabled the CBL to be a major clinical partner in the diagnosis of the disease. This development has thus made it possible to protect both the nursing staff and patients from infection by carrying out targeted screening campaigns in units at risk, such as dialysis, oncology, geriatrics, etc.
As part of its strategic development plan, the CBL continues to invest in the automation of its techniques, enabling it to process more and more samples and to meet the new expectations of its partners, patients and clinicians. Automation techniques affect all the main sectors of the CBL: clinical biochemistry, hormonology, serology, haematology, coagulation and now autoimmunity, molecular biology and microbiology. At the same time, the CBL also trains future doctors/pharmacists specialists and technologists, in partnership with the Universite Libre de Bruxelles and the Hautes Ecoles.
These different approaches finally allow the Clinical Biology Laboratory of the Charleroi University Hospital to be a major player in the regional healthcare basin and to prepare for the challenges of tomorrow.

Emails:
Laboratoire de Biologie Clinique
Hôpital Civil Marie Curie
CHU de Charleroi
Chaussée de Bruxelles 140
B-6042 Lodelinsart
Tel.: +32 (0)71 92 47 70
alexandre.athanasopoulos@humani.be (CBL Head of Service) aurelie.cino@humani.be (CBL Quality Coordinator)
https://www.humani.be/chu-charleroi-chimay/nos-services-etdisciplines-medicales/biologie-clinique/
Mitis was founded in 2012 and specialises in the development of high-speed turbines (~100,000 rpm) and integration of such systems. Its products are by nature energy efficient, clean, sustainable due to the flameless combustion they are able to deliver. Mitis aims to increase the efficiency of decentralised fuel conversion by combining heating, cooling and electricity generation.
Mitis is developing products from the ground up with its in-house simulation and modelling skills, engineering capabilities in high-precision mechanics and electronics, and performance testing capacities. The company develops both its own products (cogeneration microturbines) and participates in specialized industrial projects with select partners. For example, Mitis is currently working for ESA to develop a 120 kW UPS (uninterruptible power supply) using a hydrogen fuel cell for use at the Kourou site in French Guiana.
Mitis is best-known for its flameless combustion microturbine solution, a microcogeneration system that converts any fuel, ideally of renewable origin, into electricity and heat. The energy contained in the fuel is converted into thermal energy using its patented technology, which burns the fuel cleanly, with very low NOx emissions (nitrogen oxide, a greenhouse gas). This solution also emits less CO2 for the same amount of produced useful energy. This turbine rotates very quickly (100,000 RPM) on aerodynamic air bearings. The system is oil-free enabling very long maintenance intervals and thereby reducing the total operating cost of the machine. Furthermore, the turbine emits very little noise and can handle all types of gaseous (e.g. natural gas, biogas, propane, hydrogen, etc.) and liquid fuels (fossil and carbon neutral fuels). It is ideal for applications where heat needs to be produced while the cogenerated electricity becomes low-cost (at the price of fuel), for example: nursing homes, swimming pools, hotels, spas, multi-residential buildings, etc. It is also a useful solution for agricultural, waste water treatment sectors and even landfill applications where the microturbine can directly use biogas.
Since it was founded, Mitis has raised four rounds of financing. The latest round, launched in July 2022, raised €2.5 million with the addition of three new shareholders, including WING (Wallonie Entreprendre) and two families alongside original private and public shareholders such as NOSHAQ. This dynamism is reflected in the growth of the team, which has grown from 4 to 18 people since 2019. Mitis is also one of few Walloon companies to be awarded an Accelerator project in 2020 by the European Commission’s European Innovation Council (EIC). A further source of pride is that Mitis has been appointed to coordinate an R&D project under the Horizon Europe programme: Fit4Micro. The project, which was launched in October 2022 for a 4-year period, involves 9 European partners and has a budget of €4.5 million. It aims to develop a new generation of two-stage microturbines for liquid biofuels.

Mitis intends to have its first product on the market during 2024, the 10 kWe micro-10. This will require the development of production facilities and a network of service partners across Europe with access to local markets and installers. The company also has contacts through which it can expand into North American markets, where localised combined heat, cooling and power generation is more prevalent. A new round of fund raising is planned for launch at the end of 2025 to achieve this objective. True to its roots in R&D, Mitis will continue developing its own machines. Hydrogen fuel cells are also within Mitis’ scope and first steps in this area are through the work with ESA, following completion of that project Mitis hopes to have a clear path to expand further in the field. This diversification bodes well for the future.

MITIS SA
Rue des Chasseurs Ardennais 5 - B-4031 Angleur
Tel.: +32 (0)42 905 010 - Email: info@mitis.be
https://www.mitis.be/


What are the key figures for GreenWin?
With 220 members including over 150 businesses, the innovation cluster has given its label to 92 projects for a budget of € 304+M. GreenWin has been the coordinator of 2 European projects and is a partner in 4 others. Green- Win is split up into 9 Strategic Activity Areas covering the chemistry, construction and environmental technology sectors. GreenWin is the leader of 2 inter-cluster research themes: circular economy and carbon neutrality. Moreover, the cluster is supporting four structuring partnerships:
> RENO+ (dedicated to the deep housing renovation)
> HECO2 (aiming at decarbonating the Walloon heavy industry)
An interview with Ms Véronique GRAFF, Managing Director of the GreenWin innovation cluster
> REMIND Wallonia (for mineral ecocircularity solutions)
> BUILD4WAL: an experience center dedicated to construction & building sector’s innovations and based on the Walloon location of our partner Buildwise.
GreenWin is a member of 5 international networks. It has also concluded 4 international partnerships (not forgetting the 800 contacts of its international network) and an interregional partnership with Flanders and Brussels. Thanks to its activities, GreenWin stands at the heart of a network of businesses with a job growth rate of 23% (39% for SMEs) and an added value growth rate of 27% (73% for SMEs).
Could you present GreenWin’s industrial sectors to us?
They represent 85,000 direct jobs (26% from industrial employment)

and 160,000+ indirect jobs, and €7.8 billion in exports (15% of Walloon exports). Between 2017 and 2021, the 880 corporates of the cluster’s 3 sectors have generated 25,840+ FTE jobs.
Could you talk to us about the cluster’s strategic activity areas and themes?
GreenWin is organised into 3 main areas of activity: chemistry, construction materials and environmental technologies. In addition, the cluster deploys in 9 strategic activity areas concerning the following sectors: green chemistry, the transformation of CO2 (CCU), biotechnologies, sustainable materials, energy storage and efficiency, construction systems, recycling, soils and sediments, sewage and sludge, air and sediments. Two transversal areas (the circular and digital economy) are added to this. These various activities have openings in three application sectors: chemistry, construction and environment.
Our 2020-2025 roadmap has set up 11 priority themes we aim at developing with targets we want to reach by the end of that period. In 2022, we have already reached our target in terms of number of projects in our portfolio. Our roadmap was cogenerated with our members and was the first Walloon innovation clusters roadmap. It happens that it perfectly matches the European Green Deal that was released only few months after we unveiled our roadmap. We are now working on an even longer run strategic and technological roadmap, which will feed the public authorities with targets to be reached within between 10 to 15 years.

Could you talk to us about your members and the services that you offer them?
GreenWin members, above all a network of SMEs, large businesses, universities and colleges of higher education, Certified Research Centres (CRAs) and training centres… are among the best performing in their field and produce the most impressive results. The cluster’s businesses generate job growth of between 20 and 25%. Lastly, the cluster is made up of a network whose individual members are highly inspirational: we call them GreenWinners.
What partnerships have you developed?
More than 150 innovation partnerships have been developed in our strategic sectors. We work tirelessly on “interoperability” with other clusters, in particular in the field of the circularity of polymer production and construction building materials and processes. 4 years ago, we signed an interregional Memorandum of Understanding with our Flemish alter ego Catalisti, and this agreement has itself generated an agreement between the Walloon, Flemish and Brussels administrations to facilitate putting interregional projects together, whatever the size of the consortium partners. This was and still is an historic first in Belgium. The goal is to allow for smoother innovation opportunities and to stimulate the creation of direct and indirect jobs within the interregional projects. In 2022, we have signed a new MoU, with the highly regarded Cambridge Cleantech innovation cluster, that is endeavouring cross-Channel cooperation with both our memberships, despite BREXIT.
Could you give us a few examples of projects bearing the cluster’s label in R&D and training?
We have several success stories of which we are very proud, and here are two examples (but you can find many more on our website greenwin.be):
- REPLIC is one of the circular economy success story of GreenWin. It was focused on the development of an industrial unit for the treatment of post-consumption gypsum, with an initial capacity of 12.000T/year and capable of treating waste of various origins (recycling centres, deconstruction,…) to produce high quality gypsum. The innovative aspect of this project comes from the novel combination of mineralurgical techniques which

makes for a process that is solid and versatile. A new industrial line and a dedicated new enterprise have been inaugurated in 2020.
- MEDIX focuses on micropollutants in effluents from the hospital and pharmaceutical sector, with some success. This project led by JOHN COCKERILL Group brings together a company active in sewage treatment and one active in ecodesign, hospitals, cutting edge expertise that is the result of European projects involving some Universities and CRAs.
What do the Walloon projects BATILOOP, WaloSCRAP and Wallace consist of?
These two projects are linked to the identification of deposits of recyclable materials in Wallonia, which combine several characteristics:
> A challenge for industries given the volumes concerned;
> The characteristics that allow for the deployment of a “self-carrying” business model;
> Their capacity to generate activities and income. BATILOOP and WaloSCRAP have made it possible to build innovation partnerships in the field of recycling for plaster, flat glass, automotive glass etc.
WaloSCRAP has opened up the path to a new agreement with Wallonia, WALLACE, which aims at setting new value chains for plastic and construction building wastes and make sure they are re-used and valorised as proper resources. It is now a very important part of Circular Wallonia, the Walloon strategic plan towards a circular economy and circular industries.
As an expert in circular economy transition, GreenWin takes an active part in the implementation of Circular Wallonia, the Walloon strategy to turn our economy into a circular one.
GreenWin is also one the founding members of the RENO+ structuring programme partnership, together with the Walloon Construction Confederation (CCW) and CSTC (the Certified Research Centre dedicated to Construction & Building). It has a threefold objective:
> RENO+ is a Research-Action initiative supported by regional authorities that will facilitate the access to new technologies and the relationship between suppliers and final customers, in an organised and pre-scheduled manner.;
> ensuring the rapid start-up of concrete projects - via the pooling of skills and equipment and a direct connection between the research players and industry;
> accelerating the bringing to market of competitive industrialisable solutions, by allowing industries in Wallonia to access a regional skills pool via a platform that groups together several Approved Walloon Research Centres working in partnership on project guidance and feasibility.
Could you tell us about the LCiP project? How do you rate it as regards the Walloon SMEs involved?
LCiP (Life Cycle in Practice) was a European project, which the cluster has been a partner of. Its goal was to make life cycle analysis (LCA) accessible to SMEs. 8 Belgian SMEs have played the game and benefited as pioneers from customised tools as well as being able to take strategic decisions to adapt their business model to the LCA principles. These are businesses such as PREFER, MOBIC, PCIM, ISOHEMP, RUBBERGREEN, PUR VER, BIOWASTE RECYCLING and PAN-TERRE.
In addition, the cluster has put in place a resource centre articulated around 3 of our members: Buildwise, MATERIA NOVA and ULiège-PEPS. It is consequently perfectly possible for any interested SME to contact the cluster in order to access the services of this resource centre. Ever since, all GreenWin projects must include a LCiP before, during and at the end of their implementation.
Another European project for which we have been a coordinator is remarkable for its pioneering status and high involvement: SCOT, the number 1 European initiative in the field of capturing and using CO2, which has generated and promoted the notion of carbon neutrality and/or carbon circularity.
This project brought to the table clusters and universities from France, Germany, the Netherlands and the United Kingdom and defined the European strategic agenda in this regard. And for the continuation of this project, GreenWin has been commissioned to establish a lasting European structure carried by industry in a number of different sectors: CO2 Value Europe. SPIRE, a Public-Private Partnership between industries and the European Commission, has for that matter integrated the lessons from SCOT into its strategy and in its priority areas. This is also the case for the BBI JU (Joint Undertaking), now named CBE JU (Circular Bio-based Europe Joint Undertaking).
What calls for projects are planned for 2024 on the cluster’s themes? Two calls for projects will be organised with the projects to be submitted in March and June 2024 respectively. They always follow the same procedure: starting with handing in a letter of intent and holding an orientation meeting with the cluster’s operational team, and ending with a validation of the file with the GreenWin technical-economic panel of experts. After that comes the submission of the full project to the Walloon Government which will then
decide which of the projects will be retained for the label. Lastly the completion of the consortium agreement will open up the path to the grant agreement and project start-up.
GreenWin has produced a 2020-2025 Road Map, in which a list of 11 specific themes are added to the regular strategic fields of action. Because a goal without a plan is just a wish, eventually. More than ever, and in a very volatile global context, agility is a factor of survival and resilience. GreenWin aims at optimising all opportunities, setting up unlikely but complementary alliances, reinventing adapted actions and potential interactions to back up its Members and help them cope with the new, circumstantial challenges. GreenWin has set up a steady link with its Members and Partners, which enables to support our ecosystem. This tool will follow and back up the steady work of strategic analysis and adaptations which GreenWin already set up a while ago, leaning on an effective community that is used to cooperate and work within a collaborative innovation approach. We will of course try and help our members to cope with the impact of the energy crisis due to the war in Ukraine: business networking and energy production solutions awareness and R&D will be at the core of our actions. “Union is strength” is the Belgian national motto, and it is not a vain leitmotiv as far as GreenWin is concerned.
What activities are you developing internationally?
GreenWin takes part in international official missions organised by the Belgian government and/or the Walloon Export & Investment Agency. In 2023, our mission to Senegal and to the Baltic States enabled us to set up connections with credible local partners. We also took part in the famous POLLUTEC Lyon Trade Show, in October 2023, in which GreenWin’s skills and experience with EU funding were shared and acknowledged.

What are the main challenges that have to be overcome in the next few years by players in sustainable chemistry, materials, sustainable construction and environmental technologies?
The COVID-19 crisis and the consequences of the war in Ukraine had highlighted pre-existing challenges we knew we had to face, only with more accuracy and adding a sense of emergency to several of them. Agility, adaptability, keenness to cooperate and reconsider usual production processes will be, more than ever, key factors to be enhanced and encouraged, within our eco-system. Setting up value chains in the field of ecocircularity remains a top priority. GreenWin’s steady expertise in that matter is a plus and its contribution to the Walloon Strategic Plan Circular Wallonia is therefore even more meaningful. The challenges in our fields of action are in truth cross-disciplinary but our areas of activity are at the heart of the solutions to be developed and deployed to overcome them on a broader stage, that of society.
Chemistry is faced with a threefold challenge:
> The challenges linked to climate change;
> Vulnerability of access to resources;
> Access to energy. Limitation to access to resources and impacts of climate change will lead to the emergence of tensions and geopolitical pressures from which no one is able to escape.
The very nature of our planet is circular and finite, and the increasing rarity of resources will pose problems. Green chemistry will therefore be a crucial key to reduce these pressures and risks of tensions.
Construction for its part is faced with a twofold challenge:
> In the very short term, the digital tidal wave that is washing over the links of the production chain and its impact on the creation of new jobs, all the contours of which it is currently impossible to fully imagine, as well as on employment in this sector with the risk of crisis that this implies;
> The calling into question of business models and flexibility, which will increasingly be key factors in the industrial prosperity of the Belgian construction sectors.


There is also a need to take waste management more into consideration, both at industry and consumer level. In this respect, “cradle-to-cradle” is increasingly imposing itself as the solution but it implies the changing of the entire sector of recycling which needs to become a partner and not an adversary of “zero waste” by agreeing to call into question its mode and type of functioning according to Lavoisier’s universal principle which retains its full force today: nothing is lost, nothing is being created, everything is being transformed…
Another aspect that takes a growing importance, in a very swift manner, is the role of AI to optimise the efficiency of production processes and reduce waste (of material, time, energy…) to the maximum. GreenWin is fully embracing the Industry 5.0 targets of the European Commission on that matter, and will do so specifically through to applied AI programmes: ChiMérique (for Chemical industry) and Dig’Easy and Connect (for the Construction and Building sectors).


What are the key figures and areas of competence of CAP Construction?
CAP Construction has more than 234 members, including designers (architects, engineering offices), producers and suppliers of materials, construction contractors and system installers, developers and building managers. In order to enable our members to acquire new skills, develop their business and collaborate to anticipate tomorrow, the cluster has defined a strategic action plan with 5 objectives: to accelerate energy renovation, to promote the reduction of the sector’s environmental footprint, to support the players in the digital transition, to adapt buildings to changing needs and to increase skills while promoting business opportunities and collaborative projects.
What services do you offer to your members?
Our services are divided into 6 parts. The first part is the organisation of different types of events. The major events generally take the form of conferences followed by a cocktail party dedicated to networking: Positive Waves evenings - presentation of project leaders with business opportunities, Headlines evenings - topical subjects with debates and positioning of players, Business & Construction - macroeconomic conferences, an annual event - presentation of a speaker of international renown. In addition, the “Members” Activities, reserved for a limited number of participants in order to encourage exchanges, include the Decision-makers’ Lunch and the Afterwork (a privileged exchange with major clients, political decision-makers or leading personalities), round tables and working meetings on various themes or during the presentation of opinions representative of the sector, participation in international missions as a participant, speaker or exhibitor. CAP Construction has also set up thematic networks (energy renovation, silver economy, circular economy, wood construction, special techniques, new technologies) to enable its members to discover new market opportunities, to receive strategic information, to communicate with the other members of the network and to be consulted on opinions or actions. CAP Construction offers its members a communication platform (website, newsletter, social networks, reports, guides and articles, new markets, exemplary projects, innovative products, job offers…) and gives them the opportunity to participate in collaborative projects. Finally, the cluster proposes international actions based on its network of international partners and its collaboration with AWEX: fairs, exhibitions, congresses, visits to exemplary sites, prospecting missions, meetings with local players, etc.
Could you tell us about your main projects?
The cluster is participating in the XRFAB2Built project which explores how augmented reality and virtual reality technologies can provide

concrete answers to the problems faced by construction companies, such as increased efficiency, process optimisation and waste reduction. The XRFAB2Built project was selected as part of the Industry of the Future Programme of the Digital Wallonia digital strategy to support the digitalisation of Walloon manufacturing companies in the construction industry through the use of XR (Virtual and Augmented Reality) technologies. The project was launched in March 2023 and will run until June 2024. Another Walloon project is “Objectif Réno Copro” which started in January 2024 and aims developing and testing an integrated support service specifically for condominiums. The aim of this integrated service will be to guide co-owners and their decision-making bodies through the various procedures (administrative, financial and technical) at each stage of the project, while taking an overall view of the renovation project. The cluster was also part of INTERREG projects such as the Blockchain4prosumers project (2020-2023), which aimed to support actors in the digital transition by targeting the development of an innovative blockchain technology for a more secure, sustainable energy market and Senior Activ’ 2 (2024-2027), which goal is to provide cross-border response to home support and loss of autonomy. CAP Construction will organize discussion workshops on the implementation of the evolving/adaptable housing guidelines developed as part of the Senior Activ’ 1 project, targeting professionals in the construction sector (feedback from the field) and support the installation of “senior” street furniture in local authorities; while organizing design workshops on housing.
What is the role of innovation and new technologies in promoting sustainable construction?
Technological innovations are sources of disruption and creation of new business models; technologies such as BIM and new concepts like modular construction will encourage actors to move towards greater collaboration and integration. The green transition imposes a new mindset and a complete paradigm shift synonym of innovation for the construction value chain when focusing on the renovation wave and circular concepts applied to buildings. All these innovations are promising to save time, optimize resource use and ultimately minimize the environmental impact of construction and renovation sites.

Wallonia has a number of major assets at its disposal to ensure that eco-construction becomes the norm, rather than the exceptionAn interview with Mrs Anne-Michèle JANSSEN, Director of the Eco-construction Cluster
How is the eco-construction sector developing in Wallonia?
The context is favourable. Firstly, Wallonia has a great need to renovate its buildings to reduce energy costs and thus cut CO2 emissions. What’s more, Europe is calling for more materials with a low environmental impact to be used in construction and renovation. For example, the DNSH principle is increasingly being applied to projects funded by the European Union and the Belgian authorities. The aim of this “Do No Significant Harm” principle is to avoid investments and reforms that would cause significant harm to the environment, and to encourage investments and reforms that are in line with the European Union’s environmental policies and strategies. Finally, the prices of eco-materials, which require less energy to manufacture, have become competitive with conventional materials. Wallonia has a lot to offer in this context. To meet these needs, the region can count on around fifty producers of eco-materials (grass, cellulose or sheep’s wool insulation, hemp-lime blocks, natural paints, clay coatings, raw earth, etc.) and construction systems (CLT, timber frames, post-and-beam, mixed wood-straw systems, etc.). In addition, there are around a hundred construction companies capable of using these products and techniques. There are also around twenty eco-materials traders and distributors.

members, encourage networking and share their know-how to ultimately develop their sector. We promote eco-construction to the general public and act as a lobbyist for public authorities and conventional construction players. This year, the Eco-construction Cluster is celebrating its 20th anniversary. Two decades in the service of sensible, high-performance construction.
What kind of projects are you currently working on?
Damien Compère and Charles Carbonnelle, our two engineers, are responsible for guiding towns and cities in their construction or renovation projects. The aim is to make local authorities aware of the benefits of eco-materials and to facilitate meetings with the professionals involved. These colleagues are also carrying out a study into the potential for strengthening eco-materials sectors. Together with the Communications Department, these ingeneers are helping to draw up an exhaustive directory of building materials of plant, animal, minimally processed mineral and recycled origin. This technical database will be available on our website in 2024.
What European projects are you involved in?
Can you tell us about your members and the services you offer them?
The Eco-construction Cluster has around 270 members. 90% are companies (architects, design offices, materials producers, builders and traders) and 10% are training bodies (universities, public training centres), research centres, associations and federations. As a result, we represent the entire eco-construction chain, from design to finishing. Our role is to facilitate meetings between our

As part of the Interreg North West Europe programme, we are collaborating on the Circular Reno project. This project aims to encourage the development of 4 energy-efficient renovation solutions for collective and individual housing using bio-based materials (straw, wood, biopolymer, miscanthus). These solutions will be used to renovate 88 social housing units. To supply the materials needed for these systems, industry players in 5 countries will be involved: Belgium, the Netherlands, Ireland, France and Germany, where these techniques will then be shared and disseminated more widely.
What are the challenges that need to be overcome in order to further develop the eco-construction sector?
The main challenge is to change people’s mindsets and convince clients, architects, contractors and public authorities to favour eco-materials. One way of doing this is to train young people in the eco-construction professions. To this end, the Eco-construction Cluster is taking part in a programme of courses in the IFAPME (sandwich courses training center for small and medium-sized enterprises). The aim is to provide appropriate training for young people from the age of 15 and adults undergoing retraining. We are also urging the authorities to adapt the standards for construction products, which currently penalise eco-materials. For example, the Totem tool, which takes into account the lifecycle analysis of materials and their carbon impact, is more favourable to concrete than wood, even though wood absorbs CO2 during its growth and stores it during the use of the building.

ould you present your network and the technological skills of your members?
The cluster has been in existence for about twenty years and brings together about 130 digital players: companies, of course, but also research centres, skills centres (training organisations) as well as research and higher education players (universities and colleges). The member companies are of all sizes, from very large companies such as NRB (Network Research Belgium) and NSI IT to SMEs employing a few to a few dozen people. In 2020, these companies represented 7,000 full-time equivalents. Their technological skills are just as diversified, from first step technologies (software development, etc.) to cutting-edge technological advances in cybersecurity, via the development of CRM or ERP applications (for the initial structuring of good databases) and the integration of solutions based on artificial intelligence (AI) and the Internet of Things (IoT). Our network covers the entire value chain and the players concerned in all their diversity: innovative players, advanced technology players, players resolutely focused on exporting to Benelux, France, other European Union countries and even beyond... This diversity is a source of wealth.
How does the cluster participate in the implementation of the Digital Wallonia strategy?
We ensure the operational aspect of this strategy by getting involved in various programmes such as “Industry of the Future”. In this context, we are participating in the ChiMérique project with the Greenwin competitiveness cluster and the Plastiwin cluster: the objective is to raise awareness among green chemistry and plastics companies and to help them to jump on the bandwagon of the “Industry of the Future” thanks to the development of new digital tools adapted to their needs. Our collaboration with the Walloon clusters is also reflected in the organisation of cross-sectoral meet ings for industry in the broad sense (with MecaTech) or the Building sector: we run workshops to enable companies to express their needs and to propose appropriate digitalisation solutions. In addition, we relay the calls for projects launched within the


framework of Digital Wallonia and organise meetings between the various players to help them submit projects. For example, in this respect, we work with the CAP Construction and TWEED clusters on circular economy projects (Digital Wallonia 4 Circular).
What services do you offer to your members?
As a cluster, we are like a hub for the Walloon digital sector. We connect companies and digital players. In addition to the above-mentioned calls for projects or workshops, we offer dedicated and personalized services to connect our members with companies looking for digital partners. Moreover, we are keen to see how to make two competing companies complementary, in the field of IoT for example, and how to transform them into sources of innovation for a product or service at the intersection of their respective activities. Furthermore, we help our members grow by developing their business, by proposing collective visits to international fairs and exhibitions to make technology watch or be inspired. Finally, we offer them a showcase and put them forward to promote their companies, use case and business in Wallonia.
In your opinion, what are the major challenges in your field of expertise?
The major challenges concern both the digital sector and companies in need of digital tools (data analysis and enhancement, AI, cybersecurity, etc.) in various sectors such as construction, logistics or even industries undergoing relocation. Digital technologies have serious advantages in meeting the challenges of labour shortages, competitiveness, market changes, cost pressures, etc. Entire sectors are being transformed, encouraged to reduce their energy consumption and greenhouse gas emissions, and to produce goods and services differently at a time when customisation is booming. This transformation is closely linked to the issue of the professional skills to be acquired between now and 2030: it is important to know that 30 to 40% of professions will evolve, that others will disappear and that digital technology and AI will play a greater role. Production operators and laboratory researchers alike will have to train to stay in the race. It is therefore urgent to develop the digital skills of Walloons: specialized skills that will benefit the entire regional economy.
Founded in 2006 on the basis of a technology developed at UCLouvain, it4ip has seen its turnover grow by more than 10% per year since 2014. The company, owning a new building in the university’s science park, relies on 15 employees to manufacture nearly 200 finished and validated products. This large offer is much appreciated by the company’s 250 customers around the world.

it4ip was created thanks to track-etching, a 2 steps technology that enables the creation of uniform and well-controlled porosity in thin polymer films. In the first step, polymer films are irradiated with energetic heavy ions accelerated by the cyclotron at UCLouvain, creating linear tracks (damaged polymer) across the polymer films. The second step is a selective chemical etching to reveal the tracks into well-calibrated holes from 0.01 to 30 microns - an operation carried out in a clean room envir onment. Three types of polymer film are used, namely polycar bonate, polyester, and polyimide, which are from 6 to 50 microns thick. Various pore orientations and porous membrane colors (white, transparent, or black dyed) are available.
The it4ip manufacturing process is therefore tailor-made for a wide range of applications. As examples, the track-etched membranes can be used in gas or liquid filtration, cell and tissue culture, screening, and diagnostics tests, bioanalytics, transfusion medicine,…
Other applications lay in nanotechnology where the membranes are used as template to synthesise nano-objects made of metal, oxide, or polymer - nano-objects that can be used in sensors, catalysis, semiconductors, microfluidics, batteries,… Those niche markets have one thing in common: the need for cutting-edge technology.
it4ip, aware of these demanding requirements, develops R&D projects in collaboration with its customers who want to adapt
its standard products to their own applications. These customizations are successfully carried out thanks to the applied research expertise of the it4ip team and to the competence of its key subcontractors, pleasing new and existing customers. As an example, it4ip is currently supporting an industrial research project involving European partners in the field of PEM fuel cells containing nanowire-based cathode.
With these perspectives in mind, it4ip is intensifying its collaboration with current products distributors to strengthen its growth, particularly in the Asian and American markets. The company is frequently approached by new customers to apply its technology to more complex product shapes such as tubes. The latter, a technological challenge requiring significant adaptations, is due within less than three years, with promising applications in the biomedical sector.

it4ip S.A.
Avenue Jean-Etienne Lenoir, 1 B-1348 Louvain-la-Neuve
Tel.: +32 (0)10 226114
Email: contact@it4ip.be
https://www.it4ip.be/

What was the impact of the pandemic and subsequent crises on logistics activity?
The health crisis has demonstrated the vital importance of logistics activity for society. But while logistics chains have grown considerably over the past 40 years, they have proven to be less resilient and less agile. The general public has discovered our high level of dependence on necessities such as computer chips. More broadly, successive crises are undermining the cost-optimisation logic of geographically dispersed production of the various components that our economy so badly needs. The blockage of the Suez Canal in the spring of 2021, the war in Ukraine, tensions between the United States and Russia, the situation in Taiwan and the impact of Brexit, which has seen the reappearance of border controls: the international situation is a vivid reminder of this. This is why the resilience of the logistics business has become an absolute necessity, as has innovation, which should make a major contribution to this.
What are the key figures for Logistics in Wallonia?

If 2022 can be considered as the year of economic rebound, let’s not forget that for three years, industrial companies across all sectors have been faced with new challenges in terms of security of supply. That said, Logistics in Wallonia recorded 23 letters of intent (a record in the cluster’s history), 1 approved project and 7 projects in progress. The cluster also organised 18 networking events, bringing together nearly 650 people. In addition, the cluster now has 319 member organisations.
Could you tell us about the contract with the Walloon government and your new service offer?
This contract of objectives and means was desired by the cluster because it allows it to stabilise its activity in a multi-year framework. Its “Sustainable Logistics and Mobility” strategy, adopted in 2019, is still relevant. What is changing is the Walloon government’s desire to comply with European rules on the financing of innovation clusters: indeed, the latter must not receive more than 50% public funds, which encouraged us to seek private financing. We have therefore thoroughly reviewed our business model by significantly increasing the membership fee. In the end, we managed to retain 90% of our members. What is more, we have implemented a brand new service offer for our members in order to intensify our relationship with them. From now on, our package of services will depend on the nature of their activity, their degree of involvement in our cluster and their willingness to impact our action (by proposing certain activities for example). Thus, BOOST is dedicated to organisations with
a role in supporting the transformation of transport, logistics and mobility activities, IMPULSE is aimed at those who are mobilising in favour of this transformation, PERFORM targets those who wish to inspire the ecosystem active in this field, while SHINE is intended for those who specifically support the cluster’s activities and associate their image with that of the cluster. We are proud to have 10 SHINE members: Alstom, MG Real Estate, Deloitte, TotalEnergies, vpd, Intraco Consulting, DSV, Liege Airport, Euroterminal and AISIN. These different offers include networking services, project support, participation in the cluster’s actions, visibility and communication, access to useful information and watch, as well as support for human resources.
Could you present some of the cluster’s projects?
I’d like to start with E-ORIGIN: it aims to develop artificial intelligence to detect false customs declarations which, when considered as anomalies, can generate financial penalties of several hundred thousand euros. To remedy this, the E-ORIGIN solution is a platform that automatically collects and processes declaratory data for customs compliance. It features 4 innovative elements: AI-based fraud detection, decision support in taking corrective action, management of the risk of financial penalties, and the collection of legally binding evidence of the value and classification of goods which can therefore be used against the customs authorities. Euroterminal, UMONS and HEC Liège are involved in this project. The customs declaration thus becomes a simple formality that makes it possible to process large volumes and reduce the risk of errors and penalties. A good thing for logistics operators: they regain control over the declaration process, maintain their competitiveness and remain resilient and efficient.

The SLS project, supported by Foster and Little Health Management, is an IT tool that recalls the data necessary for the optimal management of a surgical operation. The innovation lies in the integration of all stakeholders in the surgical process and the use of AI to list all events, collate them and send alert signals when a high risk is identified in certain particular situations. Three stakeholders benefit from this solution: the patient, the nursing staff, the hospital. And also society as a whole thanks to the reduction of health costs.
The CYRUS project is led by Guardis. It aims to provide a solution to the cyber vulnerability of critical systems. A generic solution for industry 4.0, rail, automobiles, energy, water distribution… The objective is also to anticipate future regulatory frameworks which will be imposed by the European Commission. For their part, the end user will be able to respond to their customers’ requests in terms of cybersecurity. Ultimately, an independent testing center will be created to certify companies on different security standards. Companies like Alstom, project partner.

Eventually, STARS, a European project, aims to stimulate the adoption of advanced technologies by SMEs in the rail sector (AI, big data, cybersecurity, blockchain, IoT, etc.). This requires the conclusion of strategic alliances between “classic” companies and technology companies: a process that the cluster supports with targeted business and technology consulting services and hackathon-type networking. In 2022, the cluster organized a survey at European level to assess the “digital” maturity of participating companies, participated in the establishment of twelve strategic alliances and took part in the first Hackathon.
How does the cluster support its members in their transition to multimodality and the reduction of their transport-related CO2 emissions? We use the Lean & Green Europe programme to support companies wishing to draw up an action plan to reduce their CO2 emissions by at least 20% in a maximum of 5 years. The cluster


also offers an analysis of companies’ flows in order to formulate solutions to reduce their dependence on road transport. Finally, it works with municipalities wishing to invest in the optimisation of urban logistics. This is a necessity with the explosion of online commerce and the free deliveries (an abuse of language!) offered by many websites. To remain sustainable, such traffic must benefit from innovations such as cargo bikes or solutions such as Rayon 9: this small structure based in Liège employs couriers who are part of a reintegration programme, in line with the logic of the social and solidarity economy.
What are the main challenges to increasing the adaptability of logistics supply chains?
The dual digital and environmental transition concerns all sectors of activity, and of course logistics. From 2024, companies will have to carry out scope 3 reporting of their CO2 emissions generated by the volumes transported. They must prepare now. Furthermore, the fragmentation of the supply chain continues, in a period of economic contraction whose end is difficult to predict. The fact remains that the world economy remains based on international flows: we will always need transport. However, I observe a worrying phenomenon: there is a real lack of awareness of the environmental impact of online shopping. However, online commerce players could be agents of change if they reward virtuous purchasing behavior: they could, for example, offer discounts to consumers who accept longer delivery times. To be continued!


The MecaTech Cluster: a belgian pioneer in European cascade funding projects for Walloon SME’s:
The MecaTech Cluster’s international positioning
The MecaTech Cluster’s international activities are designed to increase the promotion and enhancement of Wallonia’s accredited innovations, create international partnership opportunities for the Walloon ecosystem, help Walloon operators seize funding opportunities and connect to European ecosystems.
The “Cascade Funding” principle: a ripple effect that directly benefits businesses
What is it all about? Initially, a consortium of European partners responds to a call for projects in order to receive European funding. This “Cascade Funding” has another name, “Financial Support for Third Parties (FSTP)”. In other words, the financial support is allocated to a third party organisation which will be responsible, via mini calls for projects, for redistributing these funds to local beneficiaries, such as start-ups or SMEs, who need support to develop or market their innovation.
This mechanism is well known to the MecaTech Cluster, as we were the first Belgian partner to be approved for this type of funding thanks to the IoT4Industry project (2018). The aim of this project was to promote the dissemination of IOT technologies within manufacturing industry activities. Over the course of two calls for pro posals, the project enabled 7 Proof of Concept projects to be set up, involving 15 Walloon SMEs that are members of our cluster.
The MecaTech Cluster is new partner in 2 European “cascade funding” projects



Since the end of 2022, the cluster has been heavily involved in two projects, of which it is a partner, resulting from the European Eurocluster call: DREAM and GEMSTONE. These projects also provide funding for industrial innovation projects via the “Cascade Funding” mechanism.
The DREAM project
Behind the name DREAM (Digital Resilient Europe for Advanced Manufacturing) is a consortium of European competitiveness clusters: the MecaTech Cluster in Wallonia, the French SCS cluster (Provence Alpes Côte d’Azur), MESAP (Turin, Italy), Cluj IT (Romania), and consultants from GAC (France). The aim of this Eurocluster is to accelerate the adoption of digital technologies and processes within manufacturing companies in order to make them greener, more competitive and more resilient.
The results of the DREAM call have now been announced: 12 projects involving 12 Walloon companies will benefit from European financial support, up to a third of the total funding available. Among them :
Two examples of the projects selected:
MAIN - Supported by B-SENS:

The aim of MAIN is to interface the fibre optic temperature sensing solutions developed by B-Sens with the communication and data processing standards developed by Saint Gobain, so that the technology can be massively adopted by the group to instrument its furnaces. B-Sens is a spin-off from the University of Mons specialising in fibre optic network detection solutions for the industrial sector. Saint Gobain is a world leader in glass and sustainable construction.
TRACKY - Supported by FADDTORY:
TRACKY aims to 3D print orthopaedic corsets using controlled and monitored recycled materials based on old corsets. The part incorporates information, collected digitally and transferred automatically from the materials to the 3D model. Faddtory offers advanced digital manufacturing and additive manufacturing solutions.


GEMSTONE project
GEMSTONE (“GreEen Manufacturing SupportTing recOvery and resiliency of industrial SMEs”) aims to mobilise companies, particularly innovative SMEs, around the challenges of “Green manufacturing” by developing a dedicated joint ser vice offering and operational and financial support tools based on three pillars: TRAIN, INNOVATE, EXPLORE.
This project is coordinated by a number of European clusters: CIMES cluster (Rhône-Alpes Auvergne) with Clust-ER MECH (Italy, Emilia-Romagna), Metal Processing Cluster (Poland), Green Tech Latvia (Latvia), POOL-Net (Portugal) and, of course, the MecaTech Cluster.
Throughout the project, four calls will follow one another:
- EXPLORE: to support participation in business fairs and international events
- GREEN INNOV: to support the development of new environmentally-friendly technologies and processes.
- TRAIN: to facilitate the connection between training providers and SMEs for green skills.
- GREEN ADOPT: to encourage the implementation of innovations in business processes.
The aim is to provide direct funding to support the development and adoption of technologies that promote the environment and resilience in five priority application areas: aerospace/defence, agribusiness, mobility, energy and materials. These five application areas are broadly similar to those of the MecaTech Cluster, such as sustainable energy, defence and security, the circular economy and digitalisation. The GEMSTONE project is on track. The first wave of Cascade Funding calls for projects opened on 15 June 2023 for

the first two funding rounds: TRAIN and EXPLORE. A call for INNOVATION projects has also been open since September 2023. The GEMSTONE project is scheduled to close on 31 August 2025.
Walhub accelerates the digital transformation of manufacturing companies through awareness and adoption of key technologies

WALHUB is an EDIH (European Digital Innovation Hub) located in Wallonia that supports manufacturing companies in their digital transformation. It focuses specifically on Walloon manufacturing and supply chain companies. This project is in synergy with the “Industrie Du Futur (IDF)” programme of the “Digital Wallonia” initiative, the regional public strategy in this field. The project, coordinated by AGORIA, brings together eight Walloon partners: the MecaTech and Logistics in Wallonia clusters, the SIRRIS, MULTITEL, CENAERO and CETIC research centres, and the IDELUX inter-municipal association. This EDIH is financed by the European Commission (50%) and regional co-financing (30%). A range of services are on offer, including access to technology demonstrators, Living Labs, help with access to funding, networking events between technology providers and industry, and much more. The MecaTech Cluster is responsible for “funding assistance” and “ecosystem promotion” activities (local and European). The project officially started on 1 November 2022, for a period of 3 years, renewable for 4 years after an interim evaluation.
Mecatech’s international unit offers much more:
Our International Unit facilitates our members’ access to new European funding opportunities through personalised support and contacts with support structures and/or partners and European networks. It has set up a permanent watch on European events, networks and calls for projects likely to be of interest to MecaTech Cluster member companies and research entities. Thibaud van Rooden, Sophie Schmitz and Jean-Paul de Mussy also represent the Walloon innovation ecosystem at international trade fairs and conferences, such as the Pollutec trade fair in Lyon in October 2023, the EIT Raw Materials Summit in Brussels last May, and the Hannover Messe in April. They also support the Walloon Export Agency on a number of international trade missions.
Don’t hesitate to contact our International Unit: international@polemecatech.be


HELMo Gramme is an industrial engineering school that is part of the Haute École HELMo in Liège. It trains multi-skilled industrial engineers who are in demand in production, technological R&D, sales, management, quality management, etc. The course, which is divided into two cycles over 5 years, is backed up by research into low-tech and innovation for all.


Each year, HELMo Gramme welcomes 220 students in the first year, around twenty in the ‘passerelle’ formula (which enables holders of a vocational bachelor’s degree to go on to a master’s degree) and around twenty in the IBE (Industrial & Business Engineering) programme. At the same time, the Haute École is graduating around a hundred students. To do this, it relies on a hundred or so teaching staff, i.e. around fifty full-time equivalents.
HELMo Gramme is renowned for its three master’s degrees, which are perfectly attuned to economic and social issues. The ‘Industrial Engineering’ master’s is distinguished by its versatility. Well aware of the new industrial revolution underway, the Haute École has made a point of incorporating Industry 4.0 technologies into the course: digital tools for managing production and processes.
The master’s degree in sustainable energy engineering, which has just celebrated its 10th anniversary, aims to support the ongoing environmental transition. Thanks to the expertise it has acquired in the complete analysis of a product’s life cycle (from production to recycling), HELMo Gramme has acquired a head start in processes that can reduce the environmental footprint of human activities, make energy savings and ensure more efficient energy production.
Finally, the IBE master’s degree is a double degree, developed and run in collaboration with the HEC at ULiège. It pushes versatility to the limit by tackling technical issues on the one hand, and management and economic issues on the other.
Although specialised, these three masters’ courses have one thing in common: the human training of their students. The Haute École aims to build their character, their critical thinking, their sense
of service... in a word, their soft skills. Future engineers are encouraged to grasp complexity: to decode socio-cultural issues alongside technological challenges, to sort out what is true from what is false in the scientific approach and the current context...
For several years, HELMo Gramme has been recognised as an ‘Entrepreneurial School’ by the Agency for Enterprise and Innovation (AEI). This recognition means that the school receives an annual subsidy to implement a programme of ‘entrepreneurial’ activities, ranging from the funding of certain student projects to raising awareness of entrepreneurship among teachers through appropriate training. The aim is to develop creativity and innovation so that teachers can help students to adopt ‘entrepreneurial’ attitudes in their lessons, particularly in project management.
HELMo Gramme is also active in the field of research, although this is not its primary mission. Its research unit operates on a project basis, confronting students with problems submitted to them by companies. These projects can result in the creation of prototypes or mechanical machines: wind turbines, tennis racket dryers, etc.
The Haute École is actively involved in an Interreg project that is nearing completion: Digital Twin as part of Industry 4.0. The aim of this project is to raise the level of awareness among companies in the Liège region regarding the issues of digitalisation and the digital twin. Aware that these companies are not ready to take the plunge due to a lack of data, HELMo Gramme has contributed to the development of awareness-raising modules. This is an essential first step in ensuring the digital transition of the Walloon economy.


Another emblematic research project for the Haute École is Hermatia illucens, named after a species of fly whose larvae can develop on household refuse or production waste. The aim here is to stop this development and use the larvae in the food industry. Brewery waste (hops) could be used to rear larvae so that they can be used as animal proteins, either to feed farm animals or to develop new pasta recipes. With this in mind, HELMo Gramme is contributing its expertise in the regulation of automation devices to make this production profitable.
The Haute École is also very active internationally, particularly in sub-Saharan Africa. Through the CITAC project, it has joined forces with a French engineering school, Icam, to help four African schools (2 in Cameroon, 2 in the Democratic Republic of Congo) to establish a benchmark quality system for higher education: the aim is to establish a label equivalent to the French CTI label (Commission des Titres d’Ingénieurs - Engineering Qualifications Commission) while taking account of the African context: how can quality e-learning be ensured when the electricity supply is not guaranteed? What skills framework sho uld be adopted? These are all crucial questions for this project, which is more educational than technical, enabling HELMo Gramme to deploy the full range of its expertise.
But the collaboration with Africa doesn’t stop there: as part of their end-of-studies work, some students travel to Africa to set up biodigesters in partnership with ISF (Ingénieurs sans frontières). This low-tech project is based on a simple principle: recovering the methane emitted by decomposing household waste for cooking. This allows less wood to be burnt, thereby reducing deforestation. What’s more, it’s easy for local people to understand, set up
and maintain. In the same spirit, HELMo Gramme contributes to another low-tech project: to exploit banana fibres, which have interesting mechanical properties, for non-food purposes. The project is still under consideration, but the applications already look promising.
Ultimately, collaboration is essential for the future of the Haute École. Starting with collaboration with companies, which needs to be promoted even more. To achieve this, we will no doubt need to introduce greater flexibility and simplicity into the procedures for setting up projects - procedures that are still very cumbersome at present. Company-initiated research projects would be a perfect complement to projects from the Walloon Region and the Interreg programme, not forgetting the Haute École’s own internal projects. To the great benefit of teachers and students alike.


HELMo Gramme
Campus de l’Ourthe
Quai du Condroz, 28 - B-4031 Angleur (Liège)
Tel.: +32(0)4 340 34 30 - Email: gramme@helmo.be
https://helmo.be/Profils/International/EN.aspx

Automation & Robotics (A&R) is the world leader in quality control for the ophthalmic market. Since 1985, A&R machines have been used for automatic positioning, local power inspection, mapping inspection, (pad) printing, engraving, packaging and dispatch of lenses.


Over the years, A&R has designed and produced innovative inspection devices and machines integrating disruptive, innovative and proprietary technologies in terms of hardware, software, optical configuration and calculations. The PPOS enables automatic, accurate and reliable positioning of progressive or multifocal lenses, orientation of tinted and polarized lenses, as well as shape measurement and product identification. The FOCOVISION allows accurate local power measurement by transmission; ISO compliant (FOA configuration). The DUAL LENSMAPPER (DLM) accurately measures the surface power at any point by transmission and by reflection, it rebuilds the front surface. It also provides an Error Map (difference between the theoretical and the measured map). Other A&R equipment are considered as reference in the ophthalmic market, such as the AutoMapper (automatic mapping inspection, just after the surfacing process) and the ProMapper, table-top solution gathering all latest A&R technologies. A&R Statistical Process Control (SPC) software uses the results of metrological inspection of lenses as feedback to assess the quality of production machines in order to immediately detect any drift in the process. These are fine business cards for a company built on three pillars: a clear vision of market needs; a circular, agile internal organization geared to the challenges faced by its customers; and a workforce rich in diversity, whose expertise and soft skills stimulate them to express their full potential as part of a collective intelligence approach.
A&R’s development and manufacturing activities are carried out in-house by 150 employees worldwide, the majority of whom are technicians and engineers with expertise in a wide range of technologies. Around 20 people are involved in R&D activities. A&R constantly monitors technological developments (3D printing,
AR, VR, etc.). The next challenge is the cosmetic inspection. The company is counting on its proximity to the market, the trust of its customers and its collaboration with major actors in the field to meet this challenge. A&R solution (automatic and industrial) for the full lens inspection would encompass not only the verification of geometrical and optical characteristics - metrological controlbut also cosmetic control. A prototype for testing semi-finished lenses is currently running in Latin America. The results are promising and encourage to investigate Rx lenses, field with the biggest potential. Automated cosmetic inspection will involve defining objective rules and quality thresholds, which will make it possible to link defects to errors in adjusting the manufacturing process. This proactive approach should lead to the optimization of production equipment settings and the lifespan of consumables, thereby reducing lens rejection rates. This approach demonstrates the value of A&R inspection devices and machines not only in terms of lens quality, but also in terms of sustainability.
Today, A&R is opening a new chapter in its history with an Employee Buy Out, with financial assistance from Wallonie Entreprendre. Three years after the launch of the operation, 96% of the staff are participating in the buyout. The 50% treshold will be reached by the employees within 7 years. Employees are both shareholders and intrapreneurs, aware of their impact on their environment.


Automation & Robotics
Rue des Ormes 111
B-4800 Verviers
Tel.: +32 (0)87 322 323
Email: salesmarketing@ar.be
https://www.ar.be
Founded in Brussels in 1937 and based in Louvain-la-Neuve since the 1990s, JEMA combines 40 years of expertise in magnetic products (transfomers, inductances) for railways and telecoms, 45 years in particle accelerators and 10 years in energy transition.
With a turnover that has doubled in 3 years and an order book that has multiplied by 6 in 2 years, JEMA Belgium has seen its workforce grow from 32-33 people in 2019 to 55 people in Louvain-la-Neuve, not forgetting its 25 employees in Alsace (Haguenau). It’s a cascade of good news for this specialist in power electronics and DC converters. JEMA’sexpertise is based on respect for customer requirements (its power supplies are custom-designed), the high precision and stability of its products dedicated to particle accelerators, and its ultra-fast high-power (high current, high voltage) management and control solutions for the industrial energy transition.
The technologies offered by JEMA cover high-performance AC/DC converters: precision, stability, power (current & voltage), control speed, efficiency, etc. They are aimed at two main markets. The first is particle accelerators for medical applications (cancer treatment or detection, medical sterilization) or advanced research (major international research centres). The second market is the energy transition, with applications in the electrification of industrial processes (plasma torches and plasma furnaces), energy storage (industrial batteries and industrial chargers), hydrogen production (electrolysers and pyrolysis), DC microgrids, etc.
R&D is naturally at the heart of JEMA Belgium’s activities. A small half of its staff are power electronics engineers, responsible for designing systems and supporting their production, testing and installation. In
addition to the specific needs of its customers, JEMA is looking for specific solutions to facilitate the energy transition in terms of interactions with public networks. Major industrial projects are likely to cause major disruption (in addition to the huge demand for reinforcement of these networks). The company is therefore endeavouring to design topologies that will cause as little disruption as possible, and that are best adapted so as not to slow down this transition.
As well as working with the aerospace industry (by supplying test benches to simulate, validate and test the batteries that activate the electric actuators), JEMA continues to strengthen its in-house skills through training and to push the envelope of technologies and topologies further. As part of this, the company is taking part in R&D projects with universities (UCLouvain, UMons) and other companies (Engie Laborelec, Calyos, CE+T) to limit yield losses, reduce the impact on networks for high-power systems (industrial electrification projects and hydrogen production), encourage the digitisation and industrialisation of processes, etc.
These projects offer a wealth of development opportunities for JEMA, which sees its future in both particle accelerators for the medical sector and energy transition in the broadest sense. For example, the company is being asked to design systems for producing organic fertiliser from liquid manure using renewable energy. This would solve the problem of manure disposal and avoid the need for chemical fertilisers. A virtuous circle!



JEMA Belgium
8, rue de Rodeuhaie
B-1348 Louvain-la-Neuve
Tel.: +32 (0)10 45 43 33
Email: nicolas.bronchart@jema.be
https://www.jema-power.com/

Approved and supported by the Walloon Region, Plastiwin is a network of companies that brings together players specialised in polymers and biopolymers, elastomers, composite materials and synthetic textiles.
Plastiwin has three missions. First mission: to promote business development and innovation. To do this, the cluster brings out innovative projects, supports the marketing and promotes the plastics industry. Second mission: to stimulate ideas. This involves creating a dynamic exchange between members to enable technology and skills transfers. This is key to bringing out the ideas of tomorrow and making the plastics industry more sustainable and eco-circular. Third and last mission: to inform. Plastiwin facilitates access to contractors by increasing the visibility of the value chain and by communicating the technological potential of Wallonia. The cluster also prepares the future by informing its members about technological trends and growth markets. Finally, it raises public awareness of the innovative, sustainable and circular nature of the plastics industry, which is still not well known.

It must be said that this industry weighs heavily in Belgium with more than 30,000 jobs, 14.2 billion euros in turnover and 630 million euros in investment in 2018 (according to Plastics Europe and essenscia). And there are many application markets: the packaging industry, of course (39.6% of global plastics consumption), but also the construction sector (20.4%), the automotive industry (9.6%), the electrical and electronics sector (6.2%), households, sports and leisure (4.1%), agriculture (3.4%), etc.
In this context, Plastiwin has developed a 4-step strategy: to increase the competitiveness of companies thanks to its extended network and its partnership with AWEX (organisation of meetings,

publication of promotional articles and videos on its platforms), to facilitate recruitment by developing and facilitating access to training and by relaying the job offers of its members, support businesses towards the circular economy through its involvement in Circular Wallonia (with an added value creation that could reach 488 million euros and the potential creation of 3,500 jobs) via 6 concrete actions, to strengthen the digitalisation and innovation of the plastics industry (transition to 5.0) in cooperation with all member research centres and universities. In this respect, a new collaborative project validated by the Agence du Numérique will allow Plastiwin to support its members in their digitalisation process for 2 years. The objective is to offer three types of turnkey solutions: the development of tools to identify needs and facilitate the digital transition, the establishment of a network to raise awareness through flagship events (GreenW’Innovation Challenge, Infopôle On Tour, etc.) and the personalised support of SMEs in their digitalisation process, from diagnosis to digitalisation itself. Plastiwin is also participating in the “Industry of the Future” strategy as part of the “Digital Wallonia” programme.
Plastiwin’s strategy is accompanied by three types of services. Networking is the first of these. The cluster uses its partnerships to put its members in touch with key players in the plastics industry, both locally and internationally. Participation in plenary meetings, working groups and other collective work or networking meetings within the framework of partner projects, development of a specific strategy with AWEX and EEN to ensure promotion abroad, constant monitoring of the evolution of the international market and prospecting work by participating in key events linked to the plastics industry: all these avenues are designed to increase the growth prospects of companies in the sector. The second service is consulting. Plastiwin puts its expertise at the service of companies to support their projects towards more eco-circularity (development of offers, sustainable services and partnerships in line with Wallonia’s circular economy strategy), facilitate innovation (digitization of activities, orientation towards investment aid), but also to facilitate the recruitment of new talent and training (with a dedicated working group since 2020). Storytelling is Plastiwin’s third mission. Telling the story of a company and that of the plastics industry: this is the ambition of the cluster, which wants to highlight those who today shape the plastics industry of tomorrow. There’s nothing like a great story to mobilize talent and encourage vocations!
Founded in 1999, LASEA is the European leader in ultra-short laser micromachining machines for the luxury goods, medical and energy sectors. The company owes this pioneering position to its 120 patents, divided into 30 families, and to the 15-20% of its annual income reinvested in R&D.

Having grown from 12 to 190 FTEs between 2012 and 2023, LASEA proudly boasts consolidated sales of €32m in 2022 (€40m expected by 2023) and annual growth of 30% over the past 12 years. The company has 6 sites worldwide (2 in Belgium at Liège and Mons, 2 in France, one in Switzerland and one in the United States) and exports 95% of its sales to over 26 countries.
The key to this success? Mastery of an ultra-short pulsed (USP) laser technology that produces pulses in the femtosecond range, i.e. one millionth of a billionth of a second. Developed in 2003, this automated laser-based technology does not heat up the materials being machined, such as polymers and metals, enabling a very high degree of precision to be achieved. This precision is highly sought after in LASEA’s niche sectors, which include luxury goods (components and casings for prestige watches), the medical sector (cochlear, intraocular and cardiovascular implants), energy and electronics (micro-batteries, fuel cells, etc.).
The company also supplies laser machines to the world’s most prestigious R&D centers and universities. Demanding customers include leading eyewear manufacturer EssilorLuxottica, the top 5 Swiss prestige watches, 5 of the top 10 surgical implant manufacturers in the US and Japan, two of the GAFAMs, as well as numerous universities in China, Japan, Brazil, the UK, Taiwan, Europe and the US.
LASEA is actively involved in 8 regional collaborative projects and 8 European projects. As part of the latter projects, the company is working with major clients in the aerospace, automotive and electronics industries, as well as leading universities such as the Fraunhofer Institute and the Universities of Stuttgart and Dresden in Germany, several R&D centers in Spain and France, and major players
in Belgium such as Sirris, Multitel, the CRIBC (Research Centre of the Belgian Ceramic Industry), the CRM (Metallurgical Research Centre) and ULiège. LASEA’s success rate for European projects is a remarkable 50%, well below the European average. This is a great accolade for the company, which has become a key player in everything to do with very high USP laser power, setting a world speed record in the process.
LASEA intends to consolidate this lead by maintaining its high level of creativity and innovation. Its primary ambition is to develop increasingly efficient, productive, fast, flexible and precise machines. LASEA also aims to apply its surface treatment solutions to larger components, particularly in the aerospace sector. LASEA is relying on biomimicry to design a sharkskin texture that can be applied to the leading edge of aircraft wings to make them more aerodynamic. In the same vein, there are plans to prevent ice from forming on turbines or wind turbines and to make certain surfaces hydrophobic by taking inspiration from the texture of lotus leaves. Being European leader is not enough for LASEA: the company is now aiming for world leadership in the supply of its technologies, of which laser machines are the first ambassadors. Another objective for LASEA is to increase its presence in the North American and Asian markets. Two stimulating challenges indeed!


LASEA Belgium
Liège Science Park - Rue Louis Plescia, 31 - B-4102 Seraing
Tel.: +32(0)4 365 02 43 - Email: info@lasea.com
https://www.lasea.com


An interview with Mr. Étienne POURBAIX, Managing Director of the Skywin competitiveness cluster
And Mr. Stéphane GUALANDRIS, Project Manager at Skywin

In September 2023, François Lepot (SAB) succeeded Jacques Smal as Chairman of Skywin. François Lepot, CEO of Safran Aero Boosters, has been appointed Chairman of the Skywin Wallonie competitiveness cluster. A civil engineer with a degree in electromechanics and aerospace engineering from the University of Liège, Lepot spent a year working for Cockerill-Sambre after graduation. He then devoted his entire career to one of Wallonia’s leading aerospace companies, Techspace Aero, now Safran Aero Boosters.

More specifically, the future CEO started at Herstal in the Design Office in 1993, before becoming Project Manager for the development of the CFM56-7 engine two years later, and then moving on to General Electric (US) and Snecma (France). In 1998, he became Technical Brand Manager for the General Electric and Pratt & Whitney engine programmes. In 2006, at the age of thirty-six, François Lepot was appointed Director of Operations, in charge of production, supply chain and investments. Finally, in 2019, he succeeded Yves Prete as CEO of SAB.
The Skywin cluster’s strategy has been completely overhauled for 2022. Could you tell us more about it?
Étienne Pourbaix (E.P.). In 2022, the Walloon government reviewed its relationship with the 6 regional competitiveness clusters with the implementation of a multi-year contract of objectives and means that defines five missions. This was important for two reasons: the sustainability of the cluster is guaranteed in the medium term and its activity is both formalised and clarified. The conclusion of this contract was accompanied by internal reflection within the cluster on the technical axes.
What are the 5 missions of the Skywin cluster?
E.P. The first mission is to support the government’s regional strategy by producing among others technological and strategic roadmaps for the sectors that are relevant to our cluster. We will come back to this. The second mission is innovation, based on two main areas: ensuring a technological watch for members (seminars, participation in fairs, etc.) to make them proactive, and organising two calls for projects per year in order to launch collaborative R&D projects to develop new technologies.
Third mission: to ensure the economic growth of the sectors covered by the cluster through scaling-up: this involves enabling SMEs
that have been established for 2 to 3 years with a marketable product or service and a small number of employees to move up a gear by acting on several levers simultaneously (commercial aspect, marketing, personnel management, innovation, new financial resources from the Walloon Region, etc.) We are keen to act as growth accelerators for potential future “nuggets”: we target them, define together the points to be improved and establish an appropriate action plan.
The fourth mission concerns the development of talent and training along two lines: the reduction of labour shortages in the sectors concerned and the technological innovation generated by R&D projects. Design offices should not be the only beneficiaries of these advances: it is also in the interest of industry to make use of them in their production processes.
Finally, our fifth and last mission relates to internationalization in close cooperation with AWEX. It is crucial to increase the visibility of our four sectors, which are international by definition. This requires the use of digital tools but also, and above all, in-person participation in the largest specialised trade fairs throughout the world. To conclude this subject, let us specify that each of these five missions has been broken down for each sector.



Here we go!
E.P. The Skywin cluster has identified four sectors: aeronautics, space, drones and defence. In 2022 and 2023, we have produced the roadmaps for space, civil and military aerospace as well as drones. The aeronautics sector covers aircraft structures and engines thanks to the presence of a very dense industrial fabric in Wallonia. I am of course thinking of the two world leaders, Sonaca, which manufactures the leading edges of wings, and Safran Aero Boosters, which produces 60% of the boosters for the first stage of air compressors in aircraft. But there are also a great many SMEs, active in subcontracting or in direct access with the major contractors.
Skywin has defined 5 technological axes…
E.P. Indeed. These five technological axes or DAS were determined internally, in consultation with the project managers and member companies, and then approved in December 2021 by the cluster’s board. The first axis is that of flying substructures and subsystems to provide global solutions to be integrated into an aircraft, a launcher or a satellite. It also includes new types of fuel (synthetic or hybrid fuel - combining paraffin for propulsion and electricity for air conditioning, cockpit lighting, etc. - and hydrogen), whose effects on structures are far from negligible.
The second DAS includes innovative materials and processes for the use of these materials, whether they are composite, hybrid (electronic equipment and composites using carbon fibres to make different layers of structures) or metallic (with lighter alloys). Mixed solutions are increasingly envisaged with the electrification of materials for control purposes but also to prevent the appearance of cracks or to calculate the resistance and wear of materials.
The third technological area is embedded and communicating systems, with a focus on the cyber security of systems communicating with the ground. The more intelligent and communicating the systems are, the higher the risk of cyber-attack.
The fourth axis includes the data economy and artificial intelligence: more and more satellites, drones and aircraft are generating data in real time. What remains to be done is to detect the relevant and useful information to be processed on the ground…
Finally, the fifth technological axis encompasses simulation and digital modelling (with the digital twin in particular). It is increasingly common to develop digital models before an initial prototyping. This fifth axis also aims to make the most of the very substantial physical testing facilities that we are lucky enough to have in the Walloon region. There is, of course, the Liège Space Centre (CSL), whose simulation system with vacuum tanks 6 m in diameter is used to reproduce the effect of the vacuum of space and is recognised by the ESA. I am also thinking of the cyclotron at UCLouvain, which is used to simulate the influence of cosmic radiation, which is very harmful, on satellites in orbit. And let’s not forget the private equipment, which can be used for R&D projects, such as test engine facilities from Safran in Liège to simulate the operation of aircraft engines or a large anechoic chamber from AGC Glass Europe group to simulate the electromagnetic environment and observe the reactions of antennas to electromagnetic disturbances. As you can see, we have a lot to offer!
The health crisis linked to Covid-19 brought the aeronautical sector to a sudden halt with a high risk: the erosion of R&D skills with the departure of engineers to other sectors. Following the example of the important aids granted by the French and German governments, the Walloon government launched the WINGS project in the summer of 2020 to support the regional aeronautical sector, and it is Skywin that was naturally entrusted with its implementation. I’ll let Stéphane Gualandris speak more about this.
Now that activity has resumed, we are faced with another challenge: recruiting competent and qualified personnel to compensate for the departure of many people to other sectors.
Let’s talk about the WINGS project!
Stéphane Gualandris (S.G.). This is an aerospace technological innovation partnership that was launched in the last quarter of 2020 to respond to a double challenge: the health crisis and the grounding of the Boeing 737 Max.
It brings now together 21 partners (2 additional SMEs joined the partnership):
- 3 three large companies: Safran Aero Boosters, Sonaca, Thales Belgium,
- 11 SMEs: GDTech - CAD and CAE engineering service, AnyShape - Additive Manufacturing, Calyos - Passive thermal management systems development and manufacture, Technochim - Surface treatment of metals, V2i - Vibration testing and measurement, numerical simulations, control and monitoring of NDT, MachineSight - Integration into special machines, mechatronics engineering design office, MSC Software Belgium, Rovitech - Integration of inspection solutions, DELTATEC - Development and manufacture of electronic systems, thermal, IoT, AI, Coexpair and ID Industrie & Développement, - 7 research centres: CENAERO - Aeronautical design, processes, spacecraft, buildings and smart cities, von Karman InstituteR&D fluid mechanics, CRM - Metallurgy, characterization of metallic materials, assembly, coatings, industrial processes, CETIC - Software engineering, communicating embedded systems, data science, Sirris - Composite materials, metals, modelling, digital simulation, industrial processes, Multitel - Applied photonics, signal processing, electronic prototyping, AI, Materia Nova - Polymeric Materials, Surface Coatings and design of batteries.
How is this project organized in concrete terms?
S.G. WINGS is at this time a 3,5-year project with a budget of € 115.5 million, 75% of which is public funding. This is a colossal amount if you consider that a project labelled by Skywin generally has 3 to 5 M€. This public investment is important because it allows the private partners to take risks while keeping the work of the personnel assigned to aerospace research and thus avoiding the flight of talent to other sectors of activity. The administrative steering of the project was entrusted to our cluster for the transition from phase 1 to phase 2 (a “go no go” evaluation has decided on the continuation until at least 30th April 2024 of the project by the Cabinet of Minister of Economy Willy Borsus and the Walloon

Public Service Economy, Employment, Research). This steering is done in agreement with Safran Aero Boosters, in charge of coordination. In addition, the project mobilises 285 full-time equivalents. The objective of WINGS is to enable our aerospace industry to maintain its R&D efforts at low TRL levels (2, 3 and 4) with a view to designing a low-carbon aircraft by 2035 (which implies a 30% reduction in fuel consumption per passenger) and a carbon-neutral aircraft by 2050, in accordance with the Paris agreements.
Could you tell us about the research themes of WINGS?
S.G. Six themes have been defined:
- Aerostructure, - Propulsion, - Communication systems, - Materials and processes, - Digitalization and digital simulation, - Industry 4.0.
For example, the “propulsion” theme focuses on the development of new decarbonised modes with hydrogen or sustainable alternative fuels. Similarly, the “digitalisation and digital simulation” theme focuses on virtual testing and digital continuity.
What about the future prospects for WINGS?
S.G. We are more than fourth fifths through the project, which will end in April 2024 for phase 2 of the project. The first results are already being seen, as patents have already been filed. Ultimately, we expect to have 600 to 650 deliverables and we expect to increase the TRL level of the research projects with a view to their subsequent integration into projects such as Clean Aviation, Horizon Europe or Regional projects in line with the six WINGS research themes. This is crucial to initiate R&D with a more industrial vocation for results expected by 2030-2035.


On the occasion of the Paris Air Show in June 2023, the Wings project partners communicated externally for the first time.
During the event, Minister of Economy Willy Borsus announced that he would be proposing to the Walloon government that phase 2 of WINGS project be extended by 14 months to 30 June 2025.
Twenty million euros will be made available, in addition to the 82 million already invested by Wallonia for the first two phases of WINGS.
This is a fine acknowledgement by the Region of the work done and the results achieved. 29 patents have already been filed.
Let’s come back to the “space”, “UAV” and “defence” sectors… E.P. For more than 50 years, the Walloon space sector has been an important part of the Belgian sector, which ranks 5th in Europe in terms of investment both in research and in the space industry (305 million euros a year).
The Walloon space sector includes 40 active players who generated a turnover of 300 million euros in 2022 and provides more than 2,000 direct jobs.
The “space” sector is divided into seven main areas: the ground segment; launchers and space vehicles; satellites; instruments (for Earth observation); testing of space equipment; ground-based satellite applications; space science which covers scientific missions and exploration.
In 2022, our cluster has developed a roadmap to more actively support two major space value chains:
• The Earth Observation industrial chain (bringing together more than 25 actors) including the Upstream and the Downstream Segment and cybersecurity dimensions,
• The space transportation, in its “reusable launcher” segment which brings together more than 15 actors.
Regional support and public funding will be provided from 2023 to complement important industrial investments in these two sectors.
At the same time, Research Centres and Universities will be structured through the Joint Research Institute for Space (JRI4Space) to jointly develop these fields by pooling equipment and supporting more than 30 theses.
The results of these industrial and scientific projects are expected by 2025 to place our region among the most active European Regions in the field of New Space.
The “drone” sector is not yet in a mature phase from an industrial point of view. The cause is essentially regulatory: the public authorities have not yet completely transposed the relevant European regulations into local law, which is delaying the development of the professional drone sector. For example, it is not yet allowed in Belgium to operate drones that can be flown beyond direct vision.
In the meantime, synergies should be developed between drones and satellites to cross-reference data at these two Earth observation scales.
Despite these legal and administrative issues, the drone sector is strongly growing in Wallonia. It mainly revolves around the following activities:
• Development of on-board applications, which can be closely linked to on-board applications in space;
• Development of services of all types for industry and the public sector;
• Machine design for various applications;
• Design of on-board electronics;
• Autonomous flight;
• Pilot training;
• Diversified testing facilities.
For its part, the “defence” sector has once again become an essential sector with the war in Ukraine. This situation has created a new dynamic and a renewal of the R&D projects devoted to it, some of which are supported by the European Commission. Furthermore, Skywin has concluded an agreement with the MecaTech Cluster to coordinate together this sector, whose increasingly complex weapons systems integrate land, air and UAV armaments.
The Walloon sector devoted to Defence and Security is a historical sector resulting from the metallurgical and mechanical skills acquired in the 20th century. It is still a growing sector in Wallonia. It brings together several large companies (Belgian and international) as well as an extremely dynamic network of SMEs that are constantly developing new skills.
The Defence and Security activity focuses on the following areas:
• Structures (metal and composite, shielding) for military aviation and land armored vehicles ;
• Military aircraft engines (production and MRO);
• Maintenance for military aviation (planes and helicopters);
• Complex Systems integration;
• Military drone system (sensors, secure operating systems, remote control, etc.);
• Weaponry;
• Weapon boarding system on-board air carrier (pod) or ground (turret);
• Secure communication system for military mission aircraft (Awacs, maritime patrol, etc.);
• Embedded electronic systems according to military and civil qualification.
Key figures of the Skywin cluster
- 148 members - 98 projects labelled since 2007 - 295 M€ of total project budget - for 2023: 3 new labelled projects

A research centre operated by the University of Liège, the Liège Space Centre (CSL) is employing 100 people and leading almost 60 projects for an annual turnover of €18 M. It has the advantage of being a non-profit research organisation, with a funding from industrial contracts and R&D collaborations.
Founded in 1959 as part of the Astrophysics Department of the University of Liege, the CSL owes its existence to its forerunner, the ESA, which wanted to have tests carried out and scientific optical instruments calibrated. Its reputation soon gained momentum and it became, from 1976, the chief centre for tests coordinated by the ESA. All scientific optical satellites had to undergo all their spatial qualification testing at CSL. These tests are carried out, specifically, in very large vacuum chambers that can reach up to 6.5 m in diameter, and even larger in a couple of years! All large space integrators as well as numerous instrument primes are assigning to the CSL the responsibility to fully calibrate their instrument or to support them by providing Ground Support Equipment and facili ties for the execution of qualification testing.
As a complement to these tests, the CSL designs optical instruments for use in space for ESA, NASA or JAXA with the support of BELSPO or through industrial contracts. It also develops thermal, mechanical and electronic engineering expertise in conjunction with the manufacture of these instruments. Finally, the CSL forms technological partnerships for R&D projects with Walloon and European industries as well as with other research centers. The aim of these upstream research projects is the development of technologies that can be used in space.

The CSL is involved in numerous scientific space missions, with a peculiar focus on far ultraviolet imagers for heliospheric missions and for solar wind missions: a better understanding of our sun dynamics and the propagation of sun particles is the foundation of life on earth, summarized by the so-called space weather! The CSL has indeed over the last decades developed a deep expertise in the design of sun-watching instrumentation and auroral imagers. Following the Extreme UV Imager (EUI) for Solar Orbiter, the CSL is now involved in the Vigil ESA mission, with the Coronal Ultraviolet Imager (LUCI) and the GLIDE NASA mission dedicated to the survey of the exosphere that plays an important role in Earth’s response to space weather.
Amongst the skills of the CSL, optical calibration plays an important role. From 2022 to 2024, the CSL is highly involved in the calibration of a very complex space instrument called 3MI, mounted on board MetOp Second Generation: a EUMETSAT’s, next generation of polar-orbiting satellites.
The 3MI instrument will provide a multi-spectral, multi-polarisation, and multi-angular image of the Earth outgoing radiance at the top of the atmosphere. The primary objective of the 3MI mission is to provide high quality imagery of aerosol variables for climate records, aimed at an air quality study!


Centre spatial de Liège
Université de Liège
Liège Science Park
Avenue du Pré - B-4031 Angleur
Tel.: +32 (0)4 382 46 00
Email: shabraken@uliege.be
http:// www.csl.uliege.be
Bridgestone Aircraft Tire Europe, a member of the Bridgestone Group, a global leader in tires and rubber building on its expertise to provide solutions for safe and sustainable mobility, employs 200 people in Belgium and generates annual sales of more than €100 million. The company is the market leader in commercial aviation in the Europe, Middle East and Africa region
Created more than 50 years ago, the Belgian aircraft subsidiary of Bridgestone Corporation, supplies new and retread tires for the majority of the models of commercial aircraft. Aircraft tires perform under extreme conditions, repeating takeoffs and landings, supporting and enduring the heavy weight and high speed of the aircraft. What’s more, an aircraft tire can carry a load of almost 20 tons and has to withstand a speed of 350 km/hour on take-off. In other words, it has to meet the requirements of an F1 car and civil engineering. It is therefore a highly technical tire, and its robustness must be beyond reproach. When it’s worn, it can be retreaded mulptiple times: first the casing goes through various tests such as shearography, leak detection system, then it’s buffed, reinforced by fabrics and then fitted with a new tread. Each new life allows the tire to make between 300 and 400 additional landings.
Thanks to this exemplary recyclability, Bridgestone is developing solutions to support OEMs (Airbus, Boeing, Embraer…) and airlines (Qatar Airways, Emirates, Turkish Airlines, Lufthansa, Wizzair, Ethiopian Airlines, etc.) in maximising flight safety and reducing their CO2 emissions. Developed 100% in Frameries (Belgium), the easytrack solution uses the barcodes and QR codes attached to tires to locate them throughout their life cycle, eliminating all paper-based maintenance procedures and accurately tracking each tire part, which has a unique serial number. Another solution, the result of a collaboration with Japan Airlines, is a tire wear prediction model. An algorithm designed by Bridgestone uses data communicated by the aircraft to predict when a tire will need to be demounted. This has two advantages: it avoids overstocking and flight interruptions due to lack of foresight.
Bridgestone has also developed the FOD solution for foreign object damage. This refers to any foreign object such as a main-


tenance tool, an aircraft part, etc., with all the risks for the aircraft that a tear in the tread entails. This innovation is accompanied by training courses for airlines and airports on the risks associated with FOD. It has even drawn up a map of all the world’s airports to raise their awareness, and suggests they organize anti-FOD patrols and install sensors to detect and collect those foreign objects.
Bridgestone is at the forefront of developing advanced solutions for sustainable mobility. It is working to reduce the weight of future generations of tires and the carbon footprint of tire production by taking retreadability as far as possible. Bridgestone is also working to reuse all end-of-life waste such as retread powders that can be reused under Belgian railway tracks. In addition, the Frameries plant is the Group’s pilot plant for most manufacturing innovations related to aircraft tire retreading: an ultrasound system for detecting micro-leaks, fully automatizing certain specific retreading processes, a new nitrogen curing method, an AI system to improve the reliability of non-destructive tests using shearography, the use of digital twins to model tire behaviour, etc. These are just some of the ways in which the tire life cycle can be extended and the ultimate waste pushed further and further back.
Bridgestone Aircraft Tire (Europe) SA
Route de Bavay
B-7080 Frameries
Tel.: +32 (0)65 61 11 00

Email: jean-philippe.minet@bridgestone-bae.com
https://www.bridgestone.aero


Drawing on over 40 years of experience and a unique combination of skills, expertise and cultures, Thales Alenia Space delivers cost-effective solutions for telecommunications, navigation, Earth observation, environmental management, exploration, science and orbital infrastructures. Governments and private industry alike count on Thales Alenia Space to design satellite-based systems that provide anytime, anywhere connections and positioning, monitor our planet, enhance management of its resources, and explore our Solar System and beyond.
Thales Alenia Space sees space as a new horizon, helping to build a better, more sustainable life on Earth. A joint venture between Thales (67%) and Leonardo (33%), Thales Alenia Space also teams up with Telespazio to form the parent companies’ Space Alliance, which offers a complete range of services. Thales Alenia Space posted consolidated revenues of approximately €2.15 billion in 2021 and has around 8,000 employees in 10 countries with 17 sites in Europe and a plant in the U.S.
In Belgium, Thales Alenia Space is represented by its subsidiary Thales Alenia Space in Belgium, in Charleroi, Leuven and Hasselt This Belgian company is an expert in several high-technology fields. Thales Alenia Space in Belgium is the Belgian front-runner in space electronics applications for satellites and launchers, a world leader in power conditioning and distribution for satellites, a key supplier of electronics for European launchers and will be the first automated manufactory of photovoltaic assemblies (PVA) in the Europe. Day after day, our staff of 700 offers quality products and services to our customers all over the world.
Since 1963, we have contributed to most European space programs and many international satellite launches.
Satellites are our core business…
We are a world leader in satellite power conditioning and distribution, the electric core of satellites. Our product range covers needs from observation microsatellites up to the large geo-stationary satellites for telecom applications, with power requirements from 250 W up to 20 kW. The company also enjoys a position at the forefront of flight electronics products: avionics, power supplies for plasmic propulsion thrusters, power supplies for travelling wave tubes, DC/ DC converters and other dedicated power products.

With the construction of a one-of-a-kind center of excellence in automated manufacturing, we confirm our position at the forefront of digital innovation and our ability to accompany our partners through the transformational evolution of the space industry.
Since more than 40 years, Thales Alenia Space in Belgium contributes to the European launchers adventure by providing key electronics systems for the entire Ariane family (Ariane 1 to Ariane 6).For each Ariane 5, Thales Alenia Space in Belgium has provided 50% of the on-board electronics and participates in the development of the safeguard system of Ariane 6.
From more than 15 years, Thales Alenia Space has leveraged its expertise in constellations, navigation systems, Earth observation, and orbital infrastructures to span the different New Space markets concerning the Internet of Things (IoT), search and rescue, and optical observation systems featuring high revisit rates. The digital transformation is now running in the space sector, and Europe is leading the charge for software-defined flexible satellites with all-electric propulsion for all types of satellites. Thales Alenia Space’s Space Inspire product line, featuring ultra-flexible and fully reprogrammable-in-orbit payloads, has been chosen by major telecom operators, who expect increasingly innovative and agile solutions to comply with their fast-evolving markets.
New Space also applies to space exploration, and Thales Alenia Space is at the heart of this dynamic as it has become the world leader in pressurized modules dedicated to human space exploration and to support new initiatives for a commercial use of low Earth Orbit.
After supplying more than 50% of the ISS’s pressurized modules, including the iconic Cupola, a room with a 360° view of the Earth and the station, Thales Alenia Space is developing the first 2 modules of the first commercial space station in the world (Axiom Space) which will be attached to the ISS initially for commercial operation, then detached to live its own life, when the ISS reaches the end of its life in 2028.
Thales Alenia Space will also supply three pressurized elements of the lunar space station (part of Artemis NASA program), the International Habitat I-HAB, the communication and supply module ESPRIT and the pressurized compartment of the logistics and accommodation module HALO, one of the first two elements of the lunar space station to be launched in 2023. The company is also involved in Orion.

25% of Thales Alenia Space’s revenues are reinjected into Research, Innovation and Development in order to stay at the forefront of new technologies.
Our one motto: routine quality
Day after day, some 700 employees apply a strict quality system at each stage of development, manufacturing and marketing activities, in compliance with the standards ISO 9001, EN 9100, AQAP 2110, ISO 14001 and OHSAS 18001. We are also accredited with the CMM3 certificate from the Software Engineering Institute (SEI).
Telecom satellites:
Globalstar, O3B, Iridium Next, Koresat 7, AMC12, AMC13, Apstar, Syracuse, Star One, HotBird 7, Chinasat, Express, AM11-22-33-44, Koreasat, Ciel-2, Turksat, W2A, W7, Satcom, BW, Sicral 2, Globalstar, Nilesat, Loutch, Palapa- D, Apstar 7B, Rascom, O3b, Arsat, Iridium, W6A, Artemis, Turkmenalen...
Observation, scientific and navigation satellites: COSMO-SkyMed, Sarah, GEO-KOMPSAT, Jason-CS, Euclid, Meteosat, Smart 1, Pleiades-HR, Spirale, Stereo, Galileo, Herschel, Planck, Giove-B, Myriad, Sentinel 1, 2, 3, Spot, Helios, Iso, XMM, Integral, Huygens, Soho, Jason 1, 2, 3...
Launchers and space transports: Ariane 5, Ariane 6, Vega, ATV, Expert, Colombus, ARD.

Thales Alenia Space in Belgium offers you a full range of technological skills, technical expertise, high-quality tools and services, high-performance fabrication sties and long experience in applications and equipment requiring a high level of reliability.
• A high capacity for innovation;
• High-performance production capabilities;
• 60 years’ experience;
• Member of an international group;
• The main supplier of electronics for launchers;
• Quality & flexibility.

Thales Alenia Space in Belgium
Rue Chapelle Beaussart, 101 B-6032 Mont-sur-Marchienne
Tel.: +32 (0)71 44 22 11
Email: info.belgium@thalesaleniaspace.com
http://www.thalesaleniaspace.com

What are the key figures of the TWEED cluster?
Active for 15 years, the cluster created one year ago the H2O cluster, which is complementary to our initial field of expertise: renewable energy. Our 230 members (industrialists, research centers, design offices, universities, etc.) have shown a definite interest in this crucial issue and our role, in addition to putting them in contact, is to support or participate in research and innovation projects (about a hundred to date).
Could you tell us about your priority innovation area devoted to hydrogen?
Launched in November 2022, the Belgian Hydrogen Council brings together the Belgian H2 ecosystem of TWEED (H2HubWallonia) and its Flemish counterpart, WaterstofNet. It aims to create synergy between all regional and federal initiatives on hydrogen, a key element of the Walloon, federal, European recovery plans. Furthermore, TWEED signed a Convention with Morocco to gather competences around new alcalin electrolysers projects and factories. This Council is counting on the complementarity of the players to maintain Belgium’s competitive advantage in the development of a competitive green H2 value chain. Partnerships could be created (as between Colruyt Besix and John Cockerill in HyOffWind for example) while cross-participation in the boards of TWEED and WaterstofNet is ideal for defining appropriate roadmaps with the right players in the right place. With this in mind, the Interreg EMR H2 BOOSTER project brings together Dutch, German, Flemish and Walloon partners around a common roadmap for the synergy of skills and the preparation of investment portfolios integrating proj ects such as European Corridor H2 which will link Occitanie in France to the ports of Antwerp and Rotterdam and to Germany. The aim is to propose a concerted infrastructure to be able to convert truck fleets to run on hydrogen through Europe. This axis of innovation is completed by three other axes: Energy Communities on smart grids, renewable heat and Circular Water.
Could you tell us about the SOCCER and AMORCE projects?
These two complementary projects, subsidised by the Walloon Energy Administration, are part of the Living Lab program launched two years ago. They are part of the CERACLE portfolio of 20 pilot projects and research actors working on energy communities since 2019. AMORCE focuses on the pricing of 2 pilot communities (in partnership with ULiège), their socio-economic implications beyond the financial aspect (intelligibility for individuals), the implementation
of communication protocols, the activation of the electric discharge at the right time, business plans and business models according to the typology of the buildings and networks (peer to peer sharing operations, renewable energy or citizen communities). A pilot is launched since summer 2023 in Liège (with Noshaq Invest). For its part, SOCCER aims to set up 3 social energy communities in Ans and Verviers and to measure their impact on the inhabitants of social housing who could not always afford to invest in renewable energy. The goal is to make information accessible and to raise awareness about the proper use of energy. The first pilot is running in Ans (with Municipality).
What is the DIS axis 4 “Energy-Building” of the Walloon Smart Specialisation Strategy (S3)?
This axis aims to bring together all the actors concerned and to create a portfolio of projects (and actors) in order to meet the challenges facing the energy and building sectors. Its philosophy is similar to that of TWEED: to create synergies between the differ ent projects and the different actors on specific ecosystems, i.e., CERACLE for energy communities, H2HubWallonia for hydrogen, and HEAT2NET, for district heating. With this in mind, the Cluster manages, together with the MecaTech competitiveness cluster, the 4 Strategic Innovation Initiatives (SII) of the DIS 4, part of the 19 SII supported in 2023 by the Walloon Region. Our objective is to bring these 4 SIIs to life, each with a lead partner. This implies linking the priorities of Walloon industry for the next 6 years with future research programming, funding opportunities and calls of projects. These bottom-up methodology should be based on a common roadmap encompassing energy communities, hydrogen, geothermic and heat networks, mobility and building renovation as an integrator of technological solutions, in co-construction with the other four DIS of the Walloon S3 strategy.
What do you see as the main challenges in meeting environmental and sustainable development challenges?
In terms of opportunity, Wallonia has a high potential for deep and medium geothermal capture, with an open or closed cycle. The 2022 call for projects was a great success, with 32 projects selected for an amount of €30 million. This was the trigger for the emergence of a dedicated ecosystem within TWEED for district heating, called HEAT2NET, which is based on CERACLE’s portfolio management expertise. Within HEAT2NET, support will be offered to this new emerging sector in the coming years, with a focus not only on capture techniques but also on the recovery of heat, via heating networks, governed by new legal provisions since 2023. Moreover, green gas networks, renewable hydrogen, sustainable energy sharing and management of our water are also at the heart of the short-term issues. The players involved will have to create synergies so that their solutions benefit everyone and can match the market in order to realize our ambitious target: reducing 55% of our CO2 emissions by 2030… until 100% in 2050. The opportunities are enormous and all innovations are welcome to make Wallonia and Belgium more autonomous and cleaner in energy, now!
The Centre for Applied Molecular Technologies (CTMA) at UCLouvain is an academic-clinical biotechnological platform, specialising in infectious diseases research and operations. Our focus includes the development of strategies for quickly, safely, and specifically detecting, identifying, and monitoring life-threatening pathogens, among which lethal biowarfare agents, on-site, as close to the contaminated zone as possible.
With a first prototype being created in March 2009, the current B-LiFE (Biological Light Fieldable Laboratory for Emergencies) mobile laboratory, classified as a Rapid Response Mobile Laboratory (RRML type 2) by the World Health Organization, was designed for this purpose.
CTMA’s expertise lies in deploying B-LiFE during health crises resulting from accidental, intentional, or natural releases and the spread of biological threats. Our experiences from past crises, such as the Ebola outbreak in West Africa (2014-2015), as well as recent communicable disease outbreaks like influenza and monkeypox, and the global COVID-19 pandemic, highlight the critical importance of preparedness, rapid response, and patient containment. Large-scale crises with potential cross-border implications require the swift on-site deployment of mobile analytical capabilities, strong logistical support, adherence to standard operating procedures (SOP), and coordinated responses involving national and international stakeholders. B-LiFE serves as an operational (Ops) tool to provide rapid identification and surveillance in response to requests for assistance during local or cross-border crises that overwhelm national or local capacities and ensures duplex communication with the rest of the world (host nation health authorities, national crisis centers, experts, WHO, etc.).
How to improve B-LiFE Ops capacity during public health emergencies? To improve global response capabilities, CTMA continually updates and integrates technologies into the B-LiFE Ops workflow (Fig. 1). B-LiFE functions as a technological incubator, testing and evaluating

new tools and technologies, both in-house and from third-party sources, and validating their on-site use during Ops missions. Our selection process prioritises solutions tailored to specific needs across a wide range of Ops applications, such as targeted and agnostic biothreat detection, identification, monitoring, telecommunications, and data management (including data storage, transfer, and protection). Additionally, B-LiFE serves as a platform for just-in-time training (JiTT) for local biological staff unfamiliar with on-site analytical work and the unique challenges of the Ops environment, including biosafety and biosecurity. Our multidisciplinary team works to develop procedures and methods that set “minimum standards” for other mobile capacities to follow. This objective guides our participation in DG ECHO-organized Module Exercises (MODEX) in the European Union and simulation exercises (SimEx) co-organized by WHO and the Global Outbreak Alert Response Network (GOARN) in non-EU countries. We have pursued this goal in prior European projects like FP7-EDEN and H2020-eNOTICE (Fig. 1), as well as in our current involvement in eNOTICE-2 (UCPM-2023-KAPP-PREP), MOBVEC (HORIZON-EIC-2022-PATHFINDEROPEN-01-01), and TeamUp (HORIZON-CL3-2022-DRS-01-09). One of the most significant challenges we face is the efficient, timely, and secure collection, storage, and transfer of biological and medical data. To address this, we aim for RRML tool and technology interoperability, versatility, scalability, cross-sectoral applications, harmonisation, and, whenever possible, standardisation, along with rigorous data protection procedures.

Centre for Applied Molecular Technologies (CTMA) & Biological Light Fieldable Laboratory for Emergencies (B-LiFE)
Pr Jean-Luc Gala, MD, PhD, Col. (Ret.), Director Université catholique de Louvain – UCLouvain Avenue Hippocrate 54 - Bte B1.54.01
B-1200 Woluwe-Saint-Lambert
Tel.: +32 (0)2 764 33 32
Email: jean-luc.gala@uclouvain.be
http://www.uclouvain.be/ctma.htlm
Research is what makes a university special.
But research requires an enormous amount of resources. How does UCLouvain manage to fund it?
Apart from structural public funding, our researchers have a great capacity to work together to find funding resources, through partnerships, European grants, pooling of resources between research institutes and universities, etc. This success is illustrated, for example, by the number of grants awarded to our researchers by the European Research Council.
International collaborations are also growing steadily, particularly around Circle U. As a reminder, nine European universities, including UCLouvain, have decided to share their expertise and common interests to build a European university. This is taking shape, and the European Commission, which supports this programme for networking European universities, has renewed its confidence in us. We have received a grant of 12.8 million euros to continue to develop and strengthen our project based on the mobility of students and researchers around the themes of health, democracy and the environment.

taking place on our campuses and in Brussels. For example, we were able to host a seminar on the adaptation of the agricultural sector to water scarcity, under the aegis of the FAO on the occasion of World Food Day. We organise major conferences on the university of tomorrow, on global health... Circle U, which I had the honour of chairing in 2023, allows us to be much more ambitious, to increase the number of meetings and to stimulate collaboration in many areas of research.
As well as Circle U, what other major projects are being carried out at UCLouvain?
In concrete terms, what are you doing with these additional resources?
Thanks to this funding, the Alliance will consolidate and develop the shared ecosystem. We are going to create the Open Campus, a single entry point for all the educational opportunities in Circle U. A fourth Knowledge Hub will be created and will address a new theme, in addition to the existing themes of climate, democracy and global health. The backbone of Circle U, the University Chairs programme, will be complemented by a Fellowships programme, ensuring strong, sustainable and tangible links between academics, researchers, students and partners.
We want to move up a gear and by 2030 Circle U. will be a truly integrated European university - inclusive, interdisciplinary and research-intensive - where students and staff from across Europe and beyond will work together in a shared ecosystem using common tools, procedures and infrastructure.
Are UCLouvain researchers already benefiting from this alliance?
Yes, we have a professor from our university in each of these hubs: Marnik Vanclooster, bioengineer, Olivier Standaert, assistant at the School of Communication, and Sandy Tubeuf, professor of health economics.
Since the start of the academic year, members of our university have been able to take concrete advantage of our alliance by participating in a whole series of international scientific events
Several of our researchers have received research grants. Christine Frison, a professor in the Faculty of Law at UCLouvain, has just been awarded an ERC Starting Grant from the European Research Council for a totally cross-disciplinary project involving law, biodiversity, anthropology and genetics. The aim of the project is to propose a different approach to biodiversity conservation law, at a time when biodiversity is in freefall. The project is remarkable for its cross-disciplinary dimension, its methodological approach and its willingness to serve society and, more specifically, the populations concerned by the subject of the study.
A few months ago, three of our researchers were awarded an ERC Advanced Grant that will enable them to continue their work: Thomas Pardoen and François-Xavier Standaert, both professors at the École polytechnique de Louvain (EPL), and Frédéric Laugrand, professor at the Faculty of Social Sciences. Thomas Pardoen will be able to continue his research into the strength and toughness of materials. François-Xavier Standaert will continue to study the development of cryptography and algorithms for secure communication on the Internet. This is the third consecutive grant he has received: he has already received the Starting Grant and the Consolidator Grant. This demonstrates the excellence of research in the field of cryptography at UCLouvain. Finally, Frédéric Laugrand is also working on new anthropological approaches to biodiversity.
Are there any areas of research where UCLouvain has made progress?
We have made great strides in medical research. A team of scientists from UCLouvain’s Institute of Neuroscience (IoNS), led by Prof. Bernard Hanseeuw, has been able to uncover a lead that could lead to a better diagnosis of Alzheimer’s disease, and open up the prospect of new treatments.
We also have researchers at the forefront of microbiota research. For years, the Louvain Drug Research Institute has been working to discover the secrets of our ‘second brain’. Their advances, led
by Professor Nathalie Delzenne, are of global significance. This is all the more remarkable given that in Belgium we don’t have colossal resources at our disposal. This pushes us to reinvent ourselves, to be innovative, to work as a team, to think interdisciplinary... Despite limited financial resources, our researchers are pushing back the boundaries of knowledge.
How is UCLouvain approaching the development of Artificial Intelligence? In a very pragmatic way. Artificial intelligence has received a lot of media coverage since last year with the deployment of conversational agents. But AI is constantly improving and affects a multitude of sectors: medicine, the environment, mobility, law, etc. Recently, some scientists from our Louvain4Rare consortium, which studies rare diseases, succeeded in elucidating the causes and discovering a possible treatment to combat cystinosis, a devastating genetic disease. They would never have achieved this without the help of AI.
The challenge now is to master this technology and to work on trusted AI. We are working on this through the Trusted AI Labs (TRAILS) network, a community of scientists specialising in Artificial Intelligence. One of our objectives is to educate scientists and companies about the use of AI and to make them aware of their responsibilities. We are actively working on this within our university, so that AI can be used for research and teaching.
Finally, have your researchers won any prestigious awards or nominations? There have been some prestigious awards and nominations. Prof. Debarati Guha-Sapir received the Blue Planet Prize for her research into natural disasters linked to climate change and their impact on vulnerable populations. This is the second time that one of our researchers has been awarded this prize by the Asahi Glass Foun dation.
Miikka Vikkula, Prof. of Human Genetics at UCLouvain’s Institut de Duve, has been awarded a prestigious prize by the North American Vascular Biology Organization (NAVBO) for her many contributions to understanding the genetic basis of vascular malformations. His research has led to a world first at our Saint-Luc University Hospital: the treatment of a vascular malformation in utero.
Among the prestigious appointments, astronomer Véronique Dehant, who is also head of department at the Royal Observatory of Belgium, has been named an International Fellow of the American National Academy of Sciences. She has also been appointed Grand Officer of the Order of the Crown by the King of Belgium.
In a completely different field, archaeology professor Jan Driessen has been appointed Commander of the Order of the Crown by the Belgian Ambassador to Athens, in recognition of his outstanding research work in Crete. Finally, I would also like to mention sociologist Geoffrey Pleyers, who has been elected President of the International Sociological Association.
As you can see, our researchers excel in a wide variety of fields. We are proud of this diversity, which enables us to offer high-quality teaching to the thousands of students who place their trust in us every year.










What are the key figures for the CGH?
The CGH at Cliniques universitaires SaintLuc (CUSL) is 1 of the 8 national genetic centers, (agreement by Law and endorsed by Ministery of Public Health). The Academic affiliation is established with the Faculty of Medicine, UCLouvain; 4.000 consultations /year - 3 clinical geneticists, 4 part time oncogeneticists, 4 trainees, 2 genetic counselors, 1 psychologist, 1 social nurse, 1 social worker; >14.000 tests/year - 14 board certified scientific lab supervisors - constitutional, acquired cytogenetics and molecular biology located inside the Department of Laboratory https://saintluc.be/fr/g%C3%A9n%C3%A9tiquehumaine-techniques
Could you tell us about the accredited cytogenetics and molecular genetics laboratories?

Laboratory activities are accredited ISO15189 (>10 years). Every investigation currently part of daily medical genetics is available. Concomitantly, expertise has also been developed to distinctive clinics in CUSL as geneticists and common as rare disorders specialists :
- Non-Invasive Prenatal Testing (NIPT) 1st line screening for aneuploidy/optional access to all genome CNV), QF-PCR, conventional banding and molecular karyotype; constitutional Pre /Post-natal settings
- Acquired disorders /cytogenetics investigations (blood, bone marrow, skin)
- Molecular diagnosis: MLPA /MS-MLPA (Spinal Muscular Atrophy, Beckwitt Wiedemann syndrome*), targeted sequencing: FMR1/ Fragile X; complete CFTR gene sequencing; Huntington disease, Haemochromatosis and Haemophilia*; NGS panels for liver/ cholestasis disorders*, Vascular /Capillary malformations genes*; Hydrops*, lymphedema* as tuberous sclerosis TSC1 and TSC2* genes – see list on page 2 link: https://saintluc.be/sites/default/ files/2021-05/Bon%2027G.pdf; Hypercholesterolemia NGS panel https://saintluc.be/sites/default/files/2021-02/form-5447hypercholesterolemie-familiale-2019-02-13.pdf
Pharmacogenetics* (Prof V Haufroid) https://saintluc.be/sites/ default/files/2023-05/bon-17PG-v8.pdf ; Neonatal screening (metabolic, SMA, CFTR); Constitutional oncology, Birt-Hogg-Dubé syndrome, Paraganglioma* and Pheochromocytoma* https://saintluc.be/sites/default/files/2021-05/Bon%2027OE.pdf
… as the non-selected approach: Whole Exome Sequencing.
Could you tell us about your genetic counselling activities?
In Belgium: any individual may take appointment to a genetic center /no pre requisite general practitioner prescription. Our activities are offered to 1) general population: pre conceptional “carrier screening” (national program not yet reimbursed , recessive conditions); PGD indications, work up and assisted reproductive procedures (Coordinator: Prof. Anne De Leener); Prenatal diagnosis (Yves Sznajer YS); Neonatal and Pediatric (congenital malformation, syndromic, metabolic, intellectual disability,… (Prof. Nicole Revencu (NR) and YS; 2) inside dedicated clinics with expert clinicians in: intellectual disability patients (Profs Marie-Cécile Nassogne (MCN) and NR), Epilepsy (Prof. Roberta Cilio), Capillary and vascular malformations (NR), Clefts (NR), Autism (MCN), Metabolic and mitochondrial disorders (Profs MCN, Joseph Dewulf and NR), Deafness (YS), congenital cutaneous disorders (Dr. V. Dekeuleneer and YS), cardiogenetic and heart rhythm disorders; neuromuscular reference Center (Profs P. Van den Bergh and YS), kidney diseases and nephrology (Profs K. Dahan and Eric Olinger), constitutional bone disorders (NR), Haematology and Haemophilia (Prof. C. Hermans), acquired haematology disorders (Profs V. Havelange, M.-C. Vekemans, E. Vandenneste and P. Saussoy), neurology and neurodegenerative disorders - Alzheimer diseases and dementia (Profs Bernard Hanseeuw, Adrian Ivanoiu and Anne De Leener), and the complete range of indication and follow-up in Oncogenetics: “at-risk clinic” for breast/ovarian cancer (Prof. François Duhoux and Anne De Leener), digestive tract (Dr. Astrid Decuyper) or prostate (Dr Guillaume Grisay). A true bridge is thus built with the Oncology Department and Molecular Tumor board lead and coordinated by Prof. Jean-Pascal Machiels.
*We receive samples from all over Europe/North Africa.
Cliniques Universitaires Saint-Luc Genetic Center
Avenue Hippocrate 10 - B-1200 Bruxelles
Tel.: +32 (0)2 764 67 74
Email: secretariat-gmed-saintluc@saintluc.uclouvain.be https://www.saintluc.be/fr/genetique-humaine-presentation
Affiliated to the Faculty of Medicine at UCLouvain university, CGH has built gateways to research Institutes inside the campus as national/ European and/or internationally. Scientific collaboration (case patient description and/or DNA transfer) is completed from clinics to science and reverse, to possibly obtain/increase evidence or to reach a diagnosis.
Gateway 1: the internationally renowned The “De Duve Institute”: 33 research groups (cancer; genetics; infection and inflammation; metabolism/hormones; biology). CGH took advantage from the pioneer research discoveries of Prof. Miika Vikkula’s lab: from original identification of genes causal for capillary and vascular malformations (pathway to therapy) as for lymphedema and clefts. Prof. Nicole Revencu (NR) is the clinical geneticist at CGH that represents the perfect example of link from clinic to research. She originally identified RASA1 gene (PhD) in M. Vikkula’s lab. For >10 years, she guarantees genetic counseling for patients from all over the world coming to her clinic with Prof. L. Boon; she is promotor of PhD students and Prof. of Genetic at the Faculty of Medicine. Of note also inside De Duve Institute, Prof. E. Van Schaftingen’s outstanding work on metabolic disorders, which legacy presently handed over by Prof. Joseph Dewulf.
Gateway 2: “IONS” (Institute for Neurosciences): 240 members a.o. Prof. Bernard Hanseeuw (Alzheimer’s disease and dementiafunctional to neuroimaging), Prof. Stefan Constantinescu (Haematology), Prof. Jean-Baptiste Dumoulin (immunology and bone), Prof. Anabelle De Cottignies (Epigenetics), Prof. Nisha Limaye (immunology and autoimmune diseases).
Gateway 3: the “Institut de Recherche Expérimentale et Clinique” (IREC). > 500 clinicians and scientists converge to unravel disease mechanisms and pioneer novel therapies. Clinical in vestigators, fundamental scientists, technical experts and the Clinical Trial Center collaborate seamlessly with Cliniques Uni versitaires SaintLuc (CUSL). Investigations are completed from regenerative medicine to cardiovascular diseases, from cancers to orphan diseases, spanning diagnostics to patient care. This unique environment nurtures exploration and innovation. Our mission is resolute to forge collaborative knowledge in the fight against diseases. IREC website: https://uclouvain.be/fr/instituts-recherche/irec Discover the institute on this video: https://youtu.be/fkG8OLSbt3c
Gateway 4: As 80% of rare diseases are of genetic origin, an additional natural link exists with ‘The Institute for Rare Diseases’ (IMR). http://www.institutdesmaladiesrares.be/ Created within the Saint-Luc Academic Hospital in 2014, ‘IMR’ includes > 350 healthcare professionals / 28 expert centers among which 15 are leaders or collaborators of European Reference Networks (ERNs) establishing diagnosis and define the personalized treatment for >17,000 patients. This level of activity makes CUSL the leading center for rare diseases in the French-speaking Community (Belgium) as one of the most active in Europe. Yves Sznajer is the leader (full member - consortium) inside ERN ITHACA for CUSL-IPG, Prof. I. Maystadt et al. ERNs allowed for collaboration (larger cohort size, more precise description, promoting R&D from diagnosis to research and conversely). The IMR is also part

of the “Louvain4Rare” platform (which promotes collaboration between experts of the UCLouvain to address medical, scientific, ethical, legal and socio-economic aspects (ELSI) of rare diseases in Belgium).
Gateway 5: Prof. Yves Sznajer (YS) expertise extends also to phenotype descriptions in Noonan syndrome patients and from molecular biology findings merging inside a common pathway “RASopathy”. International consortium work in progress is on updating “Dyscern” guidelines: YS is the leader of the workgroup on neurology and behaviour.
Gateway 6: Expertise is available for tuberous sclerosis (TSC) since CGH lab is sequencing TSC1 and TSC2 genes since 1994. YS is part of the panel of experts for Belgian TSC patients’ association (‘BeTSC’) and guarantee gateways with Anna Jansen (UZAntwerp) and Prof. Mark Nellist (The Netherlands) a.o. to enable further evidence based on gene expression as for the dedicated patients organization (TSC Alliance,…).
Gateway 7: CGH participates in the national pilot study, BesolveRD (whole genome sequencing) coordinated by Prof. Joris Vermeesch (KULeuven): a clinical trial to possibly identify the cause in patients with intellectual disability.
Do not hesitate to contact us for further discussion and/or interaction E mail: secretariat-gmed-saintluc@saintluc.uclouvain.be




The UMONS ENERGY Institute is dedicated to research and development activities related to energy issues. This multidisciplinary theme covers scientific, technological, societal, legislative, economic and political aspects. It therefore requires an integrated approach from a number of disciplines. The Institute draws on the expertise of 125 researchers and more than 30 PhD students, who are involved in 150 annual publications and 50 ongoing projects.

The challenges of the ecological transition are such that medium- and long-term political plans are being drawn up. Such political objectives require new developments in all sectors of society. The issue requires an integrated approach from a number of disciplines and a vision covering different time scales.
Within UMONS, the ENERGY Institute is the organisational structure concerned with research and development activities in this area. Its activities are based on its members’ skills in the fields of science, applied science, economics, architecture and urban planning. The Institute’s mission? To support these different areas of R&D with the societal objective of helping to build the energy system of the future.
The Institute’s activities cover the synthesis and characterisation of active materials for energy applications, phenomenological studies (experimental and simulation), technological prototyping, energy monitoring and the development of simulation tools, in the following areas:
• Biofuels and combustion: New combustion techniques, environmental impact, production of biofuels from micro-algae.
• Capture and sequestration of CO2: Purification and capture of CO2 in post-combustion, storage of CO2, electrofuel production.
• Photovoltaic technologies: Development of new generations of photovoltaic cells.
• Energy communities: Zero energy and positive energy buildings, alternative technologies for heat and cold production and their integration in buildings.
• Energy storage: Geological storage of solar thermal energy, inter-seasonal heat storage by thermochemical reactions.
• Materials and processes for energy applications: Materials for the transportation of electrical energy, optimisation of industrial processes, heat recovery.
• Wind energy: Assessment of wind potential, optimisation of wind turbine blade profiles, acoustic and vibration aspects.
• Smart grids: Impact of decentralisation of electricity generation on distribution networks, electricity supply and demand management, IT security for data transfers.
• Geothermal energy: Characterisation of geothermal resources, heat networks.

The Institute develops its activities primarily through collaborative research projects. These research projects are based on interdisciplinarity and prioritise collaborative research and co-development. They are based on a partnership approach with all players in society (industry, services, research centres, local authorities, government institutions, etc.). These projects enable partnerships to be forged at provincial, regional, federal, European and broader international levels.

Here are a few examples of the ENERGY Institute’s projects:
Led by UMONS, the project portfolio of the Centre of Excellence in Energy Efficiency and Sustainable Development aims to create research infrastructures that will be able to create ecosystems favouring innovation, as well as carry out integrated, economic-focused research projects and generic studies.
The “Wal-e-Cities” project aims to develop an ecosystem of smart cities in Wallonia, in line with the Smart Region philosophy, in terms of mobility, energy and the environment, governance and living environment. The institute is involved in the energy part of the portfolio with the general objective of proposing innovative solutions for heat production and storage systems for heating buildings, particularly on a neighbourhood scale. The proposed solutions must allow a renewable contribution to the coverage of heat needs.
The MOF4AIR project, for which UMONS is the coordinator, aims to develop and demonstrate the performance of CO 2 capture technologies by adsorption based on the use of “Metal-Organic-Frameworks (MOFs)” in power plants and energy-intensive industries. MOF4AIR should provide reliable and reproducible TRL-6 technology that meets the needs of end-users, notably by limiting energy penalties by more than 10%.
The POPE project aims to develop and evaluate a high-fidelity but low-cost modelling chain which, based on weather data and the characteristics of a wind farm site (including surrounding obstacles), can provide the operational characterisation (in terms of power and forces on the blades) of a given machine installed there.
This project will study and develop innovative aspects of Belgian offshore wind generation: provision of grid support services (e.g., participation in frequency regulation), stability of grids with a high proportion of wind energy, longevity estimation and predictive maintenance of offshore wind fields. To this end, physical and data-driven models will be developed using data collected from Belgian offshore wind farms.
Development and implementation of energy system models to support a realistic, sustainable and cost-effective energy future in Belgium while ensuring security of supply. The time horizon of the developed models is 2030 and 2050, the parameters and results of the models will be discussed and validated by a wide and consistent range of Belgian stakeholders.
The objectives of the MOREGEO project, which is part of the “energy distribution” project portfolio for which IDEA is lead partner, are to increase the knowledge of the deep geothermal reservoir in the Heart of Hainaut region and, based on this, develop a model to promote the adequate and sustainable development of the deep geothermal resource in this territory.
E-Cloud aims to develop and optimise open microgrids in industrial areas. These will allow different companies located in the same area to invest together in renewable energy production and storage capacities and to share the electricity produced in an optimal way by optimising interactions with the grid and the markets.
More information about the ENERGY Institute: https://web.umons.ac.be/energie/en/


At the Heart of Europe: an exceptional setting
Namur, the capital city of Wallonia, is a lively and multicultural city of around 110,000 inhabitants. It is Wallonia’s most accessible city located at the intersection of a large rail and road network and near three international airports. Namur sits at the confluence of the Meuse and the Sambre Rivers and is dominated by a 17th century citadel built by the famous military architect Vauban.
The university campus is a vibrant place only a ten-minute walk from the train station, ideally located next to the city’s pedestrian zone and high street with easy access to shops, restaurants, and cultural venues.

The University of Namur’s mission is to help its students to become responsible members of society. It encourages extra-curricular activities and social, humanist and civic projects that contribute to the development of a democratic, multi-cultural and supportive society.
The University of Namur promotes scientific research which combines excellence with a truly long-term vision. It encourages interdisciplinary approaches and a thorough comprehension of the human and social implications of science and technology.
The University also engages with society. The University of Namur aims to sow the seeds of the cultural, social, political and economic development of the region it is part of. It confronts and evaluates major social problems, especially those associated with inequality.
Meaning and a focus on the human person are the guiding principles at UNamur in order to give human-centered and ethical teaching. The students are trained to take responsibility. The commitment of the professors to their teaching role is a priority, hence, the students are central to their concerns.
With 40 different programs at the Bachelor, Master and Doctorate levels, the UNamur welcomes over 4,900 students in six Faculties: Arts, Law, Economics, Social Sciences and Business Administration, Computer Science, Medicine and Sciences. Its reputation is based on the quality of its education, the availability of its professors and sufficient resources to ensure maximum chances of success for each student: introduction to study techniques, preparation courses, small group work, course materials available on-line, personalized assessments…
The UNamur has redesigned its study programs in line with the European harmonization of Higher Education (“Bologna Process”). The UNamur has widened the choice of its studies to reconcile both specificity and openness to social and human issues. Quality of study in Namur is a first-class advantage for those who wish to discover a university on a human scale at the crossroads of Europe, as part of a study exchange program or to prepare to enter professional life.
The number of international exchange students hosted in Namur continues to rise. Most of these students come from our European partner universities but an increasing number of non-European students now choose the University of Namur as their destination.
Foreign students enrolled in an exchange programme can stay at the International House with our other international students, or share flats with Belgian students. Living and studying together facilitates the integration of the students and helps them to improve their French and other language skills.
In order to facilitate the integration of its international students, the University of Namur offers an intensive two-week programme to help students improve their French and English language skills. They get the opportunity to discover Belgium, Namur and the campus. These orientation weeks are organized before the beginning of each academic year in collaboration with Namur’s various post-secondary institutions, and are very popular.
Since 1989, UNamur students have been encouraged to take part in exchange programmes. At first, only a small number of partner universities were available as exchange destinations. But, over the years, the number of partners has increased considerably and now
includes a number of non-European destinations. Students can spend a term abroad to study in a partner university or take part in an internship, either in the private sector or in a research laboratory of prestigious universities, such as Harvard University, the University of California, Texas A&M, the University of Montréal…
Since 2015, the Erasmus+ International Credit Mobility Programme allows European HEIs to set up mobility agreements with partners from around the world that concern both students and staff members. Thanks to this programme, the UNamur has developed 20 new partnerships with Asian, African and Latin American universities and has organized many teaching and research missions. The University of Namur has received the European Commission “Good Practices” label.

Value-based research: interdisciplinarity as UNamur DNA in research
The mission of every university is, not only to diffuse knowledge, but also produce new knowledge, which requires providing an essential place for research. Our laboratories and research institutes aim to develop quality projects, by resolutely joining collaboration networks at the national and international levels. Whether this research is fundamental or more oriented, it is “meticulous in taking into account the human and social dimensions of science and technology”. Research in Namur aims at balancing ethics and excellence with an internationally recognized strength: the interdisciplinarity. The UNamur research institutes bring together and interweave various skills and expertise around a global topic. This way of functioning favors transdisciplinary collaboration and original approaches for research as well as for teaching. These research institutes are centers of excellence in their fields of expertise, including Energy and the Environment, Materials, Social Sciences and Humanities, Life Sciences and ICT.
Within the 11 transdisciplinary research institutes and the 7 faculties of the UNamur, the researchers develop their projects with numerous

other research teams coming from the 5 continents. Furthermore, UNamur is committed to international development cooperation. This is exemplified by the various research projects deployed with countries from the South.
In 2022, there have been 1089 publications, more than 1000 researchers, with a budget of more than 21 million euros for the newly financed research contracts. Five sectors of excellence have been delineated: Life sciences and health; Society, transition and digital; Heritage, culture and societies; social and economic vulnerabilities; Materials. These five themes gather outstanding researchers and lead the visibility of UNamur for all the research stakeholders, being partner universities and research centers as well as funding bodies.
The University of Namur invests in state-of-the-art equipment grouped in nine transverse technology platforms. These platforms are open to all researchers and to companies willing to perform measures or analyses and benefit from the skills of specific experts.
In November 2022, the University of Namur has become an official member of UNIVERSEH European University: “European Space University for Earth and Humanity”. UNIVERSEH is an alliance of seven young and mature universities from five European countries. It aims to create new higher education interactive experiences for the university community, teachers and students, and for the benefit of society as a whole. Such initiatives will enable broadminded, informed and conscientious European citizens to capture and create new knowledge and become smart actors of European innovation, valorisation and societal dissemination within the Space sector, from science, engineering, liberal arts to culture.

The UNIVERSEH partners are committed to securing new approaches for Teaching & Learning in an evolving world where knowledge and its transmission have never been so difficult to streamline to learners. Student-centered learning, peer-to-peer and collaborative teaching designs will be the cornerstone of UNIVERSEH educational endeavour. It comprises in-person, distance and blended learning within UNIVERSEH collaborative campus, including students’, teachers’ and researchers’ thematic and cultural European mobility. Innovative pedagogical approaches, interdisciplinary and cross-sectoral curricula are key components of our educational approach.
UNIVERSEH relies on a wide range of expertise and already acquired extensive contacts with the space industry and European Space Institutes to rapidly adapt and implement the most relevant Teaching & Learning environment to cover European needs in the area of Space.
UNIVERSEH has been awarded a second 4-year grant from the Erasmus+ programme in July 2023.
The SPACE researchers have an astronomical observatory at their disposal with state-of-the-art instruments such as a large-diameter solar telescope, unique in Wallonia, which allows the sun to be observed safely during the day, giant telescopes for visual observation, and a high-magnification telescope for observing the moon and stars at night.
The Namur institute for Complex Systems (naXys) mentioned above is home to a research pole (pôle de recherche) called ‘SPACE’. The SPACE researchers deal with the modelling of the Universe, on different scales: space debris, Solar System, extrasolar systems, up to the large-scale structures of the Universe. They focus on the non-linear interactions and chaotic dynamics of these physical and

mathematical objects, sharing the tools of celestial mechanics, cosmology, general relativity and modified gravity. Well-integrated into international networks, the SPACE researchers beyond any doubt have the potential to contribute in a complementary way to the further development of space-related research activities of the UNIVERSEH alliance.
Researchers active in both ILEE and NARILIS obtained ESA-funding for their project “Rotifers In SpacE” that aims at understanding how these very small animals can sustain different kinds of stresses such as dryness and high levels of radiations. They appear to be a suitable model system to study the impact of microgravity and ionizing radiation on living organisms in order to develop adequate solutions to the challenges space travelers face or will face in the future. For this purpose, the University of Namur, in collaboration with SCK-CEN (the Belgian nuclear research centre), has launched rotifers into two missions within the International Space Station. The results are still under investigation.
Even though the links with the space-topic might at first sight not be all that apparent, significant contributions to the alliance can also be made by UNamur researchers active in NISM (e.g. by the scientists who work on the development of new types of batteries and of new 2D and 3D coatings as well as nanomaterials with new properties that can be applied in different contexts), in NARILIS (e.g. by the scientists who seek to advance our understanding of the biological effects of radiations at molecular, cellular and whole organism levels), and by scientists active in the Espace philosophique namurois (ESPHIN). Typical of ESPHIN is that it unites natural scientists, life scientists and philosophers who not only deal with research ethics from an interdisciplinary point of view, but also focus on robotics from the point of view of philosophy and science and - not so long ago - were involved in an inter-university project on the life and work of Georges Lemaître, the Belgian physicist and priest known for his contribution to the Big Bang theory.
https://www.unamur.be/en
With nearly 200 members, some twenty scientific publications, 600 requests from project leaders and some twenty projects monitored, Valbiom is actively contributing to the development of biomass production and processing sectors for non-food applications in Wallonia.

Valbiom’s mission is to valorise the biomass and its co-products and by-products for a more local and resilient economy. Specialised for 20 years in biosourced economy at the service of territories, municipalities, services of the Walloon Region, project promoters and industrialists, Valbiom combines scientific, technical and economic skills to guarantee a tailor-made response and a professional quality of service. It is responsible for innovative sector strategies integrated with global issues, prospecting and project support. For example, Valbiom can advise a territory on the merits of developing a biomethane production chain. Valbiom is also very active in training, information, awareness raising, technical monitoring and networking. This is evidenced by the 20 or so events per year (thematic conferences, field visits, including the tour of the biosourced economy and biomethanisation) and the 50 requests to speak as an expert at conferences and debates.
Approved for many years by the Walloon Region as a consultancy for UREBA and AMURE grants, Valbiom offers services to define a strategy, the elaboration of master plans and methods to reduce the energy and climate impact of a company, a district, a municipality or a city (POLLEC). A complete service is offered for the implementation of bioenergy solutions: diagnosis, territorial study, animation of local actors’ networks, elaboration of a master plan, supply plan, elaboration of a spreading plan, agronomic advice, technical and economic feasibility study, environmental assessment of a project (carbon assessment, life cycle analysis), administrative support, assistance to the financial set-up and communication plan are combined so that the project owner puts all the chances on his side.

At present, Valbiom is involved in many projects of the Walloon Recovery Plan, which concern in particular the development of the extraction of molecules of interest from plant materials (wood bark, hemp inflorescence, etc.), the wool industry, oleochemistry or the development of the biogas production industry. Special mention to the European project Hemp4Circularity (Interreg NWE): it aims to implement an innovative, local and biobased ecological fibre - long hemp fibre - in the textile value chain of North West Europe, from growers to weavers/ knitters, from field to designers, and recycling. It is implementing pilot actions at several stages of the value chain (cultivation, primary processing, data-driven agriculture, spinning, fabric production) to optimize all stages of sustainable production, from field to recycled fibre. In doing so, hemp becomes a driver of circularity in the textile industry.
Valbiom is well placed to know that the biobased economy allows the relocation of production and transformation channels since biomass grows everywhere and offers interesting alternatives such as wood wool or hemp for insulation. Moreover, the biobased economy is less energy intensive and facilitates CO2 capture. Its future is all the more promising as Wallonia benefits from all the necessary expertise: a long agricultural and forestry tradition, important research and training centres... not to mention the entrepreneurial spirit. A dynamic that Valbiom intends to support and stimulate.

Valbiom
Chaussée de Namur, 43 B-5030 Gembloux
Tel. : +32 (0)81 84 58 87
Email : info@valbiom.be
https://www.valbiom.be/

This team of LLS specialises in high-resolution molecular spectroscopy for the study of gas mixtures, including atmospheric pollutants. The team’s objectives are to understand the interactions within gas mixtures and to carry out applied research.
Three complementary approaches contribute to achieving the LLS objectives: experimental (measurements with cutting-edge instruments), theoretical (simulation with state-of-the-art models), and technological (development, co-development of instruments). As the importance of environmental issues grows, the ‘Atmospheric Pollutants’ team has been contributing its long-standing expertise in high-resolution molecular spectroscopy to atmospheric studies. The quantification of pollutants in the atmosphere can be deduced from atmospheric spectra recorded by instruments on various platforms (ground, satellite, stratospheric balloons, ...). The analysis of these spectra, based on state-of-the-art physico-chemical models that require an accurate knowledge of spectroscopic parameters previously determined in the lab, allows to determine the pollutant concentrations and their spatiotemporal evolutions. The ‘Atmospheric Pollutants’ team uses its technological, experimental and theoretical expertise, and the complementarity of these approaches, to determine accurate spectroscopic parameters in support of atmospheric studies. These parameters are needed for Earth’s atmospheric pollutant concentration retrievals, residual gases of combustion study, and remote sensing of extraterrestrial atmospheres (planets, exoplanets, stars, etc.).

studies focus on small hydrocarbons (such as acetylene) produced by diesel engines, the absorption spectrum of water vapour to clarify its role in the atmosphere (to prepare specific satellite missions) and nitrous oxide, relevant in the issue of nitrogen fertilizers.
The Lepère’s team’s expertise in spectroscopic studies of gases with great atmospheric interests explains its long-standing collaboration with the Royal Belgian Institute for Space Aeronomy (BIRA-IASB). This collaboration takes several forms: joint participation in international projects such as an ESA project on methane, and thesis co-supervisions, e.g., one on the characterization of Mars’ atmosphere to find out whether the planet could host life, and others on Venus’ atmosphere to prepare a future space mission that will use VenSpec-H instrument developed by BIRA-IASB. In addition, after a postdoctoral stay in the USA, Dr B. Vispoel, a former PhD student of Prof. Dr M. Lepère, carried out a second postdoctoral stay at BIRA-IASB. He is now developing his expertise at the LLS. Finally, Prof. Dr. A. C. Vandaele (IASB) has given since many years a lecture devoted to the sounding and the physics of atmospheres for Master’s students at UNamur.
The LLS ‘Atmospheric Pollutants’ team is involved in numerous ongoing research projects. These include the study of methane under specific atmospheric (terrestrial, planetary) pressure and temperature conditions. Methane is diluted in various gases such as N2, CO2 or H2O. Other

Today, the LLS ‘Atmospheric Pollutants’ team considers the increased performance of atmospheric sensing instruments and atmospheric models. Laboratory measurements and calculations of spectroscopic parameters must achieve the accuracy required for future space missions. Other challenges include the lab study of new gas mixtures relevant for terrestrial and extra-terrestrial atmospheres and exploring extreme pressures and temperatures. Together, all these research efforts carried out by several teams in the world will improve the understanding of atmospheres and better predict the evolution of our atmosphere.




IRis-F1, designed by the Swiss company IRsweep AG, is the next generation of fast, broadband, high-resolution dual comb spectrometers. Here’s a look back at a technological breakthrough and a predicted success.

In 2005 the Nobel Prize in Physics was awarded for the contributions to the quantum theory of optical coherence and to the development of laser-based precision spectroscopy, including the optical frequency comb technique. Some years later, Prof. Dr Jérôme Faist at ETH-Zurich followed suit by leading a PhD thesis on the development of a dual comb spectrometer based on quantum cascade lasers. This was the first of its kind operating in the mid-infrared, one of the most interesting areas of the electromagnetic spectrum for studying the atmosphere and for many other applications, but also very challenging from the technological point of view. Ultimately, the PhD thesis of Dr Andreas Hugi led to the development of a marketable instrument and the setting up in 2014 of a spin-off: IRsweep. In its first version, the IRis-F1 spectrometer takes measurements with a time resolution of less than a microsecond. What’s more, its luminosity is such that it can be used in a wide range of applications even in very dense environments. Moreover, it works over a wide spectral range. The applications of IRis-F1 are already numerous. Studying protein dynamics, diagnosing combustion, carrying out polymer chemistry analyses, monitoring dental curing, and analyzing liquids and solids in physics, chemistry, biology, pharmaceuticals and biotechnologies are just some of the possibilities.
In 2019, Prof. Dr Muriel Lepère, director of the LLS at UNamur, discovered IRis-F1 and challenged IRsweep to develop a new version allowing high spectral resolution with a perfect knowledge of the relative wavelength scale, and a very good signal-to-noise ratio. A technological and scientific collaboration between IRsweep and Namur’s team started with the acquisition by Prof. Dr Muriel Lepère of IRis-F1 in 2020. This marked the start of joint development of the instrument, combining the expertise of LLS and IRsweep. This collaboration gave rise to the second improved version of the spectrometer with high spectral resolution for gas studies, and temporal resolution capabilities for liquids and solids. This technological breakthrough has been the subject of several scientific publications: the first, a seminal one, appeared in Nature in 2014 (Nature 492 (7428), 229-233, by A. Hugi, G. Villares, S. Blaser, H.C. Liu, J. Faist), while another published in 2022 was devot-
ed to the characterization of this new version of IRis-F1, with Prof. Dr Muriel Lepère as first author (Journal of Quantitative Spectroscopy and Radiative Transfer 287, 108239, by M. Lepère, O. Browet, J. Clément, B. Vispoel, P. Allmendinger, J. Hayden, F. Eigenmann, A. Hugi, M. Mangold). This summer 2023, Prof. Dr Lepère was an invited speaker at Optica (the American leading society in optics and photonics) sensing congress. Other sources of pride for her: Jean Clément, the world’s first PhD student working on the new version of IRis-F1, won first prize at the annual meeting of the Belgian Physical Society in 2023 for his study of methane; the quality of the results obtained recently with IRis-F1 allows the LLS’ team to present several communications during international conferences leading to exchanges in view to develop new projects and collaborations. Her team has now acquired the expertise to use and further develop the instrument.
The IRis-F1 spectrometer of LLS is unique in the Belgian market. It has already established itself as a benchmark instrument thanks to its broad spectral range and performance. In addition, the quality of the signal is continuously improved by Olivier Browet, a specialized technician at LLS, while the field of application is broadened through meetings with specialists from different disciplines. One thing is certain for Prof. Dr Lepère: this is an instrument for the future. By combining fundamental research, applied research and a marketing approach, Prof. Dr Muriel Lepère has changed her outlook. A vision that now encompasses simulations, measurements, technological developments and collaboration with industry: a continuum that will lead to even greater advances in science!




Created in 2017 by Dr. Jonathan Douxfils, professor at the University of Namur (UNamur), QUALIblood offers a wide range of biological analyses integrating innovative biomarkers.


With 9 scientific experts dedicated to its clients’ preclinical and clinical projects and to its internal research projects, QUALIblood has more than 10 years’ exper tise in haemostasis and biomarkers, with more than 600 biomarkers available in its portfolio. The CRO also has over 100 scientific publications in the therapeutic and diagnostic fields of interest.
QUALIblood stands out for its expertise in biomarker identification and the development of innovative analysis methods. In 2023, the CRO finished the development a blood test which is now available for the practicians, to assess the risk of thrombosis for women taking the contraceptive pill. Other indications are currently being evaluated: pregnancy, the menopause, breast cancer treatments, etc. The biomarker developed in this context can be used to alert the prescribing clinician to potential unidentified pathologies and enable further investigation (genetic or other tests) if necessary. To date, this test is the only solution that can identify thrombotic risks acquired under estrogen therapy. The test is carried out by QUALIblood laboratory, and partnerships have been set up with analysis laboratories (including Laboratoire Olivier), hospitals and gynaecologists in Belgium to make the test available to the widest possible audience. At the same time, the team is working on the development of a dedicated kit to reduce the cost of analyses and promote its transferability to analysis laboratories worldwide.
As well as developing new biomarkers, QUALIblood is attentive to the new technologies available, the needs of the market and the demands of new guidelines. With this in mind, the laboratory has acquired Quanterix’s Simoa technology, which enables biomarkers to be identified at very low concentrations in the femto molar range (1.10-15 molar). This technological feat eliminates the need to collect cerebrospinal fluid (CSF), since the marker of interest can be detected in the blood. This allows to measure markers of neuronal damage as well as cancerous and cardiovascular markers. This means that pathologies can often be diagnosed earlier, using less invasive sampling techniques. Ultimately, this improves patient care and, above all, enables to better characterise the biological effect of new innovative therapies. At the same time,
QUALIblood is working on specific cellular models that have been developed to highlight immune responses to infectious diseases, for example.
Thanks to its partnerships and its team of experts, the laboratory can offer a portfolio of analyses involving more than 10 different technologies for biological haemostasis analyses, identification of known biomarkers, development of new biomarkers, blood biocompatibility assessments, etc. Its project managers are also at the service of its partner customers in defining clinical protocols in order to guide and determine the most appropriate clinical testing strategy in line with regulations. Thanks to their expertise in this field, QUALIblood’s experts can advise on the (pre-)analytical methods to be applied and can also manage the samples collected before and after their analysis, using, if necessary, the services of the NAB-X biobank with which they collaborate.
The versatility and dynamism of the team enables QUALIblood to position itself as a partner for companies with product portfolios at an early stage of development. Depending on the client, support can be one-off or more comprehensive, covering the early stages of development right through to submission of the dossier to the authorities, and even beyond, during the post-marketing authorisation (MA) phases. A recent example is the partnership with Mithra in the development of their new contraceptive pill, which has a more favourable safety profile than traditional pills.
As part of this partnership, the QUALIblood team developed a biomarker enabling this characteristic to be highlighted during clinical trials. This biomarker made it possible to prove the safety of the drug without having to wait for the post-authorisation studies


normally required for this type of product. The post-marketing studies will, of course, be carried out, but they will be reduced thanks to the test that has been put in place. QUALIblood’s support for this product began at a very early stage and continues to this day. In addition to the development and validation of the biomarker, it has included sample management, the completion of clinical files, data analysis and interpretation, and the promotion of the product with the partner.
QUALIblood attaches great importance to quality and the scientific support provided. It operates in accordance with the ISO17025 standard, for which accreditation is currently being sought from BELAC. This demand for quality is also facilitated by the advanced technological platforms used by QUALIblood. SIMOA, HPLC MS/ MS, MULTIPLEX, Calibrated Automated Thrombogram, ST-Genesia, STAR-MAX, ACL-TOP, Cell-based NETosis model, Cell-based serological model, Cell-based adenovirus resistance model, etc. These platforms are highly valued by the laboratory’s customers: small and medium-sized pharmaceutical companies, universities and hospitals in Belgium and neighbouring countries.
Committed to the circular economy, QUALIblood serves mainly Belgian customers and partners. The laboratory is fully aware of the potential of its environment and the levers available to grow and evolve in the sector. In this context, some of its partnerships are established as part of research and development projects subsidised by the Walloon Region or the federal government.
That said, QUALIblood intends to extend its range of services to more Belgian and European biotech companies. The laboratory also wants to promote and publicise the nAPCsr test to all gynaecologists in Belgium, France and Europe in general: the risk of thrombosis linked to contraceptive pills does not stop at borders. The QUALIblood team is convinced that it can ach ieve this objec tive not only with the medical public, but also with the general public. After all, it’s up to patients to choose the style of contraception they prefer. Ultimately, the laboratory plans to strengthen its global service offering by establishing partnerships with other companies with expertise in this field. A winning strategy to strengthen the Belgian value chain and encourage the emergence of innovative therapies in the country.


QUALIblood
Rue du Séminaire 20A - B-5000 Namur
Tel.: +32 81 44 49 92
Email: jonathan.douxfils@qualiblood.eu
https://www.qualiblood.eu/

Could you remind us of Wagralim’s key figures and strategy?
The Walloon agri-food competitiveness cluster Wagralim has 275 members, 75 projects approved by the Walloon Government, 246 products, services or processes and 21 patent applications. The cluster’s strategy is based on innovation and the construction of a strong collaborative network serving a majority of SMEs and a few compagnies in the sector, which it supports in their development and transition. The challenge is to adopt a global vision of innovation: products, processes, raw materials, packaging... All these parameters will undergo major upheaval over the next 5 years. To have an impact and be relevant, we need to promote innovation that encompasses science, technology, sales, distribution, and even the way SMEs work with their partners, suppliers and customers.

What are the salient features of the agri-food industry in Wallonia?
In 2022 the Walloon agri-food market accounted for €10.5 billion in sales, including €6 billion in exports and €4 billion in imports, €499 million in investment, 25,298 direct jobs (or 20,708 full-time equivalents) and 1,648 employers. It’s a very open market: its players think far beyond the region’s borders. But it’s also a market where companies are more or less advanced in terms of energy and environmental transition. It has to be said that the sector is highly dependent on energy for transport and processing. Yet it is crucial to anticipate current and future developments, to be innovative and proactive in order to increase our level of resilience. We saw this clearly during the Covid crisis: the sector showed itself to be very flexible. It is much less flexible when it comes to dealing with the fluctuations in the prices and quantities of raw materials that we have seen since the start of the war in Ukraine. Faced with the risk of overexposure to geopolitical and natural hazards, we need to plan stress tests to check our degree of dependence on various raw materials. Analyse and proactive innovation.
What is the general objective behind all the projects awarded the Wagralim label? Energy efficiency is a constant concern. It is no longer acceptable for a company to generate too much waste or emit too much CO2. Digitalisation and ar tificial intelligence need to be harnessed to

improve the control and efficiency of production processes: that’s how an SME will judge the added value of an innovation and be inclined to adopt it. We are also working to make water use more circular. With this in mind, we are setting up studies that will enable us to establish the state of the art and propose concrete solutions for reducing the sector’s water footprint. For example, wastewater can be used as a source of energy or to irrigate crops. Similarly, the cluster is very interested in recycling by-products into high added-value products with a high environmental value.
Could you give us a few examples of projects approved by the cluster?
The Wallep project aims to bring to market a new range of products based on Walloon spelt, which will create added value in the region and offer consumers products of differentiated quality, while promoting the establishment of a spelt industry in Wallonia. This involves selecting the most suitable varieties and optimising the in dustrial processes involved. The aim of the WalMeat2U! project is to provide training in the meat processing industry through a modularised and integrated offer from slaughtering to portioning. It is based on the use of a mobile training unit fitted out to industry standards for cutting up domestic ungulates: a rapid and flexible response to employers faced with labour shortages, and a welcome addition to the traditional training courses. Finally, the Ecopoon project (an investment project of Wagralim) has enabled the design and marketing of 100% edible cutlery: a classic spoon and an aperitif spoon. The production process has been replicated on a larger scale thanks to the brand new manufacturing workshop in Battice, which promotes local production in the Liège region, in perfect harmony with local sourcing: the wheat flour comes from Moulins du Val Dieu, just 10 km away.
Could you give us a few examples of companies recently supported by Wagralim in their innovation projects?
As part of the Delicen’s project, several companies were involved in improving the nutritional quality of the food offered to elderly


people living in retirement homes: Copains (a bread manufacturer), Pasta della Mamma (a pasta manufacturer), Detry (a charcuterie and meat producer) and Materne (which makes compote and jam). Several criteria specific to this age group had to be taken into account, including protein requirements and the need to make food attractive and easy to chew and swallow. Another project, Microbiostress, brings together three companies (Botalys, Lacto Research and Ortis laboratoires) alongside three Walloon universities (ULiège, UCLouvain, UMons). It stands out for its innovative approach to stress through the development of nutritional ingredients. The aim is to develop a natural, effective and safe-to-use solution, an innovative formulation based on solid scientific research that will combine ingredients targeting the mechanisms involved in the development of disabling symptoms generated by the stress factor. As these symptoms affect both young and old, the product developed will be suitable for a very wide range of people!
What European projects are you involved in?
We are taking part in 7 projects + 3 projects as coordinator : F2F Health Matters (which targets the internationalisation of healthy food products, bio-based techno-functional solutions and biosolutionscoordinator), B-Resilient (which aims to give SMEs in food production and processing the means to become more resilient and accelerate the dual green and digital transition - coordinator), Biotech4Food (which supports creation of new circular agri-food value chains - coordinator), Tribiome (which aims to implement a systemic solution to transform today’s food production systems), MixMatters (which separates and valorises three types of mixed bio-waste streams containing impurities from the agri-food industry), HighFive (which implements or brings to the market innovative digital solutions to concrete challenges of the food processing companies) and Manurefinery (new granted project). Our finalized EU projets are: New Frontiers in Food (NF4, which aims to develop a joint internationalisation strategy for the connected food,
functional food and healthy ingredients and processed food markets) and S3Food (intelligent sensors for the food industry). We are also involved in 2 thematics at the international level: AgriBioCare (Walloon biosolutions for sustainable agriculture) and BHIG (Belgian Health Ingredients Group, a collective initiative bringing together 7 companies active in the field of nutrition and health). Finally, we are actively involved in EU initiative: thematic Smart Specialisation Platform on agrifood. We lead ingredients for a circular economy partnership and participate in Smart sensors 4 agri-food and S3 food packaging. Thanks to our team of 15 dedicated people, we intend to increase our European involvement even further in 2024.
What do you see as the main challenges facing the Walloon agri-food industry? Fluctuating raw material prices, the difficulty of recruiting staff, high energy prices, the revaluation of the food system and the new rules on sustainable development are all issues that are mobilising all the players in the sector. The DNSH (Do no significant harm) principle now prevails at European level as a criterion for funding projects Walloon compagnies are not always aware but Wagralim stress them on those changes. With this in mind, Wagralim has an important role to play: acting as a sustainability accelerator for businesses.


Founded in 2010, the Walvert consultancy is a key partner for developers of biomethanisation projects in Wallonia. Its expertise, both recognised and sought after, is aimed at companies, local authorities and businesses.
Offering pre-studies and feasibility studies for biomethanisation projects was Walvert’s initial raison d’être when it was set up. Its engineers were enthusiastic about the idea of promoting the development of renewable energy from biomass. But they were soon disillusioned when they real ised that some projects were not going ahead. So they stepped up a gear in 2016 by proposing solutions for the construction of biomethanisation units. This involves applying for planning permission and the construction itself. A welcome initiative, since 5 biomethanisation units were launched between 2010 and 2020.
But that wasn’t enough for Walvert. It was urgent to go even further. So, in 2020, in addition to its existing offering, the consultancy proposed to operate biomethanisation sites. A judicious proposal, given that waste treatment and maintenance require the services of professionals. And Walvert hasn’t stopped there: financing solutions are now available to ensure that projects go ahead. Ultimately, the design office is offering a complete solution to support a sector of the future in Wallonia.
For Walvert, it is essential to establish a partnership with the project owners - whether they are companies, local authorities or farmers wishing to convert their biomass into renewable energy that is less costly for their farms. Project owners are co-partners, or even co-owners, since they can become shareholders in the project even if they wish to remain in the minority. A fine illustration of the circular economy with medium-sized projects: the biomass is harvested within a 15 km radius.
Building on its highly-prized expertise in Wallonia, Walvert operates the biogas plant located in Mettet. Walvert is also currently building a new plant in Estinnes. Another site construction is planned for 2024 at Froidchapelle. And let’s not forget the dozen or so projects under study or at the planning permission


stage. This dynamic should accelerate if we consider that in Wallonia one commune in two is a potential partner for Walvert. The consultancy estimates the installed capacity per biogas unit at 1 MWe for Estinnes and Froidchapelle. If we deduct self-consumption (of the order of 8%), we reach the very appreciable result of 7,500 MWhe per year, which represents the electricity consumption of 5,000 inhabitants - consumption that would require, by way of comparison, the operation of two medium-sized wind turbines.
Biomethanisation therefore has its place in the energy mix promoted by the Walloon Region. Convinced of this, Walvert is a member of the TWEED cluster, which promotes the development of renewable energies and the circular economy. The cluster has also put it in touch with project developers interested in the biomethanisation solution. By 2030, Walvert has big ambitions: to have ten new biomethanisation units in operation. In December 2022, Walvert was awarded ISO 9001 certification for the industrialisation and professionalisation of its support process regarding studies experience. Not content with its presence in Belgium, the design office is now looking to expand across Europe and outside Europe, where it is offering its turnkey solution. Expansion and internationalisation: two reasons for Walvert to be confident!

Walvert
Rue de Beaumont 150-152 - B-6030 Charleroi
Tel.: +32 (0)71 49 55 88
Email: info@walvert.be - https://www.walvert.be/
























